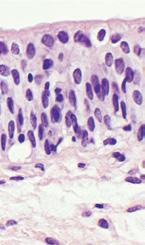
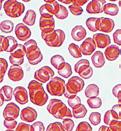

MOSTRA














































Els sabers bàsics del curs

Ada Jonath. Curiosa per naturalesa
Comprén, reflexiona i posa a prova les teues competències
a nutrició i l’alimentació
Louis Pasteur. Un químic entre bacteris


42
Comprén, reflexiona i posa a prova les teues competències
a la funció de nutrició
• Lucy Wills. Una guerrera contra l’anèmia
1. L’aparell digestiu
2. La digestió
3. L’aparell respiratori
4. L’aparell circulatori
5. La circulació sanguínia
6. El sistema limfàtic i el medi intern
7. L’aparell excretor
8. La salut i la funció de nutrició
60
Comprén, reflexiona i posa a prova les teues competències
10 24 26
Dossier d’aprenentatge 82 Índex
DESAFIAMENTS QUEMARQUEN
És una emergència! 84
4 L a funció de relació
• Rita Levi-Montalcini. La dama de la neurona
1. La relació en l’ésser humà
2. La percepció: els sentits
3. La percepció i la salut
4. La coordinació nerviosa
5. La salut del sistema nerviós
6. La coordinació endocrina
7. La salut del sistema endocrí
8. Les drogues i la drogoaddicció
9. L’execució de la resposta. L’aparell locomotor
10. L’execució de la resposta i la salut
Comprén, reflexiona i posa a prova les teues competències
5 A parells per a la funció de reproducció
• Marie-Anne Victorie Gillain Boivin. Una ginecòloga sàvia
1. La reproducció humana
2. Els aparells reproductors
3. Els gàmetes humans
4. Els cicles de l’ovari i de l’úter
5. La fecundació, l’embaràs i el part
6. Salut i planificació reproductiva
Comprén, reflexiona i posa a prova les teues competències
6 Vida sana
• James McCune Smith. L’esperança d’un poble
1. La salut i la malaltia
2. Els tipus de malalties
3. El medi ambient i la salut: One Health
4. La transmissió de les malalties infeccioses
5. El sistema immunitari
6. Prevenció i curació de malalties infeccioses
7. Els trasplantaments i la donació
8. Els primers auxilis
Comprén, reflexiona i posa a prova les teues competències
DESAFIAMENTS QUEMARQUEN Viure en un volcà
7 L a Terra canviant
• Alfred Wgener. Un explorador a la deriva
1. La superfície terrestre i els seus canvis
2. El temps geològic
3. L’energia interna de la terra i els processos endògens
4. El magmatisme i els volcans
5. Les forces tectòniques
6. Els riscos geològics
Comprén, reflexiona i posa a prova les teues competències
8 El modelat del relleu
• Marjorie Sweeting. La gran exploradora del carst
178
1. El modelat del relleu
2. Els processos geològics exògens
3. El modelat de les aigües de torrentera
4. El modelat dels rius
5. El modelat de les aigües subterrànies
6. El modelat glacial
7. El modelat del vent
8. El modelat de la mar
9. Els éssers vius modelen el relleu
10. El sòl
Comprén, reflexiona i posa a prova les teues competències
Dossier d’aprenentatge

86
118
136
Dossier d’aprenentatge 158
160
162
Explorem el nostre patrimoni geològic
202
DESAFIAMENTS QUE MARQUEN

























OBERTURA D’UNITAT



havia un altre ginecòleg, Hannay, que tractava els seus pacients de gonorrea d’una forma dolorosa i, al meu entendre, ineficaç. Hauria sigut més fàcil mantindre’m al marge, però soc incapaç d’ignorar aquestes coses, de manera que em vaig posar mams a l’obra. Vaig entrevistar pacients de Hannay, vaig recopilar dades sobre el seu tractament les vaig comparar amb les d’altres opcions. Vaig ser pioner a usar l’estadística per a traure conclusions. Vaig reunir tota la meua investigació



Recursos relacionats amb LES CLAUS del projecte













Situació d’aprenentatge, una per a cada trimestre, que et farà posar en acció els coneixements, les destreses i les actituds que treballaràs, i que contribuirà a l’adquisició i al desenvolupament de les teues competències.




Coneix una figura científica. Coneix la biografia de científiques i científics i descobrix les grans aportacions que han fet al coneixement científic.
Continguts i recursos digitals de la unitat.


Passos de la seqüència d’aprenentatge corresponents a la unitat amb les explicacions necessàries per a desenvolupar-la.


Compromís ODS Pla lingüístic Desenvolupament del pensament Aprenentatge cooperatiu
DOSSIER D’APRENENTATGE Per comprovar si la informació recollida en els tríptics ha promogut un canvi d’hà- bits, pots tornar a analitzar els costums alimentaris dels teus companys com- panyes unes setmanes després. Comprova quins aliments porten per a l’esplai compara la informació amb la que vas recollir al principi del projecte. Les conclusions de comparar l’evolució dels costums al teu centre servirà per a comprovar si hi ha hagut un impacte positiu de la vostra intervenció, en aquest cas, potser voldràs estendre aquesta pràctica a altres nivells o difondre-la en xar- xes perquè es faça en altres centres. També és possible que no s’haja produït un impacte significatiu. En aquest cas, seria interessant analitzar les raons per les quals no ha funcionat plantejar reptes nous que es dirigisquen a obtindre re- sultats millors. l’últim escenari possible és que us trobeu amb dades pitjors que les inicials; si fora així, podeu reflexionar sobre quins aspectes del projecte hi han pogut influir quins canvis es podrien introduir per a evitar-ho. A més d’aquesta anàlisi d’impacte, les conclusions extretes en aquest projecte es poden ampliar amb una anàlisi de les diferències en l’alimentació a gran escala. Com és possible que 690 milions de persones al món no tinguen aliments sufici- ents, mentre que en altres llocs del planeta es malgasten cada dia milers de tones d’aliments? Et proposem veure el documental «Taste the waste» recollir dades per a establir un debat a classe, prenent com a estímul aquesta afirmació: «La fam és conse- qüència directa d’un sistema alimentari injust». SUPERXEFS Si aquest projecte t’ha resultat interessant vols investigar més sobre la funció de nutrició, ací tens algunes idees per a crear els teus projectes. TAMBÉ POTS PROVAR AQUESTS PROJECTES Descriptor Aconseguit Parcialment aconseguit No aconseguit Utilitze el científic comprove hipòtesis mitjà de l’experimentació indagació. desenvolupat hàbits de saludables relacionats amb Conec importància meua participació en de la salut pública de l’alimentació. accions amb fonament científic preservar la entorn. Expresse conceptes pensaments científics de forma adequada. Use el pensament per a entendre explicar fenòmens. digitals per a crear continguts compartir-los. Estudi de la teua dieta setmanal Repartits per parelles, cada alumne o alumna pot ana- litzar el menjar que ha con- sumit un company o una companya al llarg d’una setmana, analitzant de nou nutrients oferint propostes de millora. Concurs teu centre: «Snacks saludables» A més d’investigar, dissenyar escriure sobre di- etes saludables, podem proposar a l’alumnat que dissenye cuine snacks sans nutritius. Un concurs de cuina amb jurat premis pot ser un gran incen- tiu per fomentar la creativitat basada en crite- ris científics. Els snacks es poden elaborar a casa (gravant vídeos o portant el resultat a classe) o, si és possible, les instal·lacions del centre. Revisa la teua planificació del treball el treball del teu grup en aquest projecte omplint la rúbrica que pots trobar en anayaeducacion.es REVISA LA TEUA PLANIFICACIÓ EL TREBALL EN GRUP PERFIL COMPETENCIAL D’EIXIDA En finalitzar aquests desafiaments, reflexiona comprova si has aconseguit els ob- jectius següents: Completa en el quadern Col·laboració amb centre de salut o hospital pròxim El centre de salut és un lloc on es promouen els bons hàbits de vida, ja que aquests pre- venen l’aparició de moltes malalties. A més, allà acudixen persones de l’entorn, de totes les edats característiques socials, per la qual cosa és un lloc ideal per a proposar una col- laboració; per exemple, repartint els tríptics elaborats per l’alumnat. Estudi de la dieta proposada al menjador escolar Fes estudi nutricional sobre els productes d’un menjador o cafe- teria escolar. Elabora una proposta de dieta saludable. Es pot fer una infografia final a manera de cartell amb les conclusions obtingudes amb la dieta alternativa elaborada. TRIMESTRE 1 140 SEQÜÈNCIA D’APRENENTATGE Què descobriràs? anayaeducacion.es En aquesta unitat James McCune Smith. L’esperança d’un poble 1. La salut la malaltia 2. Els tipus de malalties 3. La transmissió de les malalties infeccioses 4. El sistema immunitari 5. Prevenció curació de malalties infeccioses 6. Els trasplantaments la donació Comprén, reflexiona posa a prova les teues competències En anayaeducacion.es Per a motivar Vídeo: Abans de començar Coneix més... James McCune Per a detectar idees prèvies Presentació: Què necessites saber Per a exposar Infografia: La circulació sanguínia Presentació: Emergències sanitàries en el segle El cicle d’un retrovirus: el cas del VIH Vídeos: La importància de llavar-se les mans Per a exercitar Activitats interactives: Aprén jugant; Posa’t a prova Taller de ciències: Analitza la composició del tabac I, a més, tota la documentació necessària per a aplicar les claus del projecte. 7.1 7.2 7.3 8.1 8.2 8.3 9.1 9.2 T’imagines com és pertànyer a una altra persona? Que el teu cos les teues accions siguen propietat d’un altre... Això és el que significa ser esclau. Em dic James McCune abans de dedicar-me a la medicina vaig ser un dels últims esclaus a Nova York. Vaig nàixer en 1813, però la meua vida, la vertaderament meua, va començar quan vaig ser alliberat 14 anys després. Vaig créixer només amb ma mare, que també era esclava. Ella em va enviar a estudiar a l’«African Free School», un dels pocs llocs on s’educava els xics negres. Allà vaig demostrar ser un alumne excel·lent, sensible al patiment alié. El meu professorat em va animar a estudiar Medicina, però em van rebutjar totes les universitats de Nova York per ser afroamericà. Un dels meus professors, el Reverend Peter Williams, em va proposar intentar-ho a la Universitat de Glasgow a Escòcia. allà que vaig anar!, armat només amb la meua intel·ligència i amb els diners que el meu professor alguns dels seus socis havien reunit per a ajudar-me. En 1837 em vaig graduar en Medicina vaig ser el primer de la meua classe. A partir d’aleshores vaig començar a exercir com a ginecòleg vaig publicar els meus primers articles. Els primers escrits per un metge afroamericà! En aquella època hi
en un article que va acabar amb les pràctiques de Hannay, cosa que em va alleujar molt. Quan vaig tornar a Nova York, em van rebre com un heroi. Vaig obrir la meua consulta per a atendre tot tipus de pacients, sense discriminació. Vaig muntar una escola una farmàcia, després vaig treballar més de 20 anys com a metge d’un orfenat. Vaig publicar desenes d’articles sobre medicina en contra de l’esclavitud del racisme... Així tot, mai em van admetre en l’Associació Mèdica Americana. Que hi podem fer! La meua contribució a la comunitat afroamericana a la humanitat en general és igual de valuosa. Vida sana JAMES MCCUNE SMITH. L’esperança d’un poble 6 PRESENTACIÓ DE LA SITUACIÓ SUPERXEFS ☞✠✄✌✝✕✍ Nutriscore ✆✞✝✆✑ ✏✆✕ ✖✑☎✕✎✗✄✎ ✖✑✕✟✄☎✄✖✌ ✜✁✆✄ ✌ ✠☎✄✍✕✎✖✑✎ ✖✕✠✟✕ ? ✙✚✖✟☎✕✎✕ ✆✞✖✕✎✟✑✘✑ ➃✄✎✑✟✢✕✍✠✄✎✓✝✑✛ ✑✎✓✝➄ ✎✓ ✖✕✞✆ ✞✕✆✄ ✠✟✑✘✣✎✄✠ ❸✄✎✟✘✄✠✝ Unitat 1 Unitat 2 Unitat 3 3 INFRAESTRUCTURA
Així és el teu llibre
Inici del trimestre
Final del trimestre
SABERS BÀSICS
I ADQUISICIÓ DE COMPETÈNCIES



mosquit, la ràbia, pel mos de gossos infectats. Vies d’entrada L’entrada dels agents infecciosos en les persones es pot produir per:
Via cutània. La nostra pell pot tindre talls, arraps o altres lesions per on poden penetrar els patògens. Aquests es distribuïxen a través de la sang per tot l’organisme.
Via respiratòria. L’aire que respirem pot contindre bacteris o virus que entren a través de l’aparell respiratori. - Via digestiva. Els gèrmens penetren quan prenem aliments o aigua contaminats.
Via genitourinària. Els patògens poden entrar de diferents formes, com, per exemple, per contacte sexual.
COMPRÉN, PENSA, INVESTIGA... Enumera les vies d’entrada dels agents infeccio2 Classifica en el quadern com es transmeten les malalties següents busca les vies de transmissió d’aquelles que no conegues: la ràbia, el còlera, la grip, la fenilcetonúria, la psoriasi, el dengue, l’Ebola, la malaltia de Chagas l’anorèxia, la parotiditis la candidiasi. 3 Explica almenys una mesura per a evitar contagiar-te d’una malaltia respiratòria, d’una digestiva d’una genitourinària.

TANCAMENT D’UNITAT

Formes diverses de representar la informació (textual, gràfica) per a ajudar-te a comprendre, expressar-te i oferir-te experiències que et motiven a participar en el teu aprenentatge.
Activitats, especialment dissenyades per al desenvolupament de les teues competències, que et permetran refermar l’aprenentatge i relacionar coneixements.
Les icones incloses en algunes activitats suggerixen la clau del projecte que es pot aplicar en cada cas.













anticossos? En què consistix la memòria immunitària?
9 Indica si les frases següents fan referència a una vacuna o a un sèrum.
a) És un mètode curatiu.
11 Definix cèl·lula mare indica els avantatges d’utilitzar-les en els trasplantaments.
Avança 12 Responeu en grup. a) Seleccioneu una malaltia

Organitzador visual dels continguts
Qüestions sobre els aspectes essencials de la unitat, amb les quals podràs elaborar el teu resum.
Imatges perquè treballes l’observació i la interpretació.
Aplica i avança
Reflexió sobre els avanços realitzats en la situació d’aprenentatge corresponent a la unitat.
Proposta en la web d’una avaluació de les teues competències.



U 6 Recorda seleccionar el material de treball d’aquesta unitat per al dossier d’aprenentatge. COMPRÉN Mapa conceptual jeràrquic. quadern els espais buits del diagrama d’Ishikawa següent. Aprén a usar aquest organitzador amb el recurs disponible en anayaeducacion.es Malalties no infeccioses Endocrines metabòliques Genètiques Nutricionals Al·lèrgiques Autoimmunes Mentals Traumatismes Toxicològiques Degeneratives Es deuen Exemples Es deuen Exemples Es deuen Exemples Es deuen Exemples Es deuen Exemples Es deuen Exemples Es deuen Exemples Es deuen Exemples Es deuen Exemples Toxines que originen trastorns Hemofília, síndrome de Down... Al·lèrgia pol·len, àcars... Depressió, esquizofrènia, anorèxia… Desgast dels òrgans ? ? ? ? ? ? ? ? ? Fes un resum 2 Elabora el teu resum de la unitat seguint aquest guió. Definix salut malaltia anomena els factors que influïxen en la salut. Explica què són les malalties infeccioses quins són els agents que les causen. Anomena les vies de transmissió d’entrada al nostre cos dels organismes patògens. Indica les fases en què es desenvolupa una malaltia infecciosa. Definix sistema immunitari establix les diferències entre immunitat específica inespecífica. Explica com té lloc la resposta inflamatòria. Explica com es poden previndre curar les malalties. Indica què és un trasplantament de quins tipus poden ser. Esmenta els possibles donants explica per què es produïx el rebuig en els trasplantaments. Interpreta imatges 3 Observa les imatges respon. a) Quin tipus d’organismes són quina classe de malalties produïxen? b) Anomena tres exemples de malalties causades per aquests tipus d’organismes. 4 Observa el gràfic següent contesta. 40 59,3 72,4 75,1 60 50 70 Font: ONU/El nostre món en dades. Esperança de vida en nàixer per regió — Amèrica del Nord — Europa — Amèrica del Sud — Món — Nord d’Àfrica — Àsia — África subsahariana 1950 1960 1980 2000 1970 1990 2010 2015 a) On hi ha més esperança de vida? menys? b) Deduïx les causes de les diferències observades quant a esperança de vida a les diferents parts del món. c) Com ha evolucionat l’esperança de vida al llarg de les últimes dècades? Per què? Aplica 5 Indica dos factors que poden influir en la nostra salut positivament dos que poden fer-ho negativament. Justifica la resposta. 6 Establix les diferències entre: a) Salut malaltia. b) Signe símptoma. c) Diagnòstic teràpia. d) Resposta inflamatòria resposta immunitària. e) Fagòcit limfòcit. f) Vacuna sèrum. 7 Explica què és de què depén la virulència d’un organisme patogen.
Com s’adquirix la immunitat específica? Què són els
8
És un mètode preventiu.
Conté anticossos. d) Provoca la resposta immunitària en el pacient. 10 Raona si una persona ha d’estar morta per a ser donant d’un òrgan.
b)
c)
sobre la qual elaborareu un informe detallat del protocol mèdic per a diagnosticar-la tractar-la. b) Exposeu la informació a classe mitjançant una presentació. 13 Preparar la tasca. La SIDA (síndrome d’immunodeficiència adquirida) està produïda per la infecció d’un virus, el VIH (virus de la immunodeficiència humana). Investigueu sobre diferents aspectes d’aquesta malaltia sobre l’agent causal elaboreu un mural per a exposar-lo a classe. a) Efecte de l’entrada del virus en el cos humà. b) Símptomes, conseqüències tractament. c) Formes de transmissió de la malaltia. d) Prevenció. 14 En l’actualitat, el mal ús dels antibiòtics i d’altres medicaments és un dels grans problemes sanitaris a què s’enfronten la societat la ciència. Respon les preguntes següents sobre aquest fenomen. a) Quins riscos sanitaris planteja aquest problema? b) Quines mesures es podrien plantejar per a solucionar-lo? REFLEXIONA Al llarg de les dues primeres unitats hem posat a prova l’eficàcia de diversos models de sistemes sanitaris comprovant com respondrien davant d’un accident de trànsit, un embaràs un part, i, en aquesta unitat, davant de la pandèmia de la COVID-19. Reflexiona sobre el que has aprés omplint el qüestionari la rúbrica corresponent, disponibles en anayaeducacion.es Totalment aconseguit aconseguit AconseguitQuasi aconseguit Entenc el que significa estar sa, comprenc les tres dimensions de la salut. Valore la importància de tindre un sistema sanitari fort davant d’emergències com la generada per la COVID-19. POSA A PROVA LES TEUES COMPETÈNCIES Fes l’autoavaluació competencial inclosa en anayaeducacion.es Recuerda que dispones, en tu banco de recursos: de diversos tallers per gestionar les teues emocions d’una diana per avaluar-les; de fitxes per a millorar la teua ciutadania digital. 47 U 6 146 La malària Observa la infografia respon: Quin és el nom del paràsit que causa la malaltia? Com arriba la malaltia als humans? Escriu un informe sobre la mortalitat de la malària, la incidència que té quines mesures es poden adoptar per a previndre-la. Recentment, l’OMS ha certificat l’eliminació de la malària a la Xina; busca informació sobre com s’ha aconseguit això. • Busca informació sobre la vacuna RT,S/AS01 explica si ha sigut eficaç o no. 3 La transmissió de les malalties infeccioses 3.2 Desenvolupament de les malalties infeccioses Les malalties infeccioses es caracteritzen per l’aparició de distints símptomes, entre els quals estan la febra, el malestar general o el decaïment. Totes aquestes malalties passen per un període d’incubació, un de desenvolupament la convalescència. El període d’incubació El període d’incubació és el temps transcorregut entre l’entrada del germen l’aparició dels primers símptomes. En aquesta fase, el microorganisme es multiplica envaïx el cos. El període de desenvolupament El període de desenvolupament és aquell en què apareixen els símptomes característics de la malaltia. Per exemple, les bambolles cutànies de la varicel·la o les erupcions rogenques de la pallola. La convalescència Aquesta és l’etapa final, en la qual ha desaparegut l’agent infecciós l’organisme es recupera dels danys patits durant la malaltia. 3.1 Formes de transmissió Els agents infecciosos o organismes patògens ens envolten. Es poden trobar en l’aire, en els aliments, en l’aigua, en el sòl, fins tot en els animals en les persones. Aquests mitjans són fonts d’infecció de transmissió de malalties. La transmissió pot tindre lloc: - Per contacte directe amb el malalt, com en la sida la sífilis. - A través de l’aire, de l’aigua d’objectes o aliments contaminats, com és el cas de la grip, el còlera o la salmonel·losi. - Per mitjà de vectors de transmissió, que, generalment, són animals. Per exemple, la malària es contagia per la picadura d’un
-
-
-
El mosquit injecta el paràsit Plasmodium en un ésser humà. 2 Els paràsits arriben a les cèl·lules hepàtiques es multipliquen fins que les trenquen. 3 Els paràsits passen a la sang infecten els glòbuls rojos, on es reproduïxen asexualment diverses generacions fins que sorgixen noves formes del paràsit que es poden reproduir sexualment. 4 Els paràsits arriben als mosquits a través de glòbuls rojos infectats amb les formes que es poden reproduir 5 El paràsit es reproduïx sexualment dins del mosquit dona lloc a les que es poden transmetre als éssers humans. en els éssers humans. Formes asexuals del paràsit Cèl·lula hepàtica Cèl·lula parasitària del paràsit El cicle de vida en els mosquits. De segur que alguna vegada has escoltat ordres com «No vages descalç que et refredaràs». Observa les imatges contesta les preguntes. a) En quina creus que és més probable que algú agafe un refredat? Argumenta la resposta. b) Com creus que es produiria el contagi? c) Viatges en l’espai en el temps. Creus que fa dos segles la gent hauria respost d’una altra forma? Per què? Per a saber com aplicar aquesta estratègia de pensament, consulta anayaeducacion.es Mites contagis ges r a imat V Via gent onsulta ana causades ejarplant anta antatges ges d’utilit Educació emocional TIC Orientació acadèmica i professional Avaluació


Així és el teu projecte digital

Un projecte que t’oferix tots els continguts del curs a través del llibre digital, juntament amb una gran diversitat de recursos.
Descobrix una altra forma d’aprendre senzilla, intuïtiva i compatible amb qualsevol plataforma i dispositiu.































































Com hi accedixes?
Tens totes les indicacions necessàries per accedir-hi al costat de la primera pàgina del teu llibre.






























































Com és?

Una resposta global per a un entorn educatiu divers.



Intuïtiu
Fàcil d’utilitzar per a tu.









Multidispositiu
S’adapta i es visualitza en qualsevol tipus de dispositiu (ordinador, tauleta, smartphone...) a qualsevol grandària i resolució de pantalla.
Descargable
Et permet treballar sense connexió a Internet i descarregar-lo en més d’un dispositiu.
Sincronitzable
Els canvis que faces se sincronitzen automàticament en connectar qualsevol dels dispositius en els quals estigues utilitzant-lo.








Què t’oferix?
Conté diversitat de recursos; és molt més que una reproducció del llibre en paper. Amb aquests recursos podràs:
Exercitar activitats interactives
Estudiar resums interactius, esquemes...
Aprendre vídeos, Game Room...
Avaluar autoavaluació, Dossier d’aprenentatge...
Universal
Compatible amb tots els sistemes operatius, els entorns virtuals d’aprenentatge (EVA) i les plataformes educatives (LMS) més utilitzades als centres escolars.
Abans de començar
Coneix els teus desafiaments
COM SÓN?








Són tres propostes de situacions d’aprenentatge, una per a cada trimestre:
• Pensades per a mobilitzar coneixements, actituds i destreses i fomentar l’in-tercanvi de sabers i el desenvolupament de les teues competències.
• Compromeses amb els Objectius de Desenvolupament Sostenible 2030.
• Pròximes i respectuoses amb el teu món real i les teues experiències.
• Amb una estructura clara i senzilla de les tasques i activitats que hauràs de dur a terme.
COM HI TREBALLARÀS?




A L’INICI DE CADA TRIMESTRE TROBARÀS:
A L’INICI DE CADA TRIMESTRE TROBARÀS:






















• Un text motivador que et descobrirà un marc de desafiaments relacionats amb les unitats del bloc.
• La proposta d’una situació d’aprenentatge.
• La seqüència d’aprenentatge de la situació proposada.









• Els passos de la seqüència d’aprenentatge corresponents a la unitat, amb les explicacions necessàries per a desenvolupar-los.
SEQÜÈNCIA D’APRENENTATGE Què descobriràs? anayaeducacion.es En aquesta unitat James McCune Smith. L’esperança d’un poble La salut la malaltia 2. Els tipus de malalties La transmissió de les malalties infeccioses 5. Prevenció curació de malalties infeccioses 6. Els trasplantaments la donació Comprén, reflexiona posa a prova les teues competències En anayaeducacion.es Per a motivar Vídeo: Abans de començar Coneix més... Per a detectar idees prèvies Presentació: Què necessites saber Infografia: La circulació sanguínia Presentació: Emergències sanitàries en el segle El cicle d’un retrovirus: el cas del VIH Vídeos: La importància de llavar-se les mans Activitats interactives: Aprén jugant; Posa’t prova Taller de ciències: Analitza la composició del tabac I, a més, tota la documentació necessària per a aplicar les claus del projecte. 7.1 7.3 8.1 8.2 8.3 9.2 T’imagines com és pertànyer una altra persona? Que el teu cos les teues accions siguen propietat d’un altre... Això és el que significa ser esclau. Em dic James McCune abans de dedicar-me a la medicina vaig ser Vaig nàixer en 1813, però la meua vida, la vertaderament meua, va començar quan vaig ser alliberat 14 anys després. Vaig créixer només amb ma mare, que també era esclava. Ella em va enviar a estudiar l’«African Free School», un dels pocs llocs on s’educava els xics negres. Allà vaig demostrar ser un alumne excel·lent, sensible al patiment alié. El meu professorat em va animar a estudiar Medicina, però em van rebutjar totes les universitats de Nova York per ser afroamericà. Un dels meus professors, el Reverend Peter Williams, em va proposar intentar-ho la Universitat de Glasgow a Escòcia. allà que vaig anar!, armat només amb la meua intel·ligència amb els diners que el meu professor alguns dels seus socis havien reunit per a ajudar-me. En 1837 em vaig graduar en Medicina vaig ser el primer de la meua classe. A partir d’aleshores vaig començar a exercir com ginecòleg vaig publicar els meus primers articles. Els primers escrits per un metge afroamericà! En aquella època hi havia un altre ginecòleg, Hannay, que tractava els seus pacients de gonorrea d’una forma dolorosa i, al meu entendre, ineficaç. Hauria sigut més fàcil mantindre’m al marge, però soc incapaç d’ignorar aquestes coses, de manera que em vaig posar mams a l’obra. Vaig entrevistar pacients de Hannay, vaig recopilar dades sobre el seu tractament les vaig comparar amb les d’altres opcions. Vaig ser pioner a usar l’estadística per a traure conclusions. Vaig reunir tota la meua investigació en un article que va acabar amb les pràctiques de Hannay, cosa que em va alleujar molt. Quan vaig tornar a Nova York, em van rebre com un heroi. Vaig obrir la meua consulta per a atendre tot tipus de pacients, sense discriminació. Vaig muntar una escola una farmàcia, després vaig treballar més de 20 anys com a metge d’un orfenat. Vaig publicar desenes d’articles sobre medicina en contra de l’esclavitud del racisme... Així tot, mai em van admetre en l’Associació Mèdica Americana. Que hi podem fer! La meua contribució a la comunitat afroamericana a la humanitat en general és igual de valuosa. Vida sana JAMES MCCUNE SMITH. L’esperança d’un poble 6 PRESENTACIÓ DE LA SITUACIÓ Nutriscore propi Superxefs: dissenyant una dieta saludable Què passa amb els aliments dins del teu cos? Ajudants en el procés de nutrició Organitzem la informació en una infografia en forma de tríptic repartim el tríptic final INNOVACIÓ
QUINS SÓN?
• Superxefs, per al primer trimestre.
• És una emergència!, per al segon trimestre.
• Viure en un volcà, per al tercer trimestre.


EN LES PÀGINES FINALS DE CADA UNITAT TROBARÀS:



EN FINALITZAR EL TRIMESTRE TROBARÀS:








• Una reflexió sobre els avanços realitzats en la situació d’aprenentatge al llarg de la unitat.
• Una proposta d’avaluació de les teues competències que podràs descarregar d’anayaeducacion.es








El teu dossier d’aprenentatge del desafiament, amb:
• Tasques de comunicació i de compromís social.
• Altres propostes de desafiaments que et poden interessar.
• Propostes d’instruments de diagnòstic, que pots descarregar d’anayaeducacion.es
• Una rúbrica del perfil d’eixida, que pots descarregar d’anayaeducacion.es, per a autoavaluar l’adquisició de competències aconseguida.
U Recorda seleccionar el material de treball d’aquesta unitat per dossier d’aprenentatge. COMPRÉN Mapa conceptual jeràrquic. quadern els espais buits del diagrama d’Ishikawa següent. Aprén a usar aquest organitzador amb el recurs disponible en anayaeducacion.es Malalties no Endocrines Genètiques Al·lèrgiques Mentals Traumatismes Toxicològiques Degeneratives Exemples Es deuen Exemples Exemples Es deuen Exemples Exemples Exemples Es deuen Exemples Toxines que originen trastorns Hemofília, síndrome de Down... Desgast dels òrgans Fes un resum Elabora el teu resum de la unitat seguint aquest guió. anomena els factors que Explica què són les malalties infeccioses quins són els agents que les causen. nostre cos dels organismes patògens. Indica les fases en què es desenvolupa una malaltia infecciosa. Definix sistema immunitari establix les diferències entre immunitat específica inespecífica. Explica com té lloc la resposta inflamatòria. Explica com es poden previndre curar les malalties. Indica què és un trasplantament de quins tipus poden ser. Esmenta els possibles donants explica per què es produïx el rebuig en els trasplantaments. Interpreta imatges 3 Observa les imatges respon. a) Quin tipus d’organismes són quina classe de malalties produïxen? b) Anomena tres exemples de malalties causades per aquests tipus d’organismes. 4 Observa el gràfic següent contesta. 72,4 75,1 77,7 79,5 60 70 a) On hi ha més esperança de vida? menys? b) Deduïx les causes de les diferències observades quant esperança de vida les diferents parts del món. c) Com ha evolucionat l’esperança de vida al llarg de les últimes dècades? Per què? Aplica Indica dos factors que poden influir en la nostra salut positivament dos que poden fer-ho negativament. Justifica la resposta. 6 Establix les diferències entre: b) Signe símptoma. Diagnòstic teràpia. d) Resposta inflamatòria resposta immunitària. Fagòcit limfòcit. f) Vacuna sèrum. Explica què és de què depén la virulència d’un organisme patogen. 8 Com s’adquirix la immunitat específica? Què són els anticossos? En què consistix la memòria immunitària? 9 Indica si les frases següents fan referència una vacuna o un sèrum. a) És un mètode curatiu. b) És un mètode preventiu. c) d) Provoca la resposta immunitària en el pacient. Raona si una persona ha d’estar morta per ser donant d’un òrgan. 11 Definix cèl·lula mare indica els avantatges d’utilitzar-les en els trasplantaments. Avança Responeu en grup. a) Seleccioneu una malaltia sobre la qual elaborareu un informe detallat del protocol mèdic per a diagnosticar-la tractar-la. b) Exposeu la informació a classe mitjançant una presentació. Preparar la tasca. La SIDA (síndrome d’immunodeficiència adquirida) està produïda per la infecció d’un virus, el VIH (virus de la immunodeficiència humana). Investigueu sobre diferents aspectes d’aquesta malaltia sobre l’agent causal elaboreu un mural per exposar-lo a classe. a) b) Símptomes, conseqüències tractament. c) d) 14 En l’actualitat, el mal ús dels antibiòtics d’altres medicaments és un dels grans problemes sanitaris a què s’enfronten la societat la ciència. Respon les preguntes següents sobre aquest fenomen. a) Quins riscos sanitaris planteja aquest problema? b) Quines mesures es podrien plantejar per a soAl llarg de les dues primeres unitats hem posat a prova l’eficàcia de diversos models de sistemes sanitaris comprovant com respondrien davant d’un accident de trànsit, un embaràs un part, en aquesta unitat, davant de la pandèmia de la COVID-19. Reflexiona sobre el que has aprés omplint el qüestionari la rúbrica corresponent, disponibles en anayaeducacion.es Entenc el que significa estar sa, comprenc les tres dimensions d’emergències com generada per COVID-19. POSA A PROVA LES TEUES COMPETÈNCIES Fes l’autoavaluació competencial inclosa en anayaeducacion.es de diversos tallers per a gestionar les teues DOSSIER D’APRENENTATGE Per comprovar si la informació recollida en els tríptics ha promogut un canvi d’hàbits, pots tornar analitzar els costums alimentaris dels teus companys companyes unes setmanes després. Comprova quins aliments porten per a l’esplai compara la informació amb la que vas recollir al principi del projecte. Les conclusions de comparar l’evolució dels costums al teu centre servirà per a comprovar si hi ha hagut un impacte positiu de la vostra intervenció, en aquest cas, potser voldràs estendre aquesta pràctica a altres nivells o difondre-la en xarxes perquè es faça en altres centres. També és possible que no s’haja produït un impacte significatiu. En aquest cas, seria interessant analitzar les raons per les quals no ha funcionat plantejar reptes nous que es dirigisquen a obtindre resultats millors. l’últim escenari possible és que us trobeu amb dades pitjors que les inicials; si fora així, podeu reflexionar sobre quins aspectes del projecte hi han pogut influir quins canvis es podrien introduir per evitar-ho. A més d’aquesta anàlisi d’impacte, les conclusions extretes en aquest projecte es poden ampliar amb una anàlisi de les diferències en l’alimentació a gran escala. Com és possible que 690 milions de persones al món no tinguen aliments suficients, mentre que en altres llocs del planeta es malgasten cada dia milers de tones Et proposem veure el documental «Taste the waste» recollir dades per a establir un debat a classe, prenent com a estímul aquesta afirmació: «La fam és conseqüència directa d’un sistema alimentari injust». SUPERXEFS Si aquest projecte t’ha resultat interessant vols investigar més sobre la funció de nutrició, ací tens algunes idees per a crear els teus projectes. TAMBÉ POTS PROVAR AQUESTS PROJECTES aconseguit Utilitze el pensament científic comprove hipòtesis per mitjà de la salut pública través de l’alimentació. adequada. Estudi de la teua dieta alumne alumna pot ana-sumit un company o una companya al llarg d’una nutrients oferint propostes Concurs al teu centre: Snacks saludables» A més d’investigar, dissenyar escriure sobre didissenye cuine snacks sans nutritius. Un concurstiu per a fomentar la creativitat basada en criteris científics. Els snacks es poden elaborar casa (gravant vídeos o portant el resultat classe) o, si és possible, les instal·lacions del centre. Revisa la teua planificació del treball el treball del teu grup en aquest projecte omplint la rúbrica que pots trobar en anayaeducacion.es REVISA LA TEUA PLANIFICACIÓ EL TREBALL EN GRUP PERFIL COMPETENCIAL D’EIXIDA En finalitzar aquests desafiaments, reflexiona comprova si has aconseguit els objectius següents: Completa en el quadern Col·laboració amb centre de salut hospital pròxim El centre de salut és un lloc on es promouen els bons hàbits de vida, ja que aquests prevenen l’aparició de moltes malalties. A més, les edats característiques socials, per la qual cosa és un lloc ideal per proposar una collaboració; per exemple, repartint els tríptics elaborats per l’alumnat. Estudi de la dieta proposada al menjador escolar Fes un estudi nutricional sobre els productes d’un menjador o cafeteria escolar. Elabora una proposta infografia final manera de cartell amb les conclusions obtingudes TRIMESTRE


El mètode científic
El mètode científic és una metodologia específica que sistematitza la investigació i que ha permés a la humanitat progressar en la història de la ciència i la tecnologia.
1.1 El mètode científic
El mètode científic és un conjunt de passos ordenats que s’usen per a adquirir coneixements nous.
Plantejament del problema
Els científics i les científiques observen l’entorn de manera sistemàtica, la qual cosa els conduïx a plantejar-se problemes que requerixen una resposta i que es convertixen en l’objecte del seu estudi.
Elaboració d’una hipòtesi
A partir de l’observació realitzada i de la informació que recopilen sobre els coneixements previs, per mitjà de la recerca bibliogràfica, s’elaboren hipòtesis. És molt freqüent plantejar diverses hipòtesis diferents, que s’acceptaran o es rebutjaran després de l’experimentació.
Experimentació per a comprovar la hipòtesi
En aquesta etapa es dissenyen experiments, de camp o de laboratori, que permetran contrastar les hipòtesis plantejades.
Per a això, se solen elaborar models, formes simplificades del problema real, que disminuïxen el nombre de variables que s’han d’estudiar, la qual cosa facilita l’estudi del problema. Generalment, els experiments es fan per duplicat o triplicat per a obtindre dades més fiables.
Anàlisi dels resultats
Després de l’obtenció dels resultats per mitjà de l’experimentació, se’n fa l’anàlisi corresponent. D’aquesta es podran extraure conclusions sobre el problema estudiat. Per a això, s’elaboren taules, representacions gràfiques, etc. amb les dades obtingudes, que en faciliten la interpretació. Quan és possible, es duen a terme estudis estadístics de les dades, que augmenten la seua fiabilitat. L’anàlisi dels resultats permet:
- Comprovar la hipòtesi.
- Refutar la hipòtesi i modificar-la o plantejar una hipòtesi nova.
Hipòtesi. Possible explicació del fenomen observat, que s’haurà de sotmetre a experimentació.
Variable. Factor que pot canviar i que pot influir sobre el resultat de l’experiment, com, per exemple, la temperatura o la concentració d’una substància.
Comunicació dels resultats
Una vegada acceptada la hipòtesi, els investigadors i les investigadores comuniquen a la resta de la comunitat científica els seus resultats. Per a això, redacten articles científics i informes. També es reunixen en congressos amb altres científics de la mateixa àrea de coneixement, on intercanvien informació.
La difusió dels resultats és clau perquè altres investigadors i investigadores puguen reproduir l’experiment i validar-lo, i també per a poder dissenyar estudis nous que contribuïsquen a l’avanç del coneixement.
10
1
Els passos del mètode científic












































els resultats.


11 EL MÈTODE CIENTÍFIC
Comunica
Exemples de lleis científiques
Llei de Charles i Gay Lussac
La llei de Charles i Gay Lussac postula que el volum que ocupa una massa determinada d’un gas és proporcional a la seua temperatura, si la pressió es manté constant.

Lleis de conservació
Les lleis de conservació postulen que en els sistemes aïllats hi ha magnituds que tenen un valor constant, com, per exemple, la massa o l’energia.
Així, segons la llei de la conservació de la massa i la llei de la conservació de l’energia, la massa i l’energia d’un sistema aïllat es mantenen constants, és a dir, no es creen ni es destruïxen, únicament es transformen.
Energia potencial
Energia cinètica
Energia potencial

1.2 Com és el mètode científic
El mètode científic és un procés destinat a explicar fenòmens, establir relacions entre els fets i enunciar lleis que expliquen els fenòmens físics del món i permeten obtindre, amb aquests coneixements, aplicacions útils per a l’ésser humà.
Per a ser anomenat científic, el mètode ha de complir les característiques següents:
- Ser empíric, és a dir, es basa en l’experimentació. Es duu a terme en un laboratori o en el medi natural, en condicions controlades.
- Ser objectiu, és a dir, no es veu influït per la persona que fa l’estudi.
- Ser reproduïble per la resta de la comunitat científica, que ha de ser capaç de repetir l’estudi en les mateixes condicions i obtindre els mateixos resultats.
- Ser refutable, ja que no és infal·lible, és a dir, que està sotmés a estudis nous que podrien contradir-lo.
- Ser acumulatiu, ja que es basa en els coneixements, lleis i teories previs. La difusió dels resultats afavorix la construcció del coneixement i l’avanç de la ciència.
1.3 Lleis, teories i models
Quan la comunitat científica accepta que una hipòtesi és correcta i passa a formar part del conjunt de coneixements contrastats i acceptats, pot formular una llei o una teoria científica.
Altres vegades proposa models per a facilitar l’anàlisi i l’estudi dels fenòmens estudiats.
Les
lleis científiques
Una llei científica és un enunciat àmpliament demostrat, que relaciona de manera concreta dues o més variables, que són propietats d’un sistema determinat.
Les lleis solen estar expressades amb un llenguatge formal, generalment, en llenguatge matemàtic. Així, encara que una llei permet predir esdeveniments, no n’explica les causes.
12 1 El mètode científic
V1 T1 = V2 T2
Les teories científiques
Una teoria científica és un conjunt d’hipòtesis demostrades que expliquen o definixen un sistema o fenomen determinat. Generalment, les teories permeten fer prediccions sobre el sistema o fenomen d’estudi.
Les teories científiques poden incloure altres lleis o teories. La formulació d’una teoria implica el coneixement contrastat que permet explicar un sistema o fenomen. S’hi descriuen les variables que intervenen i la relació que s’hi produïx, i també les condicions davall les quals es pot aplicar la teoria. De les teories es poden deduir prediccions, que es poden sotmetre a l’experimentació.
Models científics
El mètode científic utilitza moltes vegades models, que faciliten l’experimentació de les hipòtesis proposades. Són instruments molt útils per a la investigació científica. Els models poden ser diversos (matemàtics, físics, estadístics, etc.) i s’utilitzen per a l’anàlisi, l’estudi i la simulació de sistemes o fenòmens, però d’una forma simplificada, és a dir, no es corresponen completament amb el sistema o fenomen real, però faciliten l’estudi del seu funcionament.
Un model científic és la simplificació teòrica d’un sistema o fenomen, que facilita l’estudi del sistema i la formulació de lleis i teories.
Exemples de teoria científica
La teoria cel·lular

Exemples de model científic


La teoria cel·lular afirma que la cèl·lula és la unitat estructural, funcional i reproductora de tots els éssers vius.
La teoria de l’evolució
La teoria de l’evolució explica el procés de transformació de les espècies a través de canvis genètics al llarg de generacions successives. Actualment, la teoria de l’evolució combina les propostes de Darwin i Wallace amb les lleis de Mendel i altres avenços genètics posteriors; per això es denomina síntesi evolutiva moderna o teoria sintètica de l’evolució.





Els organismes model
Els organismes model s’utilitzen per a facilitar l’estudi d’éssers vius de característiques semblants, rutes metabòliques, característiques genètiques, etc. Per exemple, els ratolins i les rates s’usen per a estudiar malalties humanes; el rent del pa, Saccharomyces cerevisiae, per a estudis de rutes metabòliques i del cicle cel·lular; un dels models d’estudis de genètica és la mosca de la fruita, Drosophila melanogaster.
Model de la doble hèlix
El model de la doble hèlix, proposat per Watson i Crick, per a explicar l’estructura de l’ADN.













13 EL MÈTODE CIENTÍFIC


La investigació al laboratori
El treball experimental es fa principalment al laboratori, on es controlen i es fixen les variables d’estudi.
2.1 El treball al laboratori
En tota investigació que es faça al laboratori és necessari aplicar els passos del mètode científic. Així, després del plantejament de la hipòtesi per a donar una resposta al nostre problema de partida, s’ha de fer el disseny de l’experiment. Aquest disseny experimental requerix les etapes següents:
- Determinar les variables. La variable d’estudi serà la que canviarà, mentre que la resta de variables es mantindran fixes.
- Establir experiments control, positius o negatius, dels quals es coneix el resultat, i amb els quals es pot comparar.
- Definir quines dades es prendran i triar l’equip o l’aparell adequats per a obtindre-les. Les dades són les observacions i les mesures que fem durant l’experiment. Les dades i les anotacions s’han de registrar en el quadern de laboratori.
A continuació, s’han d’analitzar els resultats obtinguts durant l’experimentació; per a això, sempre que siga possible, es representaran les dades en forma de taules o gràfics i es faran estudis estadístics. D’aquesta anàlisi es podran obtindre conclusions sobre si les dades recolzen la nostra hipòtesi de partida, si necessitem recopilar més dades o si hi ha hagut alguna errada en l’experiment. Finalment, el resultat de qualsevol treball s’ha de comunicar a la comunitat científica perquè el conega i el sotmeta a avaluació i a crítica. En general, se sol publicar un informe científic, encara que hi ha moltes altres formes de difondre les investigacions; per exemple, a través d’articles en revistes, conferències, etc. L’estructura d’un informe científic és la següent:
- Títol i índex. Definix el tema sobre el qual es fa l’informe i s’anomenen els apartats de què consta.
- Introducció. Presenta el treball, amb l’objectiu que perseguix.
- Disseny de la investigació. S’exposa el procediment o mètode seguit, els materials i els instruments utilitzats.
- Resultats, la seua anàlisi i les conclusions obtingudes.
- Bibliografia. Recull totes les fonts consultades per a fer el treball d’investigació.
2.2 Materials, instruments i aparells de laboratori
Al laboratori hi ha reactius, instruments i equips necessaris per a l’experimentació que, per la fragilitat i/o el perill que presenten, cal conéixer com es manegen i mantindre unes mesures de seguretat adequades. En les taules de les pàgines següents es mostren els materials i els instruments usats més habitualment durant la investigació al laboratori de biologia i geologia.
14
2
Alguns materials de laboratori
Recipients de vidre o de plàstic
S’usen per a contindre o mesclar compostos.
Són, per exemple, els vasos de precipitats, els matrassos Erlenmeyer, els embuts de decantació, els tubs d’assaig, les botelles o els flascons llavadors.


Matràs Erlenmeyer


Comptagotes

Flascó llavador
Material volumètric graduat
S’utilitza per a mesurar volums amb precisió. Pot ser de vidre o de plàstic.
Són, per exemple, les provetes, les pipetes, les buretes i els matrassos aforats.


Materials de microscòpia
Generalment de vidre, s’usen per a depositar, tenyir o cobrir les mostres, com ara portaobjectes, cobreobjectes, cristal·litzadors i cubetes de tinció. Les tincions es fan amb colorants, que varien segons el que es vol tenyir.
Material de microbiologia
Necessari per a cultivar microorganismes. Inclou les anses de sembra, les plaques de Petri, reactius per a preparar els medis de cultiu, etc.
Altres materials d’usos diversos
Per exemple, els suports, els motles per a tubs d’assaig, els vidres de rellotge, les varetes agitadores, les espàtules, les pinces, el bisturí, les agulles manegades, etc.
En tot laboratori d’investigació ha d’haver-hi contenidors especials on es depositen els residus que es generen després de l’experimentació (vidre, mostres biològiques, plàstics, etc.) i que permeten eliminar-los o reciclar-los de forma correcta.
Espàtula




Bisturí













Tubs d’assaig

Vas de precipitats













Provetes Matrassos aforats
Cubeta de tinció

Portaobjectes

Cobreobjectes


Cristal·litzador

Anses de sembra
Anou



Soport

Vidre de rellotge







Plaques de Petri





Motle per a tubs


Pipeta Pasteur

Pinça per a tubs d’assaig

Vareta agitadora
Reactius per a tinció Medis de cultiu



Morter


Contenidors de residus Agulla manegada






15 EL MÈTODE CIENTÍFIC
Bureta
2 La investigació al laboratori
Alguns instruments i aparells de laboratori
Instruments de mesura
Al laboratori, hi ha diferents instruments de mesura com les balances, els cronòmetres, els termòmetres, els baròmetres, els higròmetres, etc.

Instruments d’observació
Els que s’utilitzen més habitualment són les lupes binoculars i els microscopis òptics, que són instruments que permeten augmentar la imatge de l’objecte que s’estudia. Les lupes s’usen principalment per a observar detalls de plantes, insectes o minerals, i n’augmenten fins a 40 vegades la dimensió. Els microscopis disposen de diversos objectius que poden augmentar el poder de resolució fins a ampliar la imatge unes 1 000 vegades.




Instruments d’ús divers
A més dels esmentats, hi ha instruments i aparells d’usos molt diversos; per exemple, plaques calefactores i agitadors magnètics, bec de Bunsen, banys termostàtics, centrifugadores, estufes d’incubació, etc.


Centrifugadora




Placa calefactora i agitador magnètic Bany termostàtic











Microscopi òptic




Bec de Bunsen



Estufa d’incubació de cultius
16
Manòmetre
Cronòmetre
Termòmetre
Balança
Lupa binocular
2.3 Seguretat al laboratori
A l’hora de fer un experiment al laboratori, a més d’utilitzar els sistemes de seguretat que hi ha, és necessari adoptar una sèrie de normes de seguretat bàsiques.
Abans de començar
- Portar sempre la vestimenta i l’equip de protecció apropiats, és a dir, la bata cordada, guants i ulleres de seguretat i màscara si fora necessari.
- Llegir el guió abans de començar qualsevol experiment i assegurar-nos que entenem tot el que s’ha de fer.
- Informar-se d’on estan la farmaciola i l’extintor per si calguera utilitzar-los en cas d’accident.
- Si tenim els cabells llargs, s’han d’arreplegar a la part posterior del cap. A més, cal evitar els anells, les arracades llargues o els collars al laboratori; es poden enganxar i provocar accidents.
Durant l’experimentació
- Mantindre la taula de treball ordenada i neta. Deixar sobre la taula només el guió de l’experiència i el quadern per a anotacions.
- No fer experiments que no estiguen planificats ni tocar materials, instruments o aparells sense autorització.
- No córrer pel laboratori i evitar els desplaçaments innecessaris mentre es fa l’experiència.
- No menjar ni beure al laboratori i no utilitzar els recipients de laboratori per a beure aigua o altres líquids.
En acabar
- En acabar l’experiment, arreplegar el lloc de treball i netejar l’instrumental i la taula.
- Eliminar els residus depositant-los en els contenidors adequats.
- Llavar-se les mans amb aigua i sabó abans d’eixir del laboratori.
Equip de protecció individual
Qualsevol treball al laboratori s’ha de fer sempre amb l’equip de protecció individual. Aquest està format per la bata, guants de làtex, ulleres de protecció i màscara.















17 EL MÈTODE CIENTÍFIC
Bata
Ulleres
Guants


La investigació en la naturalesa
La investigació de l’entorn natural es duu a terme en el medi real, per la qual cosa serà difícil tindre un control de totes les variables que intervenen en l’estudi. Generalment, el treball de camp comença amb l’observació i l’arreplega de mostres o dades in situ, és a dir, sobre el terreny, i es complementa amb l’anàlisi d’aquestes dades al laboratori, on es poden fer assajos i simulacions per mitjà de models experimentals.
3.1 La planificació de l’eixida
Abans d’eixir a observar o arreplegar dades del medi natural, és important:
- Establir l’època de l’any en què es farà la investigació, ja que potser el fenomen o l’ésser viu que es pretén estudiar només es veja en un determinat moment de l’any.
- Localitzar i conéixer la zona en què es farà la investigació, les condicions del terreny, l’accessibilitat, i, si és necessari, sol·licitar permisos o autoritzacions.
- Decidir la quantitat i el tipus de dades que es prendran. En cas de dur a terme una presa de mostres, decidir si es farà de forma aleatòria (s’agafen mostres a l’atzar) o sistemàtica (es definixen zones al llarg d’un transsepte o es dividix una gran zona en seccions menors per a prendre una o diverses mostres de cada secció).
- Seleccionar el material i els instruments necessaris per a prendre les dades i les mostres (equip de detecció i observació, recipients per a mostres, etc.), i també la vestimenta i el calçat adequats.
3.2 L’observació in situ
Quan s’investiga l’entorn natural, es poden obtindre diferents tipus de dades:
- Dades qualitatives. Es registren a través de dibuixos, fotografies o simples anotacions, com, per exemple, les formes del relleu, el tipus de vegetació que predomina, la presència d’empremtes d’éssers vius, observacions del comportament de determinats organismes, etc.
- Dades quantitatives. Impliquen un recompte o una mesura de dades numèriques, com, per exemple, el recompte d’individus d’una espècie determinada a la zona, o mesures de temperatura, humitat o altres condicions ambientals, per a la qual cosa es necessitarà material específic (termòmetre, higròmetre, anemòmetre, etc.).
- Recol·lecció de mostres. No sempre la investigació de camp acaba amb la presa de dades; de vegades, és necessari prendre algunes mostres i completar l’estudi al laboratori. La presa de mostres s’ha de fer de forma sostenible, de manera que el medi s’altere el mínim possible, i respectant sempre la legislació. Sempre que siga possible, és millor arreplegar restes o parts abandonades, com fulles o plomes caigudes, nius vells, mudes o crisàlides, etc. En cas de necessitar sòl, arenes o roques, la zona no ha de quedar alterada després de l’arreplega. A més, les mostres s’han de guardar en recipients adequats que s’etiquetaran correctament.
18
3
3.3 El processament de les mostres
Moltes de les mostres obtingudes a la zona d’interés s’han de processar i analitzar al laboratori per mitjà d’assajos i tècniques per a poder completar la investigació. De vegades es tracta d’un simple recompte, per exemple, si s’han arreplegat mostres d’espècimens, o potser serà necessari netejar, filtrar, tamisar i, posteriorment, fer una anàlisi fisicoquímica del material mostrejat.
3.4 Simulacions al laboratori
Les dades obtingudes del medi poden servir per a fer simulacions al laboratori. Per a això, s’utilitzen models, que permeten reproduir un sistema real i dur a terme experiències, per a entendre i predir el seu funcionament. Per exemple, els models climàtics són fonamentals per a entendre les causes i els efectes del calfament global; d’aquesta manera es poden prendre les mesures adequades per a minimitzar els seus efectes.
Un exemple d’una investigació en la naturalesa
1 Establir el transsecte amb els punts d’arreplega d’arena.

Un exemple de model. Model climàtic

1. Precipitació-evaporació
2. Interacció atmosferabiosfera
3. Interacció atmosfera-sòl
4. Interacció atmosfera-gel
5. Interacció biosfera-sòl
6. Intercanvi de calor

7. Canvis en l’oceà: circulació, nivell de la mar...
8. Activitat volcànica
9. Activitats humanes
10. Canvis en la superfície terrestre
4 Processar les mostres al laboratori.
a. Les mostres s’assequen esteses a 50 °C. A continuació, es pesen.

b. Es passen per dos tamisos, un de 5 mm i l’altre d’1 mm.
2 Delimitar la grandària de les àrees d’arreplega i determinar la profunditat d’aquesta.









3 Prendre diferents mostres.

mm
mm



c. Se separen els microplàstics per flotació introduint l’arena en una dissolució de clorur sòdic.




d. Finalment, es filtra la part líquida i es deixa assecar la membrana de filtració a 50 °C.
e. Amb un microscopi, es fa un recompte de les micropartícules.

19 EL MÈTODE CIENTÍFIC
5
1
2 6 4 8 1 3 5 7 9 10
Equipament bàsic
3.5 L’equip per a la investigació de camp
Quan es vol fer una investigació en l’entorn natural, és necessari anar ben preparats tant des del punt de vista de la indumentària com del material per a dur a terme les investigacions.
Roba i calçat adequats. Per exemple, impermeable per a la pluja, i també un barret o gorra per al sol.
Motxilla lleugera, millor si és impermeable per a poder preservar-ne el contingut.
Farmaciola de primers auxilis amb benes, gases, esparadrap, desinfectants i medicaments per a picades d’insectes.
Telèfon mòbil carregat, que pot servir de càmera fotogràfica i ens permetrà estar localitzats o poder comunicar-nos amb serveis d’emergència.



Instruments d’observació
Prismàtics. Necessaris per a observar la fauna. Han de ser lleugers, ja que el temps d’observació pot ser prolongat.
Càmera fotogràfica. Permetrà captar les característiques del paisatge, de la vegetació, registrar empremtes i rastres d’animals. En les fotografies és important col·locar un objecte que servisca com a referència de grandària, com ara una moneda o un bolígraf.
Lupa plegable, molt útil per a observar detalls xicotets en plantes, roques i rastres d’animals.
Telescopi terrestre i trípode, que s’instal·len en llocs apropiats per a l’observació d’animals, com, per exemple, posadors d’aus.











Altres materials
D’orientació: mapa de la zona (mapa imprés en paper, GPS o un mapa dibuixat prèviament) i brúixola.
D’arreplega de mostres: bosses, pots, caixes o altres recipients i etiquetes amb codis per a identificar les mostres. També pot fer falta una navaixa multiús.
De consulta i presa de dades, com, per exemple, guies d’identificació d’espècimens, llibreta o quadern de camp i llapis per a dibuixar i fer anotacions sobre les observacions.





























20 3 La investigació en la naturalesa
Mòbil
Motxilla
Roba i calçat adequats
Farmaciola
Prismàtics
Lupa
Telescopi
Càmera fotogràfica
GPS
Mapa
Brúixola
Quadern
Bosses
Navaixa multiús
3.6 Normes de comportament en el medi natural
Quan es fa una investigació al camp, s’han de complir unes normes de comportament i seguir alguns consells per a reduir l’impacte que la nostra presència puga causar en l’entorn.
Algunes de les recomanacions més importants són les següents:
- Planificar bé l’activitat que es vol fer.
- Portar la indumentària i el material apropiats a l’objectiu de l’eixida al camp.
- Evitar anar sols i, si es fera així, comunicar el recorregut que es pretén fer i l’hora de tornada.
- Caminar sempre per les sendes indicades. No s’han d’obrir camins nous perquè poden donar lloc a processos d’erosió i a xafar plantes xicotetes, ous o insectes amb funcions fonamentals en l’ecosistema en qüestió.
- Respectar sempre les propietats privades i les activitats de les persones que treballen en l’agricultura i en la ramaderia.
- Evitar produir sorolls o usar ràdios o aparells el volum dels quals moleste els animals que habiten en l’entorn. Cal passar inadvertits.
- No deixar fem al camp, ni tan sols l’orgànic. Portar sempre una bossa buida per a ficar-hi les deixalles que es generen i depositar-la en els contenidors adequats.
- No tallar ni arrancar les plantes, les branques dels arbres, etc. No agafar animals, roques, etc.
- No donar menjar als animals de l’entorn, ja que això en canvia el comportament i les pautes alimentàries.
- No encendre foc al camp. Els incendis són devastadors per a la vida silvestre en qualsevol època de l’any.
- Evitar portar objectes o envasos de vidre; el vidre pot provocar l’efecte lupa i convertir en foc els rajos del sol.
- No banyar-se en els llacs i llacunes; són ecosistemes molt delicats i es poden veure alterats per la presència de les persones.
- Prescindir dels productes químics en la naturalesa, com els detergents o els sabons.
- Deixar-ho tot com estava i avisar les autoritats si hi ha algun desperfecte o algun animal en perill.
• Isc a investigar, però sense molestar. sc investigar
• El camp he deixat, com l’he trobat. deixat


• Amb el medi soc acurat i porte el material adequat.
• Si ixes a companyiainvestigar, has de portar. es investigar, investigar
• En caminar, sigues elegant; no vages com un elefant. , el
• No llances deixalles mai. En el comportament ves a espai!





Treballa amb la imatge Pensa en altres eslògans per a la resta de normes de comportament en el medi natural.



EL MÈTODE CIENTÍFIC


Recerca d’informació

Així és un article científic
Una part essencial del treball científic es basa en coneixements previs aportats pels científics i les científiques de tot el món. Per això, resulta fonamental revisar de forma constant la informació aportada per altres grups d’investigació que fan estudis sobre el mateix tema i que, al seu torn, comuniquen els resultats de les seues investigacions perquè les coneguen altres científics i científiques del món. D’aquesta manera, es genera el coneixement científic, en un procés cooperatiu i d’intercanvi constant d’informació.
Les descobertes i els avenços científics queden reflectits en les fonts d’informació científiques, que poden ser primàries, secundàries i terciàries.







4.1 Fonts d’informació primàries
Les fonts d’informació primàries contenen informació original. Es corresponen amb publicacions en què els investigadors comuniquen les seues descobertes per primera vegada.
Articles científics



Constituïxen la font d’informació científica més important. Aquests articles es publiquen en revistes científiques, que estan especialitzades en una àrea d’investigació, com per exemple la bioquímica. Els articles científics utilitzen un llenguatge molt tècnic i s’hi fa una descripció molt precisa del treball que s’exposa, ja que estan dirigits a experts en la matèria. S’estructuren sempre en els mateixos apartats: introducció, materials i mètodes, resultats, discussió i bibliografia.







Comunicacions a congressos
























Els congressos són reunions de científiques i científics d’un camp concret d’investigació, com, per exemple, la virologia. L’objectiu d’aquestes reunions és l’intercanvi d’informació i la interacció i la discussió activa entre les persones dedicades a investigar. En aquestes trobades s’exposen els últims avenços, bé de forma oral, en una conferència, o bé exposant un cartell.
Patents



Són documents que mostren una novetat tecnològica o invenció alhora que protegixen legalment l’inventor o la inventora perquè obtinga benefici econòmic de la invenció en qüestió.
4.2 Fonts d’informació secundàries





L’objectiu d’aquestes fonts d’informació secundàries és facilitar l’accés a la informació primària. Per a això, arrepleguen la informació, l’organitzen i l’estructuren, per tal que la consulta siga més ràpida i senzilla. Les més importants són les bases de dades, que faciliten l’accés a la informació en les fonts primàries. Hi ha diverses bases de dades en les quals es pot buscar informació, per exemple, Google Scholar (o Google Acadèmic), que és una base d’accés gratuït a la informació sobre nombroses àrees de coneixement; Medline, una base de dades que aglutina la majoria de les publicacions en revistes científiques.
4
AUTORS
TÍTOL
I AUTORES
4.3 Fonts d’informació terciàries
Les fonts d’informació terciàries recopilen la informació més rellevant sobre diferents temes. Les redacten especialistes en el tema, basant-se en fonts primàries i secundàries d’informació. Són els llibres, les enciclopèdies, etc.
Llibres científics
Aquests documents solen utilitzar un llenguatge molt tècnic i recullen la informació més important sobre un tema científic concret.
Enciclopèdies
Una enciclopèdia és un treball d’investigació científica o tècnica dissenyat i redactat per un nombrós grup d’especialistes destacats. Comprén diferents disciplines científiques: medicina, botànica, zoologia, ciències de la salut.
Guies
Les guies són llibres amb imatges i descripcions d’éssers vius, minerals, fòssils, rastres o roques que es poden trobar regularment en una regió determinada. L’objectiu que tenen és ajudar en la identificació apropiada d’una espècie o d’un tipus de roca.
Com fer una recerca d’informació




L’anglés és l’idioma científic per excel·lència.


Escriu les paraules, sinònims i abreviatures.





Per a recerques molt generals, utilitza un cercador conegut (Google, Bing, etc.). Fes recerques específiques, per exemple, amb Google Scholar.





«AND» per a cercar documents que incorporen dos o més termes simultàniament.
«NO/NOT» per a eliminar documents que continguen algun terme.
«O/OR» per a cercar documents que contenen un terme o un altre.















Llig el títol i el resum dels documents per a tol i el resum dels documents per a quedar-te amb els més importants. Contrasta la informació obtinguda en diferents fonts.


No oblides anotar cada una de les fonts d’informació per a després citar-les.
23 EL MÈTODE CIENTÍFIC
TRIMESTRE 1



























PRESENTACIÓ DE LA SITUACIÓ

Què has portat per a l’esplai?













Cremant calories


Elaborem un Nutriscore propi
Unitat 1 Unitat 2














Superxefs: dissenyant una dieta saludable


Què passa amb els aliments dins del teu cos?
Unitat 3
2 FAM ZERO
SALUT BENESTAR 9 INDÚSTRIA, INNOVACIÓ I INFRAESTRUCTURA
3



SUPERXEFS


Ajudants en el procés de nutrició






Organitzem la informació en una infografia en forma de tríptic


Presentem i repartim el tríptic final




Recollida de dades i anàlisi d’impacte











1L’organització de l’ésser humà
ADA YONATH.
Curiosa per naturalesa
Per a fer ciència, allò essencial és tindre curiositat. Per tot. I creu-me, jo n’he tingut sempre de sobra. Quan tenia cinc anys, vaig intentar determinar l’alçària del nostre pis i em vaig trencar un braç en el procés. De veritat.
El meu nom és Ada Yonath i soc originària d’Israel. Vaig nàixer a la ciutat de Jerusalem, en 1939. En la meua família mai van sobrar els diners. Mon pare va morir quan jo era una xiqueta i vaig haver de fer de tot per a poder estudiar: feia classes particulars de matemàtiques, cuidava xiquets i xiquetes, netejava el laboratori de química... Tot allò era cansat, però em va donar l’oportunitat d’aprendre i de desenvolupar les meues investigacions d’amagat, de manera que no em queixe.
Començar la meua carrera com a investigadora va ser meravellós. De sobte em pagaven per fer preguntes i buscar respostes! Em vaig interessar especialment per una cosa que aleshores pareixia impossible: descobrir com són i com funcionen els ribosomes. Aquestes
màquines moleculars tan xicotetes s’encarreguen de descodificar les instruccions de l’ADN de les cèl·lules i usar-les per a construir proteïnes. Però, com era la seua estructura exactament? No en teníem ni idea.
Jo soc especialista en una tècnica que consistix a crear cristalls i observar-los usant raigs X. El problema era que els que féiem amb ribosomes es trencaven amb molta facilitat. Vam passar anys destrossant cristalls fins que, per una combinació de sort i experiència, vam desenvolupar la manera de fabricar cristalls de ribosomes que tenien un aguant suficient que ens permetia observar, per fi, els detalls de la seua estructura.
Aquesta descoberta em va valdre, entre altres premis, el Nobel de Química en 2008. La veritat és que no m’importen massa els premis. El que realment m’enorgullix és que la meua descoberta es pot utilitzar per a atacar els ribosomes dels bacteris i desenvolupar antibiòtics nous amb els quals es pot continuar guanyant la batalla a les infeccions.
26 26

Què descobriràs?
En aquesta unitat
• Ada Yonath. Curiosa per naturalesa
1. Els nivells d’organització
2. La cèl·lula humana
3. La diferenciació cel·lular
4. Els teixits humans
5. Òrgans, aparells i sistemes
• Comprén, reflexiona i posa a prova les teues competències
En anayaeducacion.es
Per a motivar
• Vídeo: Abans de començar
• Coneix més...
… Ada Yonath
Per a detectar idees prèvies
• Presentació: Què necessites saber
Per a exposar
• Presentació:
Les cèl·lules procariotes i eucariotes
L’observació de les cèl·lules
• Vídeos: La grandària de les cèl·lules
Per a exercitar
• Activitats interactives: Aprén jugant
Posa’t a prova
• Taller de ciències: Observa cèl·lules de la mucosa
I, a més, tota la documentació necessària per a aplicar les claus del projecte.


































SEQÜÈNCIA D’APRENENTATGE + anayaeducacion.es












1.1 1.2 2.1 2.2

Els nivells d’organització
Les biomolècules formen els éssers vius
Els glúcids
Són la principal font d’energia de la cèllula. Formen part d’algunes estructures cel·lulars i servixen per a construir altres biomolècules.
Poden ser complexos com la cel·lulosa, que forma les parets de les cèl·lules vegetals; o senzills, com la glucosa.
Els lípids
Els lípids són substàncies de naturalesa química molt diversa. Alguns, com els fosfolípids i el colesterol, formen part de les membranes cel·lulars; d’altres, com els triglicèrids, són una font d’energia i d’emmagatzematge energètic per a la cèl·lula, etc.
Les proteïnes
Formen part de les estructures de la cèl·lula i duen a terme la regulació i l’execució de la majoria dels processos cel·lulars; per exemple, l’hemoglobina dels glòbuls rojos transporta l’oxigen en la sang; les proteïnes de membrana regulen l’intercanvi de substàncies entre l’interior i l’exterior de les cèl·lules, etc.
Els àcids nucleics
Contenen la informació genètica, que transmeten a la descendència, i controlen les funcions cel·lulars. Són l’ADN (àcid desoxiribonucleic) i l’ARN (àcid ribonucleic).
COMPRÉN, PENSA, INVESTIGA...


L’ésser humà està format per matèria que presenta distints graus de complexitat, denominats nivells d’organització. N’hi ha de més senzills i de més complexos.
Es denominen nivells d’organització cada un dels graus de complexitat en què s’organitza la matèria viva.
Els elements de cada nivell s’agrupen per a formar altres nivells més complexos, amb característiques i propietats noves que van més enllà de la simple agrupació dels elements del nivell anterior.
1.1 El nivell atòmic



Els àtoms són les partícules més menudes en què es pot dividir la matèria, conservant les propietats que té. Són àtoms l’hidrogen (H), l’oxigen (O) o el calci (Ca). Els àtoms que formen part de la matèria viva es denominen bioelements.
1.2 El nivell molecular







1 Definix amb les teues paraules bioelement, biomolècula i enllaç químic
2 Explica què és un polímer i proposa exemples de biomolècules que ho siguen.
Les molècules són agrupacions d’àtoms, units per enllaços químics. Són molècules l’aigua (H2O), l’oxigen (O2) o el carbonat càlcic (CaCO3). Les molècules que formen part dels éssers vius es denominen biomolècules, i tenen un contingut elevat de carboni. Les biomolècules s’agrupen per a realitzar una funció dins de la cèl·lula. Formen els orgànuls com els ribosomes o els mitocondris. Aquestes biomolècules solen ser polímers; és a dir, cadenes formades per la unió d’unes quantes molècules d’un mateix tipus anomenades monòmers. Són els hidrats de carboni o sucres, els lípids, les proteïnes i els àcids nucleics (com l’àcid desoxiribonucleic o ADN).
D’altres substàncies, com l’aigua i les sals minerals, tenen una estructura química senzilla. Aquestes es troben tant en la matèria viva com en la no viva.
3 Indica, dels compostos següents, els que són exclusius de la matèria viva.
Fosfolípids
Glucosa Ferro
Clorur de sodi Potassi Aigua
ADN
Cel·lulosa
28
1
1.3 Nivell celular
Les cèl·lules són la unitat estructural i funcional de tot ésser viu; és a dir, la part més xicoteta capaç de realitzar les tres funcions vitals.
Totes les cèl·lules humanes són eucariotes de tipus animal, encara que s’especialitzen en més de dos-cents tipus. Són cèl·lules les neurones, els glòbuls rojos, els adipòcits, els òvuls, els espermatozoides, etc.
1.4 Nivell organisme
Els teixits són associacions de cèl·lules semblants especialitzades en la mateixa funció, acompanyades, de vegades, d’altres substàncies. Exemples de teixits són: el teixit nerviós, el muscular o l’epitelial. Els teixits s’agrupen i formen òrgans, que realitzen una funció concreta; alguns exemples d’òrgans són el cor, els pulmons o els renyons.
Al seu torn, el conjunt d’òrgans que realitzen una funció comuna constituïxen els aparells i sistemes. Alguns exemples en són l’aparell respiratori, l’excretor o el nerviós.
Finalment, el cos humà està constituït pel conjunt d’òrgans, aparells i sistemes que funcionen de forma coordinada per a realitzar les tres funcions vitals.



Els nivells d’organització
A quin nivell d’organització del cos humà corresponen els exemples o agrupacions següents?
a) Òvul.
b) Cor.
c) Conjunt format per la boca, l’esòfag, l’estómac, l’intestí, el pàncrees, etc.
d) Proteïna.
e) Nucli.
f) Carboni.



































s’unixen formant com que s’agrupen formant que s’agrupen formant que s’agrupen formant que s’agrupen formant


































29 U 1

La cèl·lula humana
Estructura de la cèl·lula eucariota animal
Citoplasma




Membrana plasmàtica





Orgànuls cel·lulars
Membrana cel·lular Exterior
Glúcids
L’ésser humà és un organisme pluricel·lular, format per cèl·lules, molt diferents entre si en forma i grandària, que generalment presenten tres components fonamentals: la membrana plasmàtica, el nucli i el citoplasma.
2.1 La membrana plasmàtica

La membrana plasmàtica és una capa fina que embolcalla la cèl·lula, la protegix i regula l’intercanvi de substàncies amb el medi que l’envolta.

La membrana plasmàtica està composta per lípids, que formen una capa que embolcalla la cèl·lula i en la qual s’inserixen proteïnes. Les funcions de la membrana són:
- Protegir la cèl·lula i separar-ne el contingut de l’exterior.
- Detectar els canvis que es produïxen en el medi i permetre que la cèl·lula hi responga de forma adequada.
- Regular l’intercanvi de substàncies amb el medi. El transport de substàncies a través de la membrana plasmàtica té lloc per mitjà de diferents mecanismes, segons la seua dimensió. Per exemple, substàncies xicotetes com l’oxigen poden travessar la membrana per si soles; les substàncies de grandària mitjana travessen la membrana ajudades per les proteïnes; les substàncies més grans no poden travessar-la, per la qual cosa el pas a l’interior cellular es realitza per endocitosi, que consistix en un afonament de la membrana que engloba la partícula que s’incorporarà.












Proteïnes

Lípids
COMPRÉN, PENSA, INVESTIGA...
1 Definix cèl·lula
2 Explica les funcions que exercix la membrana plasmàtica.

3 Encara que allò més comú és representar les cèl·lules animals amb formes arredonides, la morfologia de les cèl·lules del nostre cos és molt diversa. Busca imatges de diferents tipus de cèl·lules del cos humà i dibuixa-les en el quadern. Senyala-hi les tres estructures comunes: la membrana plasmàtica, el nucli i el citoplasma.
30 2
Interior
Nucli
2.2 El nucli
El nucli és una estructura gran i esfèrica que conté el material genètic (ADN), que dirigix l’activitat de la cèl·lula.
El nucli es compon de les parts següents:
- La membrana nuclear està travessada pels porus nuclears, que permeten l’intercanvi de substàncies entre el nucli i el citoplasma.
- El nucleoplasma està format per un líquid aquós, que conté el material genètic o ADN.
- La cromatina és el conjunt de totes les fibres d’ADN i proteïnes. Quan la cèl·lula està a punt de dividir-se, les fibres de cromatina s’enrotllen i es compacten, i formen unes estructures, visibles al microscopi, denominades cromosomes.
- El nuclèol és una zona esfèrica del nucli on es fabriquen els components d’uns orgànuls cel·lulars anomenats ribosomes.




Els cromosomes (es formen per condensació de la cromatina quan les cèl·lules van a dividir-se).


COMPRÉN, PENSA, INVESTIGA...

4 anayaeducacion.es No totes les cèl·lules són iguals, ni tenen la mateixa organització cel·lular. Recorda els tipus d’organització cel·lular dels éssers vius visualitzant la presentació «Les cèl·lules procariotes i eucariotes», disponible en el banc de recursos, i digues quin tipus d’organització tenen les cèl·lules següents.
a) Un protozou. d) Un insecte.
b) Un fong. e) Un bacteri.
c) Una alga. f) Un pi.
5 Dibuixa el nucli d’una cèl·lula en el quadern, escriu els noms dels seus components i les funcions que exercixen.
6 En quins dos estats pot estar el nucli des d’un punt de vista estructural?
7 Com ja saps, les cèl·lules tenen una grandària microscòpica. Per a mesurar-les, s’utilitza una unitat anomenada micròmetre o micró (μm).
1 = 0,001 mm = 0,000 001 m
a) Utilitza el cursor per a calcular el diàmetre de la cèl·lula. Quants micròmetres fa?
b) Identifica el nucli d’aquesta cèl·lula i indica quant mesura de diàmetre.
c) Com que la cèl·lula de la imatge té forma arredonida, en podem calcular el volum com el d’una esfera. Quin volum té? I el nucli?




31 U 1
Així és el nucli de la cèl·lula
5 μm
Membrana nuclear
Porus nuclears
Cromatina Nuclèol
Interpreta una imatge de microscòpia






Observa la fotografia de la cèllula i indica quina estructura cellular s’observa tenyida de color verd. Descriu el que veus en la fotografia.
2.3 El citoplasma
El citoplasma és la part de la cèl·lula continguda entre la membrana plasmàtica i la membrana nuclear.
El citoplasma està format per un líquid aquós denominat citosol, que conté substàncies i orgànuls cel·lulars.
El citosol està compost per un 70-80 % d’aigua i un 20-30 % d’altres substàncies dissoltes o en suspensió, com proteïnes, glúcids, lípids, àcids nucleics, sals minerals i ions. S’hi produïxen moltes de les reaccions químiques vitals per a la cèl·lula.
2.4 Els orgànuls cel·lulars
Els orgànuls cel·lulars són estructures immerses en l’interior del citoplasma i que realitzen funcions específiques a manera d’«òrgans».
Els orgànuls poden ser de dos tipus: els no membranosos i els membranosos.
Els orgànuls no membranosos

Els centríols són dos cilindres compostos de fibres que dirigixen el moviment del citosquelet i dels cromosomes durant la divisió de la cèl·lula.




Els ribosomes són partícules xicotetes encarregades de sintetitzar les proteïnes. Poden estar adherits al reticle endoplasmàtic o dispersos pel citoplasma.

El citoesquelet és una xarxa de fibres que sosté els orgànuls i dona forma a la cèl·lula. També intervé en els moviments cel·lulars (constituïx els cilis i els flagels).
32 La cèl·lula humana 2
Els orgànuls membranosos
Els mitocondris són estructures ovalades de membrana doble, amb nombrosos replecs a la membrana interna. Obtenen energia per a la cèl·lula per mitjà del procés de respiració cel·lular.

El reticle endoplasmàtic (RE) és un conjunt de canals i sàculs que sintetitzen substàncies. El RE rugós, que té ribosomes adherits a la paret, participa en la síntesi de proteïnes. El RE llis, sense ribosomes, intervé en la síntesi de lípids.
L’aparell de Golgi és un conjunt de sàculs aplanats que modifiquen les substàncies sintetitzades en el RE i les transporten en vesícules a l’exterior cel·lular.
Les vesícules són compartiments diminuts que transporten o emmagatzemen substàncies.


1 Observa amb atenció les microfotografies de la dreta i respon les preguntes.
a) Són cèl·lules aïllades o es tracta de l’interior d’una cèl·lula? Explica-ho.
b) Utilitza el cursor (línia roja) que apareix en la micrografia per a calcular la grandària de l’orgànul A.
c) Fes un dibuix en el quadern en què representes com creus que pot ser aquest orgànul en 3D. Calcula’n el volum.
2 Els mitocondris són els principals productors de molècules energètiques de la cèl·lula. Cada un per si sol produïx poca energia, però molts mitocondris junts poden subministrar energia per a fer funcionar tot el cos humà. Sabent que fan falta al voltant de 1,5 · 1017 mitocondris per a produir 1 kWh d’energia, calcula quants mitocondris necessitaries per a:
a) Carregar el mòbil.
b) Posar una llavadora.
c) Jugar durant una hora en la teua videoconsola favorita.
Els lisosomes són vesícules en què es digerixen partícules capturades per la cèl·lula, gràcies als enzims digestius que contenen.










33 U 1
0,5 μm
B
A

La diferenciació
cel·lular
Dissenya una cèl·lula
Pensa en una funció, real o inventada, que poguera desenvolupar una cèl·lula en el cos humà i dissenya una cèl·lula que poguera complir aquesta funció. Has de dibuixar la cèl·lula, explicar la funció i quines característiques estructurals té que li permeten complir aquesta funció. Per a això, tin en compte els consells següents:
• Considera quins orgànuls hauria de tindre per a complir amb la seua funció.
• Dibuixa una forma que tinga relació amb la funció que desenvoluparà la cèl·lula. Busca informació sobre funcions i formes cel·lulars si necessites inspiració.
• Pensa si la cèl·lula funciona de forma lliure o connectada amb unes altres cèl·lules per a formar un teixit; si és així, com es connecten les unes amb les altres?
La diferenciació cel·lular
La diferenciació és un conjunt de canvis en la forma i en l’estructura de la cèl·lula que li permet especialitzar-se en una funció determinada.
Les cèl·lules d’un organisme pluricel·lular, com l’ésser humà, es creen a partir d’una primera cèl·lula anomenada zigot, que es dividix per a formar un embrió.
Al principi, totes les cèl·lules de l’embrió són iguals, però després adquirixen formes diferents i funcions específiques; és a dir, s’especialitzen. Aquest procés s’anomena diferenciació cel·lular.
Així, encara que totes les cèl·lules de l’ésser humà compartixen unes característiques bàsiques (per exemple, tenen el mateix material genètic), no totes tenen la mateixa forma ni realitzen les mateixes funcions.
Una vegada diferenciades, les cèl·lules que realitzen la mateixa funció i tenen un aspecte semblant s’agrupen en l’organisme pluricel·lular per a formar teixits. Per exemple, les neurones tenen un aspecte estrelat amb prolongacions del citoplasma que faciliten la recepció dels estímuls i la transmissió de l’impuls nerviós, i formen el teixit nerviós.
Diferenciació cel·lular

Cèl·lula mare




34 3
Fibres musculars
Glòbuls rojos
Neurona
Astròcit

Els teixits humans
COMPRÉN, PENSA, INVESTIGA...
1 Definix teixit
2 Quin teixit forma part de les glàndules sudorípares?
3 Observa la fotografia i digues quin tipus de teixit epitelial hi observes.



Tipus de teixits epitelials
Un teixit és un grup de cèl·lules, de forma i estructura semblant, especialitzades a realitzar la mateixa funció.
Els teixits humans es classifiquen en quatre tipus bàsics: epitelial, connectiu, muscular i nerviós.
4.1 Teixit epitelial
Els teixits epitelials (o epitelis) estàn formats per una o per unes quantes capes de cèl·lules molt pròximes entre si
Els teixits epitelials recobrixen els òrgans i actuen com a barreres protectores. Els teixits epitelials poden ser de dos tipus:
- Epiteli de revestiment. Té una funció protectora, ja que recobrix tant les superfícies externes com les internes dels òrgans. Per exemple, els epitelis que entapissen les cavitats internes que comuniquen amb l’exterior.
- Epiteli glandular. Estan formats per cèl·lules especialitzades a produir i secretar substàncies sobre la superfície epitelial. Aquestes cèl·lules poden estar disperses o formar glàndules. Per exemple, les glàndules sebàcies.
Epitelis simples


Cèl·lules escatoses


Cèl·lules cúbiques
Epitelis estratificats


Cèl·lules prismàtiques
Epiteli glandular




Substàncies secretades
35 U 1 4
4.2 Teixit connectiu
Tipus de teixits connectius
Teixit conjuntiu


Fibres
Cèl·lules envoltades de fibres abundants.
Teixit adipós
Cèl·lules grasses o adipòcits amb poca substància intercel·lular.
Teixit cartilaginós

Els teixits connectius estan formats per cèl·lules que estan envoltades per una substància intercel·lular i per fibres anomenades «matriu».
Els teixits connectius actuen de suport i unió per als òrgans i altres teixits del cos. N’hi ha de diferents tipus:
- Teixit conjuntiu. Conté una matriu gelatinosa abundant en què hi ha nombroses fibres. Ompli l’espai que hi ha entre els òrgans mantenint-los en el seu lloc, i forma els tendons.
- Teixit adipós. Té una matriu amb poca substància intercel·lular. Les seues cèl·lules emmagatzemen greix com a reserva energètica i aïllant tèrmic. Es troba davall de la pell.
- Teixit cartilaginós, la matriu del qual és sòlida i elàstica. Recobrix les articulacions per a evitar el desgast i forma, per exemple, el cartílag de l’orella.
- Teixit ossi, la matriu del qual és sòlida i rígida per la presència de sals de calci. Forma els ossos.

Matriu sòlida i elàstica

Cèl·lules òssies o osteòcits envoltats d’una matriu sòlida.
Teixit sanguini

Condròcits
Teixit ossi

- Teixit sanguini, que té una matriu líquida que es denomina plasma. S’hi troben en suspensió les cèl·lules sanguínies (els glòbuls rojos, els glòbuls blancs i les plaquetes).
COMPRÉN, PENSA, INVESTIGA...
4 Explica quin tipus de teixit connectiu s’observa en cada una de les imatges següents.




Plasma sanguini
Glòbuls blancs
Glòbuls rojos
Plaquetes


36
Els teixits humans 4
4.3 Teixit muscular
El teixit muscular està format per cèl·lules amb forma allargada, que s’agrupen formant les fibres musculars, i que tenen la capacitat de contraure’s i de relaxar-se. És responsable del moviment del cos.
Hi ha tres tipus de teixit muscular:
- Teixit muscular estriat esquelètic. Constituïx els músculs de l’aparell locomotor i en permet el moviment voluntari. Les cèl·lules que conformen aquest teixit tenen diversos nuclis.
- Teixit muscular estriat cardíac. És el que forma les parets del cor. És un teixit semblant a l’anterior, però les seues cèl·lules tenen només un nucli i la seua contracció és involuntària.
- Teixit muscular llis. Es troba a les parets de distints òrgans com l’estómac o la bufeta. La seua contracció és involuntària. Les cèl·lules que el formen tenen només un nucli.
4.4 Teixit nerviós
El teixit nerviós és el principal component de totes les estructures que formen el sistema nerviós.
Està format per les neurones, unes cèl·lules amb forma d’estrela especialitzades a arreplegar i transmetre la informació, junt amb les cèl·lules de glia, que s’encarreguen de la seua nutrició, defensa i suport.
Teixit nerviós
Tipus de teixits musculars
Teixit muscular estriat esquelètic

Fibra muscular plurinucleada.
Teixit muscular estriat cardíac

Fibres musculars semblants al muscular estriat, però amb un sol nucli.
Teixit muscular llis

Cèl·lules musculars amb un sol nucli.
1 L’espill. Consulta en anayaeducacion.es com aplicar aquesta clau de pensament i elabora una taula per a comparar els diferents tipus de teixits musculars.





















2 Compara el teixit de la imatge següent amb els esquemes que has estudiat en aquestes pàgines i digues de quin tipus de teixit es tracta. Justifica la resposta.


Cèl·lules de glia







37 U 1
Neurona

Òrgans, aparells i sistemes
COMPRÉN, PENSA, INVESTIGA...

1 Trencaclosques. Formeu grups a classe i repartiu-vos els temes que heu d’investigar. Cada grup investigarà un òrgan concret (cervell, cor, estómac, intestí prim, etc.) sobre els aspectes següents:
a) Quina funció exercix?
b) Quins teixits el formen?
c) Com són les cèl·lules d’aquests teixits?
Com acabes de veure, les cèl·lules d’un mateix tipus s’organitzen formant teixits. Al seu torn, els diferents teixits s’organitzen en estructures més complexes, denominades òrgans, que formen conjunts coordinats anomenats aparells i sistemes.
5.1 Els òrgans
Els òrgans del cos humà estan formats per diversos teixits que funcionen de forma coordinada per a realitzar una funció concreta.
Per exemple, el cor bomba sang, el renyó la neteja, els pulmons intercanvien gasos...
5.2 Els aparells i els sistemes
Els aparells i els sistemes són agrupacions d’òrgans que col·laboren de forma coordinada per a realitzar una activitat comuna.
El funcionament conjunt dels diferents aparells i sistemes contribuïx que l’organisme duga a terme les funcions vitals (nutrició, relació i reproducció).



































































































38
5
5.3 El medi intern
Una característica dels organismes pluricel·lulars, com l’ésser humà, és que la major part de les seues cèl·lules no estan en contacte directe amb el medi extern i no hi poden intercanviar substàncies (gasos, nutrients, rebutjos...), com fan les dels organismes unicel·lulars. Per a solucionar-ho, han desenvolupat un medi intern.
El medi intern és el líquid que banya totes les seues cèl·lules i que entra en contacte amb l’exterior a través de la sang. Les cèl·lules prenen d’aquest medi els nutrients i l’oxigen que necessiten, i hi aboquen els rebutjos que produïxen.
L’homeòstasi
L’homeòstasi és el conjunt de processos fisiològics que mantenen estables les característiques del medi intern.
Aquest equilibri s’aconseguix gràcies a l’acció dels distints òrgans, sistemes i aparells de l’organisme. Aquest procés de regulació evita alteracions del medi intern que resultarien fatals per a les cèl·lules.
Medi extern
Aliments


COMPRÉN, PENSA, INVESTIGA...
2 Indica quina de les funcions següents realitza el medi intern.
a) Actua de vehicle per a l’intercanvi de substàncies.
b) Servix d’aïllant tèrmic.
c) Servix de protecció a les cèl·lules que envolta.

3 Què passaria si…? Explica què passaria al nostre organisme si no existira el medi intern. Per a conéixer com aplicar aquesta tècnica, consulta la informació corresponent en anayaeducacion.es
L’homeòstasi
Observa la imatge, on s’esquematitza el funcionament del medi intern. Basant-te en el que es representa en la il·lustració, elabora un text explicant com es produïx l’intercanvi dels aliments, l’oxigen, el diòxid de carboni i els rebutjos entre el medi intern i l’extern.
39 U 1
Cèl·lules dels teixits
Rebutjos
Nutrients
Oxigen (O2)
Diòxid de carboni (CO2)
Orina i suor
ORGANISME











COMPRÉN



Organitza les idees

1 Cadena de seqüències. Copia i completa en el quadern aquesta cadena de seqüències sobre els nivells d’organització de la matèria viva. Aprén a utilitzar aquest organitzador gràfic en anayaeducacion.es
Nivell atòmic
Els àtoms són ? com ?
Els bioelements són ?
Nivell organisme
El cos humà és ?
Els aparells i sistemes són ? com ?
Els òrgans són ? com ?
Els teixits són ? com ?
Nivell cel·lular
Les cèl·lules són ?
S’agrupen unint-se per mitjà d’enllaços químics
Nivell molecular
Les molècules són ? com ?
Les biomolècules són ?
S’agrupen formant orgànuls cel·lulars com ?
S’agrupen per a realitzar funcions
Les cèl·lules humanes són ? com ?
Fes un resum
2 Elabora el teu resum de la unitat seguint aquest guió:
• Diferencia els nivells d’organització atòmic i molecular, definint bioelement i biomolècula
• Definix cèl·lula i explica els nivells superiors en què s’organitza.
• Explica la composició i les funcions de la membrana cel·lular.
• Enumera els components del nucli cel·lular explicant la funció que tenen.
• Elabora una llista amb els orgànuls membranosos i els no membranosos, diferencia’ls i digues la funció principal de cada un.
• Explica en què consistix la diferenciació cel·lular.
• Anomena els diferents teixits humans amb les característiques principals de cada un.
• Anomena els diferents aparells i sistemes que formen el cos humà i la funció en què participen.






Interpreta imatges








3 Copia aquest dibuix i indica a quines estructures cel·lulars corresponen els nombres. Indica la funció de cada una.


4 i respon les qüestions.






a) De quins teixits i cèl·lules es tracta?
2


b) Quina és la funció de cada un d’aquests teixits?
c) Quines característiques de cada una de les cèllules les fa idònies per a la funció que exercixen al cos humà?
5 Quina estructura cel·lular observes en la imatge següent? Quina composició té? A quin nivell d’organització de la matèria viva correspon?


1
7
6 4 8
5 3
9

Recorda seleccionar el material de treball d’aquesta unitat per al dossier d’aprenentatge.

Aplica
6 Indica a quin nivell d’organització del cos humà corresponen: calci; renyó; nucli; conjunt format per la boca, l’esòfag, l’estómac, l’intestí, el pàncrees, etc.; espermatozoide; proteïna.
7 Establix les diferències entre:
a) Nucli i nuclèol.
b) Cromatina i cromosoma.
c) Nuclèol i nucleoplasma.
8 Elabora una taula sobre els orgànuls cel·lulars, indicant la forma de l’orgànul, acompanyada d’un dibuix, i la funció que té.
9 Copia les frases següents i indica el teixit a què fan referència.
a) La matriu és líquida i es denomina plasma.
b) Forma les glàndules, que segreguen substàncies.
c) La matriu és sòlida i elàstica. El trobem entre les vèrtebres i a l’orella.
d) Té una funció protectora pel fet d’entapissar cavitats.
e) Té poca substància intercel·lular i les cèl·lules emmagatzemen greix.
f) Les cèl·lules transmeten l’impuls nerviós.
g) Les cèl·lules són allargades i s’encarrega del moviment del cos.
h) La matriu és sòlida i amb sals de calci.
REFLEXIONA
Avança
10 Llig el text següent i respon les preguntes.
El microscopi, un invent del segle XVI, és una ferramenta clau en l’estudi de la cèl·lula. Amb l’aparició de microscopis cada vegada més potents, s’ha pogut conéixer l’estructura cel·lular. La «potència» d’un microscopi és el seu poder de resolució, és a dir, la distància més xicoteta a la qual dos punts d’una imatge s’aprecien com a punts separats. Els microscopis òptics utilitzen la llum visible, que travessa la mostra i proporciona una imatge ampliada per un conjunt de lents. El seu poder de resolució és de 0,2 μ m. Els microscopis electrònics no utilitzen la llum, sinó un feix d’electrons que, després de travessar la mostra o rebotar-hi, són captats per una pantalla, on es forma la imatge. Tenen un poder de resolució de 5 nm.
a) Indica amb quin tipus de microscopi s’han pres aquestes imatges de glòbuls rojos.
b) Sabent que el diàmetre d’un glòbul roig és d’uns 5 μm, calcula el nombre d’augments que proporciona cada microscopi.
En aquesta unitat has assentat les bases teòriques necessàries per a entendre com està estructurat el nostre cos i has vist quines són les macromolècules que el componen relacionant-les amb les que es troben en els aliments. Reflexiona sobre el teu aprenentatge omplint el qüestionari i la rúbrica, disponibles en anayaeducacion.es
Aspectes
Identifique la informació continguda en l’etiqueta d’un aliment i sé diferenciar els tipus de nutrients que hi apareixen.
aconseguit
aconseguit
POSA A PROVA LES TEUES COMPETÈNCIES
Fes l’autoavaluació competencial inclosa en anayaeducacion.es




U 1
Totalment
Bastant
AconseguitQuasi
aconseguit











La
nutrició i l’alimentació
LOUIS PASTEUR.
Un químic entre bacteris
Em dic Louis Pasteur, vaig nàixer en 1822 a la ciutat francesa de Dôle i com a estudiant vaig ser un desastre en ciències. Irònicament, hui soc un dels científics més coneguts de la història.
Quan era xiquet destacava en pintura, de manera que els meus mestres em van guiar en aquesta direcció. Vaig créixer amb el desig de convertir-me en professor d’art, però mon pare, poc convençut, em va obligar a estudiar també altres matèries. En 1842 vaig obtindre el títol de Matemàtiques a la universitat de Dijon amb notes prou mediocres en Física i Química. Em va costar bastant, però en 1847 vaig aconseguir doctorar-me precisament en Física i Química.
A partir d’aleshores em vaig guanyar la vida com a professor de Física al Liceu de Dijon i després com a professor de Química a la Universitat d’Estrasburg. Per fi podia investigar algunes de les incògnites que em plantejava. I no hi ha dubte que vaig obtindre resultats! En 1864 vaig demostrar d’una vegada per sempre que els éssers vius no es poden formar espontàniament. Fins aleshores es creia que alguns materials inerts,
com el caldo o el fang, es podien transformar en éssers vius senzills, com ara mosques o cucs. Vaig tindre la idea de deixar a l’aire un matràs amb caldo de carn i vaig posar filtres perquè cap ésser viu hi poguera arribar . Com esperava, en aquestes condicions no es van formar mosques ni cap altre ésser.
Fruit del meu treball incansable va ser també la teoria germinal de les malalties infeccioses. Establia que les malalties infeccioses estan causades per paràsits microscòpics i que són aquests gèrmens els que es transmeten entre éssers vius i provoquen els contagis. Per a combatre’ls, vaig plantejar un mètode que porta el meu nom, la pasteurització. Consistia a calfar les begudes abans de consumir-les per a matar els microorganismes que pogueren contindre. També vaig pensar que es podien usar gèrmens debilitats per a provocar que una persona s’immunitzara contra una malaltia, la qual cosa em va permetre desenvolupar vacunes contra el còlera i la ràbia.
No és per presumir, però no està gens malament per a un estudiant mediocre, no creus?
42
2







Què descobriràs?
En aquesta unitat
• Louis Pasteur. Un químic entre bacteris
1. La nutrició en l’ésser humà
2. Els nutrients
3. L’aportació d’energia
4. L’alimentació
5. Les recomanacions dietètiques
6. Alimentació i sostenibilitat
7. La dieta i la salut
• Comprén, reflexiona i posa a prova les teues competències
En anayaeducacion.es
Per a motivar
• Vídeo: Abans de començar
• Coneix més... Louis Pasteur
Per a detectar idees prèvies
• Presentació: Què necessites saber
Per a exposar
• Presentació: Les vitamines; On pot haver-hi contaminants alimentaris; L’etiqueta dels aliments.
• Infografia: Rodes, piràmides i rombes
Per a exercitar
• Activitats interactives: Aprén jugant Posa’t a prova
• Taller de ciències: Valora si una dieta és equilibrada
I, a més, tota la documentació necessària per a aplicar les claus del projecte.








SEQÜÈNCIA
















 D’APRENENTATGE
D’APRENENTATGE















anayaeducacion.es



1 La nutrició en l’ésser humà
1.1 La funció de nutrició
Les cèl·lules del nostre organisme no tenen capacitat per a aconseguir nutrients per si mateixes i depenen d’òrgans, aparells i sistemes que els els proporcionen. Els òrgans especialitzats en la nutrició duen a terme els processos següents:
La nutrició és el conjunt de processos que permet a l’ésser humà obtindre la matèria i l’energia necessàries per a construir i mantindre les seues estructures i realitzar les seues activitats.
- L’obtenció de nutrients, a partir dels aliments, i d’oxigen, a partir de l’aire.
COMPRÉN, PENSA, INVESTIGA...
1 Què és la nutrició?
2 Quins aparells són necessaris perquè els nutrients i l’oxigen arriben a les cèl·lules?
3 Quins aparells estan implicats en l’eliminació dels productes de rebuig i del diòxid de carboni? D’on procedixen aquestes substàncies?
- El transport dels nutrients i l’oxigen a les cèl·lules.
- La respiració cel·lular, que té lloc als mitocondris de les cèl·lules.
- L’eliminació dels rebutjos cel·lulars i del diòxid de carboni, que s’han de transportar des de les cèl·lules fins als òrgans encarregats d’expulsar-los a l’exterior.
1.2 Els aparells per a la nutrició
La funció de nutrició, la duen a terme, de forma coordinada, els aparells digestiu, respiratori, circulatori i excretor, i el sistema limfàtic.
Digestiu
L’aparell digestiu s’encarrega de transformar els aliments en substàncies més simples, els nutrients, i que aquests passen a la sang. Ho fa per mitjà dels processos de digestió i absorció.
Circulatori
L’aparell circulatori, per mitjà de la sang, s’encarrega del transport dels nutrients i de l’oxigen fins a les cèl·lules, retira d’aquestes els rebutjos i els porta fins als òrgans excretors.





Limfàtic
Respiratori
L’aparell respiratori s’encarrega de l’intercanvi de gasos. Pren l’oxigen de l’aire, que passa a la sang, i elimina d’aquesta el diòxid de carboni, que s’expulsa a l’exterior.


El sistema limfàtic col·labora amb l’aparell circulatori en el transport de substàncies.

















Excretor
L’aparell excretor s’encarrega d’eliminar de la sang els productes de rebuig de l’activitat cel·lular i d’expulsar-los al medi exterior. El formen els òrgans excretors.







44

Els nutrients
Classifica nutrients
L’ésser humà té nutrició heteròtrofa; és a dir, pren matèria orgànica, en forma d’aliments, per a obtindre’n els nutrients necessaris per a la seua supervivència.


Els nutrients són compostos que formen part dels aliments i són necessaris per al funcionament correcte del nostre organisme, que els obté per mitjà del procés de la digestió.











Els nutrients es poden classificar de formes diferents; per exemple, segons la funció que realitzen, segons la quantitat que es necessita ingerir dels aliments o segons la composició química.







2.1 Tipus de nutrients segons la funció















- Nutrients amb funció estructural o plàstica. Alguns nutrients com les proteïnes, alguns lípids, el calci o l’aigua subministren a l’organisme materials per a la formació i la renovació de les estructures i teixits de l’organisme.







Observa l’organitzador visual i llig el text sobre les diferents formes de classificar els nutrients per a completar la taula següent en el quadern.




- Nutrients amb funció energètica. Els hidrats de carboni i els lípids són els principals nutrients que aporten al nostre organisme l’ energia necessària per al manteniment de les funcions vitals. Encara que les proteïnes també poden aportar energia, exercixen una funció principalment estructural.
- Nutrients amb funció reguladora. La duen a terme els nutrients que regulen els processos metabòlics del nostre organisme. Són, sobretot, les vitamines i els minerals, però també l’aigua i la fibra exercixen aquesta funció en l’organisme.






Funció estructural i, ocasionalment, energètica Macronutrients ? ? ? ? ? ? ? ? ? ? ? ?
2.2 Tipus de nutrients segons la quantitat que es necessita ingerir
- Micronutrients. Són aquells que l’organisme necessita en quantitats molt reduïdes. Els nutrients d’aquest tipus són les vitamines i els minerals.
- Macronutrients. Són els nutrients que l’organisme necessita en quantitats més grans. Són les proteïnes, els lípids, els hidrats de carboni i l’aigua.
45 U 2 2
Els nutrients essencials són aquells que el nostre organisme no pot sintetitzar en suficient quantitat, però són imprescindibles per al creixement i el desenvolupament de cada persona. Per això, s’han d’obtindre dels aliments que prenem.
2.3 Tipus de nutrients
Nutrients inorgànics
segons la composició
- L’aigua és el principal component de l’ésser humà; forma entre el 55 i el 70 % del pes corporal. És un nutrient essencial, per la qual cosa és necessari ingerir-la o directament o a través dels aliments. Les funcions que té són molt diverses: actua com a dissolvent dels nutrients, cosa que permet transportar substàncies i facilita les reaccions químiques a les cèl·lules, complix funcions estructurals, manté la temperatura corporal, etc.









- Els minerals. Destaquen per la importància que tenen: calci, fòsfor, ferro, iode, fluor, sodi, clor, potassi, sofre, magnesi, manganés, coure, cobalt, zinc, crom, molibdé i seleni. Tenen funció reguladora; per exemple, el calci, en la contracció muscular, o el ferro, en el transport d’oxigen a les cèl·lules; i funció estructural; per exemple, el fòsfor i el calci, en els ossos.




COMPRÉN, PENSA, INVESTIGA...
1 Elabora una taula en què relaciones els nutrients amb les seues funcions respectives.

2 Consulta el recurs «Les vitamines» en el banc de recursos en anayaeducacion.es i respon:
a) Quina diferència hi ha entre les vitamines hidrosolubles i les liposolubles?
b) Explica quines funcions exercixen la vitamina C i la vitamina A.

3 Full giratori. Feu una llista amb les biomolècules que componen l’organisme, i una altra amb els nutrients. Compareu ambdues llistes i debateu a classe si el que observeu es relaciona amb la famosa frase «Som el que mengem».
Nutrients orgànics
- Els glúcids o hidrats de carboni. La principal funció que tenen és proporcionar energia. Els més senzills són els sucres, com la glucosa, la fructosa i la sacarosa. Els més complexos, també anomenats polisacàrids, estan formats per diversos centenars de sucres senzills units en cadenes llargues que poden ramificar-se. Entre aquests cal destacar els anomenats polisacàrids digeribles, com el midó digerible i el glucogen, i els polisacàrids no digeribles, que només es poden utilitzar en part i constituïxen el que es denomina fibra alimentària; per exemple, el midó no digerible, les cel·luloses, les hemicel·luloses i les pectines.
- La fibra alimentària. Encara que tradicionalment s’ha inclòs la fibra dins del grup dels hidrats de carboni (el 90 % dels compostos que formen la fibra són polisacàrids), altres compostos que és consideren fibra, com la lignina, no tenen aquesta estructura química. La fibra exercix un paper essencial en la regulació de les funcions digestives, fonamentalment regula el trànsit intestinal i l’absorció de nutrients.
- Els lípids. Tenen composicions químiques molt diferents i complixen funcions diverses. Per exemple, els greixos proporcionen energia; el colesterol o els fosfolípids formen part de les membranes cel·lulars; uns altres lípids tenen funció reguladora, com els que componen les hormones sexuals.
- Les proteïnes. Són macromolècules formades per la unió de molècules senzilles anomenades aminoàcids. Tenen una funció estructural, ja que constituïxen el segon component més abundant del cos. També tenen funció reguladora, com els enzims, que acceleren les reaccions químiques; funció defensiva, com els anticossos; funció transportadora, com l’hemoglobina.
- Les vitamines. Són substàncies de composició molt variada i, encara que es requerixen en quantitats molt xicotetes, són essencials per al funcionament correcte de l’organisme. Es dividixen en hidrosolubles (vitamina C i vitamines del grup B) i liposolubles (A, D, E i K).
46 Els nutrients
2
2.4 Les fonts alimentàries dels nutrients
Les fonts alimentàries dels nutrients són aquells aliments que contenen més quantitat del nutrient en qüestió en comparació amb altres.
Així, un exemple de font rica en hidrats de carboni són les creïlles; de lípids, l’oli d’oliva; de proteïnes, el peix i la carn; de vitamines, les fruites i les verdures (vegeu la taula més avall).
A més dels nutrients, els aliments contenen una sèrie de substàncies no nutritives, els anomenats no nutrients. Com es veurà més avant, algunes d’aquestes substàncies, de vegades, poden resultar perjudicials per al nostre organisme.

Analitza aliments
Observa la composició en macronutrients dels aliments següents expressada per cada 100 g de part comestible.
Poma
Aigua: 85,7 g
Proteïnes: 0,3 g
Lípids: 0 g
Glúcids: 12 g
Fibra: 2 g

Aigua: 75,1 g
Proteïnes: 1,2 g
Lípids: 0,3 g
Glúcids: 20 g
Fibra: 3,4 g










Aigua i altres begudes, i formant part d’aliments com fruites, verdures, peix, etc.
Presents en quasi tots els aliments en major o menor quantitat. Per exemple, el ferro, en fetge, carn, peix, llegums, fruita seca oleaginosa i verdura; el iode, en la sal iodada, peix, marisc, algues i vegetals, etc.
En fruites, mel, sucs, conserves, sucre de taula, cereals, llegums, creïlles i tubèrculs.
Greixos saturats: en la mantega, la margarina, els productes de pastisseria, les galetes, les vísceres, la carn roja, els ous i el marisc.
Greixos insaturats: en els olis d’oliva, gira-sol, dacsa, soja i llavors de raïm.
Proteïnes d’origen animal: en la carn, peix, ous, vísceres, llet i derivats.
Proteïnes d’origen vegetal: en llegums, soja i fruita seca.
Hidrosolubles: en carn, peix, fetge, ous, llet, fruita seca, cereals, llegums i rent.
Liposolubles: en carn, fetge, llet, rovell d’ou, cacauet, coco, olis vegetals, salmó, sardina, abadejo, bledes, crucíferes (com la col i la floricol), etc.
Sobretot en aliments vegetals com verdures i hortalisses, fruites, llegums, cereals i derivats, i fruita seca.
Aigua: 62,3 g
Proteïnes: 21 g
Lípids: 16,7 g
Glúcids: 0 g
Fibra: 0 g

Aigua: 4,6 g
Proteïnes: 22,9 g
Lípids: 54,1 g
Glúcids: 7,9 g
Fibra: 7,5 g


Aigua: 87,9 g
Proteïnes: 3,7 g
Lípids: 2,7 g
Glúcids: 4,4 g
Fibra: 0 g


Aigua: 87,5 g
Proteïnes: 2 g
Lípids: 0,4 g
Glúcids: 4,5 g
Fibra: 5,6 g


a) Ordena els aliments d’aquesta activitat de major a menor aportació dels macronutrients següents: d’aigua, de proteïnes, de lípids, de glúcids i de fibra.

b) Abans pensava..., ara pense… Digues si t’han sorprés o no coneixies algunes de les dades sobre la composició dels aliments d’aquesta activitat aplicant aquesta tècnica de pensament. Per a conéixer com fer-ho, consulta la informació disponible en el banc de recursos d’anayaeducacion.es
c) Busca informació sobre la composició d’alguns dels aliments que has pres hui en el desdejuni i en el dinar i ordena’ls de la mateixa manera que en l’apartat a) d’aquesta activitat.
47 U 2
Carn semimagra
Mescla de fruita seca
Plàtan
Iogurt
Bledes
3

L’aportació d’energia
COMPRÉN, PENSA, INVESTIGA...
1 En quin lloc de la cèl·lula té lloc l’obtenció d’energia?
2 Explica pas a pas la respiració cellular.
3 Per a què utilitza la cèl·lula l’energia que obté dels nutrients?

4 Busca informació per a definir metabolisme, catabolisme i anabolisme. Quin tipus de procés metabòlic és la respiració cel·lular?
Com ja s’ha comentat, alguns nutrients procedents dels aliments s’utilitzen com a font d’energia.
La cèl·lula usa l’energia obtinguda dels nutrients per a realitzar diverses activitats cel·lulars, com, per exemple, transportar certes substàncies a través de la membrana, fabricar components cel·lulars, efectuar moviments, etc.
El valor energètic d’un aliment és proporcional a la quantitat d’energia que poden aportar els nutrients que conté en cremar-se en presència d’oxigen; és a dir, durant la respiració cellular.
3.1 La respiració cel·lular
L’obtenció d’energia té lloc a l’interior de les cèl·lules, a través de la respiració cel·lular, un procés que es produïx als mitocondris i que requerix oxigen.
La espiració cel·lular comprén les etapes següents:
- Els nutrients orgànics, fonamentalment la glucosa, procedents de la digestió dels aliments, arriben a les cèl·lules.
- Una vegada en aquestes, la glucosa entra en el mitocondri, junt amb l’oxigen (O2) captat de l’aire, a través dels pulmons.
- Al mitocondri, el O2 es combina amb la molècula de glucosa, que es trenca i allibera l’energia emmagatzemada en els seus enllaços químics.
- La molècula de glucosa es transforma en aigua (H2O), que queda a l’interior cel·lular, i diòxid de carboni (CO2), un rebuig que s’expulsa fora de la cèl·lula.
De forma senzilla, la respiració cel·lular es pot esquematitzar així:
La respiració cel·lular al mitocondri
Nutrients orgànics (glucosa) procedents de la digestió dels aliments





O2 (procedent de la respiració pulmonar)





48
H2O CO2 Energia
3.2 El contingut energètic dels aliments
Encara que la major part de l’energia que s’obté procedix dels glúcids, les cèl·lules poden també obtindre energia a partir dels lípids, i fins i tot de les proteïnes. La cèl·lula utilitza els lípids per a obtindre energia només en absència de glucosa; les proteïnes només s’utilitzaran per a aquest fi en absència de glúcids i lípids. Quan aquests nutrients, procedents dels aliments, arriben a les cèl·lules, alliberen l’energia que contenen.
La quantitat d’energia alliberada pels aliments es mesura en quilocalories o en quilojoules. Una caloria és la quantitat d’energia que cal subministrar a 1 gram d’aigua per a elevar la seua temperatura 1 °C.
Així, cada gram de glúcids o de proteïnes aporta unes 4 quilocalories, enfront de les 9 quilocalories que aporta un gram de lípids. No tots els nutrients aporten energia; així, per exemple, els micronutrients (vitamines i minerals), l’aigua i la fibra no aporten energia.
Quilocaloria i caloria
1 kcal = 1 000 cal
1 cal = 4 ,186 joules
Equivalències
Quilojoule i joule
1 kjoule = 1 000 joules
1 joule = 0,24 cal
3.3 Els requeriments energètics
Les nostres necessitats energètiques diàries depenen de la constitució, del sexe, de l’edat i de l’activitat física. Hem de prendre l’energia necessària per a cobrir les nostres necessitats sense excedir-nos, la qual cosa podria conduir al sobrepés. La nostra despesa energètica total és la suma de l’energia que gastem en:
- El metabolisme basal o taxa de metabolisme basal (TMB), que és la quantitat mínima d’energia necessària per a realitzar les funcions de l’organisme en repòs; manté, per exemple, la temperatura corporal, l’activitat cerebral, el ritme respiratori o el batec cardíac, en absència d’activitat física. El valor del metabolisme basal varia amb la talla, el pes, el sexe i l’edat de la persona. També experimenta canvis durant l’embaràs i la lactància.
- L’activitat física que realitzem diàriament. Així, les persones que porten una vida sedentària gasten menys energia que les que exercixen una activitat física intensa. A més, segons l’activitat física, es gasta més energia o menys; per exemple, caminar a pas ràpid consumix unes 300 kcal/h i córrer, unes 650 kcal/h.
- La digestió i l’absorció de nutrients també té un requeriment energètic que no està contemplat dins de la TMB.
Càlcul de les necessitats calòriques diàries
El metabolisme basal diari (TMB) es pot calcular de forma aproximada de la manera següent per mitjà de les equacions de Harris-Benedict:
Homes
TMB = (10 x massa en kg) + (6,25 × altura en cm) – (5 × edat en any
Dones

TMB = (10 x massa en kg) + (6,25 × altura en cm) – (5 × edat en anys) – 161
Al resultat obtingut s’afig un factor de correcció per a tindre en compte l’activitat física realitzada:
– Si es porta una vida sedentària:
Calories diàries necessàries = TMB x 1,2
– Si es fa exercici regularment i de forma moderada:
Calories diàries necessàries = = TMB x 1,5
– Si es fa molt d’exercici tenint en compte la freqüència i la intensitat:
Calories diàries necessàries = = TMB x 1,725

COMPRÉN, PENSA, INVESTIGA...
5 Per què creus que les cèl·lules utilitzen els lípids i no els glúcids com a magatzem energètic?
6 100 g de carlotes contenen 90 g d’aigua; 7,30 g d’hidrats de carboni totals; 0,90 g de proteïnes; 0,20 g de lípids, i 2,40 g de fibra. Quanta energia donarà un suc de 5 carlotes que pesen 400 grams?
7 Calcula les teues necessitats calòriques diàries aplicant la fórmula de Harris-Benedict.
49 U 2

L’alimentació
COMPRÉN, PENSA, INVESTIGA...
1 Explica la diferència entre alimentació i nutrició.
Alguns exemples de racions
Organitza en una taula la informació que es mostra a continuació i relaciona el nom de la ració i la seua mesura (massa, volum, etc.).
Líquids

La terrina sol contindre 125 mL.

Un got pot contindre 200-250 mL d’un líquid com la llet o l’aigua.
Sòlids



Aquest plat de llegums equivaldria a 60 g en cru i a 10 cullerades cuits.
Porció
L’alimentació és el procés pel qual es prenen les substàncies (aliments) que proporcionen els nutrients.
L’alimentació forma part de la nutrició; encara que en aquest cas es tracta d’un procés voluntari i conscient.
4.1 Conceptes previs sobre l’alimentació
- Dieta. Conjunt d’aliments i begudes que consumim regularment en una determinada quantitat o ració. Quan s’ingerixen, és a dir, es prenen per la boca, es denominen ingesta.
- Ració. Mesura aproximada i, de vegades, poc exacta que s’usa habitualment per a referenciar la quantitat d’un determinat aliment a l’hora de consumir-lo com a recomanació dietètica o a l’hora d’elaborar receptes com a mesura culinària. Se sol expressar en mesures de volum o de massa, en porcions com la llesca, la peça... o fins i tot en mesures considerades com «casolanes», com la cullerada, el grapat, etc.
Alguns exemples de ració
Altres mesures


Una cullerada sopera conté 20-30 mL.


Un grapat de fruita seca poden ser 20 g.

Aquesta ració de pasta en plat equival a 70 g en cru.
Una porció pot equivaldre a...


Un peça.


Un grapat.


Aquesta ració d’arròs en plat equival a 50 g en cru.

Una miqueta (porció molt xicoteta) de, per exemple, mantega poden ser 10 g.



Un bol de cereals poden ser 60-80 g, 150 g si el contingut són verdures d’ensalada o 240 mL si el contingut és un líquid.

Un tros de, per exemple, formatge, equival a 60 g.



Dues mans de verdures com les carlotes, el bròquil o la tomaca equivalen a 150 g.


Una tallada.




2 o 3 unitats que serien, aproximadament, 100 g.


Un filet de 110-120 g.
1 o 2 ous, segons el tipus.


Una llesca o un tros de 3 dits d’ample d’uns 30 g.
50
4
4.2 Alimentació saludable
L’alimentació saludable és aquella que aporta a l’organisme els nutrients i l’energia necessaris per a realitzar les funcions vitals, conservar o restablir la salut, disminuir el risc de patir malalties, assegurar la reproducció, la gestació i la lactància, i que promou un creixement i un desenvolupament òptims.
Estil de vida saludable o dieta equilibrada o saludable són conceptes equivalents a alimentació saludable.
No es pot afirmar que hi haja un sol tipus de dieta per a tindre una alimentació saludable, ja que aquesta varia segons l’edat, el sexe, l’activitat física, l’embaràs, les malalties, l’estació de l’any, la regió geogràfica...
L’ALIMENTACIÓ SALUDABLE HA DE SER:
Una alimentació saludable

a) Mapa mental. Tot seguit s’exposen alguns consells per a tindre una alimentació saludable. Estructura aquesta informació en un mapa mental en què l’«alimentació saludable» siga el tema principal del qual partixen les recomanacions i amplia-la. Per a saber en què consistix aquest tipus d’organitzador de pensament, consulta el banc de recursos en anayaeducacion.es
b) Elabora el menú d’un dia en què no es complisca cap d’aquests consells. Justifica, en cada cas, per què no es complix.



Suficient. Que cobrisca les necessitats d’energia, segons les exigències de les diferents etapes o circumstàncies de la vida.
Completa. Que continga tots els nutrients que necessita l’organisme i en quantitats adequades.
Equilibrada. Que continga més presència d’una àmplia varietat d’aliments de bona qualitat nutricional, com els productes frescos i d’origen principalment vegetal, i amb una presència escassa o nul·la d’aliments de baixa qualitat nutricional.
Segura. Que la presència de contaminants físics, químics o biològics no resulte nociva per a les persones sensibles o que no supere els límits de seguretat establits per les autoritats competents.
Harmònica. Que tinga una proporció equilibrada dels macronutrients que la integren.
Satisfactòria. Que siga agradable i sensorialment plaent.
Adaptada. Que s’ajuste a les característiques individuals, socials, culturals i de l’entorn.
Social i assequible. Que permeta la interacció social i la convivència, i que siga econòmicament viable.
Sostenible. Que la seua contribució al canvi climàtic siga la menor possible i que prioritze els productes autòctons.

Consells per a tindre una alimentació saludable
• Ha d’aportar l’energianecessària. Un 55 % ha de procedir dels glúcids, un 30 % dels lípids i un 15 % de les proteïnes.
• Ha de ser variada i tindre la proporció adequada amb:
– Aliments que continguen tots els tipus de nutrients
– Cinc racions de fruites i verdures al dia, que aporten vitamines, minerals i fibra vegetal.
– Sense abús d’aliments rics en proteïnes i greixos, i en aquest cas són millors els d’origen vegetal o els procedents del peix blau (tonyina, sardina, aladroc, salmó, etc.).
• Ha d’incloure almenys litre i mig d’aigua al dia i evitar l’excés de sal.
• Convé fer cinc menjades al dia: desdejuni i esmorzar, més energètics; i dinar, berenar i sopar, més lleugers.







51 U 2

Les recomanacions dietètiques 5
Hi ha nombroses formes de presentar les recomanacions per a seguir un estil de vida saludable; entre aquestes, les més destacades i conegudes són la roda dels aliments, la piràmide de l’alimentació saludable, el patró alimentari saludable, etc. Totes, a més, es complementen amb la recomanació de realitzar exercici físic i tindre una hidratació suficient i adequada.
5.1 La roda dels aliments
La roda dels aliments
Per què els grups V i VI d’aliments es presenten sobre fons verd i els grups I i II sobre fons groc? Per què el sector del grup IV és més xicotet que el sector del grup I?
Color del sector Grup d’aliments Funció
I, II Energètica
III, IV Plàstica
V, VI Reguladora
Grup I. Inclou els cereals i els seus derivats, com el pa o la pasta, les creïlles i el sucre. Són aliments rics en glúcids, amb funció energètica.
La roda dels aliments és una representació gràfica de la quantitat i del tipus d’aliments que ha d’incloure una dieta equilibrada, incloent, a més, els consells relacionats amb l’activitat física i la hidratació. En la roda alimentària, els aliments es distribuïxen en sis sectors de colors diferents (groc, roig i verd), que són indicatius del grup d’aliments (n’hi ha sis), de la funció que exercixen els nutrients que hi predominen (energètica, plàstica o reguladora), i de la freqüència i la quantitat en què s’han de consumir (com més gran siga el sector, més gran n’ha de ser el consum).
Aquesta és una de les representacions més utilitzades per a fer recomanacions dietètiques; per exemple, és una de les propostes de la Societat Espanyola de Dietètica i Ciències de l’Alimentació.
Grup II. Inclou els olis i els greixos, com la mantega. Són aliments rics en lípids, amb funció energètica.
















Grup VI. Inclou la fruita fresca. Són aliments rics en sals minerals i vitamines, amb funció reguladora.




































Grup III. Inclou la carn i el peix, els ous, els llegums i la fruita seca. Són aliments rics en proteïnes, amb funció plàstica.



Grup IV. Inclou la llet i els seus derivats, com el formatge. Són aliments rics en proteïnes, amb funció plàstica.





Grup V. Inclou les verdures i les hortalisses. Són aliments rics en sals minerals i vitamines, amb funció reguladora.
52
5.2 La piràmide de l’alimentació saludable
La Societat Espanyola de Nutrició Comunitària, coneguda per l’acrònim SENC, plasma la seua recomanació en la piràmide de l’alimentació saludable. En aquesta, hi ha sis nivells que representen estils de vida, conductes relacionades amb l’alimentació i la salut, i freqüència de consum dels aliments:
- La base: els estils de vida saludable com l’activitat física, l’equilibri emocional, la hidratació adequada, etc.
- Els tres nivells següents: aliments que s’han de consumir diàriament.
- El cinqué nivell: aliments que s’han de consumir setmanalment.
- I el sisé: aliments el consum dels quals ha de ser ocasional i moderat.
Ocasionalment i amb moderació
Setmanal
COMPRÉN, PENSA, INVESTIGA...

1 Consulta el recurs «Rodes, piràmides i rombes de l’alimentació» del banc de recursos d’anayaeducacion.es i digues en què es basa cada una de les classificacions i recomanacions.

2 1-2-4. Sabent què cal menjar i quant, elaboreu un menú saludable per a una setmana.






Lactis: 2-3 al dia
Resta: < 3 al dia
Verdures: 2-3 al dia
Fruites: 3-4 al dia
Diàriament
Mantindre estils de vida saludables








Segons el grau d’activitat física
















5.3 El patró alimentari saludable


La piràmide dels aliments








Les recomanacions alimentàries també es fan en forma de llista o de patró amb consells per a seguir un estil de vida saludable:
Prendre aliments nutritius i variats; consumir al dia:



• 4-6 racions de llegums, tubèrculs o fruita seca.
• 2-4 racions d’aquests grups d’aliments: cereals i derivats; fruites; carn, peix i ous.
• 2-3 porcions de lactis.
• 40-60 g de greixos.


àmide de l’alimentació, a més eqüència de consum dels oposen normes de conducelacionades amb l’alimentació com la ta en cinc menjades al onsum d’aliments de proximiocorre alguna conducta més que ajude a tindre una alisaludable? Proposa’n, s, una.














I seguir consells com: fer f c om: f onsells c er 3-5 menjades al dia, procurar consumir productes de onsumir product ar c es de rar proximitat, menjar en comc ximitat,o om- pr panyia, cuinar... cuinar yia,pan

• Mantindre una hidratació adequada per mitjà del consum d’aigua, infusions, brous, fruites, verdures...
• Procurar que les proteïnes i els greixos consumits siguen d’origen vegetal, de peix blau o de carn blanca; o oli d’oliva.
• Limitar el consum d’aliments rics en greixos saturats, begudes amb sucres afegits i sal.

53 U 2
Hidratació adequada
Equilibri emocional Balanç energètic Tècniques culinàries saludables Activitat física

L’alimentació
i la sostenibilitat
Alguns aliments de la dieta mediterrània









Investiga sobre aquests plats típics de la dieta mediterrània i indica quines característiques fan que hi pertanguen.
Segons la FAO, l’Organització de les Nacions Unides per a l’Alimentació i l’Agricultura, les dietes sostenibles són aquelles que, a més de criteris relacionats amb la nutrició i la seguretat alimentària, tenen en compte el component mediambiental.
Les dietes sostenibles són aquelles que generen un menor impacte ambiental.
Les dietes sostenibles protegixen i respecten la biodiversitat i els ecosistemes, i complixen els criteris d’alimentació saludable. Són culturalment acceptables, accessibles; econòmicament justes i assequibles; nutricionalment adequades i innòcues, i optimitzen els recursos naturals i humans.
Alguns exemples de dietes sostenibles pròximes al nostre entorn són la dieta mediterrània i la dieta atlàntica.
6.1 La dieta mediterrània
La dieta mediterrània és tradicional de la regió del mateix nom. És un exemple d’alimentació saludable.
La base de la dieta mediterrània són les verdures, l’oli d’oliva, el peix, els cereals, els llegums, les creïlles, les fruites, el iogurt i la llet fermentada, a més de l’aigua.
La dieta mediterrània
Fes una llista amb tot el que has menjat en els últims 7 dies i respon les qüestions següents.
a) Anota al costat de cada plat quin es podria considerar com a part de la dieta mediterrània.
b) Els plats que no formen part de la dieta mediterrània, es poden considerar plats saludables? Justifica la resposta.
c) Si en la teua llista hi ha algun plat que es poguera considerar no saludable, com podries substituir-lo per alguna cosa que sí que ho fora?
d) Planifica un menú per a 3 dies que complisca amb les normes d’una dieta saludable i especifica si hi ha algun plat que es poguera considerar part de la dieta mediterrània.
És important mantindre la dieta mediterrània a pesar dels obstacles de hui en dia (falta de temps per a comprar i cuinar...), ja que evita malalties relacionades amb la nutrició com l’obesitat, les malalties cardiovasculars, la diabetis i alguns tipus de càncer.
Les característiques principals d’aquesta dieta són:
- Les receptes basades en els cereals, els llegums o les creïlles (pasta, arròs, llentilles, fesols, cigrons, guisats, etc.) i que inclouen verdures abundants (fesols, carlotes, cebes, espinacs, etc.) i poques proteïnes.
- Les principals fonts de proteïnes són el peix, les aus de corral, els ous i els productes lactis. El consum de carn roja, com el porc i la vedella, és molt menor.
- Les menjades principals s’acompanyen d’ensalades, amb verdures i hortalisses: encisam, tomaca, cogombre, etc., i acaben amb fruita de temporada.
- S’utilitza l’oli d’oliva i condiments, com ara all, julivert, llima, orenga o pebre, que disminuïxen la necessitat de l’ús de sal.
54 6
6.2 La dieta atlàntica
Un altre exemple de dieta sostenible i saludable és la dieta atlàntica. Aquesta té moltes similituds amb la dieta mediterrània, algunes de les quals són:
- El principal greix culinari és l’oli d’oliva.
- Abunden els aliments d’origen vegetal com el pa, les creïlles, els llegums i les fruites i verdures.
- Hi ha un consum elevat d’ous i lactis, i un consum moderat de carn, enfront d’un consum de peix i de marisc més elevat.
La dieta atlàntica és típica dels països banyats per l’oceà Atlàntic, en la qual predomina el consum de peix i marisc, creïlles, cereals, llegums, fruites i hortalisses com la col, la col copada, les fulles tendres de nap, entre altres.
6.3 Altres dietes sostenibles i saludables
A més de les dietes esmentades, hi ha altres maneres de tindre una alimentació saludable que també complixen amb els criteris de sostenibilitat establits. Totes prioritzen aliments obtinguts seguint un model de producció més sostenible amb mesures com:
- Tindre en compte la procedència i la temporalitat dels aliments a l’hora de consumir-los, afavorint els que es produïxen en l’entorn pròxim i la data d’obtenció. Per exemple, són d’hivern la carabassa, les carxofes, el llobarro; d’estiu, el meló d’Alger, la tonyina...
- Utilitzar com a font de lípids i proteïnes aliments d’origen vegetal com l’oli d’oliva o de gira-sol, l’alvocat, l’avena, la fruita seca, els llegums com els cigrons, les llentilles...
- Limitar el consum de determinats aliments com les begudes ensucrades, els aperitius salats o els envasats en plàstic.
- Utilitzar tècniques culinàries més saludables i sostenibles que requerixen menys consum d’energia, ajuden a previndre malalties... Per exemple, afavorir el consum en cru dels aliments, reduir el consum de sal o de sucre utilitzant com a adob o condiment herbes aromàtiques, all, llima, canella...
COMPRÉN, PENSA, INVESTIGA...

1 La dieta mediterrània ha sigut declarada Patrimoni Cultural Immaterial de la Humanitat. Investiga i digues què significa aquest reconeixement i quan i per què s’ha atorgat.
2 Elabora un calendari amb aliments de temporada; inclou, almenys, una fruita, una verdura i un peix per a cada mes.
3 Proposa maneres de reduir el consum de sal i de sucre.

4 Mapa conceptual sistèmic. Completa, amplia i relaciona les idees de l’organitzador de la dreta sobre formes de portar una alimentació sostenible i saludable. Per a saber en què consistix aquest organitzador gràfic, consulta el banc de recursos en anayaeducacion.es
Un aliment tradicional i saludable



El pa és un dels aliments estrela des del punt de vista nutricional. Ha sigut la base de l’alimentació tradicional del nostre entorn. És molt recomanable l’elaborat a la manera tradicional, amb farines integrals i poc refinades, i amb un contingut en sal baix.
Predominen l’oli d’oliva, el peix, les fruites i les verdures com frui ? ; els llegums com ? , els cereals com ?
























55 U 2

La dieta i la salut



Molts aspectes de la salut es poden millorar si s’adopten estils de vida saludables. Per exemple, es poden previndre malalties com el càncer, l’aterosclerosi, l’ictus, etc.



La falta de glòbuls rojos és un tipus d’anèmia que es pot previndre si es porta una dieta saludable i variada. La malaltia provoca debilitat i cansament.
COMPRÉN, PENSA, INVESTIGA...
1 Quins són els perills de prendre sovint un excés d’aliments i portar una vida sedentària?
2 Diferencia malnutrició i desnutrició.

3 Busca el significat d’aquests termes relacionats amb la malnutrició: raquitisme, marasme, caquèxia i emaciació.

4 On creus que hi ha més freqüència de xeroftàlmia o ceguera infantil, una malaltia causada per la falta de vitamina A? Proposa, almenys, una mesura per a evitar-la.
La forma d’alimentar-se, quant a tipologia d’aliments, varietat, quantitat, components..., té efectes sobre la salut de les persones. Per aquests efectes sobre la salut, la dieta està relacionada amb la seguretat alimentària.
La seguretat alimentària és l’accés de totes les persones i en tot moment a aliments nutricionalment adequats i innocus en quantitat i qualitat suficients per a portar una vida activa i sana.
Aquests efectes poden ser positius, si contribuïxen a tindre un bon estat de salut (ajuden a previndre o a curar malalties, per exemple), o negatius si, al contrari, són la causa de malalties relacionades amb la falta o amb l’excés de nutrients i d’energia, com la malnutrició, o amb la presència de substàncies que poden causar danys, cosa que faria perdre a l’aliment la seua qualitat d’innocu, com és el cas de les intoxicacions alimentàries.
7.1 La malnutrició
La malnutrició està causada per una dieta inadequada amb dèficit o superàvit de nutrients o d’energia, que provoca alteracions com la desnutrició o la sobrenutrició, les malalties per carència...
La desnutrició
Es produïx per una ingesta inadequada d’aliments que deriva en la falta d’energia, la qual cosa ocasiona que el cos utilitze les reserves de glúcids i lípids, i, en els casos més greus, la pèrdua de les pròpies proteïnes, cosa que pot conduir a la mort.
Entre els trastorns d’aquest tipus estan el raquitisme; l’anorèxia nerviosa, un trastorn psicològic amb conseqüències greus per a la salut que es caracteritza pel rebuig a alimentar-se per por d’engreixar; i la bulímia, una altra malaltia mental que es caracteritza pel desig compulsiu pel menjar, la fartada consegüent i la porga posterior, normalment per mitjà del vòmit, per la por d’engreixar, pel sentiment de culpa, etc.
La sobrenutrició
Es produïx normalment per una ingesta excessiva d’aliments, nutrients i energia que acaba emmagatzemant-se i que provoca, en la majoria dels casos, efectes negatius per a la salut de les persones.
Un dels efectes més habituals d’aquest tipus de malnutrició és l’obesitat, una malaltia caracteritzada per l’acumulació de l’excés de greix corporal que, a més, està relacionada amb el patiment o l’agreujament d’altres malalties com les cardiovasculars (l’aterosclerosi), el càncer, la diabetis, etc.
Les malalties per carència
Estan produïdes per una dieta poc variada o insuficient, en la qual falten determinats nutrients. Les més freqüents són les avitaminosis (falta de vitamines) o l’anèmia per deficiència de ferro.
56 7
7.2 Les al·lèrgies i les intoleràncies alimentàries
Algunes persones mostren reaccions adverses (intoleràncies o reaccions al·lèrgiques o de defensa davant de substàncies que haurien de ser innòcues) en ingerir alguns aliments. Les més comunes són la intolerància a la lactosa, que és un sucre de la llet, i la celiaquia, o intolerància al gluten, que és una proteïna present en el blat. Les al·lèrgies alimentàries més freqüents són a la fruita seca, a l’ou o al marisc.
7.3 Les malalties i la higiene alimentària
Algunes vegades, en els aliments pot haver-hi substàncies o microorganismes que poden causar danys en la salut de les persones que els consumixen provocant malalties de transmissió alimentària o intoxicacions alimentàries.
La presència d’aquestes substàncies contaminants està relacionada amb el mal estat dels aliments. Normalment, aquesta contaminació es produïx en alguna de les etapes de la cadena alimentària (procés que va des de la producció fins al consum) o es deu a la contaminació ambiental. La legislació establix les quantitats màximes permeses per a aquest tipus de substàncies.
Entre les mesures d’higiene alimentària destaquen la llavada dels aliments que es consumixen crus, la neteja dels objectes que s’utilitzen per a cuinar o menjar, la conservació en fred dels aliments que necessiten refrigeració, etc.
Els contaminants dels aliments, segons el seu origen, poden ser: biològics, químics o físics.
Contaminants biològics
Les mesures encaminades a garantir el bon estat dels aliments a fi d’evitar la presència de substàncies que causen malalties constituïxen la denominada higiene alimentària.
- Organismes causants de malalties com el bacteri Salmonella, que causa la salmonel·losi, el cuc Taenia solium, que causa la teniosi, les larves del cuc Anisakis, que provoquen la malaltia del mateix nom, etcètera.
- Toxines com la toxina botulínica, que causa el botulisme i que està produïda pel bacteri Clostridium botulinum, o l’aflatoxina, produïda per certs fongs de la família Aspergillus.
Contaminants químics
- Alguns additius alimentaris poden tindre efectes nocius.
- Altres substàncies com els pesticides o els metalls pesants com el plom o el mercuri, exemples de contaminants ambientals, es relacionen amb malalties com el càncer, certes alteracions neurològiques, etc.
Contaminants físics
De vegades, en els aliments pot haver-hi restes de vidre, metall, fusta..., que poden produir ferides en la persona que els consumix.
COMPRÉN, PENSA, INVESTIGA...
5
no poden prendre les persones amb intolerància a la lactosa i les persones amb celiaquia.
6 Què són els additius alimentaris? Esbrina què són i anomena’n, almenys, un exemple.

7 La predicció. Què pot passar si no llaves o peles la fruita que et vols menjar, encara que la peça estiga neta en aparença?

8 Consulta «En quins aliments pot haver-hi contaminants alimentaris» en el banc de recursos en anayaeducacion.es. Després, relaciona les substàncies o els microorganismes causants de malalties que s’hi citen amb els aliments d’aquest plat en què es poden trobar.










Contaminants biològics


Contaminants químics








Contaminants físics

57 U 2
Salmonella
Restes de vidre Pesticides
Taenia solium
Mercuri
Toxina d’Aspergillus
Anisakis











COMPRÉN




Organitza les idees
1 Roda d’atributs. Copia i completa en el quadern l’organitzador visual següent. Aprén a fer una roda d’atributs amb el recurs disponible en anayaeducacion.es.
Ha d’aportar l’energia necessària ?
Fer cinc ? Ha de ser variada ?

Les més energètiques ? i les més lleugeres ?
Fes un resum

Beure ?


Prendre aliments ? ? ?
Evitar ?
2 Elabora el teu resum de la unitat seguint aquest guió:
• Definix nutrició i anomena i explica breument els processos necessaris per a dur-la a terme.
• Cita els aparells implicats en la nutrició, especificant la funció de cada un.
• Anomena les funcions dels nutrients.
• Explica quins tipus de nutrients hi ha segons la seua composició química.
• Explica per què els requeriments energètics no són els mateixos per a totes les persones.
• Digues en què consistix una alimentació saludable.
• Comenta com és i per a què servix la roda dels aliments.
• Comenta com són i per a què servixen la piràmide i el patró alimentari.
• Explica quines característiques han de tindre les dietes sostenibles i digues dos exemples d’aquest tipus de dietes.
• Anomena els tipus de malnutrició i explica’ls breument.
• Explica en què consistix una intolerància alimentària.
• Digues quines conseqüències té per a la salut una mala higiene alimentària.






Interpreta imatges








3 Observa les imatges següents i respon.










a) Quins nutrients es representen en les imatges?
b) Quina funció tenen en l’organisme?
c) De quins aliments els podem obtindre?
4 En els gràfics següents apareix la composició de quatre tipus d’aliments. Compara’ls i intenta assignar-los a cada un d’aquests aliments. a) Mantega b) Maduixes c) Pit de pollastre d) Pastissos. Justifica la resposta.




5 Observa les imatges següents d’aliments i contesta.
a) De quins nutrients són fonts alimentàries?
b) Quines funcions exercixen en l’organisme els nutrients que contenen?
c) Quins d’aquests aliments s’han de consumir diàriament i quins ocasionalment?












A B C D E F
A C B D
Aigua Proteïnes Lípids Hidrats de carboni Fibra
A C B D E


Aplica
6
Establix les diferències entre:
a) Alimentació i nutrició.
b) Nutrient orgànic i inorgànic.
c) Macronutrient i micronutrient.
d) Grapat i porció.
7 Copia i corregix les frases falses següents relatives als nutrients.
a) L’aigua és necessària per la seua aportació energètica.
b) Les vitamines són necessàries en quantitats grans.
c) Les fruites són aliments molt rics en lípids.
d) Les proteïnes estan formades per aminoàcids i només tenen funció defensiva.
8 Classifica els aliments següents segons que tinguen funció plàstica, energètica o reguladora: pimentó, filet de peix, xocolate, fruita, pastís de poma i ou.
9 Digues quines són les racions diàries més adequades dels aliments següents.
a) Arròs o creïlles o cereals. e) Aigua
b) Oli d’oliva. f) Verdures
c) Fruita. g) Llegums
d) Carn o peix.
10 Explica en què consistixen l’anorèxia i la bulímia i indica’n les conseqüències.
REFLEXIONA
Avança

11 Explica el significat de l’oració següent: «Hi ha moltes formes diferents d’alimentar-se, però només una manera de nodrir-se».
12 Elabora una dieta basada en la teua alimentació diària. Has d’anotar tot el que prens i les quantitats aproximades de cada aliment. Després, respon.

a) Recorda la informació del recurs «Taula nutricional dels aliments» que està en el banc de recursos d’anayaeducacion.es i digues els nutrients i el contingut energètic dels aliments que formen part de la dieta que has elaborat.
b) Calcula el contingut energètic de la teua dieta diària.
c) Estudia la teua dieta i analitza si complix amb els requisits d’una dieta equilibrada.

13 Investiga quins aliments es podien trobar en l’Edat Mitjana a Espanya. Fes una llista amb alguns d’aquests aliments i elabora el menú d’un dia. Compara’l amb un de l’actualitat i comenta les diferències des del punt de vista de l’alimentació saludable i sostenible. Per a facilitar-te la resposta, tin en compte aquests aspectes:
– Varietat d’aliments.
– Origen dels aliments.
– Higiene alimentària.
Hem identificat els nutrients presents en el menjar que portem a classe. A més, hem creat un sistema de classificació i hem comprovat com de saludables són els nostres hàbits alimentaris. També hem posat en pràctica els nostres coneixements sobre dietes saludables fent propostes sanes i nutritives. Reflexiona sobre el que has aprés omplint el qüestionari i la rúbrica corresponent, disponibles en anayaeducacion.es
Aspectes Totalment aconseguit
Comprenc el contingut energètic d’un producte, relacionant-lo amb les necessitats energètiques d’un individu.
Bastant aconseguit
POSA A PROVA LES TEUES COMPETÈNCIES
AconseguitQuasi aconseguit
Fes l’autoavaluació competencial inclosa en anayaeducacion.es
U 2
Recorda seleccionar el material de treball d’aquesta unitat per al dossier d’aprenentatge.












Aparells per a la funció de nutrició
LUCY WILLS.
Una guerrera contra l’anèmia
Saps quina ha sigut la idea més feliç que he tingut en tota la meua carrera? Donar Marmite a una mona desnodrida. El Marmite és un aliment típic del meu país, Anglaterra. És una espècie de crema per a untar que es fabrica amb extracte de rent i que s’obté com a subproducte en la fabricació de cervesa. Pot semblar un experiment molt simple, però els resultats han salvat la vida de milers de dones. No em creus? Deixa’m que t’ho conte.
Soc Lucy Wills. Vaig nàixer en 1888 a Royal Sutton Coldfield i em vaig llicenciar en Botànica i en Geologia en 1911 per la Universitat de Cambridge. Abans que em donara temps a dedicar-me en profunditat a aquestes ciències, l’esclat de la I Guerra Mundial em va portar a treballar com a infermera voluntària a Sud-àfrica i allà vaig descobrir la meua vocació vertadera: la medicina. Vaig tornar a Londres per tal d’estudiar a la London School of Medicine for Women i vaig aconseguir llicenciar-me en 1920. Em fascinava especialment l’hematologia, la branca que estudia la sang i els seus components,

de manera que, en comptes de dedicar-me a atendre malalts, vaig preferir concentrar-me en la investigació.
Entre 1928 i 1933 vaig treballar a Bombai, estudiant una malaltia coneguda com anèmia macrocítica que causava moltes morts entre les dones embarassades. El meu equip i jo havíem arribat a la conclusió que existia una relació entre l’alimentació de les dones i el desenvolupament de l’anèmia, de manera que vaig començar a experimentar a la recerca d’algun aliment eficaç per a contrarestar la malaltia.
Entre les moltes proves que vaig concebre, se’m va ocórrer donar Marmite a una mona en estat particularment greu. La nostra sorpresa va ser majúscula quan l’animal es va recuperar en pocs dies! Com que no sabia quin component del Marmite era el responsable de combatre l’anèmia, el vaig anomenar simplement «factor Wills». Gràcies als meus avenços, hui en dia sabem que el meu «factor Wills» és la vitamina B9, l’àcid fòlic, i hem aprés a previndre eficaçment l’anèmia administrant-lo a les dones embarassades.
60
3

Què descobriràs?
En aquesta unitat
• Lucy Wills. Una guerrera contra l’anèmia
1. L’aparell digestiu
2. La digestió
3. L’aparell respiratori
4. L’aparell circulatori
5. La circulació sanguínia
6. El sistema limfàtic i el medi intern
7. L’aparell excretor
8. La salut i la funció de nutrició
• Comprén, reflexiona i posa a prova les teues competències
En anayaeducacion.es
Per a motivar
• Vídeo: Abans de començar
• Coneix més... … Lucy Wills
Per a detectar idees prèvies
• Presentació: Què necessites saber
Per a exposar
• Infografia: La circulació sanguínia
• Presentació: La dentadura humana
• Vídeos: Una animació de la circulació sanguínia
Per a exercitar
• Activitats interactives: Aprén jugant; Posa’t a prova
• Taller de ciències: Com actua la bilis I, a més, tota la documentació necessària per a aplicar les claus del projecte.














































+ anayaeducacion.es


5.1 5.2 5.3 6.1 6.2
SEQÜÈNCIA D’APRENENTATGE

1 L’aparell digestiu
La funció de l’aparell digestiu és digerir els aliments i absorbir els nutrients.
Anatomia de l’aparell digestiu
L’aparell digestiu






L’aparell digestiu està format pel tub digestiu i per les glàndules digestives.
El tub digestiu
El tub digestiu és un conducte llarg compost per la boca, la faringe, l’esòfag, l’estómac, l’intestí prim i l’intestí gros.
- La boca. És una cavitat que conté la llengua i les dents. Les dents són unes peces dures inserides en la mandíbula que trituren els aliments. N’hi ha de quatre tipus: incisives, que tallen el menjar; canines o ullals, que l’esgarren, i les premolars i els molars, que el trituren.
- La faringe. És un conducte comú a l’aparell respiratori. Per la faringe circulen els aliments cap a l’esòfag, i l’aire des del nas o des de la boca cap a la laringe (conducte de l’aparell respiratori). A la faringe es troba l’epiglotis, una membrana cartilaginosa que impedix el pas dels aliments a la laringe.
















- L’esòfag. És un conducte envoltat d’una capa muscular, les contraccions de la qual ajuden a portar l’aliment fins a l’estómac.



- L’estómac. És un òrgan que es comunica amb l’esòfag i amb l’intestí a través dels orificis denominats càrdies i pílor, respectivament. L’obertura d’aquests orificis està regulada per músculs denominats esfínters.




En la il·lustració pots observar que hi ha certes parts marcades en color. Explica a què creus que es deu això. Després escriu en ordre tots els òrgans que recorre l’aliment des que entra per la boca fins que s’expulsa per l’anus.
- L’intestí prim. És un tub molt llarg que comunica l’estómac amb l’intestí gros. A les parets hi ha uns replecs, les vellositats intestinals, que augmenten la superfície d’absorció i estan envoltades de capillars limfàtics i sanguinis. A l’intestí prim es distingixen tres parts: el duodé, el jejú i l’ili.
- L’intestí gros. És un conducte ample que envolta l’intestí prim i arriba fi ns a l’ anus. Es dividix en tres parts: el cec, el còlon i el recte. El cec conté una prolongació sense eixida denominada apèndix.
62
Faringe
Llengua
ees
Anus
Les glàndules digestives
Les glàndules digestives vessen les seues secrecions al tub digestiu.
- Les glàndules salivals. Són un conjunt de glàndules que segreguen saliva a la boca. Hi ha tres parells de glàndules majors anomenades glàndules paròtides, glàndules sublinguals i glàndules submaxil·lars, i un conjunt gran de glàndules menors distribuïdes per tota la superfície de la boca, excepte a les genives i al paladar dur.
- El fetge. És un òrgan la funció digestiva del qual és produir la bilis, una substància que s’emmagatzema a la vesícula biliar abans de ser vessada al duodé.
- El pàncrees. És una glàndula que té la funció digestiva de segregar el suc pancreàtic i vessar-lo al duodé.
- Les glàndules gàstriques. Són cèl·lules de la mucosa gàstrica que segreguen el suc gàstric i el moc protector.
- Les glàndules intestinals. Són cèl·lules de la mucosa intestinal que segreguen el suc intestinal i el moc protector.
COMPRÉN, PENSA, INVESTIGA...
1 Definix fetge, faringe, esòfag i pàncrees
2 Enumera els tipus de dents dels éssers humans i específica per a què servix cada una.

3 Pense-m’interessa-investigue. Utilitza aquesta estratègia de pensament per a descobrir les funcions de l’apèndix i de l’epiglotis, i què passa quan no funcionen adequadament. Descobrix com aplicar aquesta estratègia en anayaeducacion.es





Alguns detalls de l’aparell digestiu




Glàndula submandibular
















63 U 3
Capil·lar limfàtic
Vellositats intestinals
Capil·lars
Fetge
Esòfag
Duodé
Sucs gàstrics
Estómac Estómac
Vesícula biliar
Duodé Pàncrees
Glàndula paròtide Dents
Llengua
Glàndula sublingual

La digestió
Una digestió difícil
Segur que alguna vegada has sentit que certs menjars són de digestió difícil, que determinats aliments provoquen gasos o que altres faciliten la digestió. Escriu dos tòpics relacionats amb la digestió i busca informació sobre la seua veracitat i amb quines substàncies i processos digestius es relacionen. Alguns exemples de tòpics que podries analitzar són:
• Els llegums provoquen gasos.
• L’encisam és indigest a la nit.
• Si pica en entrar, pica em eixir.
• Si menges espinacs, els teus excrements es fan verds.
• L’all provoca mal alé.
COMPRÉN, PENSA, INVESTIGA...
1 Explica amb les teues paraules què són els moviments peristàltics i posa dos exemples d’òrgans de l’aparell digestiu en què es produïsquen.
2 Anomena els fluids que intervenen en la digestió química.
3 Raona el tipus de nutrients que no es podrien digerir si no hi haguera:
a) Àcid a l’estómac.
b) Bilis.
La digestió és la transformació dels aliments en nutrients. Té lloc al llarg del tub digestiu i consta de diverses etapes: la digestió mecànica, la digestió química, l’absorció intestinal i la defecació.
2.1 La digestió mecànica
La digestió mecànica consistix a reduir la mida dels aliments mecànicament i moure’ls al llarg del tub digestiu.
Comprén els processos següents:
- La masticació i la insalivació. Les dents trituren l’aliment i la llengua ajuda que els aliments triturats es mesclen amb la saliva. Una vegada triturats i insalivats, els aliments es transformen en el bol alimentari.
- La deglució. És el procés en què el bol alimentari passa cap a la faringe impulsat per la llengua de forma voluntària. A continuació, el bol alimentari passa a l’esòfag i s’hi desplaça impulsat pels moviments peristàltics que realitzen els músculs de les parets del tub digestiu.
2.2 La digestió química
La digestió química consistix a transformar mitjançant reaccions químiques les grans molècules (macromolècules), com els hidrats de carboni o els lípids (greixos) en les molècules més xicotetes que les constituïxen (els nutrients).
La digestió química és la que realitzen la saliva, el suc gàstric, la bilis, el suc intestinal i el suc pancreàtic que segreguen les glàndules digestives.
- La saliva conté aigua i enzims, que trenquen els hidrats de carboni, com el midó, en altres de més senzills. És a dir, a la boca comença la digestió dels hidrats de carboni. Ací les grans molècules es transformen en fragments menors, però no se’n completa la digestió.
- El suc gàstric de l’estómac conté fonamentalment àcids clorhídrics i enzims, que trenquen les proteïnes en fragments xicotets de diversos aminoàcids.
- La bilis emmagatzemada a la vesícula biliar contribuïx a la digestió dels greixos emulsionant-los, és a dir, convertint-los en gotes xicotetes per a facilitar l’acció dels enzims.
- El suc intestinal conté enzims que transformen les proteïnes i els hidrats de carboni en nutrients.
- El suc pancreàtic conté molts enzims que digerixen els greixos i els convertixen en àcids grassos i en altres substàncies.
64 2
La transformació dels aliments en nutrients















Comença la seua digestió amb enzims de la saliva No s’alteren


No s’alteren No s’alteren

No s’alteren
2.3 L’absorció intestinal

Comença la seua digestió amb enzims dels sucs gàstrics

L’absorció dels nutrients és el procés pel qual els nutrients obtinguts en la digestió travessen la paret intestinal i passen a l’aparell circulatori per a ser repartits a totes les cèl·lules.
Com es realitza l’absorció
- A l’intestí prim es produïx l’absorció de la major part dels nutrients orgànics. Aquests travessen la membrana plàsmatica de les cèl·lules de la mucosa intestinal cap a l’interior de les vellositats intestinals, que estan envoltades d’una xarxa de capil·lars sanguinis per on passen a l’aparell circulatori.
- A l’intestí gros continua l’absorció de l’aigua i de les sals minerals, i s’hi formen les matèries fecals. En aquest tram d’intestí viuen uns bacteris que descomponen els aliments no digerits ni absorbits a l’intestí prim. Aquests bacteris, coneguts com flora intestinal, sintetitzen aminoàcids i vitamines que són absorbits pels capil·lars sanguinis.
2.4 La defecació
Les matèries fecals formades a l’intestí gros són les restes que l’organisme no pot digerir ni, per tant, absorbir. Els excrements s’acumulen al recte fins que es desencadena el mecanisme reflex de la defecació, és a dir, l’expulsió dels excrements a través de l’anus.






Acaba la seua digestió amb enzims dels sucs intestinal i pancreàtic Sucres simples

Els enzims del suc pancreàtic actuen sobre els greixos Àcids grassos



Acaba la seua digestió amb enzims dels sucs intestinals Aminoàcids
Detalls de les vellositats





A les vellositats intestinals es produïx la major part de l’absorció dels nutrients orgànics. Raona com l’estructura que es mostra en la fotografia es relaciona amb la funció que té.
65 U 3

L’aparell respiratori
COMPRÉN, PENSA, INVESTIGA...
1 Explica què són el diafragma i la pleura.
2 Descriu el camí que seguix l’aire des que entra en l’organisme fins que és expulsat.
L’aparell respiratori
Fosses nasals. Es comuniquen amb l’exterior pels orificis nasals.
Bronquis
Diafragma
La funció de l’aparell respiratori és captar l’oxigen necessari per a la respiració cel·lular i eliminar el diòxid de carboni generat en aquest procés.
3.1 Anatomia de l’aparell respiratori
L’aparell respiratori està format per les vies respiratòries i els pulmons.
Les vies respiratòries
Les vies respiratòries són un conjunt de conductes a través dels quals arriba l’aire als pulmons. A mesura que avancen cap als pulmons, els conductes es ramifiquen i són cada vegada més estrets.
Estan formades per les fosses nasals, la faringe, la laringe, la tràquea, els bronquis i els bronquíols. Els bronquíols acaben, a l’interior del pulmó, en unes estructures amb forma de sac, denominades alvèols pulmonars, les fines parets de les quals estan formades per una sola capa de cèl·lules i envoltades de capil·lars sanguinis.
Els pulmons
Els pulmons són dos òrgans d’aspecte esponjós, situats a l’interior de la caixa toràcica i separats de l’abdomen per un múscul anomenat diafragma. Estan protegits per una membrana, denominada pleura, a l’interior de la qual es troba el líquid pleural, i per les costelles.

Laringe. S’hi troben les cordes vocals.

Bronquíols
Bronquíols. Són ramificacions de dimensió reduïda que procedixen dels bronquis.

L’intercanvi gasós es produïx als capil·lars.



Alvèols pulmonar
66 3
Faringe
Tràquea
3.2 Així funciona l’aparell respiratori
L’aparell respiratori realitza la seua funció en tres etapes: la inspiració, l’intercanvi de gasos i l’expiració.
La inspiració
Té lloc quan els músculs que eleven les costelles i el diafragma es contrauen. L’acció conjunta d’aquests músculs provoca l’eixamplament de la cavitat toràcica i, per tant, l’entrada d’aire pel nas, on es calfa, s’humiteja i recorre les vies respiratòries fins als pulmons.
L’intercanvi de gasos
L’intercanvi de gasos té lloc als alvèols pulmonars i als teixits. Es realitza per difusió; és a dir, els gasos passen de forma natural travessant les membranes cel·lulars des d’on es troben més concentrats fins on són menys abundants.
Per exemple, l’aire contingut als alvèols pulmonars té més quantitat d’oxigen que la sang dels capil·lars que els envolten; per tant, l’oxigen tendix a passar a l’interior dels capil·lars. De forma semblant, el diòxid de carboni té una major concentració en la sang dels capil·lars pulmonars que l’aire de l’interior dels alvèols i tendix a passar de la sang als alvèols, i d’ací és expulsat a l’exterior.
L’expiració
Es produïx quan els músculs que eleven les costelles i el diafragma es relaxen, la cavitat toràcica reduïx el seu volum i els pulmons es comprimixen i expulsen l’aire de forma passiva per les vies respiratòries.
Mecanisme de la circulació de l’aire
La inspiració
Músculs intercostals
Mecanisme de la circulació de l’aire
Observa la imatge i contesta les preguntes següents.
a) Quines diferències hi ha entre el procés d’inspiració i el d’expiració?
b) Descriu detalladament què passa als alvèols durant l’intercanvi gasós.

c) Esbrina i descriu què passa durant l’intercanvi gasós quan es respira accidentalment aire ric en monòxid de carboni. Quines conseqüències té per a l’organisme?
L’intercanvi gasós L’expiració
Entra O2
O2 O2 Ix CO2 2
Costelles



CO2 CO2



El diafragma es contrau i els músculs eixamplen la cavitat toràcica.
Sang rica
Sang rica Músculs intercostals



El O2 passa de l’alvèol a la sang.
El CO2 passa de la sang a l’alvèol.



El diafragma es relaxa i la cavitat reduïx el seu volum.
67 U 3

L’aparell circulatori
La funció de l’aparell circulatori és transportar els nutrients i l’oxigen a totes les cèl·lules del cos i retirar d’aquestes les substàncies de rebuig procedents de l’activitat cel·lular.
L’aparell circulatori està format pel cor i pels vasos sanguinis, pels quals circula la sang, que constituïx el mitjà de transport de l’organisme.
Artèries, venes i capil·lars ? ? ? ? ? ? ? ? ?
Artèria



Les artèries porten la sang des del cor fins als teixits. Són grosses, la qual cosa els permet suportar la força amb què la sang ix del cor.
Vena



Les venes porten la sang de tornada al cor. Les seues parets són més primes i menys elàstiques que les de les artèries.
Capil·lar

Els capil·lars estan formats per una sola capa de cèl·lules. S’hi produïx l’intercanvi de gasos entre la sang i els teixits.
4.1 Els vasos sanguinis
Hi ha tres tipus de vasos sanguinis: les artèries, les venes i els capil·lars.
- Les artèries. Són vasos de secció circular, de parets grosses i elàstiques. Porten la sang del cor als òrgans. Es ramifiquen en vasos més fins.
- Les venes. Són vasos de secció oval, de parets primes i poc elàstiques. Porten la sang dels òrgans al cor. Es formen per la unió de venes xicotetes, les vènules. Tenen vàlvules que eviten el retrocés de la sang, i així faciliten que arribe al cor.
- Els capil·lars. Són vasos molt prims que comuniquen les artèries i les venes. Com que són tan fins, permeten l’intercanvi de nutrients, rebutjos i gasos entre la sang i les cèl·lules.
COMPRÉN,
PENSA, INVESTIGA...

1 L’espill. Utilitza aquesta estratègia de pensament i el seu organitzador per a comparar les característiques de les artèries i les venes. Descobrix com aplicar aquesta estratègia en anayaeducacion.es















68 4
4.2 La sang
La sang humana és un líquid viscós, roig i lleugerament salat, compost pel plasma i per les cèl·lules sanguínies.
Funcions
de la sang
La sang exercix una gran varietat de funcions al nostre organisme. Són:
- Transporta substàncies. La sang subministra a les cèl·lules els nutrients i l’oxigen que necessiten i retira d’aquestes el diòxid de carboni i els productes de rebuig del metabolisme cel·lular, i els porta fins als òrgans excretors.
- Defensa l’organisme. Els distints tipus de leucòcits, els anticossos que aquests produïxen i altres substàncies protectores defensen l’organisme d’infeccions i de lesions.
- Regula la temperatura corporal. Com que la sang circula per tot el cos, ajuda a mantindre i a distribuir la calor corporal.
Els components de la sang
El plasma sanguini
El plasma sanguini és una dissolució, formada principalment per aigua. Està composta per gasos, sals minerals i substàncies orgàniques com la glucosa, les proteïnes i les hormones.
COMPRÉN, PENSA, INVESTIGA...
2 Enumera i descriu les funcions de la sang. Quina d’aquestes funcions es pot relacionar amb els glòbuls rojos? Quina amb els glòbuls blancs?

3 La quantitat de cèl·lules d’un tipus o d’un altre en la sang és un paràmetre que s’usa per a diagnosticar distintes malalties. Esbrina com es denomina l’excés i el defecte dels tres tipus cel·lulars.
Les cèl·lules sanguínies
Els glòbuls rojos, eritròcits o hematies. Són les cèl·lules més nombroses de la sang. Són molt elàstics. Transporten O2 i CO2, gràcies a l’hemoglobina present al seu citoplasma.
No tenen nucli











Centrifugadora
Plasma Sang
En centrifugar una mostra de sang, els seus components se separen.
Els glòbuls blancs o leucòcits. Són cèl·lules amb nucli, més grans que els glòbuls rojos. Poden desplaçar-se activament per mitjà de pseudòpodes. La seua funció és la defensa de l’organisme enfront d’infeccions i de cèl·lules tumorals.







Leucòcits i plaquetes
Eritròcits
Les plaquetes o trombòcits. No són realment cèl·lules, sinó fragments de citoplasma. La seua funció és intervindre en la coagulació sanguínia.


Plaquetes activades
69 U 3
Monòcit Eosinòfil Basòfil Neutròfil Limfòcit Macròfag
8 μm aproximadament
El camí de la sang

1-2-4. Després d’eixir del cor, l’aorta es dividix en tres artèries que partixen cap a la zona superior del cos; cap a on creieu que es dirigix cada una? De quines parts del cos penseu que procedix cada una de les venes caves?
Les parts del cor
4.3 El cor
El cor és un òrgan musculós, situat a la cavitat toràcica, entre els dos pulmons.
- A l’interior, el cor presenta quatre cavitats. Les dues cavitats superiors són les aurícules, que reben la sang. Les dues inferiors són els ventricles, de parets més gruixudes, que impulsen la sang a l’exterior. Longitudinalment, el cor presenta un envà que el dividix en dues meitats i que impedix que la sang d’un costat i d’un altre es mesclen.
- A la meitat dreta, la sang procedent del cos, pobra en oxigen, entra a l’aurícula a través de les venes caves. De l’aurícula passa al ventricle, a través de la vàlvula tricúspide, que s’obri al pas de la sang i es tanca a continuació, de manera que n’evita el retrocés. La sang ix del ventricle per les artèries pulmonars, que la porten als pulmons.
- A la meitat esquerra, la sang procedent dels pulmons, carregada d’oxigen, entra a l’aurícula per les venes pulmonars. De l’aurícula passa al ventricle, a través de la vàlvula mitral. La sang ix del ventricle per l’artèria aorta per a ser distribuïda per tot el cos.
L’eixida de la sang dels ventricles, a través de les artèries més grans, està regulada per les vàlvules semilunars, que impedixen que retrocedisca.
Vena ca
Venes pulmonars


Aurícula dreta
Vena cava inf
Vàlvula tricúspide
Ventricle dret



èria aorta
Artèria pulmonar

Venes pulmonars

Aurícula esquerra àlvula mitral

Ventricle esquerre
Septe interventricular
70
L’aparell
circulatori
4
4.4 El cicle cardíac
El cor té un sistema muscular especial que li permet generar impulsos, que produïxen una contracció rítmica (el batec cardíac), i conduir aquests impulsos per tot el cos.
Cada batec cardíac es compon d’una contracció o sístole, i d’una dilatació o diàstole. Es dividix en tres etapes:
1 La sístole auricular. Les aurícules es contrauen, i impulsen la sang cap als ventricles a través de les vàlvules tricúspide i mitral, que estan obertes. Les vàlvules semilunars estan tancades.
2 La sístole ventricular. Quan la sang arriba als ventricles, aquests es contrauen. L’espenta de la sang fa que es tanquen les vàlvules tricúspide i mitral, i així s’evita que retorne a les aurícules. Simultàniament, s’obrin les vàlvules semilunars, que permeten que la sang isca per les artèries. Aquesta eixida és intermitent i es percep com el pols cardíac.
3 La diàstole general. Les aurícules i els ventricles es relaxen. Les vàlvules semilunars es tanquen. La sang entra a les aurícules a través de les venes. Els ventricles, també dilatats, comencen a rebre sang de les aurícules quan les vàlvules mitral i tricúspide s’obrin.
Les fases del cicle cardíac



Sístole auricular. Les aurícules es contrauen i la sang passa als ventricles.


COMPRÉN, PENSA, INVESTIGA...
4 Definix sístole i diàstole
5 Enumera els moviments del cor i explica quina és la conseqüència de cada un.

6 Esbrina a què es deuen els sons del cor que es poden sentir en una auscultació.

Sístole ventricular. Els ventricles es contrauen i la sang ix per les artèries.


Diàstole general. Les aurícules i els ventricles estan relaxats. La sang entra a les aurícules, i comença a passar als ventricles. Una nova sístole auricular impulsa la sang a les aurícules, els ventricles s’acaben d’omplir i el cicle es tanca.
71 U 3
2 3

La circulació sanguínia
El viatge mític de la Brisa. De Corpus a Pululung
A la ciutat de Corpus és un honor formar part dels portadors de brisa, i un nou grup de valents i valentes es prepara per a enfrontar-se a l’aventura del viatge a Pululung. Guia’ls en el seu camí perquè puguen complir la seua missió i els engranatges de Corpus continuen funcionant.
Llig el text de la missió i completa aquestes tasques:
- Dibuixa el camí que seguix el grup d’aventurers i aventureres.
- Després, canvia els noms dels llocs per parts del sistema circulatori perquè es descriga el recorregut que fa la sang a través del cos.
- Escriu què creus que és la brisa i per què és tan important per a Corpus.
Per a complir amb la missió, el grup d’aventurers i aventureres haurà de seguir aquest camí:
- La recerca de la brisa comença a l’Atri del Destí, on els últims portadors de Brisa acaben, cansats, el seu viatge.
- Els nous herois i heroïnes hauran d’obrir les portes de triple fulla de la Veritat Testarruda per començar el viatge.


La circulació sanguínia descriu el recorregut de la sang des que ix del cor fins que hi torna. En les persones, aquesta circulació és doble, és a dir, seguix dos circuits: el pulmonar i el general.
- Arribaran al Vehicle Daurat, que els farà passar a través de les portes del Valor Sufocat i recórrer els camins de l’Aridesa Perdurable.
- Els camins de l’Aridesa Perdurable els conduiran fins a Pululung, la Casa de la Brisa on descansaran i es renovaran gràcies a la brisa que carregaran i protegiran en les seues motxilles.
- La brisa s’ha de transportar ràpidament fins a l’Atri Immaculat a través de les Vies Polsegoses.
- Si el grup transporta la suficient brisa fins a l’Atri Immaculat, s’obriran les portes de la Veritat Material i podran arribar fins al Vehicle Immaculat.
- Amb el Vehicle Immaculat en marxa, s’obriran les portes de la Veritat Silent, que permetrà que la brisa siga transportada per les Àrees Àuries per a distribuir-se per tot Corpus.
- L’ús de la brisa a Corpus deixa residus que els herois i heroïnes hauran de transportar de tornada a l’Atri del Destí, on el seu viatge tornarà a començar en un cicle sense fi.

Si necessites alguna pista, consulta els recursos «La circulació sanguínia» i «Una animació de la circulació sanguínia» en anayaeducacion.es.
72 5


El sistema limfàtic i el medi intern
El sistema limfàtic
Ganglis limfàtics




6.1 El medi intern
Com ja has estudiat en la unitat 1, les cèl·lules de l’organisme no poden realitzar intercanvis de nutrients i rebutjos directament amb el medi extern, per la qual cosa necessiten un medi intern per a poder fer-los. En l’ésser humà, el medi intern està format per la sang, el líquid intersticial i la limfa.
- El líquid intersticial és el medi que envolta les cèl·lules i amb el qual intercanvien directament les substàncies que necessiten i produïxen.
- La limfa és un líquid de color clar que es forma a partir del plasma intersticial i que circula a través d’un segon sistema circulatori: el sistema limfàtic.






Cor Vasos limfàtics


Melsa
Capil·lars limfàtics
6.2 El sistema limfàtic
El sistema limfàtic és un sistema que no té bomba impulsora. La limfa es desplaça quan, en moure’ns, els músculs esquelètics que envolten els vasos limfàtics es contrauen.
Està format pels capil·lars limfàtics, els vasos limfàtics i els ganglis limfàtics.
- Els capil·lars limfàtics són conductes de grandària molt reduïda que desemboquen en la majoria dels teixits de l’organisme.












Detall d’un gangli limfàtic

Lloc on es fabriquen els glòbuls blancs
- Els vasos limfàtics són semblants a les venes i recullen la limfa dels capil·lars. Aquests vasos desemboquen en el sistema circulatori sanguini.
- Els ganglis limfàtics són uns nòduls que es troben al llarg dels vasos limfàtics i la funció que tenen és filtrar la limfa i produir els glòbuls blancs.
Vasos limfàtics
COMPRÉN, PENSA, INVESTIGA...
1 Explica les diferències entre capil·lars, vasos i ganglis limfàtics.
2 Explica què és i com es mou la limfa a través dels ganglis i dels vasos limfàtics.
3 Raona si el sistema limfàtic té alguna funció que no estiga directament relacionada amb la nutrició.

4 Esbrina el nom del principal vas limfàtic i explica com es comunica amb el sistema circulatori.
73 U 3 6

L’aparell excretor
L’aparell excretor
Renyons
Vena cava inferior



Artèria
Artèria







Detall d’un renyó













Glomèrul
Escorça renal
Medul·la renal
La funció de l’aparell excretor consistix a eliminar les substàncies de rebuig, procedents de l’activitat cel·lular, que poden resultar tòxiques per a les cèl·lules.
7.1 Anatomia de l’aparell excretor
L’aparell excretor està format pels renyons i les vies urinàries.
Els renyons
Són dos òrgans amb forma de fesol situats a la zona lumbar, a un costat i a l’altre de la columna vertebral.
S’encarreguen de filtrar i de netejar la sang, i formen l’orina. En un tall longitudinal del renyó s’aprecien les zones següents:
- L’escorça o zona externa, de color rogenc i aspecte granulós. Les principals funcions que té són la filtració de la sang i la reabsorció de substàncies recuperables de l’orina.
- La medul·la, dividida en sectors amb forma de piràmide. És el lloc on es forma l’orina.
- La pelvis renal, cavitat en forma d’embut on desemboquen totes les piràmides i que s’encarrega d’arreplegar l’orina formada.
La nefrona
En cada renyó hi ha més d’un milió d’estructures microscòpiques anomenades nefrones. Cada nefrona consta d’un glomèrul, format per un cabdell de capil·lars sanguinis envoltats de la càpsula de Bowman, que continua amb un túbul renal, que desemboca, junt amb els d’altres nefrones, en un tub col·lector.
Les vies urinàries


Túbul renal

Càpsula de Bowman



Tub col·lector
S’encarreguen de transportar l’orina des del renyó fins a l’exterior. Aquestes vies són els urèters, la bufeta urinària i la uretra.



Nansa de Henle (part del túbul renal)



- Els urèters són conductes que partixen de la pelvis renal i porten l’orina de forma contínua fins a la bufeta urinària, l’òrgan musculós on s’emmagatzema. Quan la bufeta està plena, apareix la necessitat d’orinar, i és la uretra el conducte per on l’orina ix a l’exterior. La bufeta pot emmagatzemar entre 200 i 300 mL d’orina.
74 7
renal Vena renal Pelvis renal Urèter
Nefrona
7.2
La formació de l’orina
Càpsula de Bowman




1 La filtració. Té lloc al glomèrul on, a través de les parets dels capil·lars, es filtren aigua i molècules xicotetes dissoltes, com ara sals minerals, glucosa, aminoàcids o substàncies tòxiques. El filtrat glomerular s’arreplega a la càpsula de Bowman i comença a circular pel túbul renal.



Tub col·lector



Xarxa de capil·lars
2 La reabsorció. Al llarg del túbul renal, la majoria dels components del filtrat glomerular són reabsorbits, i passen novament a la sang. Es reabsorbix el 98 % de l’aigua, tota la glucosa i els aminoàcids, i gran part de les sals minerals.
7.3 Altres òrgans excretors
En el procés d’excreció participen altres òrgans, com:
- Els pulmons, que expulsen a l’exterior el diòxid de carboni produït durant la respiració cel·lular.
- Les glàndules sudorípares, que, distribuïdes per tota la pell, excreten la suor a través dels porus. La suor és un líquid semblant a l’orina diluïda, que es produïx per filtració de la sang dels capil·lars pròxims a la glàndula. A més de ser un producte d’excreció, té una funció termoreguladora, ja que, en evaporar-se sobre la pell, absorbix calor i disminuïx la temperatura corporal.
- El fetge. A més d’intervindre en la digestió i en altres processos metabòlics, actua com a òrgan d’excreció d’algunes substàncies, com els pigments biliars que procedixen de la degradació dels eritròcits, o determinats fàrmacs, que s’excreten amb la bilis.




L’orina és un líquid format per aigua i torma substàncies de rebuig. tàncies de r subs ebuig. Es fabrica a les nefrones . abrica nefrones . f

Cap als urèters
3 La secreció. Té lloc a l’última part del túbul renal. Algunes sals passen dels capil·lars a l’interior del túbul, i formen l’orina, que s’aboca al tub col·lector.
L’orina formada passa de les nefrones a la pelvis renal i d’ací a l’urèter, que la conduïx fins a la bufeta, on es manté fins que s’expulsa.
COMPRÉN, PENSA, INVESTIGA...
1 Enumera les parts de l’aparell excretor.
2 Dibuixa un esquema d’un renyó i indica-hi l’escorça, la medul·la i la pelvis renal.
3 Definix orina i explica’n el procés de formació.

4 Pensa i compartix en parella. Discutix si la creença segons la qual suar aprima té sentit biològic o és falsa. Aprén a usar aquesta estratègia de pensament en anayaeducacion.es
75 U 3
1 2 3
Glomèrul
Nansa de Henle

La salut i la funció de nutrició
8.1 Malalties relacionades amb l’aparell digestiu
Els òrgans que componen l’aparell digestiu són molt diversos, per la qual cosa també ho són les malalties que s’hi produïxen. Algunes de les més comunes són:
- La càries dental és un procés de destrucció de les dents degut a l’activitat de bacteris.
- La gastroenteritis és una inflamació de la mucosa gàstrica i de l’intestí prim, a causa de virus, bacteris i altres paràsits.
- L’apendicitis és la inflamació de l’apèndix a causa d’una infecció bacteriana.
- L’hepatitis és la inflamació del fetge deguda a una infecció vírica o a substàncies tòxiques, com l’alcohol o alguns fàrmacs.
- La pancreatitis és la inflamació del pàncrees. Pot estar causada per la formació de càlculs biliars o pedres a la vesícula, que bloquegen els conductes biliars, o per l’alcoholisme.
Els riscos del tabac






Segons dades de l’Organització Mundial de la Salut, huit milions de persones a l’any moren com a conseqüència del tabac i aproximadament la meitat de les persones que fumen moriran a causa del tabaquisme.
Què creus que representa aquesta imatge? Fent-la servir com a inspiració, dissenyeu una campanya d’informació sobre els riscos del tabac per a la salut.
8.2 Malalties relacionades amb l’aparell respiratori
Les vies respiratòries i els pulmons estan contínuament exposats a microorganismes, a contaminants ambientals, a agents al·lergògens i a canvis de temperatura que, ben sovint, causen les malalties. Algunes d’aquestes malalties són:
- El refredat i la grip afecten les vies respiratòries superiors. Solen ser lleus i de curta durada.
- La pulmonia i la pneumònia afecten els alvèols pulmonars i hi produïxen una inflamació. Poden arribar a ser molt greus.
- L’asma és l’obstrucció de les vies respiratòries, deguda a l’estretiment causat per una contracció excessiva de la musculatura dels bronquis. En la majoria dels casos, és una malaltia produïda per allèrgies al pol·len, a la pols, etc. En altres casos, es deu al tabac, a la contaminació o a l’aire fred.
- La bronquitis crònica és la inflamació dels bronquis i l’obstrucció de les vies respiratòries quan la mucosa està danyada. La majoria de les bronquitis estan causades pel fum del tabac.
COMPRÉN, PENSA, INVESTIGA...
1 Escriu quines de les malalties respiratòries i digestives d’aquest apartat poden ser causades per virus o bacteris.

2 Actualment, hi ha definits diversos tipus d’hepatitis; busca quins són i quines en són les causes.
3 Raona per què algunes persones amb asma o amb al·lèrgies greus han d’usar màscares i ulleres protectores.
76 8
8.3
Malalties relacionades
amb l’aparell circulatori
Aquestes malalties poden afectar la sang o les vies sanguínies i el cor. Aquestes dues últimes es coneixen amb el nom de malalties cardiovasculars.
Les malalties que afecten la sang
Són malalties que generalment tenen l’origen en un mal funcionament de la medul·la òssia roja, que és la responsable de la formació de les cèl·lules sanguínies. Algunes d’aquestes malalties són:
- La leucèmia es caracteritza per una producció i acumulació incontrolada de leucòcits, que envaïxen els teixits i formen tumors. Els leucòcits no són madurs, per la qual cosa no exercixen la seua funció defensiva, i apareixen infeccions.
- L’anèmia es produïx per un dèficit de glòbuls rojos, per la qual cosa el transport d’oxigen per la sang es veu disminuït. S’associa amb fatiga, pal·lidesa o vertígens en realitzar moviments bruscos. Es pot deure a l’alteració o a la destrucció elevada d’eritròcits.
- L’hemofília és una malaltia hereditària, que es deu al dèficit de factors de coagulació, per la qual cosa es produïxen hemorràgies espontànies o degudes a traumatismes xicotets.
Les malalties cardiovasculars
Algunes d’aquestes malalties poden ser hereditàries, però la majoria estan relacionades amb hàbits no saludables. Les més habituals són:
- La trombosi és el tapament d’un vas sanguini per un coàgul o trombe. Pot ser més o menys important segons el vas sanguini afectat.
- L’angina de pit es deu a una insuficiència en el subministrament d’oxigen al cor, generalment a causa d’un trombe. Es manifesta per un dolor fort al pit en realitzar un esforç, i sol durar pocs minuts.
- L’infart de miocardi es deu a un trombe a les artèries coronàries. El teixit cardíac es queda sense oxigen i mor. Es manifesta com una angina de pit però de diverses hores de durada i amb dolor al braç esquerre.
- L’arteriosclerosi es produïx pel depòsit de plaques de colesterol a les parets internes de les artèries. Això dificulta la circulació i afavorix la formació de coàguls o trombes.
COMPRÉN, PENSA, INVESTIGA...

4 Roda lògica. Tria entre la leucèmia, l’anèmia i l’hemofília i usa aquesta estratègia de pensament per a explicar quines són les causes possibles d’aquestes malalties, com es desenvolupen i els tractaments que tenen. Aprén a usar aquesta estratègia de pensament en anayaeducacion.es
L’infart de miocardi








El depòsit de colesterol a les parets internes de les artèries dificulta la circulació sanguínia i facilita la formació de trombes. Si un trombe arriba al cor, pot produir un infart de miocardi. èries

77 U 3
onàries
Anticoagulant



8.4 Malalties relacionades amb el sistema limfàtic
Aquestes malalties afecten els ganglis i els vasos limfàtics. Tenen un origen divers i poden ser greus. Algunes d’aquestes malalties són:

Fluids
diàlisi





Bomba de sang

Dialitzador (renyó artificial)
Drenatge del fluid inservible

- Les adenopaties, en general, són inflamacions d’un o més ganglis limfàtics i apareixen després de la infecció d’una zona pròxima.
- La limfangitis aguda és una inflamació dels vasos limfàtics, produïda per bacteris.
8.5 Malalties relacionades amb l’aparell excretor
Les principals malalties lligades a l’aparell excretor són:

Fístula arteriovenosa

- La formació de càlculs renals o pedres es produïx per precipitació d’algunes sals en l’orina, generalment per ingerir una quantitat insuficient d’aigua en la dieta. Quan els càlculs ixen pels urèters, freguen les seues parets i produïxen un dolor sobtat de gran intensitat conegut com a còlic nefrític.

La sang torna al pacient.


- La cistitis és una inflamació de les parets de la bufeta urinària, provocada per una infecció bacteriana, un agent químic o una lesió. Sol provocar dolor o coentor en orinar, una necessitat que arriba a ser molt freqüent, fins i tot després d’haver buidat la bufeta.

Trampa de bambolles

Algunes persones que patixen insuficiència renal s’han de sotmetre a un procés d’hemodiàlisi. En aquest procés es fa passar la sang del pacient a través d’un filtre artificial que depura la sang i normalitza la seua composició perquè puga tornar a l’organisme.
Per a poder realitzar l’hemodiàlisi en pacients amb insuficiència renal crònica, és necessària la creació quirúrgica d’una fístula arteriovenosa. En aquest procediment s’unixen una artèria i una vena amb el fi d’eixamplar el lloc on es punxaran les agulles de diàlisi i afavorir així el flux sanguini.
Aquests pacients solen necessitar tres sessions de diàlisi a la setmana, que duren entre tres i quatre hores cada una.
- La insuficiència renal és una disminució o una interrupció de la funció de filtració del renyó, la qual cosa dona lloc a un augment de la quantitat d’urea en la sang. Es produïx l’enverinament sanguini, amb símptomes d’intoxicació, alteracions nervioses i cardiovasculars. El malalt d’insuficiència renal ha de ser tractat amb hemodiàlisi, en una màquina que actua com un renyó artificial. Quan la insuficiència és crònica, es procedix a un trasplantament de renyó.
L’hemodiàlisi
Observa la imatge i llig el text relacionat amb l’hemodiàlisi. Després, descriu com creus que és el dia a dia d’una persona amb insuficiència renal crònica. Creus que podrà treballar o anar de vacances de forma normal? Com creus que se sentirà en el seu dia a dia? Com creus que podria millorar la seua qualitat de vida?
78
La salut i la funció de nutrició
8
8.6
Hàbits saludables
Moltes de les malalties que afecten els aparells que intervenen en la nutrició poden previndre’s seguint una sèrie d’hàbits saludables relacionats amb l’estil de vida.
Hàbits saludables relacionats amb l’aparell digestiu
Per a protegir i cuidar el nostre aparell digestiu, hem de:
- Portar una dieta equilibrada i evitar els excessos.
- Moderar el consum de sal, café, te, xocolate i salses coentes.
- Evitar l’alcohol i el tabac.
- Menjar lentament, mastegant bé els aliments, i distribuir la ingesta en quatre o cinc menjades, preferentment a les mateixes hores.
- Evitar el sedentarisme i l’estrés.
- Mantindre una bona higiene dental.
- Llavar-se les mans per a manipular els aliments i abans de menjar.
Hàbits saludables relacionats amb l’aparell respiratori
Per a protegir i cuidar el nostre aparell respiratori, es recomana:
- No fumar. El consum de tabac es relaciona amb moltes malalties, entre les quals destaca el càncer de pulmó, la primera causa de mortalitat per càncer en els homes i la tercera en les dones.
- Evitar ambients contaminats.
- Respirar pel nas i protegir del fred les vies respiratòries.
- Tapar-se la boca i el nas durant l’esternut o la tos.
Hàbits saludables relacionats amb l’aparell circulatori
Per a protegir i cuidar el nostre aparell circulatori, hem de:
- Fer exercici físic.
- Portar una dieta sana i equilibrada.
- Evitar ambients amb fum de tabac.
- Intentar portar una vida sense estrés.
Hàbits saludables relacionats amb l’aparell excretor
Per a protegir i cuidar el nostre aparell excretor, és necessari:
- Beure líquid abundant, preferiblement aigua, per a evitar la concentració de l’orina i la formació de càlculs.
- Portar una dieta equilibrada, sense abusar d’aliments salats.
- Evitar el consum d’alcohol i d’altres substàncies tòxiques que el fetge depura, i que pot resultar danyat si treballa en excés.
- Mantindre la higiene de les vies urinàries.
- Orinar sovint, evitant mantindre durant molt de temps la bufeta plena.
Hàbits saludables
En equips, trieu un dels aparells del sistema digestiu i elaboreu una campanya de conscienciació per a promocionar els hàbits saludables per a aquest aparell. La campanya ha de tindre els elements següents:
• Un eslògan.
• Un element gràfic que pot ser un cartell, un tríptic, un fanzín, etc.
• Un element audiovisual en format de vídeo; pot ser un anunci, un curtmetratge, un monòleg, etc.
• Un anunci pensat per a incloure’l en un format que siga només d’àudio, com un podcast o la rà- t dio.




Una de les recomanacions per a previndre malalties relacionades amb l’aparell respiratori és protegir del fred les vies respiratòries.



Una de les recomanacions per a previndre malalties relacionades amb l’aparell excretor és beure almenys un litre i mig d’aigua al dia.
79 U 3











COMPRÉN




Organitza les idees
1 Diagrama de Venn. Completa en el quadern els espais buits del diagrama de Venn següent sobre els hàbits saludables per als aparells digestiu, respiratori i circulatori. Aprén a fer-los amb el recurs disponible en anayaeducacion.es
Aparell digestiu
– Mastegar bé els aliments
– Bona higiene dental –?
Aparell respiratori
– Respirar pel nas
– Tapar-se la boca en esternudar –?
Fes un resum
Aparell circulatori
– Evitar ambients amb fum de tabac. –? ?
2 Elabora el teu resum de la unitat seguint aquest guió.
• Anomena els aparells implicats en la funció de nutrició i indica de què s’encarrega cada un.
• Descriu l’anatomia del tub digestiu i anomena les glàndules que hi aboquen el seu suc.
• Explica en què consistix la digestió i diferencia entre la digestió química i la mecànica.
• Explica en què consistixen l’absorció i la defecació.
• Descriu l’anatomia de l’aparell respiratori.
• Explica com i on es produïx l’intercanvi de gasos.
• Indica els components i les funcions de la sang.
• Descriu l’anatomia del cor i explica el cicle cardíac.
• Anomena els tipus de vasos sanguinis i com es produïxen la circulació major i la menor.
• Explica què és i com funciona el sistema limfàtic.
• Descriu l’anatomia de l’aparell excretor i explica on i com es forma l’orina.
• Comenta les principals malalties relacionades amb els aparells i sistemes que intervenen en la funció de nutrició.






Interpreta imatges
3 Observa i contesta.












a) Quin aparell del cos humà es representa en la imatge?
b) Indica cada una de les parts senyalades i explica’n breument la funció.
c) Tots els òrgans que apareixen en les imatges són del mateix aparell o sistema? Justifica la resposta.
4 Copia i completa en el quadern l’esquema del cor humà següent. Després, contesta les preguntes.




a) Anota quin teixit constituïx fonamentalment aquest òrgan i quines característiques presenta.
b) Senyala en el dibuix per on entra i per on ix la sang i indica cada una de les parts senyalades.
c) Per què es representa en blau una part del cor i l’altra en roig?
B J F A I E C G D H
B F A I E C G D H

Recorda que en el banc de recursos disposes de:

• de diversos tallers per a gestionar les teues emocions i d’una diana per a avaluar-les;
Aplica
5 Explica per què és important la microbiota intestinal.
6 Establix les diferències entre:
a) Ingestió i digestió.
b) Inspiració i expiració.
c) Sístole i diàstole.
d) Limfa i sang.
e) Renyó i nefrona.
7 Per què és necessari que els alvèols pulmonars estiguen humits? Ix vapor d’aigua per la teua boca quan exhales aire?
8 Establix les diferències entre artèries, venes i capillars sanguinis.
9 Descriu el recorregut d’una molècula d’oxigen des que entra per les fosses nasals fins que arriba al cor.
10 Explica els processos que tenen lloc en una nefrona per a formar l’orina.
11 Escriu almenys tres hàbits saludables per a evitar un infart de miocardi i tres més per a previndre el càncer de pulmó.
12 Explica per què és important:
a) Llavar-se les mans abans de manipular els aliments.
b) Menjar lentament mastegant bé els aliments.
c) Ingerir una bona quantitat d’aigua al llarg del dia.
REFLEXIONA
Aspectes Totalment aconseguit
Identifique el regne a què pertanyen els organismes de la meua nevera i diferencie parts d’aquests.
Bastant aconseguit
POSA A PROVA LES TEUES COMPETÈNCIES
• de fitxes per a millorar la teua ciutadania digital.

Avança

13 El pa està elaborat amb farina (glúcids complexos i proteïnes), oli i aigua. Descriu el recorregut d’un tros de pa des de la boca fins que és totalment digerit i els nutrients són absorbits. Indica què passa en cada secció del tub digestiu.
14 Analitza la taula sobre la composició de la sang i l’orina, contestant les preguntes següents.
a) Quines substàncies es troben en major proporció en el plasma sanguini que en l’orina, i al revés?
b) A què es deuen aquestes diferències?

c) Investiga sobre alguna malaltia que provoque l’aparició de glucosa en l’orina.
En aquesta unitat has identificat els nutrients presents en el menjar que porteu a classe. A més, has creat un sistema de classificació d’aliments i has usat els teus coneixements per a dissenyar dietes sanes i nutritives. Reflexiona sobre el teu aprenentatge omplint el qüestionari i la rúbrica, disponibles en anayaeducacion.es
AconseguitQuasi aconseguit
Fes l’autoavaluació competencial inclosa en anayaeducacion.es


U 3
Recorda seleccionar el material de treball d’aquesta unitat per al dossier d’aprenentatge.
Plasma sanguini % Aigua 95 90 Urea 2 0,03 Àcid úric 0,05 0,004 Glucosa 0 0,1 Proteïnes 0 8 Sals 1,5 0,72 Altres substàncies 1,45 1,15






















DOSSIER D’APRENENTATGE













SUPERXEFS
Per comprovar si la informació recollida en els tríptics ha promogut un canvi d’hàbits, pots tornar a analitzar els costums alimentaris dels teus companys i companyes unes setmanes després. Comprova quins aliments porten per a l’esplai i compara la informació amb la que vas recollir al principi del projecte.
Les conclusions de comparar l’evolució dels costums al teu centre servirà per a comprovar si hi ha hagut un impacte positiu de la vostra intervenció, i en aquest cas, potser voldràs estendre aquesta pràctica a altres nivells o difondre-la en xarxes perquè es faça en altres centres. També és possible que no s’haja produït un impacte significatiu. En aquest cas, seria interessant analitzar les raons per les quals no ha funcionat i plantejar reptes nous que es dirigisquen a obtindre resultats millors. I l’últim escenari possible és que us trobeu amb dades pitjors que les inicials; si fora així, podeu reflexionar sobre quins aspectes del projecte hi han pogut influir i quins canvis es podrien introduir per a evitar-ho.
A més d’aquesta anàlisi d’impacte, les conclusions extretes en aquest projecte es poden ampliar amb una anàlisi de les diferències en l’alimentació a gran escala. Com és possible que 690 milions de persones al món no tinguen aliments suficients, mentre que en altres llocs del planeta es malgasten cada dia milers de tones d’aliments?
Et proposem veure el documental «Taste the waste» i recollir dades per a establir un debat a classe, prenent com a estímul aquesta afirmació: «La fam és conseqüència directa d’un sistema alimentari injust».









TRIMESTRE 1
TAMBÉ POTS PROVAR AQUESTS PROJECTES
Si aquest projecte t’ha resultat interessant i vols investigar més sobre la funció de nutrició, ací tens algunes idees per a crear els teus projectes.
Estudi de la teua dieta setmanal
Repartits per parelles, cada alumne o alumna pot analitzar el menjar que ha consumit un company o una companya al llarg d’una setmana, analitzant de nou nutrients i oferint propostes de millora.
Concurs al teu centre: «Snacks saludables»
A més d’investigar, dissenyar i escriure sobre dietes saludables, podem proposar a l’alumnat que dissenye i cuine snacks sans i nutritius. Un concurs de cuina amb jurat i premis pot ser un gran incentiu per a fomentar la creativitat basada en criteris científics. Els snacks es poden elaborar a casa (gravant vídeos o portant el resultat a classe) o, si és possible, a les instal·lacions del centre.
Col·laboració amb centre de salut o hospital pròxim
El centre de salut és un lloc on es promouen els bons hàbits de vida, ja que aquests prevenen l’aparició de moltes malalties. A més, allà acudixen persones de l’entorn, de totes les edats i característiques socials, per la qual cosa és un lloc ideal per a proposar una collaboració; per exemple, repartint els tríptics elaborats per l’alumnat.
Estudi de la dieta proposada al menjador escolar
Fes un estudi nutricional sobre els productes d’un menjador o cafeteria escolar. Elabora una proposta de dieta saludable. Es pot fer una infografia final a manera de cartell amb les conclusions obtingudes i amb la dieta alternativa elaborada.
REVISA LA TEUA PLANIFICACIÓ I EL TREBALL EN GRUP
Revisa la teua planificació del treball i el treball del teu grup en aquest projecte omplint la rúbrica que pots trobar en anayaeducacion.es
PERFIL COMPETENCIAL D’EIXIDA
En finalitzar aquests desafiaments, reflexiona i comprova si has aconseguit els objectius següents:
Descriptor
Utilitze el pensament científic i comprove hipòtesis per mitjà de l’experimentació i la indagació.
He desenvolupat hàbits de vida saludables relacionats amb la nutrició.
Conec la importància de la meua participació en la promoció de la salut pública a través de l’alimentació.
Emprenc accions amb fonament científic per a preservar la meua salut i la del meu entorn.
Expresse conceptes i pensaments científics de forma adequada.
Use el pensament científic per a entendre i explicar fenòmens.
Use eines digitals per a crear continguts i compartir-los.




Aconseguit Parcialment aconseguit No aconseguit
Completa en el quadern



























PRESENTACIÓ DE LA SITUACIÓ















Unitat 4















L’accident A l’hospital Pensant a ampliar la família


L’embaràs i el part A l’hospital Les conseqüències de l’accident

Unitat 5
1
DE LA
SALUT BENESTAR
REDUCCIÓ DE DESIGUALTATSLES
FI
POBRESA 3
10
TRIMESTRE 2




ÉS UNA EMERGÈNCIA!


De què depén la nostra salut?



Unitat 6

Una malaltia més?

Primers auxilis




Fem una anàlisi DAFO de tres sistemes sanitaris





Escrivim un informe


Presentem l’informe











La funció de relació
RITA LEVI-MONTALCINI.
La dama de la neurona
Al meu entendre, si realment creus en alguna cosa, has de lluitar per aconseguir-la. Al llarg dels meus 103 anys de vida vaig haver de lluitar per moltes coses. Pel meu dret a estudiar, per la meua vida, per la meua investigació... No puc dir que sempre isquera victoriosa, però crec que sí que vaig guanyar algunes batalles que van suposar una gran contribució a la medicina i a la societat.
Em dic Rita Levi-Montalcini. Vaig nàixer a Itàlia, a la ciutat de Torí, en 1909. De jove, vaig haver de convéncer mon pare que no tenia cap interés a dedicar la meua vida a casar-me i a tindre fills. El que realment desitjava era estudiar medicina i ajudar altres persones. I això vaig fer! Vaig treballar en forns per a pagar-me la carrera i en 1936 em vaig graduar en l’especialitat de neurologia i psiquiatria.
La cosa es va tòrcer en 1943. Ens vam veure obligats a fugir. La meua família era jueua, i per tant susceptible de ser perseguida pel règim nazi, la influència del qual s’estenia per Europa. Vam escapar primer de Torí a Bèlgica. Després, en tornar a Itàlia, a Piemont, i finalment, a Florència, fins que va concloure la II Guerra Mundial. Jo no podia
permetre’m interrompre la meua investigació, que estava molt avançada, de manera que durant aquesta època vaig treballar en secret muntant laboratoris clandestins.
M’interessava especialment la manera en què es desenvolupa el sistema nerviós. Com saben les neurones quan s’han de reproduir? En acabar la guerra, em van invitar a treballar uns mesos a la Universitat de Washington, de manera que vaig fer les maletes i em vaig emportar el meu treball als EUA, on vaig acabar passant 30 anys i vaig aconseguir aïllar, junt amb el meu col·lega Stanley Cohen, el NFG: el factor de creixement neuronal. Aquesta és la proteïna que dona a les neurones l’ordre de reproduir-se, i per descobrir-la ens van concedir el Premi Nobel de Medicina en 1986.
Durant tota la meua vida vaig defensar que homes i dones tenim la mateixa capacitat intel·lectual i que, per tant, podem contribuir de la mateixa manera a l’avanç de la humanitat. Espere que algun dia el meu treball es puga usar per a curar malalties nervioses com l’alzhèimer o la demència. Si és així, tota la meua lluita haurà valgut la pena.
86
4

Què descobriràs?
En aquesta unitat
• Rita Levi-Montalcini. La dama de la neurona
1. La relació en l’ésser humà
2. La percepció: els sentits
3. La percepció i la salut
4. La coordinació nerviosa
5. La salut del sistema nerviós
6. La coordinació endocrina
7. La salut del sistema endocrí
8. Les drogues i la drogoaddicció
9. L’execució de la resposta. L’aparell locomotor
10. L’execució de la resposta i la salut
• Comprén, reflexiona i posa a prova les teues competències
En anayaeducacion.es
Per a motivar
• Vídeo: Abans de començar
• Coneix més... Rita Levi-Montalcini
Per a detectar idees prèvies
• Presentació: Què necessites saber
Per a exposar
• Presentació: Els tipus de llàgrimes
• Vídeos: L’esquelet; La musculatura; Hàbits posturals
Per a exercitar
• Activitats interactives: jugant; Posa’t a prova
• Taller de ciències: Busca pareidolies
I, a més, tota la documentació necessària per a aplicar les claus del projecte.






























SEQÜÈNCIA D’APRENENTATGE

















+ anayaeducacion.es


4.1 4.2 5.1 5.2 6.1 6.2 6.3

La relació en l’ésser humà
Un món d’estímuls
Dedica dos minuts a concentrar-te, intenta ser conscient de tots els estímuls que reps durant aquest temps i escriu-ne una llista. Després, contesta les qüestions següents:
a) És molt difícil ser conscient de tots els estímuls que rep el nostre cervell. Intenta pensar en aquests dos minuts i analitza si se’t pot haver escapat anotar algun estímul.
b) Classifica els estímuls que has anotat segons l’òrgan dels sentits que l’ha captat. De quins n’hi ha més? De quins n’hi ha menys? A què creus que es poden deure les diferències?
c) Compara les respostes amb les dels companyes i companys i comprova les diferències. A què es deuen?
COMPRÉN, PENSA, INVESTIGA...
1 Escriu dos exemples d’òrgans que perceben estímuls, dos que elaboren respostes i dos que executen respostes.
2 Explica de forma breu i amb un exemple com es duu a terme la funció de relació en els éssers humans.
La funció de relació és la que permet a l’ésser humà detectar canvis en el medi i respondre-hi.
Es realitza per mitjà de tres processos: la percepció de l’estímul, l’anàlisi de la informació i l’elaboració de la resposta, i l’execució de la resposta.
1.1 La percepció dels estímuls
La percepció dels estímuls és el que realitzen els receptors, que són cèl·lules especialitzades a detectar aquests canvis; és a dir, a detectar canvis físics i químics de l’entorn i enviar aquesta informació als centres de coordinació.
Els receptors poden ser cèl·lules aïllades o estar agrupats formant òrgans com l’ull o l’orella.
1.2 L’anàlisi de la informació. L’elaboració de la resposta
L’elaboració de les respostes té lloc als centres de coordinació, la funció dels quals és analitzar la informació que reben els receptors i elaborar una resposta per a enviar als òrgans efectors.
Els centres de coordinació del nostre organisme són:
- El sistema nerviós està format per un conjunt d’òrgans, com l’encèfal o la medul·la espinal, que envien les respostes als òrgans efectors en forma d’impulsos nerviosos, que permeten coordinar respostes ràpides i breus, com la contracció i la relaxació dels músculs, que provoquen els moviments.
- El sistema endocrí està format per un conjunt d’òrgans denominats glàndules endocrines, com el pàncrees o la tiroide, que envien les respostes als òrgans efectors, a través de la sang, en forma de substàncies químiques anomenades hormones, que les mateixes glàndules sintetitzen.
L’execució de la resposta
Els efectors són òrgans la funció dels quals és executar les respostes. Els òrgans efectors són:
- Els músculs, que, en rebre l’ordre de contracció o de relaxació per mitjà d’impulsos nerviosos, poden realitzar moviments voluntaris com alçar un braç, o involuntaris, com els moviments peristàltics de l’intestí.
- Les glàndules, que sintetitzen i vessen substàncies. Són, per exemple, les glàndules salivares o les gàstriques, que alliberen saliva o sucs com a resposta a la presència d’aliments o, fins i tot, a l’olor que fan.
88 1
Així es realitza la funció de relació




















són captats per






que envien senyals a


que elabora ordres en forma d’impulsos nerviosos i els envia a


que executen























89 U 4
com
com

La percepció: els sentits
El tacte
Termoreceptor del fred Mecanoreceptor del contacte

















Mecanoreceptor de la pressió


2.1 Tipus de receptors
La percepció es realitza per mitjà dels receptors, que poden ser de dos tipus:
- Els receptors interns. Capten els canvis del medi intern. Estan dispersos per tot l’organisme i ens informen del seu estat general. Ens permeten, per exemple, detectar fam, set o dolor.
- Els receptors externs o sensorials. Capten els estímuls del medi extern. Segons la naturalesa de l’estímul que perceben, es classifiquen en:
• Mecanoreceptors, si capten estímuls mecànics; per exemple, la pressió, les vibracions i el moviment.
• Termoreceptors, si perceben variacions de temperatura.
• Quimioreceptors, si detecten substàncies químiques.
• Fotoreceptors, si perceben la llum.
Termoreceptor de la calor

• Nociceptors, si són sensibles al dolor.






Terminacions nervioses que capten el dolor
Els receptors sensorials poden agrupar-se i, junt amb altres estructures, formar els òrgans dels sentits. En les persones, els sentits són l’olfacte, el tacte, el gust, l’oïda i la vista.
2.2 El tacte
Els receptors del sentit del tacte són mecanoreceptors, sensibles al contacte i a la pressió; termoreceptors, sensibles a la calor i al fred, i nociceptors, sensibles al dolor. No són cèl·lules, sinó terminacions nervioses, lliures o tancades en càpsules (corpuscles).
Les terminacions nervioses tàctils es troben davall de la pell. Els receptors del tacte es distribuïxen de forma desigual per la pell i transmeten la informació a través dels nervis; són, fonamentalment, termoreceptors, mecanoreceptors i nociceptors.
Els llocs més sensibles són les puntes dels dits, les plantes dels peus, les mans, el rostre i la punta de la llengua.
90 2
2.3 El gust
Els receptors del gust o cèl·lules gustatives són quimioreceptors sensibles a les substàncies que es dissolen en la saliva quan mengem o bevem.
Les cèl·lules gustatives es troben als botons gustatius, unes estructures arredonides situades a les papil·les gustatives. Les papil·les gustatives són unes protuberàncies que es localitzen al paladar, a la faringe i, principalment, a la llengua. El sabor dels aliments és la mescla dels senyals de quatre tipus de receptors: els del sabor dolç, salat, àcid i amarg, la distribució dels quals no és totalment uniforme per tota la llengua. En la percepció dels sabors influïxen les percepcions olfactòries, ja que, en mastegar, es desprenen substàncies volàtils que arriben a la cavitat nasal a través de la faringe.
2.4 L’olfacte
Els receptors de l’olfacte o cèl·lules olfactòries són quimioreceptors sensibles a les substàncies químiques gasoses que hi ha en l’aire.
Les cèl·lules olfactòries es concentren a la part superior de les fosses nasals. Quan són estimulades, envien impulsos nerviosos a través del nervi olfactori fins al cervell, que interpreta i identifica l’olor.
El gust i l’olfacte
Botó gustatiu

COMPRÉN, PENSA, INVESTIGA...
1 Enumera els tipus de receptors externs especificant què és capaç de percebre cada un.
2 Explica de què estan compostes i on es troben les papil·les gustatives.

3 Què passaria si...? Aprén a usar aquesta clau de pensament consultant el recurs disponible en anayaeducacion.es i contesta: Com creus que és la vida d’una persona que no té sentit del gust? Què creus que haguera passat si els éssers humans mai haguérem evolucionat per a percebre els sabors?
Fibres del nervi








Cèl·lules gus

Fosses
nasals






Bulb olfactori




Cèl·lules olfactòries Os del crani


91 U 4
Detall d’una papil·la gustativa C basal
2
COMPRÉN, PENSA, INVESTIGA...
4 Anomena les parts de l’orella i digues de quines estructures està formada cada una.
5 Explica raonadament per a què creus que tenim dues orelles, una en cada costat del cap.

6 En la fotografia pots veure un implant coclear, un dispositiu que permet recuperar l’audició a persones amb hipoacúsies severes; esbrina i fes un resum breu sobre com funcionen.



L’orella




2.5 L’oïda
Els receptors del sentit de l’oïda són mecanoreceptors sensibles a les vibracions. Són les cèl·lules auditives. Uns altres mecanoreceptors, les cèl·lules de l’equilibri, són sensibles al moviment del líquid que les banya.
L’orella es dividix en tres parts: l’orella externa, la mitjana i la interna.
- L’orella externa es compon de l’orella, o pavelló auditiu, i el conducte auditiu.
- L’orella mitjana està composta pel timpà, una membrana fina i tensa, i per la cadena d’ossets, que són el martell, l’enclusa i l’estrep. Es comunica amb la faringe a través de la trompa d’Eustaqui.
- L’orella interna està formada pel caragol, un canal ple de líquid en el qual es troben les cèl·lules auditives, i pels canals semicirculars, on es troben les cèl·lules de l’equilibri. Del primer partix el nervi auditiu, i dels segons, el nervi vestibular.
Com funciona l’orella
- L’audició. Les ones sonores es canalitzen, a través de l’orella i del conducte auditiu, cap al timpà. La vibració d’aquesta membrana es transmet, a través de la cadena d’ossets, fins al líquid de l’interior del caragol. Les cèl·lules auditives tenen cilis que detecten les vibracions i les transmeten a través del nervi auditiu fins al cervell, on es traduïxen en sons.
- L’equilibri. Quan es mou el cap, el líquid de l’interior dels canals semicirculars es desplaça. El moviment és detectat per les cèl·lules de l’equilibri, gràcies als cilis que tenen, i es transmet a través del nervi vestibular fins al cervell, que informa de la posició del cos.
















92
els sentits
La percepció:
Conductes semicirculars
Timpà
Caragol
Nervi vestibular
Nervi auditiu
Orella externa
Pa auditiu
Estrep Martell Cèl·lules auditives
Cadena d’ossets Enclusa
2.6 La vista
Els receptors del sentit de la vista són fotoreceptors sensibles a la intensitat de la llum i als seus colors. Són les cèl·lules denominades cons i bastons.
L’ull es dividix en dues parts: el globus ocular i els òrgans annexos.
- El globus ocular. És una esfera plena de líquid que s’allotja en una cavitat òssia. Està formada per tres capes:
• L’escleròtica. És la capa exterior blanca, la part davantera de la qual, més bombada i transparent, es denomina còrnia. Una membrana externa, denominada conjuntiva, protegix la còrnia.
• La coroide. És la capa intermèdia, la part davantera de la qual forma l’iris, un anell muscular acolorit amb un orifici central, la pupilla. Darrere es troba el cristal·lí, una lent que enfoca les imatges en la retina.
• La retina. És la capa interna en la qual es troben les cèl·lules fotoreceptores: els cons i els bastons.
- Els òrgans annexos. Les celles, les parpelles, les pestanyes i les glàndules lacrimals protegixen el globus ocular de la sequedat, de la suor i de cossos estranys. Els músculs oculars permeten moure el globus ocular.
Com funciona l’ull
La llum travessa la còrnia i passa per la coroide a través de la pupil·la, que s’obri quan la llum és dèbil, o es tanca quan és massa intensa. El cristal·lí modifica la seua curvatura gràcies a uns músculs que tensen o relaxen la lent, per a enfocar la llum sobre la retina. Els bastons (que perceben la intensitat de la llum) i els cons (que perceben els colors) transmeten la informació a través del nervi.



Les llàgrimes







Les llàgrimes són un líquid secretat per les glàndules lacrimals que tenen les funcions de mantindre l’ull humit, netejar-lo i protegir-lo contra les infeccions.
COMPRÉN, PENSA, INVESTIGA...
7 Anota en quina part del globus ocular se situen les cèl·lules fotoreceptores i el nom que reben.
8 Explica què passa a l’ull quan la llum és molt intensa i què passa quan hi ha poca llum.
9 Definix llàgrima i enumera quines funcions té.

10 Pensa i compartix en parella. Apreneu a usar aquesta estratègia de pensament consultant el recurs disponible en anayaeducacion.es i expliqueu si les persones amb ulls clars són més sensibles a la llum o no.
93 U 4
L’ull Iris
Còrnia
Conjuntiva
Nervi òptic
Retina Coroide
Pupil·la
Escleròtica

La percepció i la salut
Consells per al raspallat de les dents

Raspalla’t la part interna de les dents inclinant el raspall uns 45°.
Raspalla’t les peces dentals superiors des de la geniva cap avall i les inferiors des de la geniva cap amunt.

A més de ser essencials per a la nostra vida diària, els òrgans dels sentits ens permeten captar una gran quantitat d’estímuls que ens proporcionen felicitat i benestar.
Per això, és molt important adoptar hàbits saludables i previndre les malalties que poden alterar la nostra percepció.
3.1 La salut de l’olfacte i del gust
L’olfacte i el gust es veuen alterats generalment per processos infecciosos de les vies respiratòries, com el refredat o la grip. L’augment en les secrecions mucoses que es produïx durant aquestes malalties dificulta el funcionament dels receptors gustatius i olfactoris.
El consum de tabac també pot alterar la funció de les papil·les gustatives de la llengua i irritar la mucosa nasal, de manera que es disminuïx la capacitat de detecció dels òrgans del gust i de l’olfacte.
Els hàbits saludables
La higiene diària de la boca i de les fosses nasals i evitar el consum de tabac són hàbits saludables que milloren aquests dos sentits.


Raspalla les superfícies mastegadores aplicant-hi el raspall i efectuant moviments circulars.
La llengua també s’ha de raspallar, ja que entre les papil·les gustatives es poden acumular bacteris.
També has d’usar el fil dental.

3.2 La salut de l’orella
Les principals malalties d’aquest òrgan són les infeccions de l’orella interna, provocades per alguns bacteris i virus, que poden arribar a produir la pèrdua irreversible de la capacitat auditiva.
Un altre factor que altera la nostra percepció auditiva és l’exposició prolongada a sons intensos, com el soroll o la música a un volum excessivament elevat. Els sons d’intensitat elevada produïxen la pèrdua de receptors auditius i, per tant, una pèrdua auditiva irreversible o sordesa.
Els hàbits saludables
COMPRÉN, PENSA, INVESTIGA...
1 Raona per què els processos infecciosos de les vies respiratòries dificulten el funcionament dels receptors del gust i de l’olfacte.

2 Elabora una llista amb les conseqüències de no llavar-se les dents.
És molt important la higiene de les orelles, que s’ha de realitzar amb una solució fisiològica i evitant introduir bastonets o altres objectes que puguen danyar el timpà.
Així mateix, cal evitar els llocs molt sorollosos i no posar el volum del televisor o de qualsevol aparell de música massa alt.
94 3
3.3 La salut de la vista
Les malalties més comunes que afecten la visió es deuen a infeccions oculars, produïdes per bacteris, fongs o virus, i a l’aparició de les anomalies visuals, que provoquen un defecte en la qualitat de les imatges captades per la retina.
Les anomalies en la visió
Són degudes a alteracions en la grandària i en la forma del globus ocular i de la còrnia.
- La miopia. Es deu a una longitud excessiva del globus ocular, que provoca que la imatge captada no es forme a la retina, sinó davant d’aquesta. El resultat és la dificultat per a captar imatges llunyanes. Aquest defecte es corregix utilitzant lents divergents.
- La hipermetropia. Es deu a una longitud menor del globus ocular, que provoca que la imatge captada no es forme a la retina, sinó darrere d’aquesta. El resultat és la dificultat per a captar imatges pròximes. Aquest defecte es corregix utilitzant lents convergents.
- L’astigmatisme. Es deu a la presència d’irregularitats en la curvatura de la còrnia, la qual cosa provoca una visió distorsionada. Es corregix utilitzant lents cilíndriques.
3.4 Els hàbits saludables
Alguns dels hàbits saludables que milloren la nostra visió són la higiene dels ulls, llegir i estudiar amb bona il·luminació, mantindre una distància adequada entre els ulls i les pantalles i passar revisions oftalmològiques periòdiques.
Anomalies de la visió i com es corregixen
L’ull miop i la seua correcció

L’ull miop forma la imatge davant de la retina.

La lent divergent «endarrerix» la imatge al lloc correcte.
L’ull hipermetrop i la seua correcció

L’ull hipermetrop forma la imatge darrere de la retina.
COMPRÉN, PENSA, INVESTIGA...
3 Explica les diferències que hi ha entre un ull miop i un ull hipermetrop.
4 Raona si és possible que es combinen entre si les anomalies de la visió, és a dir, si es pot tindre al mateix temps miopia i astigmatisme, hipermetropia i astigmatisme, i miopia i hipermetropia.
5 Fes una llista amb hàbits saludables relacionats amb la visió i inclou-ne almenys un que tinga relació amb la dieta.

La lent convergent «avança» la imatge al lloc correcte.
95 U 4

La coordinació nerviosa



El sistema nerviós s’encarrega de la coordinació nerviosa. Aquest sistema està format per teixit nerviós, les cèl·lules del qual, les neurones, poden transmetre informació mitjançant impulsos nerviosos.
4.1 Les cèl·lules del sistema nerviós
La informació rebuda i elaborada pel sistema nerviós viatja en forma d’impulsos nerviosos de naturalesa elèctrica, que són transmesos per les neurones o cèl·lules nervioses.
Les neurones són les unitats estructurals i funcionals del sistema nerviós. Són cèl·lules molt diferenciades i amb una morfologia complexa.
La neurona consta d’un cos cel·lular, on s’allotgen el nucli i els orgànuls citoplasmàtics, del qual partixen prolongacions curtes i ramificades, anomenades dendrites. D’un extrem del cos cel·lular ix una única prolongació, molt més llarga, que es denomina àxon, que acaba en extrems eixamplats, anomenats botons terminals.
Els àxons de diverses neurones s’agrupen en feixos que constituïxen les fibres nervioses; algunes d’aquestes, al seu torn, s’agrupen i formen els nervis.
Segons la funció que realitzen, hi ha diferents tipus de neurones:
- Les neurones sensitives, les dendrites de les quals estan connectades a un receptor.
- Les neurones motores, l’àxon de les quals està connectat a un òrgan efector.
- Les neurones d’associació o intermèdies, que comuniquen les anteriors.
- Al teixit nerviós, les neurones estan acompanyades de les cèl·lules de glia, que s’encarreguen de la seua nutrició, defensa i suport.
L’impuls nerviós
Les funcions de les neurones són possibles pel fet que aquestes cèllules transmeten informació en forma de senyals electroquímics anomenats impulsos nerviosos.
COMPRÉN, PENSA, INVESTIGA...
1 Dibuixa en el quadern dues neurones i indica’n les parts.
2 Definix impuls nerviós i neurotransmissor

3 Comprovem. Creieu que les neurones són capaces de reproduir-se? És igual durant tot el cicle de vida dels éssers humans?
Els impulsos nerviosos viatgen per la membrana neuronal, sempre des de les dendrites o des del cos cel·lular cap a l’extrem de l’àxon. Una vegada allà, la neurona connecta amb una altra neurona o amb un efector per a transmetre l’impuls.
No obstant això, les neurones no arriben a tocar-se, ja que entre l’extrem de l’àxon d’una neurona i el cos o una dendrita d’una altra, hi ha una zona de comunicació anomenada sinapsi. En aquesta, la neurona transmissora de l’impuls nerviós emet unes substàncies denominades neurotransmissors, que arriben a la membrana de la neurona receptora i fan que en aquesta es genere el mateix impuls.
96
4
Així és un nervi
Nervi
Fibra nerviosa
Així es transmet l’impuls nerviós
Neurona transmissora
Àxon

Impuls nerviós

1 La neurona rep l’impuls nerviós
Botó terminal de l’àxon

Sinapsi
Dendrites
2 L’impuls nerviós recorre la neurona
Neurona receptora
3 La neurona transmet l’impuls nerviós a la neurona següent

Observa la imatge i respon les preguntes
a) Explica per què es diu que l’impuls nerviós és un senyal electroquímic.
b) Quina part de la sinapsi creus que pot rebre el nom de fenedura sinàptica?
Neurona transmissora
Impuls nerviós
Botó terminal de l’àxon


Neurotransmissors
4 L’impuls nerviós recorre la neurona següent


Neurona receptora La sinapsi
Espai sinàptic
Impuls nerviós


97 U 4
L’encèfal
4.2 El sistema nerviós
El sistema nerviós és una xarxa de neurones que interpreta els senyals o estímuls que envien els òrgans dels sentits i elabora ordres perquè els efectors hi responguen.
El sistema nerviós està constituït pel sistema nerviós central (SNC) i el sistema nerviós perifèric (SNP).
4.3 El sistema nerviós central (SNC)
El SNC coordina totes les funcions de l’organisme. Està format per l’encèfal i la medul·la espinal.
L’encèfal
L’encèfal està protegit pel crani i per tres membranes, les meninges, entre les quals circula el líquid cefaloraquidi, que amortix i el protegix dels colps. Consta de tres parts: el cervell, el cerebel i el tronc encefàlic.






El cervell, que està dividit en dos hemisferis interconnectats. La seua superfície, que rep el nom d’escorça cerebral, és rugosa i té replecs anomenats circumvolucions. Al cervell es fa conscient la informació i residixen les funcions avançades, com la memòria, la intel·ligència o la voluntat.
Tàlam i hipotàlam
El cerebel, també amb dos hemisferis i escorça replegada. S’encarrega de controlar l’equilibri i els moviments voluntaris prèviament apresos, com caminar, escriure o tocar un instrument.
Bulb raquidi
El tronc encefàlic enllaça l’encèfal amb la medul·la i controla diverses funcions involuntàries. Per exemple, la part denominada bulb raquidi controla els moviments de la respiració i el ritme cardíac.
98
4 La coordinació nerviosa
Crani Cos callós
La medul·la espinal
És un cordó nerviós, protegit per la columna vertebral, que connecta l’encèfal amb la resta del cos.
Hi viatgen els impulsos nerviosos des dels receptors fins a l’encèfal i des d’aquest fins als efectors. Coordina respostes senzilles, anomenades actes reflexos.
4.4 El sistema nerviós perifèric (SNP)
El SNP està format per nervis que connecten el SNC amb els òrgans del cos. Està format per 31 parells de nervis que partixen de la medul·la, o nervis raquidis, i per 12 parells de nervis que ixen de l’encèfal, o nervis cranials.
Els nervis es classifiquen en sensitius (porten informació dels receptors al SNC) i motors (transmeten ordes del SNC als efectors).
El sistema nerviós perifèric es dividix en somàtic i autònom.
- El SNP somàtic controla moviments voluntaris, com la locomoció.
- El SNP autònom controla el funcionament involuntari d’òrgans vitals, com el cor. Està format pel SN simpàtic, que prepara el cos per a situacions de perill o acció, i el SN parasimpàtic, que relaxa el cos. Ambdós són antagònics, de manera que quan un estimula un òrgan l’altre el relaxa.
La medul·la espinal
Medul·la espinal
Columna vertebral


Disc intervertebral
1. Dilata la pupil·la.
2. Estimula la salivació (suaument).
3. Accelera el batec.
4. Relaxa els bronquis.
5. Inhibix l’activitat a l’estómac i al pàncrees.
6. Estimula l’emissió de glucosa.
7. Estimula les suprarenals (adrenalina).
8. Excita els esfínters intestinals.
9. Relaxa la bufeta.
10. Inhibix els òrgans reproductors.
COMPRÉN, PENSA, INVESTIGA...
4 Indica en el quadern les parts de l’encèfal i explica, en cada cas, les funcions que té cada una.
5 Exposa, amb un exemple, què significa que els sistemes nerviosos simpàtic i parasimpàtic són antagònics.

6 1-2-4. El cervell i el seu funcionament continua guardant molts secrets, la qual cosa provoca la creació de nombrosos mites i d’informacions falses. Una de les falsedats més famoses i recurrents és la que argumenta que els éssers humans només usem un 10 % del cervell. Quins arguments es podrien donar per a refutar aquesta idea?
1. Contrau la pupil·la.
2. Estimula molt la salivació.
3. Alentix el batec.
4. Contrau els bronquis.
5. Estimula l’activitat de l’estómac.
6. Estimula l’activitat de la vesícula biliar.
7. Estimula l’activitat del pàncrees.
8. Inhibix els esfínters intestinals.
9. Contrau la bufeta.
10. Estimula els òrgans reproductors.
99 U 4
Nervis raquidis
Els actes voluntaris











1 Per a qualsevol acte voluntari, per exemple agafar un llapis, és necessari que nombrosos receptors com els del tacte o la visió transmeten informació a través de les fibres nervioses dels nervis sensitius (fletxes de color verd) fins a l’encèfal.
2 Allà s’analitzen i s’elaboren senyals (fletxes de color roig) que circulen pels nervis motors de la medul·la espinal fins a arribar als músculs que s’encarregaran de produir la resposta. En aquest cas, moure la mà i agafar el llapis.
3 La resposta, agafar el llapis, consistix en contraccions musculars que generen un moviment no especialment ràpid, però precís.
4.5 Com funciona el sistema nerviós
Davant d’un estímul, els receptors envien informació al SNC que, després de processar-la, envia l’ordre adequada als efectors per a respondre a aquest canvi del medi.
El funcionament del sistema nerviós és més o menys ràpid, depenent de les necessitats de l’organisme. Segons això, cal distingir entre actes voluntaris i actes reflexos.
Els actes voluntaris
Els actes voluntaris són respostes conscients, «decidides», que estan coordinades per l’encèfal.
En un acte voluntari intervenen:
- Un receptor que rep l’estímul; per exemple, receptors de la visió i del tacte detecten un llapis per a dibuixar.
- Un nervi sensitiu que transmet l’impuls fi ns a la medul·la, i des d’aquesta, fi ns a l’ escorça cerebral.
- L’escorça cerebral, que transforma la informació en una sensació conscient (una imatge, una forma, calor, etc.) i, amb la informació rebuda i l’emmagatzemada d’experiències anteriors, elabora una ordre de resposta, que es dirigix, passant per la medul·la, a un nervi motor.
- Un nervi motor pel qual viatja l’ordre fins a l’òrgan efector.
- Un òrgan efector (per exemple, un múscul), que es contrau de forma voluntària per a executar la resposta: agafar el llapis i dibuixar.
COMPRÉN, PENSA, INVESTIGA...
7 Descriu amb un exemple com es produïx, en el terreny del sistema nerviós, un acte voluntari.

8 Ridícul. Aprén a usar aquesta clau de pensament amb el recurs disponible en anayaeducacion.es i respon la pregunta: Què creus que passaria si haguérem de pensar amb paraules cada acte voluntari que fem?
100
4 La coordinació nerviosa
1 2 3
Els actes reflexos
Els actes reflexos són respostes ràpides, involuntàries i automàtiques, controlades per la medul·la espinal, que es produïxen en situacions d’emergència.
La informació arriba a la medul·la, que elabora la resposta sense la intervenció de l’encèfal, per la qual cosa aquesta és més ràpida.
En un acte reflex intervenen un conjunt d’elements nerviosos que reben el nom d’arc reflex; són els següents:
- Un receptor que rep l’estímul; per exemple, els receptors de la calor de la pell detecten alguna cosa molt calenta.
- Un nervi sensitiu que transmet l’impuls fins a la medul·la.
- Una neurona d’associació que elabora una ordre de resposta immediata.
- Un nervi motor pel qual viatja l’ordre fins a l’òrgan efector.
- Un òrgan efector, per exemple, un múscul, que executa la resposta, és a dir, es contrau i retirem la mà.
Els actes reflexos


1 Una informació que requerix una resposta ràpida arriba als receptors; per exemple, que et cremes la mà.
COMPRÉN, PENSA, INVESTIGA...
9 Enumera les parts del sistema nerviós que intervenen en un acte reflex.

10 En la fotografia inferior pots veure un professional de la medicina fent una prova del reflex patel·lar. Esbrina per a què es fa. Hi ha més proves de reflexos paregudes; busca el nom de quatre.





2 A la medul·la espinal es genera la resposta: retirar la mà.








3 La resposta (retirar la mà) és involuntària, molt ràpida i molt poc precisa, ja que es duu a terme sense la intervenció de l’encèfal
101 U 4
3 1 2

La salut del sistema nerviós
COMPRÉN, PENSA, INVESTIGA...
1 Descriu en què consistixen l’alzhèimer i el pàrkinson.
2 Els traumatismes són els principals causants de lesions medul·lars com la paraplegia i la tetraplegia. Escriu una llista d’almenys cinc causes d’aquest tipus de traumatismes i què es pot fer per a previndre’ls.
La gran complexitat del nostre sistema nerviós fa que puga patir malalties de dos tipus: les degudes a danys orgànics i les originades per alteracions en el seu funcionament (trastorns psicològics).
5.1 Les alteracions del sistema nerviós per causes orgàniques
Són alteracions físiques dels òrgans del sistema nerviós. Algunes d’aquestes són:
Els traumatismes causats per accidents
Són lesions a la zona cranioencefàlica o a la medul·la degudes a colps forts. Poden derivar en paraplegia, paràlisi de mig cos, o tetraplegia, paràlisi de tot el cos.
Els accidents cerebrovasculars
Són danys en el teixit nerviós que es produïxen en obstruir-se artèries cerebrals i deixar sense oxigen una zona del cervell. Hi destaquen les hemorràgies, o isquèmies cerebrals, que és la mort per falta d’oxigen d’una zona del cervell.
El consum de drogues
L’alcohol i altres drogues causen danys irreparables en el sistema nerviós, a més d’una gran dependència física i psicològica.
Les malalties degeneratives
Es produïxen per la pèrdua de les neurones a causa principalment de l’edat. L’alzhèimer, que produïx pèrdua de memòria i desorientació; el pàrkinson, que produïx una falta de control dels moviments del cos.





La boccia
La boccia és un esport paralímpic que practiquen persones amb paràlisi cerebral, lesions cerebrals o discapacitats físiques severes.
a) Busca informació sobre què és la paràlisi cerebral.
b) En la fotografia pots observar la final de boccia en categoria BC3 en les olimpíades d’Atenes en 2004, on es van enfrontar Corea del Sud i Espanya. Esbrina què significa aquesta categoria i quines altres hi ha en aquest esport.
c) Practicar esport és un dels hàbits recomanats per a cuidar de la salut del sistema nerviós. Fes una llista amb tres hàbits saludables més.
102 5
5.2 Les malalties mentals
Són canvis en el caràcter i en el comportament que creen malestar emocional. Es poden deure a problemes orgànics, a una predisposició genètica o a influències socials i ambientals. Les podem classificar en:
Trastorns d’ansietat
Determinades situacions poden sotmetre el sistema nerviós a una tensió excessiva o estrés, que pot causar danys orgànics. Per exemple, origina un estat d’angoixa o por anomenat ansietat, caracteritzat per tensió muscular, alteracions del son, augment del ritme cardíac i de la sudoració, problemes digestius...
Les fòbies, el trastorn obsessiu compulsiu o el trastorn d’ansietat generalitzada en són alguns exemples.
Trastorns en la conducta alimentària
Són, per exemple, l’anorèxia nerviosa i la bulímia:
- L’anorèxia nerviosa. Les persones anorèctiques s’autoimposen una dieta d’aprimament severa, perquè es veuen obeses encara que no ho siguen realment. En els casos greus, la persona deixa de menjar del tot, s’aprima fins a l’extrem i mor, perquè no s’adona del que li passa; ho nega i ho oculta.
- La bulímia. Les persones que la patixen també adopten dietes molt estrictes d’aprimament, però les trenquen menjant compulsivament. Això els crea un sentiment de culpa, i es provoquen el vòmit per a no engreixar. La bulímia és causa d’alteracions greus en la salut.
Trastorns de l’estat d’ànim
Un dels més freqüents és la depressió. En aquest trastorn, un sentiment de tristesa molt intens i incontrolable envaïx la persona afectada. Un altre exemple d’aquest tipus de trastorns seria el trastorn bipolar. Aquestes malalties poden tindre orígens diversos: experiències traumàtiques, trastorns hormonals (depressió postpart), predisposició genètica, etc.
Trastorns psicòtics
Són patologies en què les persones perden el contacte amb la realitat i poden patir deliris o al·lucinacions. Els més freqüents són l’esquizofrènia i el trastorn delirant.
Un problema afegit





Les persones que patixen malalties mentals solen haver de lluitar a més contra l’estigma social que aquest tipus de trastorns tenen associat.
La incomprensió de les malalties mentals en infravalorar-ne els efectes, les burles o la por cap a les persones que les patixen, la soledat i la discriminació són només alguns dels problemes que causa aquest estigma.
Es calcula que una de cada quatre persones patiran algun tipus de malaltia mental al llarg de la seua vida.
COMPRÉN, PENSA, INVESTIGA...

3 Busca el significat de la paraula estigma.

4 Tria una malaltia mental de les que s’esmenten en aquesta pàgina i fes les tasques següents.
a) Elabora una fitxa en què n’apareguen les causes, els efectes en la persona que la patix i els tractaments possibles.
b) Descriu els estigmes que porta associats aquesta malaltia.
c) Escriu una llista d’accions que es podrien dur a terme per a conscienciar sobre aquesta malaltia i ajudar a eliminar l’estigma que porta associat.
103 U 4

La coordinació endocrina
6.1 El sistema endocrí
La coordinació endocrina és un mecanisme que regula, de manera lenta però prolongada, les accions de molts òrgans del cos.
La realitza el sistema endocrí, que està constituït per un conjunt de glàndules endocrines, especialitzades a sintetitzar i segregar hormones a la sang. La sang transporta per tot l’organisme les hormones, que només actuen sobre els òrgans o cèl·lules determinades, denominades cèl·lules diana.
Les glàndules endocrines
COMPRÉN, PENSA, INVESTIGA...
1 Descriu les funcions de la hipòfisi.
2 Definix hormones i explica com es distribuïxen per l’organisme.
3 Indica dues glàndules de les que apareixen en l’esquema que no tinguen només funció endocrina i explica quina funció tenen.
Les glàndules del sistema endocrí
Masculines




- La hipòfisi. Es coneix també com a glàndula pituïtària i es troba localitzada a la base del cervell. És la glàndula més important, ja que algunes de les hormones que sintetitza controlen la secreció de la resta de glàndules.
- Altres glàndules endocrines són la tiroide, la paratiroide, les glàndules suprarenals, el pàncrees, els ovaris i els testicles.
Alguns òrgans del cos humà, que exercixen altres funcions, poden funcionar com a glàndules endocrines, com, per exemple, la placenta, que sintetitza i allibera progesterona durant tot l’embaràs.


Hipòfisi
Tiroide
Paratiroide
Tim
Pàncrees
Glàndules suprarenals





Femenines


104 6
6.2 Com es realitza la coordinació endocrina
La coordinació endocrina dels òrgans del cos per mitjà d’hormones és un procés molt complex.
Les hormones es produïxen només quan són necessàries i en la quantitat adequada. Per a produir i alliberar la quantitat necessària d’hormones, el sistema endocrí té un mecanisme de regulació anomenat retroalimentació, que està controlat per una part del cervell anomenada hipotàlem.
El procés consistix en diverses etapes:
- L’hipotàlem estimula la hipòfisi. L’hipotàlem rep un senyal i allibera factors, que estimulen la hipòfisi perquè sintetitze hormones.
- La hipòfisi estimula altres glàndules. La hipòfisi segrega hormones que circulen per la sang i estimulen altres glàndules endocrines perquè produïsquen les seues hormones.
- Les hormones actuen sobre els òrgans. Les hormones produïdes per les glàndules són alliberades a la sang i arriben als òrgans o cèl·lules diana, on actuen.
- L’augment en la quantitat d’hormones en deté la secreció. Quan la quantitat d’hormones en la sang augmenta per damunt d’uns nivells determinats, l’hipotàlem deixa d’estimular la hipòfisi, que deté l’alliberament d’hormones. És a dir, la mateixa concentració d’hormones és la que en regula la secreció.
Així funciona el sistema endocrí



COMPRÉN, PENSA, INVESTIGA...
4 Indica què és l’hipotàlem i com controla la funció de la hipòfisi.
5 Explica la importància que té el mecanisme de retroalimentació.
Així funciona el sistema endocrí

Redacta un text que explique el mecanisme de retroalimentació mostrat en la imatge.














Estimulació
Inhibició

















105 U 4
6.3 Les hormones
Cada hormona actua sobre un tipus determinat de cèl·lula o diana, controlant i coordinant la seua activitat.
Les hormones són molt eficaces, ja que una quantitat reduïda és suficient per a exercir la seua funció. L’acció que realitzen és més lenta però més continuada que la dels impulsos nerviosos.








Hormona del creixement (STH)
Hormona antidiürètica (ADH)
Gonadotropines (FSH, LH)
Hormona estimulant de la tiroide (TSH)
Oxitocina
Prolactina
Tiroxina
Hormona paratiroidea















Adrenalina
Cortisona
Insulina
Glucagó
Estrògens i progesterona
Testosterona
COMPRÉN, PENSA, INVESTIGA...
6 Indica quina glàndula i quina hormona produïx l’organisme quan hi ha poca glucosa en sang.
Estimula el creixement de músculs i ossos
Regula la quantitat d’aigua en l’orina
Estimula l’activitat de les gònades
Estimula l’activitat de la tiroide
Induïx les contraccions de l’úter per al part
Estimula la secreció de llet a les mamelles
Activa el metabolisme cel·lular i influïx en el creixement i en el desenvolupament
Regula el nivell de calci i de fòsfor en la sang
Prepara l’organisme per a una situació de perill o d’acció
Regula el metabolisme dels glúcids
Dismuniïx la quantitat de glucosa en la sang
Augmenta la quantitat de glucosa en la sang
Controlen el desenvolupament dels caràcters sexuals secundaris
Regulen el cicle menstrual i l’ovulació
Preparen el cos per a un possible embaràs
Controla el desenvolupament dels caràcters sexuals secundaris
Regula la producció d’espermatozoides
7 Quina hormona creus que és coneguda comunaom l’hormona del part? ment com
106
6 La coordinació endocrina

La salut del sistema endocrí
7.1 Les alteracions del sistema endocrí
La major part de les malalties endocrines s’originen quan es veu alterada la producció d’hormones que produïx una glàndula.
Una glàndula patix hiperfunció quan produïx més hormones del normal, i hipofunció si allibera menys hormones del que és necessari.
Algunes malalties produïdes per alteracions endocrines són:
- El gegantisme i el nanisme, que es deuen, respectivament, a una alta o a una baixa producció de l’hormona del creixement (STH), que fa que les persones siguen molt altes o molt baixes.
- L’hipertiroïdisme es produïx quan la tiroide augmenta de mida i fabrica massa tiroxina.
- L’hipotiroïdisme, que es pot deure a falta de iode en la dieta, produïx un metabolisme lent que pot provocar que la persona augmente de pes i que presente apatia i cansament.
COMPRÉN, PENSA, INVESTIGA...
1 Escriu dues alteracions del sistema endocrí que tinguen relació amb un dèficit hormonal i dues amb una sobreproducció.

2 Intuïsc i deduïsc. Aprén a usar aquesta tècnica de pensament en anayaeducacion.es i intenta explicar com podria afectar l’organisme una alteració en les glàndules suprarenals.
- La diabetis és una malaltia originada per un mal funcionament del pàncrees, de manera que segrega poca insulina. Com a conseqüència, es produïx una hiperglucèmia, és a dir, un augment del nivell de glucosa en la sang. Això ocasiona danys greus en l’organisme, com ceguesa o insuficiència renal.
Hi ha hàbits que ajuden a mantindre sa el sistema endocrí, com seguir una dieta saludable, fer exercici físic i no consumir substàncies com l’alcohol i altres drogues.
Els hàbits que afavorixen la salut del sistema endocrí són se- ema endocrí guir una dieta saludable, evitar begudes alcohòliques i fer exercici físic.




Malalties de cine
L’home que veus en la imatge s’anomena Richard Kiel i patia acromegàlia. Va ser un actor nord-americà que es va fer famós per interpretar, entre altres personatges, Jaws, un dels grans enemics de James Bond, en algunes pellícules i videojocs.
a) Segons el que pots veure en la imatge, quins símptomes creus que pot tindre l’acromegàlia? Amb quina hormona creus que pot tindre relació?
b) Busca informació sobre l’alteració del sistema endocrí que patia Richard Kiel.
c) Esbrina si hi ha altres tipus de gegantisme i si estan causats per alteracions del sistema endocrí.
107 U 4 7

Les drogues i la drogoaddicció
L’addicció al joc





L’addicció al joc es classifica dins de les anomenades addiccions sense substància. Les dades d’investigacions recents revelen que cada vegada hi ha més persones que participen en jocs amb diners tant físicament com online. Aquest augment és especialment important en persones joves, en les quals les patologies relacionades amb el joc també han augmentat. Contesteu les preguntes següents relacionades amb l’addicció al joc.

a) Full giratori. Esbrineu quins són els problemes de salut que ocasiona l’addicció al joc.
b) Elaboreu una llista d’activitats sense substància que es puguen transformar en una addicció. Com creieu que una persona arriba a tornar-se addicta a substàncies o a activitats?

c) Dissenyeu una campanya d’informació sobre els riscos de l’addicció al joc destinada a conscienciar persones joves.
Una droga és una substància que altera el sistema nerviós central i que produïx un estat de dependència física i psíquica, tolerància i trastorns greus de la salut.
La drogoaddicció és un problema social greu, ja que pot arribar a anul·lar la voluntat de qui es droga i afectar-ne greument la salut, els estudis, el treball i les relacions socials i familiars.
8.1 La dependència
- La dependència física. És la necessitat de consumir la droga, perquè l’organisme funcione de manera normal. La síndrome d’abstinència és un conjunt de trastorns fisiològics greus que es produïxen quan no se subministra la droga a un cos que hi està habituat. Els símptomes més habituals són respiració agitada, sudoració, hiperactivitat i convulsions, que poden ocasionar la mort.
- La dependència psíquica. És la necessitat de consumir la droga, per a obtindre un estat d’eufòria o de plaer, o per a evitar el malestar que produïx la privació. Per exemple, la dependència de cocaïna produïx cansament extrem, ansietat i depressió.
8.2 La tolerància
La tolerància és la disminució dels efectes desitjats a causa de l’ús continuat d’una droga. Com a conseqüència, es requerix un augment de la dosi per a aconseguir els mateixos efectes. La sobredosi es produïx quan es pren una quantitat que el cos no pot assimilar, i pot arribar a ser mortal.
COMPRÉN, PENSA, INVESTIGA...
1 Definix droga i drogoaddicció.
2 Explica què és la síndrome d’abstinència i en què es diferencia de la dependència psicològica.
3 Indica què és la tolerància a les drogues i raona quina relació té amb la sobredosi.
108 8
8.3 Tipus de drogues i trastorns en
la salut
Les drogues es poden classificar segons el mecanisme d’acció en:
- Depressores. Per exemple, l’alcohol o els tranquillitzants. Frenen la transmissió nerviosa i produïxen relaxació, somnolència i fins i tot coma.
- Estimulants. Per exemple, la cocaïna, la nicotina, les amfetamines o la cafeïna. Activen la transmissió nerviosa i produïxen sensació d’eufòria i disminució de la fatiga i de la son.
- Narcotitzants. Per exemple, l’opi, la morfina i l’heroïna. S’utilitzen per a calmar el dolor i produïxen son i estupor. Generen una dependència molt forta que és difícil de superar.
- Al·lucinògenes. Per exemple, el cànnabis o l’LSD. Alteren la transmissió nerviosa, de manera que modifiquen la percepció de la realitat i provoquen il·lusions visuals o auditives (al·lucinacions).
Trastorns en la salut
Les drogues danyen la salut, ja que afecten el cervell i la transmissió de l’impuls nerviós
Els principals danys que causen són:
- Danys en el sistema nerviós, que provoquen trastorns psicològics greus, com pèrdua de memòria, depressió, ansietat o esquizofrènia.
- Danys en altres aparells o sistemes, com l’hepatitis, que produïx l’alcohol; el càncer de pulmó, que produïx el tabac; o les arrítmies, que produïx el cànnabis.
- Trastorns del comportament, que donen lloc a problemes familiars i laborals, actes delictius o conductes agressives.
- Alteracions en la percepció de la realitat i en la resposta motora, que provoquen accidents de trànsit o laborals.
- Cal tindre en compte, a més, els efectes danyosos de les substàncies que s’utilitzen per a adulterar les drogues, moltes de les quals són molt tòxiques i sense cap tipus de control sanitari.
L’alcohol: la droga més perillosa
És important tindre en compte que, a pesar que els danys més greus se solen produir en persones que fan un ús continuat de les drogues, un ús puntual també pot causar danys irreversibles.




































L’alcohol és una droga perillosa i addictiva. El consum excessiu pot ocasionar danys irreversibles en el sistema nerviós, especialment en el dels joves.
Segons un estudi realitzat per la revista mèdica
The Lancet, es tracta de la droga més perillosa pels danys que causa als usuaris i a les persones que tenen al seu voltant.
És important tindre això present en situacions en què la pressió social d’un grup induïx al consum incontrolat de begudes alcohòliques.
Coneix els efectes de les drogues
Tria una droga legal i una droga il·legal i recopila’n la informació següent:
• Resum històric de l’ús, origen i forma de consum de la substància.
• Efectes en la salut distingint entre consum a llarg termini i reaccions agudes.
• Efectes psicosocials de l’addicció a la substància.
• Dades estadístiques sobre el consum i defuncions associades a Espanya.
Quan hages recopilat les dades, elabora un producte audiovisual en què reflectisques tota la informació reunida.
109 U 4

L’execució de la resposta. L’aparell locomotor
Les radiografies



Per a fer radiografies s’apliquen raigs X a la part del cos que es vol observar. Els raigs X són un tipus de radiacions que poden traspassar alguns materials sòlids els àtoms dels quals tinguen nombres atòmic baixos.
Podem veure els ossos en les radiografies perquè, com que estan formats per calci, un element amb un nombre atòmic elevat, els raigs X hi són absorbits. El que veiem en la radiografia és el contrast entre el que poden travessar els raigs X i el que no.
COMPRÉN, PENSA, INVESTIGA...
1 Indica com es poden classificar els ossos segons la forma que tenen i posa dos exemples en cada cas.
2 Dibuixa un esquema d’un os llarg indicant què és l’epífisi i què és la diàfisi.
3 Enumera els tipus d’articulacions i explica breument l’estructura que presenten.
9.1 El sistema esquelètic
El sistema esquelètic està format pels ossos de l’esquelet i per les articulacions. Les funcions que té són:
- Sostindre el cos.
- Protegir els òrgans vitals.
- Ser el lloc on es fixen els músculs.
- Fabricar cèl·lules sanguínies.
- Ser una reserva de calci i de fòsfor.
Els ossos
Els ossos són estructures rígides formades externament per teixit ossi compacte, i internament, per teixit ossi esponjós.
La rigidesa dels ossos es deu a la presència de sals de calci.
Segons la forma que presenten, els ossos es classifiquen en ossos llargs, com el fèmur; curts, com les vèrtebres o els ossos de la monyica; i plans, com els ossos que formen el crani.
Els ossos llargs tenen dues regions: els extrems o epífisi, i la part central o diàfisi. El teixit esponjós de les epífisis està farcit de medul·la òssia roja, la funció de la qual és formar cèl·lules sanguínies. La diàfisi, de teixit compacte, té un canal intern farcit de medul·la òssia groga o moll, formada per teixit adipós.
Les articulacions
Són les zones d’unió entre els ossos. Poden ser:
- Fixes. Són articulacions sense moviment, com és el cas dels ossos del crani.
- Semimòbils. Permeten un moviment limitat entre els ossos, com passa amb les vèrtebres, entre les quals hi ha discos de teixit cartilaginós, més elàstic i bla.
- Mòbils. Permeten el moviment dels ossos en totes les direccions. Per exemple, les del genoll o la monyica. Les zones de contacte entre els ossos estan recobertes per teixit cartilaginós i pel líquid sinovial, que evita el fregament. En aquestes articulacions, els ossos s’unixen per mitjà de lligaments.
Els ossos dels bebés
Quan naixem, no tots els ossos es troben calcificats; els del crani, per exemple, estan formats per cartílag perquè siguen més flexibles i facilitar així el part. Els ossos es calcifiquen a poc a poc fins a arribar a l’edat adulta.
110 9
L’esquelet humà
Les articulacions
Fixes: ossos del crani
Omòplat
Húmer
Mandíbula


Falanges
Ili

Costelles



Carp
Metacarp

Peroné
Falanges





Pubis
Clavícula



Isqui



Columna vertebral
Cúbit

Estèrnum



Radi


Semimòbils: les vèrtebres
Disc cartilaginós


Fèmur



Vèrtebres

Mòbils: el colze

Tars

Metatars

Lligaments
Húmer



111 U 4
Radi
Cúbit
fix�
Articul�ció
Tíbia
Ròtula
El braç s’estén




1 A través d’un nervi, arriba una ordre al tríceps i aquest es contrau.

2 El tríceps està unit a l’os per un tendó i tira d’aquest. El braç s’estira.


El braç es doblega
1 A través d’un nervi, arriba una ordre al bíceps i aquest es contrau.
Bíceps


2 El bíceps està unit a l’os per un tendó i tira d’aquest. El braç es doblega.
COMPRÉN, PENSA, INVESTIGA...
4 Enumera les funcions del sistema muscular.
5 Explica com es produïx la contracció muscular.
9.2 El sistema muscular
El sistema muscular està format pels músculs i els tendons. Dels tres tipus de músculs existents, esquelètic, cardíac i llis, només els músculs esquelètics formen part de l’aparell locomotor.
El nostre cos té al voltant de 400 músculs que constituïxen prop del 40 % del pes de l’organisme. Les funcions del sistema muscular són:
- Produir moviment, quan els músculs es contrauen i tiren dels ossos.
- Mantindre la postura del cos per mitjà del to muscular, que són xicotetes contraccions que fan que el cos es mantinga en la seua posició.
- Produir calor. La contracció muscular produïx la major part de la calor necessària per a mantindre la temperatura corporal.
Els músculs i els tendons
Els músculs esquelètics estan formats per feixos de fibres musculars reunides en fascicles. Les fibres, o cèl·lules musculars, són cilíndriques i allargades.
Cada múscul està envoltat per una capa de teixit conjuntiu, que es prolonga i forma estructures molt resistents, anomenades tendons. Aquests l’unixen fortament als ossos, a la pell o a un altre múscul.
Segons la forma, els músculs poden ser:
- Fusiformes, amb forma allargada i més estreta als extrems, com, per exemple, el bíceps.
- Plans, tan amples com llargs, com, per exemple, els pectorals.
- Circulars, com els músculs orbiculars, que obrin i tanquen els llavis.
La contracció muscular
- Els moviments del cos són el resultat de la contracció dels músculs, en actuar sobre els ossos i les articulacions.
- Quan un múscul rep un impuls nerviós, les seues fibres s’acurten i es contrau. Això provoca un moviment en els ossos als quals està unit, i fa que s’acosten, se separen o giren. Generalment els músculs esquelètics formen parelles de funció antagònica, o contrària, de manera que quan un es contrau, l’altre es relaxa. Per exemple, quan el bíceps es contrau i el tríceps es relaxa, es produïx la flexió del braç.
112
9 L’execució de la resposta. L’aparell locomotor
El moviment del braç
La musculatura humana
Temporal
Masseter
Pectoral
Bíceps

Sartori



Orbicular
Esternoclidomastoidal





Oblic

Serrat
Deltoides
Tríceps
Trapezi
Costals Abdominals

Quàdriceps


Gluti
Semitendinós
Semimembranós


Tibial anterior

Bessons






113 U 4
Dorsal
Bíceps femoral
Tendó d’Aquil·les
Adductor

L’execució de la resposta i la salut
La fractura del maluc




Les fractures del maluc són una de les lesions òssies més greus que poden patir les persones d’edat avançada, ja que suposen una disminució important de la seua qualitat de vida. Un dels tractaments suposa la implantació d’una pròtesi com la que veus en la imatge.
10.1 La salut de l’aparell locomotor
Les malalties que afecten l’aparell locomotor són molt freqüents en la població i disminuïxen considerablement la qualitat de vida de moltes persones.
La salut dels ossos i de les articulacions
Les malalties més freqüents en el sistema esquelètic són:
- L’osteoporosi. Es caracteritza per la disminució de la densitat del teixit ossi, la qual cosa provoca una major fragilitat dels ossos.
- L’artritis. És la inflamació del teixit cartilaginós que forma les articulacions. Produïx dolor i, a llarg termini, deformacions en el teixit.
- Les fractures. Són ruptures totals o parcials de l’os. Es produïxen generalment com a conseqüència de traumatismes, deguts a colps i accidents. De vegades la fragilitat dels ossos, deguda a altres malalties, pot ser l’origen de la fractura.
- Les luxacions. Es produïxen quan els ossos se n’ixen de les articulacions. Provoquen dolor i en dificulten la mobilitat.
- Les ruptures de cartílags a les articulacions, degudes generalment a traumatismes.
La salut dels músculs
Les principals malalties del sistema muscular són:
- Les contractures musculars. Són contraccions excessives i involuntàries dels músculs, degudes generalment a un esforç.
- Els esquinços. Són estirons o torsions dels lligaments, que causen dolor i inflamació.
- Les tendinitis. Són inflamacions dels tendons.
- Les ruptures fibril·lars, degudes generalment a traumatismes.
Os sa


Os amb osteoporosi


L´osteoporosi
Descriu en què consistix l’alteració òssia que pots observar en la imatge i investiga’n les causes i quins són els factors de risc per a desenvolupar-la.
114 10
10.2 Els hàbits saludables per a l’aparell locomotor
La major part de les malalties de l’aparell locomotor es poden previndre adoptant hàbits saludables. Alguns d’aquests són:
- Portar una alimentació sana i equilibrada. La nostra dieta ha d’aportar els minerals necessaris per al funcionament correcte dels músculs i per a conservar la fortalesa dels ossos. Una dieta sana prevé l’excés de pes, que pot sobrecarregar el nostre esquelet.
- Proporcionar el descans necessari al nostre organisme, practicant estiraments i exercicis de relaxació després d’una activitat física i dormint suficient.
- Adoptar postures correctes, que proporcionen descans als nostres ossos i músculs i eviten les sobrecàrregues.
- Realitzar exercici físic regular, que afavorix el desenvolupament dels músculs i augmenta la resistència dels ossos.
Prevenció de riscos laborals
Tots els treballs tenen associats riscos per a la salut, molts relacionats amb l’aparell locomotor i, concretament, amb hàbits posturals i de moviment. Et proposem que tries una professió i que esbrines quins són els riscos laborals que s’hi associen i les mesures obligatòries i recomanades per a evitar-los.
En seure

Evita seure a la vora del seient.
En agafar pes


l’esquena recta i recolzada en el respatler.

Evita les postures relaxades de la columna.


el cap i el tòrax
Consells per a adoptar postures correctes

Comprovem. Trieu cada u una postura que adopteu habitualment que siga incorrecta (pot ser a classe o a casa, quiets o en moviment). Penseu, a continuació, en com hauríeu d’adoptar-la de forma correcta. Ensenyeu als companys i companyes la postura i la correcció que heu pensat i contrasteu les vostres opinions.
115 U 4
En caminar
Evita flexionar la columna amb les cames esteses.
Mantín
Doblega els genolls, no l’esquena.
Mantín
rectes.











COMPRÉN




Organitza les idees
1 Mapa conceptual d’aranya. Completa en el quadern els espais buits del mapa conceptual següent. Aprén a fer mapes conceptuals amb el recurs disponible en anayaeducacion.es.
La funció de relació
Receptors interns: ?
Receptors externs: ?
Òrgans dels sentits: ?
Els receptors
Sistema endocrí –? – Hormones
Sistema nerviós S. N. central –? –?
S. N. perifèric –? –?
Sistema esquelètic –? – Articulacions
Sistema muscular –? – Articulacions
Les glàndules
Els efectors
Els centres coordinadors
Fes un resum
2 Elabora el teu resum de la unitat seguint aquest guió:
• Definix funció de relació i enumera els processos per mitjà dels quals es realitza.
• Explica com es duu a terme la recepció dels estímuls.
• Descriu els òrgans dels sentits i la funció que tenen.
• Definix neurona i explica com es transmet l’impuls nerviós.
• Fes un esquema del sistema nerviós central i perifèric, indicant-ne les parts i les principals funcions.
• Compara el funcionament del sistema nerviós en els actes voluntaris i en els actes reflexos.
• Anomena les glàndules endocrines i explica com realitzen la coordinació.
• Anomena les funcions dels sistemes esquelètic i muscular.
• Classifica els ossos i els músculs i anomena els principals del cos humà.
• Definix articulació i explica com es produïx la contracció muscular.
• Anomena els hàbits saludables per als òrgans dels sentits, l’aparell locomotor i els sistemes nerviós i endocrí.






imatges















a) Quin tipus de receptors es representa en l’esquema?
b) En quin dels sentits intervenen?
c) Quin tipus d’estímul capta cada un d’aquests receptors?
4 Observa el procés representant en la imatge i contesta.


a) A quin tipus d’acte correspon?
b) Quin òrgan de coordinació intervé en aquest procés?
c) Redacta un text explicatiu breu per a cada una de les etapes d’aquest procés indicades en la il·lustració.
5 Quina anomalia de la visió s’observa en aquesta imatge? Explica a què es deu i com es pot corregir.

3 Observa la imatge i respon. 4 1 3 2
Interpreta
1
2
3


Aplica
6 Indica quina part de l’ull és la responsable de:
a) Enfocar la imatge.
b) Contindre els cons i els bastons.
c) Protegir la còrnia.
d) Regular el pas de la llum.
7 Per què un constipat pot provocar una infecció d’orella?
8 Quan prenem un medicament que té un sabor desagradable, moltes vegades ens tapem el nas; per què?
9 Establix les diferències entre:
a) Miopia i astigmatisme.
b) Epífisi i diàfisi d’un os.
c) Tendó i lligament.
d) Esquinç i luxació.
e) Dendrita i àxon.
10 Classifica i anomena.
a) Els receptors segons l’estímul que capten.
b) Les articulacions segons la capacitat de moviment.
c) Les neurones segons la funció que realitzen.
d) Les drogues segons el tipus d’acció.
11 Raona per què una persona pot morir si es pega un colp a la nuca.
12 Explica quin tipus de sistema nerviós autònom actua davant d’una situació de perill i per què.
REFLEXIONA
Avança
13 El nivell de glucosa en la sang, glucèmia, està regulat per dues hormones produïdes pel pàncrees: la insulina i el glucagó.

Nivell baix de glucosa.
Nivell alt de glucosa.

Pàncrees

Glucagó segregat per les cèl·lules del pàncrees.

El fetge descarrega glucosa en la sang.
Insulina segregada per les cèl·lules del pàncrees.
Es restablixen els nivells normals de glucosa en sang.


Les cèl·lules prenen glucosa de la sang.
a) Observa l’esquema i redacta un text en què expliques com té lloc la regulació de la glucèmia en la sang.
b) Quina malaltia apareix quan l’organisme perd la capacitat de generar insulina?
En aquesta primera unitat ens hem posat en la pell d’una persona que ha patit un accident de trànsit amb possibles conseqüències permanents. Hem comprés la funció tan important que tenen els òrgans dels sentits i la importància de mantindre el bon estat del nostre sistema nerviós. Reflexiona sobre el teu aprenentatge omplint el qüestionari i la rúbrica, disponibles en anayaeducacion.es
Aspectes
Soc capaç d’explicar amb les meues paraules el que significa la funció de relació i la importància que té per a la vida.
POSA A PROVA LES TEUES COMPETÈNCIES
Fes l’autoavaluació competencial inclosa en anayaeducacion.es
U 4
Recorda seleccionar el material de treball d’aquesta unitat per al dossier d’aprenentatge.
Totalment aconseguit Bastant aconseguit AconseguitQuasi aconseguit












Aparells per a la funció de reproducció
MARIE-ANNE VICTOIRE GILLAIN BOIVIN.
Una ginecòloga sàvia
Creus que nàixer és fàcil? Pensa-ho un moment. En el nostre primer pas cap al món hi ha mil pedres amb les quals es pot entropessar. Una hemorràgia a l’úter, una posició incorrecta del fetus, una infecció, un error en el desenvolupament embrionari... i s’ha acabat. No tastaràs mai el xocolate, ni veuràs la mar, ni llegiràs aquest text... No existiràs mai.
Em dic Marie-Anne Victoire Gillain Boivin i vaig dedicar la meua carrera a intentar resoldre la infinitat de problemes que es poden donar durant l’embaràs. Vaig nàixer en un suburbi parisenc en 1773. Les monges d’un convent en Étampes em van educar i em van ensenyar les bases de la medicina fins que, durant la Revolució Francesa, el lloc va ser destruït. Afortunadament, el meu talent havia cridat l’atenció d’Isabel de França, la germana menor del rei Lluís XVI, qui em va donar l’oportunitat d’estudiar anatomia i formar-me com a comare.
En 1800 vaig començar a treballar a la maternitat de l’hospital de Versalles, on la meua habilitat per a diagnosticar i resoldre casos complicats prompte em va fer guanyar el respecte dels meus col·legues de pro-

fessió. Al llarg de la meua carrera vaig convéncer un dels ministres de Napoleó perquè fundara una escola de comaratge a París, vaig formar part de diverses societats mèdiques i fins i tot vaig ser directora d’alguns dels hospitals on vaig treballar.
A mesura que aprofundia en el camp de la ginecologia, vaig recopilar els meus mètodes i coneixements en diversos manuals que vaig escriure, vaig il·lustrar i vaig pintar jo mateixa. Feliçment, s’han traduït a nombrosos idiomes, i alguns s’han usat durant més d’un segle! També vaig inventar alguns instruments, com un nou tipus de pelvímetre i un espèculum vaginal. També vaig ser una de les primeres persones a usar l’estetoscopi per a auscultar el batec del fetus. Tot i que vaig tindre una vida modesta, especialment durant els últims anys en què em vaig veure immersa en la pobresa, sé que la meua perseverança i creativitat han facilitat que molts bebés arriben al món de forma segura per a ells i per a les seues mares. Si ho penses, aquesta és una recompensa generosa.
118 5







Què descobriràs?
En aquesta unitat
• Marie-Anne Victoire Gillain Boivin. Una ginecòloga sàvia
1. La reproducció humana
2. Els aparells reproductors
3. Els gàmetes humans
4. Els cicles de l’ovari i de l’úter
5. La fecundació, l’embaràs i el part
6. Salut i planificació reproductiva
• Comprén, reflexiona i posa a prova les teues competències
En anayaeducacion.es
Per a motivar
• Vídeo: Abans de començar
• Coneix més... Marie-Anne Victoire Gillain Boivin.
Per a detectar idees prèvies
• Presentació: Què necessites saber
Per a exposar
• Presentació: Alteracions del cicle ovàric
• Vídeos: La formació d’un nou ésser
Per a exercitar
• Activitats interactives: Aprén jugant; Posa’t a prova
• Taller de ciències: Analitzem dades sobre la igualtat de gènere
I, a més, tota la documentació necessària per a aplicar les claus del projecte.
























SEQÜÈNCIA D’APRENENTATGE

















+ anayaeducacion.es


4.1 4.2 5.1 5.2 6.1 6.2 6.3

La reproducció humana
Els cromosomes





Abans que qualsevol cèl·lula es reproduïsca, l’ADN del nucli es compacta i es condensa per a formar unes estructures anomenades cromosomes. Les cèl·lules humanes tenen 46 cromosomes.
1.1 Característiques de la reproducció humana
La reproducció humana és sexual. Es realitza a través dels gàmetes, que es formen als aparells reproductors masculí i femení. Els gàmetes transmeten part de la informació genètica de cada progenitor al descendent, per la qual cosa s’hi assembla.
Els processos de la reproducció sexual
La reproducció sexual requerix els processos següents:
- La formació dels gàmetes. Els gàmetes humans són l’òvul o gàmeta femení, i l’espermatozoide o gàmeta masculí. Són cèl·lules especialitzades que contenen la meitat de la dotació cromosòmica de la resta de cèl·lules humanes, és a dir, vint-i-tres cromosomes.
L’espècie humana és unisexual; és a dir, les dones produïxen els gàmetes femenins, i els homes, els masculins. A més, presenta diferències anatòmiques entre ambdós sexes, la qual cosa es coneix com dimorfisme sexual.
- La fecundació. És la unió dels gàmetes masculí i femení. D’aquesta unió es forma un zigot o cèl·lula ou. En la nostra espècie, la fecundació és interna i té lloc a l’interior de la dona. Els espermatozoides es depositen a les vies genitals femenines.
- El desenvolupament embrionari. És el conjunt de processos que tenen lloc entre la formació del zigot i la del nou ésser. L’espècie humana és vivípara; és a dir, el desenvolupament embrionari té lloc a l’interior de l’úter de la dona.
- El naixement. És el moment en què el nou ésser humà ix del cos matern i comença a realitzar per si mateix les funcions vitals
COMPRÉN, PENSA, INVESTIGA...
1 Explica què significa que l’espècie humana és vivípara.
2 Raona per què els òvuls i els espermatozoides tenen tan sols 23 cromosomes si els éssers humans tenim 46 cromosomes al nucli de les nostres cèl·lules.
3 Explica les diferències que hi ha entre els conceptes dimorfisme sexual i xual espècie unisexual

4 Imagina que un grup d’extraterrestres arriba a la Terra i que ets la persona seleccionada per a comunicar-se amb ells. Una de les teues tasques és explicar-los les característiques de la reproducció humana. Escriu el text que enviaries a aquest grup d’extraterrestres.
120
1
1.2 La maduresa sexual
Quan un ésser humà naix, el seu aparell reproductor està totalment format, però no és funcional.
En l’adolescència, durant la pubertat, gràcies a la producció de les hormones sexuals, es produïxen els canvis fisiològics i psicològics que doten l’home i la dona de capacitat sexual i reproductora.







Analitzem l’adolescència













maduresa psicològica










L’inici de la pubertat no és igual per a totes les persones. Respon aquestes qüestions i comenta amb les companyes i els companys com se senten en passar per aquests canvis.
• A quina edat vau començar a notar els canvis físics que es descriuen en aquest apartat?
• Us preocupa l’acne? Esbrineu què és exactament, quines en són les causes i les pautes mèdiques recomanades per a tractar-lo.
• Què creus que significa que durant l’adolescència s’adquirix una certa maduresa psicològica? Com creus que afecta això les relacions amb les persones del teu voltant?
• Pregunta a persones majors pròximes a tu què recorden sobre les seues sensacions en aquesta etapa de canvi. S’assemblen les seues experiències a les teues?











121 U 5

Els aparells reproductors
L’aparell reproductor masculí
ta de perfil
Conduct def
Bufeta urinària


Glàndula de Cowper








Uretra


Escrot


Testicle
Túbul seminífer
Descriu el camí que seguixen els espermatozoides des que es formen als testicles fins que ixen a l’exterior.
COMPRÉN, PENSA, INVESTIGA...
1 Definix escrot i ot pròstata
2 Raona per què creus que són necessaris tant el líquid que es produïx a les glàndules de Cowper com el que es genera a la pròstata.
2.1 L’aparell reproductor masculí
L’aparell reproductor masculí té la funció de produir els espermatozoides i depositar-los a les vies genitals femenines, per a facilitar que es troben amb l’òvul.
Està format pels testicles, les vies genitals masculines, el penis i diverses glàndules.
- Els testicles són les gònades masculines. Estan situats fora de la cavitat abdominal en un replegament de pell, a tall de bossa, denominat escrot. Cada testicle està format per nombrosos conductes fins enrotllats, denominats túbuls seminífers, on es formen els espermatozoides. A més, els testicles són glàndules endocrines, que vessen a la sang hormones sexuals masculines com la testosterona.
- Les vies genitals masculines són l’epidídim, els conductes deferents i la uretra.
• L’epidídim. És un conducte enrotllat, situat a la part superior de cada testicle. Hi desemboca la xarxa de tubs del testicle i s’hi emmagatzemen els espermatozoides.
• Els conductes deferents. Connecten l’epidídim amb la uretra.
• La uretra. Hi desemboquen els conductes deferents. Per aquesta, el semen i l’orina ixen a l’exterior.
- El penis és un òrgan cilíndric que acaba en un eixamplament denominat gland. Està cobert per una capa de pell, el prepuci. La funció del penis és depositar els espermatozoides a l’interior de les vies genitals femenines
- Les glàndules són glàndules exocrines que vessen les seues secrecions als conductes deferents, on s’unixen als espermatozoides per a formar el semen. Aquestes glàndules són:
• Les vesícules seminals. Segreguen substàncies que nodrixen els espermatozoides.
• La pròstata. Segrega substàncies que activen la mobilitat dels espermatozoides.
• Les glàndules de Cowper. Produïxen una secreció lubricant que neutralitza l’acidesa de la uretra i la vagina.
122
2
Vis
2.2 L’aparell reproductor femení
L’aparell reproductor femení té la funció de produir els òvuls, facilitar que es troben amb els espermatozoides i nodrir i albergar l’embrió després de la fecundació.
Està format pels ovaris, les vies genitals femenines i la vulva.
- Els ovaris són les gònades femenines. La forma i la grandària d’aquests òrgans són semblants a les d’una ametla. Estan situats a l’interior de la cavitat pelviana i contenen nombrosos òvuls immadurs, formats durant la gestació de la dona. A més de produir els gàmetes, els ovaris són glàndules endocrines, que vessen a la sang hormones sexuals femenines, com els estrògens i la progesterona.
- Les vies genitals femenines són les trompes de Fal·lopi, l’úter i la vagina.
• Les trompes de Fal·lopi són dos conductes que connecten els ovaris amb l’úter. Presenten un eixamplament en forma d’embut, amb prolongacions que recobrixen l’ovari per a arreplegar l’òvul. L’interior està entapissat per un epiteli de cèl·lules, els cilis del qual ajudaran a transportar l’òvul cap a l’úter.
• L’úter o matriu és un òrgan situat al centre de la cavitat pelviana, la forma i grandària del qual són semblants a les d’una pera. Està constituït per una paret gruixuda de teixit muscular, que delimita una cavitat interna entapissada per un epiteli denominat endometri o mucosa uterina. A l’interior s’implanta i s’alimenta l’embrió, després de la fecundació. La part de l’úter que connecta amb la vagina, més estreta, es denomina coll uterí.
• La vagina és un conducte de parets flexibles que connecta l’úter amb l’exterior.
- La vulva està formada per dos plecs de pell, anomenats llavis.
COMPRÉN, PENSA, INVESTIGA...
3 Les parets de les trompes de Fal·lopi estan compostes de cèl·lules ciliades, mentre que les de l’úter estan cobertes d’una capa mucosa.
A què creus que es deu aquesta diferència?
L’aparell reproductor femení














Dibuixa en el quadern l’aparell reproductor femení de perfil i indica’n les parts.
4 Raona per què la uretra està present en l’aparell reproductor masculí i no en el femení.

5 Pensa i compartix en parella. Explica què creus que significa que tots els òvuls d’una dona es formen durant la seua gestació.
123 U 5
Út
Coll uterí
Vulva
Trompa de Fal·lopi
Ovari

Els gàmetes
humans
COMPRÉN, PENSA, INVESTIGA...
1 Definix gàmeta

Els gàmetes són les cèl·lules especialitzades en la reproducció sexual. Els espermatozoides i els òvuls porten la informació genètica dels progenitors, necessària per a la formació de la primera cèl·lula d’un nou ésser.
3.1 Els espermatozoides
Els espermatozoides consten de les parts següents:
- El cap, on es troba el nucli.
- La zona intermèdia, on abunden els mitocondris, que aporten l’energia necessària per a la seua gran mobilitat.
2 Els espermatozoides tenen una estructura anomenada acrosoma. Esbrina’n la funció i la localització. es formen a on fins a formar
- La cua, formada per un flagel molt llarg que li permet moure’s.
L’espermatogènesi
Els espermatozoides o gàmetes masculins són cèl·lules diminutes i mòbils. Es formen als testicles mitjançant un procés anomenat espermatogènesi.
Els espermatozoides es formen als testicles, dins dels tubs seminífers. A les parets d’aquests hi ha unes cèl·lules germinals, que es multipliquen contínuament des de la pubertat. Aquestes cèl·lules es dividixen i experimenten un procés de diferenciació cel·lular que donarà la forma i la funcionalitat de l’espermatozoide.
La formació dels espermatozoides







Observa la imatge i dibuixa un espermatozoide en què indiques cada una de les parts que el formen.
Zona intermèdia









124 3
Cap Cua
3.2 Els òvuls
Els òvuls o gàmetes femenins són cèl·lules grans i immòbils que contenen substàncies nutritives per a alimentar l’embrió. Es formen als ovaris mitjançant un procés anomenat ovogènesi.
Els òvuls consten de les parts següents:
- El nucli, que conté els cromosomes.
- El citoplasma, que conté el vitel, un conjunt de substàncies nutritives que servixen de reserva per a nodrir l’embrió en les primeres etapes del desenvolupament embrionari.
- La membrana, envoltada per la zona pel·lúcida i la corona radiada, que són cobertes que el protegixen.
L’ovogènesi
Els òvuls es formen als ovaris. Durant la gestació, és a dir, quan la dona és encara un embrió, es forma un gran nombre d’òvuls immadurs protegits dins d’unes estructures anomenades fol·licles.
En la pubertat, comença la maduració cíclica dels òvuls. Quan l’òvul madura, augmenta de grandària, es trenca el fol·licle i s’allibera l’òvul; aquest procés es coneix amb el nom d’ovulació. Les ovulacions es prolonguen fins a la menopausa, moment en què cessa la capacitat reproductora de la dona.
Així és un òvul
Citoplasma Membrana pel·lúcida

COMPRÉN, PENSA, INVESTIGA...
3 Descriu el procés d’ovogènesi.
4 Definix menopausa i esbrina quines són les conseqüències que té per a la salut de les dones.
Els òvuls i l’ovulació
Observa la imatge i dibuixa un òvul en què indiques cada una de les parts que el formen.
Creixement del fol·licle i ovulació







1. Creixement i maduració del fol·licle

125 U 5
Corona radiada
Nucli
2. Ovulació
Òvul
C (resta del f

Els cicles de l’ovari
i de l’úter
COMPRÉN, PENSA, INVESTIGA...
1 Elabora una llista amb les hormones relacionades amb el cicle ovàric especificant-ne la funció en cada cas.
2 Explica què és el cos luti i quina relació té amb l’òvul.
3 Si després de l’ovulació es produïx fecundació, hi haurà menstruació durant la fase secretora? Raona la resposta.

4 Busca informació i esbrina per què les afirmacions següents són falses.
a) En el cicle menstrual només hi ha un dia fèrtil. El de l’ovulació.
b) El cicle ovàric es produïx sempre al mateix ovari.
c) El cicle menstrual dura sempre 28 dies.
d) Una forma de calcular l’ovulació és sumar 14 dies al dia en què comença la menstruació.
Els ovaris i l’úter experimenten canvis cíclics controlats per hormones. Aquests canvis estan destinats a produir òvuls i a preparar l’úter per a un possible embaràs.
4.1 El cicle ovàric
El cicle ovàric es repetix aproximadament cada vint-i-huit dies i té lloc en tres fases:
- Fase de creixement fol·licular (dies 1 al 14). La hipòfisi, una glàndula endocrina situada a la base del crani, segrega l’hormona FSH, que estimula la maduració a l’ovari d’alguns fol·licles. Durant aquesta fase, es produïxen estrògens, que són hormones alliberades pels mateixos fol·licles.
- Ovulació (al voltant del dia 14). Un dels fol·licles completa la maduració, es trenca i allibera un òvul. Aquest procés està regulat per un augment dels nivells de les hormones FSH i LH. La hipòfisi és la que segrega aquestes hormones com a resposta als estrògens.
- Fase de formació del cos luti (dies 14 al 28). Les restes del fol·licle formen el cos luti, una estructura que produïx estrògens i progesterona, hormones que preparen l’úter per a un possible embaràs. Si l’òvul no és fecundat, el cos luti degenera, disminuïxen els nivells d’hormones i es reinicia el cicle.
4.2 El cicle uterí
Aquest cicle es produïx simultàniament al cicle ovàric en tres etapes: la menstruació, el creixement de l’endometri o fase proliferativa i fase secretora.
- Menstruació (dies 1 al 5). La part superficial de l’endometri, que està molt gruixuda i vascularitzada, es destruïx i s’expulsa a l’exterior a través de la vagina junt amb la sang que hi ha als seus capil·lars, de manera que es produïx una hemorràgia. Aquesta etapa està relacionada amb la degeneració del cos luti i la disminució dels nivells d’hormones.
- Creixement de l’endometri o fase proliferativa (dies 6 al 14). Una vegada acabada la menstruació i fins a dos dies després de l’ovulació, l’endometri que s’havia perdut en l’etapa anterior es regenera i es vascularitza.
- Fase secretora (dies 15 al 28). Després de l’ovulació, si hi ha fecundació, el cos luti manté la paret interna de l’úter perquè es puga produir el desenvolupament de l’embrió. Si no es produïx la fecundació, el cos luti degenera, abaixen els nivells hormonals i es produïx una nova menstruació que reinicia el cicle.
126
4
Els cicles de l’ovari i de l’úter i la seua regulació hormonal
3 Les parets de l’úter continuen engrossint-se fins que es produïx una nova menstruació. L’òvul degenera si no ha sigut fecundat.












1 Menstruació: el cos degenera i la part superficial de l’endometri es desprén.








Menstruació 3 1 2

Ovulació









2 Quan s’ha completat la menstruació i fi ns a dos dies després de l’ovulació, l’endometri es regenera i es vascularitza.
Observa els gràfics i indica com són els nivells de les hormones que hi apareixen abans, durant i després de l’ovulació.

Esbrina la funció de cada una d’aquestes hormones en el cas que es produïsca la fecundació.
127 U 5
0 15 5 10 0 10 20 30 40 50 Estrògens Progesterona Hormones
ovàriques Hormones hipofisiàries
LH FSH 10 11 12 13 14 15 16 17 18 19 20 21 22 23 24 25 26 27 28 29 2
3 4 5 6 7 8 9 1

La fecundació, l’embaràs i el part
5.1 La fecundació i la formació de l’embrió
La fecundació és la unió d’un espermatozoide i d’un òvul per a formar una nova cèl·lula: el zigot. El procés té lloc a les trompes de Fal·lopi. El desenvolupament embrionari és el procés que té lloc entre la fecundació i el part; en els éssers humans dura al voltant de quaranta setmanes.
De la fecundació a la formació de la placenta i de l’amni
- Després de la fecundació, el zigot, que seguix el seu camí cap a l’úter, experimenta les primeres divisions cel·lulars que donaran lloc a l’embrió.
- Quan l’embrió arriba a l’úter, es fixa a l’endometri. Aquest procés es coneix com implantació.
- Per a protegir l’embrió quan ja s’ha implantat, es formen la placenta i l’amni. La placenta és un òrgan que connecta l’embrió amb la mare a través del cordó umbilical. La funció que té és permetre l’intercanvi de substàncies com els nutrients, l’oxigen i els rebutjos. L’amni és una bossa plena de líquid amniòtic en la qual l’embrió es troba immers i protegit.
La fecundació i la implantació
1 Fecundació






Espermatozoides


2 Primeres divisions del zigot
3 Implantació Òvul



Observa la imatge i copia-la en el quadern indicant les parts de l’aparell reproductor femení en les quals es produïxen la fecundació, les primeres divisions del zigot i la implantació.




128 5
El desenvolupament continua
- El primer trimestre: les divisions cel·lulars continuen i es desenvolupen la majoria dels òrgans de l’embrió. Al voltant de la setmana 7 es forma el cap, passa a anomenar-se fetus i mesura al voltant d’11 mm.
- El segon trimestre: comença a ossificar-se l’esquelet i madura el sistema nerviós, el fetus comença a moure’s i a tindre certs reflexos. Al voltant de la setmana 18 comença a sentir i en la 26 els pulmons comencen a madurar.
- El tercer trimestre: el fetus augmenta de grandària i maduren tots els òrgans, comencen a créixer els cabells i els moviments es fan més freqüents i intensos. A partir de la setmana 37, els ossos estan totalment desenvolupats, però encara són flexibles i blans, i els pulmons són completament funcionals. En el moment del part, el fetus fa entre 45 i 50 cm, i pesa un poc més de tres quilograms.
5.2 El part
Després de les quaranta setmanes de gestació, la hipòfisi de la mare allibera l’hormona oxitocina, que provoca contraccions a l’úter, amb la qual cosa comença el part. L’oxitocina estimula també la secreció de llet, de la qual s’alimentarà el bebé durant els primers mesos de vida. El part comprén tres fases: la dilatació, l’expulsió i el deslliurament.
La fase de dilatació
A causa de les contraccions uterines, cada vegada més regulars i freqüents, el coll de l’úter es dilata, fins a aconseguir un diàmetre d’uns deu centímetres. Durant aquesta fase, la bossa amniòtica es trenca i es produïx l’alliberament del líquid amniòtic a través de la vagina.
La fase d’expulsió
Les contraccions són més intenses i freqüents i espenten el fetus cap al coll uterí. La mare ajuda en l’expulsió contraient els músculs abdominals. Quan el nounat està a l’exterior, el personal sanitari lliga i talla el cordó umbilical, la qual cosa contribuïx a l’activació del seu aparell respiratori.
La fase de deslliurament
Noves contraccions fan que es desprenga la placenta i que s’expulse fora del cos, junt amb les restes de la bossa amniòtica i del cordó umbilical.
8 setmanes









COMPRÉN,
PENSA, INVESTIGA...
1 Anomena les fases del part i explica, breument, el que passa en cada una.

2 Pense - m’interessa - investigue. Usa aquesta estratègia de pensament per a explicar com es produïxen els embarassos de bessons monozigòtics i heterozigòtics. Aprén a usar aquesta estratègia de pensament amb el recurs disponible en anayaeducacion.es
129 U 5
El desenvolupament embrionari
30 setmanes
16
setmanes

Salut i planificació reproductiva
Alguns mètodes anticonceptius
Consistix a elaborar un calendari del cicle menstrual per a predir quan es produirà l’ovulació. És molt poc fiable i no prevé les ITS.
És una tècnica d’esterilització que consistix a tallar o lligar les trompes de Fal·lopi. No prevé les ITS.

6.1 Els mètodes anticonceptius
Els mètodes anticonceptius permeten la planificació familiar i alguns ajuden a previndre infeccions de transmissió sexual (ITS).










És una tècnica d’esterilització que consistix a tallar i segellar els conductes deferents perquè els espermatozoides no arriben a formar part del semen. No prevé les IT ITS.






























Impedix l’ovulació. Requerix prescripció i control mèdic. Es pot administrar en pastilles, pegats o injeccions. No prevé les ITS.




Són cremes, gels o càpsules que es col·loquen a la vagina i que inactiven o destruïxen els espermatozoides. No són molt eficaços per si sols i no prevenen les ITS.








Consistix a detectar el moment de l’ovulació per l’increment xicotet de temperatura que es dona en aquest moment del cicle. És molt poc fiable i no prevé les ITS.
Impedix mecànicament la trobada entre gàmetes. És l’únic mètode que prevé les ITS. Pot ser masculí o femení.




















És un objecte que dificulta la fecundació i impedix la implantació de l’embrió a l’úter. Requerix control i revisions mèdiques periòdiques. No prevé les ITS.









És una membrana de goma que es col·loca a l’úter. Requerix assessorament ginecològic per a usar-lo i no prevé les ITS.
130 6
6.2 La infertilitat i les seues causes
La infertilitat és la impossibilitat de poder tindre fills. Pot ser tant masculina com femenina.
Causes de la infertilitat
- En el cas de la infertilitat femenina, les principals causes són la falta o escassetat d’òvuls, anomalies en l’úter i l’obstrucció de les trompes de Fal·lopi.
- En el cas de la infertilitat masculina, les principals causes són l’absència o anomalies en els espermatozoides i les malformacions de les gònades o de les vies genitals.
6.3 La reproducció assistida
La reproducció assistida es pot realitzar per mitjà de diverses tècniques que dependran de la causa de la infertilitat. En l’actualitat, les més utilitzades són la inseminació artificial i la fecundació in vitro
La inseminació artificial
La inseminació artificial és una tècnica senzilla que se sol utilitzar quan el nombre d’espermatozoides es baix o la qualitat de l’esperma no és bona.
Consistix a obtindre els espermatozoides del semen i depositar-los directament a l’úter femení, a través de l’instrumental adequat, de manera que s’evita la barrera defensiva que suposa el coll de l’úter.
6.4 La fecundació in vitro i transferència d’embrions
La fecundació in vitro i transferència d’embrions (FIVTE) és una tècnica més complexa que la inseminació artificial. En aquesta, la fecundació es realitza a l’exterior del cos femení, en una placa de laboratori. Aquesta tècnica requerix els passos següents:
- S’estimulen els ovaris amb hormones, perquè produïsquen molts òvuls.
- S’extrauen els òvuls.
- Es realitza la fecundació (FIV). S’unixen els òvuls i els espermatozoides, prèviament obtinguts de la parella o donant, en una placa de vidre, en una proporció d’un òvul per cada 70 000 espermatozoides.
- Es cultiven els embrions i se seleccionen els més viables. A Espanya s’autoritza, a més, la selecció d’embrions amb finalitats terapèutiques; per exemple, per a curar un germà malalt a través de les cèl·lules mare del cordó umbilical.
- Es transferixen els embrions (TE). Després del cultiu, els embrions seleccionats es depositen a l’úter per mitjà d’una cànula. La resta de l’embaràs es desenvolupa com qualsevol altre.
Fake news
A continuació, tens diverses afirmacions relacionades amb els mètodes anticonceptius. Digues quines són vertaderes i quines són falses justificant la resposta. Afig a la llista un altre mite relacionat amb els anticonceptius que hages escoltat.
• No hi ha risc d’embaràs en la primera relació sexual.
• Si conec molt la persona, no hi ha risc de contraure ITS.
• Tots els anticonceptius hormonals tenen efectes adversos.
• L’únic mètode anticonceptiu que protegix també contra les ITS és el preservatiu.
• Els anticonceptius hormonals reduïxen la fertilitat posterior. Comenteu en grup quantes de les afirmacions falses havíeu sentit. Per què creus que hi ha tants mites sobre aquest tema?
131 U 5
Epidemiologia de la gonorrea
Incidència d’infecció gonocòccica
Nombre de casos i taxa per 100 000 hab. Espanya 1995-2016
6.5 Les infeccions de transmissió sexual (ITS)
Les infeccions de transmissió sexual o ITS són malalties infeccioses, la principal via de contagi de les quals és el contacte directe a través de les relacions sexuals.
Segons el tipus de patogen que les causa, podem classificar-les en: ITS causades per bacteris, ITS causades per virus i ITS causades per altres patògens.
ITS causades per bacteris
Les principals són:
- Clamidiosi: està causada pel bacteri Chlamydia trachomatis. El període d’incubació sol oscil·lar entre una i tres setmanes. Alguns dels símptomes en dones són increment de secrecions, coentor en orinar i xicotets sagnats espontanis.
En homes provoca irritació i picor al gland, dolor en orinar i secreció per la uretra d’un exsudat clar paregut al de la gonorrea. Es pot contagiar el fetus durant l’embaràs i arribar a provocar avortaments espontanis. Es tracta amb antibiòtics.
Casos notifi cats
Observa el gràfic i contesta les preguntes.
a) Què ha passat amb la gonorrea i la sífilis en els últims anys?
b) Amb què creus que poden tindre relació aquestes xifres al llarg dels anys?
c) Esbrina quins són els factors de risc per a contagiar-se d’aquestes malalties.

d) Grup nominal. En grups, dissenyeu una campanya de prevenció d’ITS especialment orientada a les persones joves.
- Gonorrea: la causa el bacteri Neisseria gonorrhoeae. El període d’incubació sol ser de dos a cinc dies. Pot ser asimptomàtica, especialment en les dones. Els principals símptomes quan es produïx la infecció a la uretra dels homes són: augment del nombre de miccions acompanyades de dolor i aparició d’una secreció uretral espessa de color groc verdós.
Es pot contagiar al fetus durant el part, la qual cosa danya habitualment els ulls. És un bacteri amb una gran capacitat de generar resistència als antibiòtics.
- Sífilis: està causada pel bacteri Treponema pallidum. El període d’incubació és de 21 dies. Es caracteritza per la presència d’una lesió anomenada xancre que no sol ser dolorosa.
Aquesta lesió sol aparéixer al penis i als llavis majors. En estats avançats, augmenta el nombre de lesions, que poden aparéixer en altres parts del cos. Els símptomes poden ser molt variats i, si no hi ha tractament, poden conduir, amb el pas dels anys, a complicacions greus, fins i tot a la mort.
132 6 Salut i planificació reproductiva
7 000 6 000 5 000 4 000 3 000 2 000 1 000 0 1995 1996 1997 1998 1999 2000 2001 2001 2003 2004 2005 2006 2007 2008 2009 2010 2011 2012 2013 2014 2015 2016 16 14 12 10 8 6 4 2 0
Casos gonocòccia Taxa gonocòccia Casos sífilis Taxa sífilis
ITS causades per virus
- Herpes: està causada pel virus de l’herpes simple (VHS). El període d’incubació oscil·la entre set i deu dies. Els símptomes són malestar, febra i aparició de lesions en genitals i anus. El tractament és simptomàtic, ja que no té cura.
- Síndrome d’immunodeficiència adquirida (SIDA): està causada pel virus de la immunodeficiència humana (VIH). Després de la infecció, pot estar latent durant molt de temps; no obstant això, si no hi ha tractament, dona lloc a la malaltia en el 100 % dels casos. És la ITS més greu, ja que el virus ataca els limfòcits i deixa la persona infectada sense defenses davant de qualsevol altre patogen. El virus es transmet a través de la sang, el semen, les secrecions vaginals, la placenta i la llet materna. Es tracta per mitjà de fàrmacs antiretrovirals, però encara és incurable. Es calcula que cada any moren al món més de mig milió de persones per malalties relacionades amb la sida.
- Malalties causades pel virus del papil·loma humà (VPH): actualment és la infecció amb un nombre més gran de persones afectades. Existixen més de 60 varietats del virus la gravetat dels quals varia de ser asimptomàtics a provocar càncer de coll d’úter. Actualment, s’inclou una vacuna contra el VPH en el calendari de vacunació.
ITS causades per altres patògens
- Lladelles: són insectes ectoparàsits de l’espècie Phthirus pubis. S’alimenten de sang que absorbixen a través de la pell. Provoquen picor que pot derivar en dermatitis. Es tracten amb sabons especials que destruïxen els insectes i els seus ous.
- Tricomoniasi: causada per protozous de l’espècie Trichomonas vaginalis. Sol ser una malaltia asimptomàtica en homes, però que pot provocar vaginitis en les dones. El període d’incubació oscil·la entre quatre i set dies. Es tracta amb un medicament antiparasitari.
- Candidiasi: està provocada per fongs de l’espècie Candida albicans i altres del mateix gènere. Pot no transmetre’s per contacte sexual. El període d’incubació oscil·la entre dos i cinc dies. Provoca picor, dolor i inflamació. Es tracta per mitjà d’antifúngics que aconseguixen curacions entre el 80 i el 90 % dels casos.
6.6 Reproducció i hàbits saludables
Moltes de les malalties relacionades amb la reproducció ho estan, al seu torn, amb hàbits saludables. Alguns d’aquests són:
- Mantindre una higiene diària, especialment dels genitals, per a evitar infeccions.
- Realitzar revisions mèdiques especialitzades.
- Davant de qualsevol dubte, demanar informació a persones qualificades.
- Evitar el consum de tabac i d’alcohol.




COMPRÉN, PENSA, INVESTIGA...
1 Anomena les ITS transmeses per bacteris.

2 Esbrina en què consistix la vacuna contra el VPH i com es fa aquesta vacunació a la Comunitat Valenciana.

3 El VIH es va identificar en els anys huitanta del segle xx. Investiga sobre com es va identificar i sobre la recerca de tractaments, i escriu un informe breu amb les fites més importants sobre la història del virus. Fotografia realitzada amb microscopi electrònic d’un exemplar de lladella (Phthirus pubis). Les lladelles fan entre un i tres mil·límetres. La part final de les potes està modificada i forma un ganxo que utilitzen per a fixar-se al borrissol púbic.
133 U 5











COMPRÉN




Organitza les idees
1 Mapa conceptual jeràrquic. Copia i completa en el quadern el mapa conceptual següent sobre la reproducció humana. Aprén a usar aquest organitzador amb el recurs disponible en anayaeducacion.es.
ELS APARELLS REPRODUCTORS
L’aparell reproductor masculí
Gònades masculines ? Penis
Gàmetes masculins ?
Hormones sexuals masculines ?
L’aparell reproductor femení
Vies genitals femenines Vies genitals masculines
Gònades femenines ? Glàndules Vulva
Escrot Epidídim ? ? ? ? ? ? ? ? Pròstata ?
Gàmetes femenins ? Trompes de Fal·lopi
Hormones sexuals femenines ?
Fes un resum
2 Elabora el teu resum de la unitat seguint aquest guió.
• Cita els processos que requerix la reproducció sexual.
• Fes una llista dels canvis físics i psicològics que es produïxen durant l’adolescència.
• Descriu l’anatomia de l’aparell reproductor masculí.
• Descriu l’anatomia de l’aparell reproductor femení.
• Explica què és l’espermatogènesi i com són els espermatozoides.
• Explica què és l’ovogènesi i com són els òvuls.
• Relaciona el cicle ovàric i el cicle uterí fent referència a les seues fases.
• Explica on i com es produïx la fecundació.
• Detalla les fases del desenvolupament embrionari i del part.
• Anomena els mètodes anticonceptius detallant si prevenen o no les ITS.
• Explica què són les ITS i anomena les més comunes.
• Compara la inseminació artificial i la fecundació in vitro.






Interpreta imatges



3 Observa la imatge i respon.










a) Quin procés de la reproducció representa?
b) Anomena les parts assenyalades i els processos indicats en l’esquema.

c) Redacta un text breu explicatiu sobre el procés.
4 Observa les imatges següents i respon les qüestions.


a) Ordena les imatges.

b) A quin procés de la reproducció corresponen?
c) Anomena cada una de les fases del part representades i explica-les breument.
5 Quins mètodes anticonceptius es mostren en les imatges següents? En què es basen? Prevenen les ITS?









1 2 3 A B D C
A B C
A B C

Recorda seleccionar el material de treball d’aquesta unitat per al dossier d’aprenentatge.

Aplica
6 Ordena els processos següents segons l’ordre en què tenen lloc.
a) Fecundació.
b) Part.
c) Formació de gàmetes.
d) Desenvolupament embrionari.
7 Raona si els canvis següents es produïxen en l’adolescència o no.
a) Més maduresa psicològica.
b) Creixement del pèl al cap.
c) Eixamplament dels malucs.
d) Ossificació dels ossos.
e) Aparició de borrissol al pubis i a les axil·les.
f) Agreujament de la veu.
8 Descriu el recorregut que realitzen els espermatozoides des que es formen fins que, a través del coit, arriben a l’òvul i el fecunden.
9 Explica per què el període fèrtil d’una dona comprén més dies que el de l’ovulació.
10 Establix les diferències entre:
a) Òvuls i espermatozoides.
b) Fecundació i gestació.
c) Fecundació in vitro i inseminació artificial.
REFLEXIONA
11 Raona si és el mateix naixement que deslliurament.
12 Definix infertilitat i cita’n les principals causes en t homes i en dones.
13 Explica per què el preservatiu és el mètode anticonceptiu més recomanable per a la prevenció de les ITS.
14 Cita les hormones sexuals femenines i masculines indicant-ne la funció principal.
Avança
15 En cursos anteriors has estudiat que, a més de la reproducció sexual, hi ha un altre tipus de reproducció: la asexual.
a) Explica els avantatges i els desavantatges d’ambdós tipus de reproducció.
b) Cita alguns exemples d’éssers vius que tinguen reproducció asexual.
16 El diagnòstic previ a la implantació permet analitzar genèticament un embrió obtingut per fecundació in vitro, abans de transferir-lo a l’úter. Busca informació sobre aquesta tècnica i respon.
a) Quan es pot realitzar aquest diagnòstic i en què consistix?
b) Quin tipus de malalties s’hi poden previndre?
c) És possible seleccionar el sexe de l’embrió? En quins casos està permés legalment?
En aquesta unitat ens hem posat en el lloc d’una parella que té problemes per a tindre descendència i hem analitzat les causes i les solucions possibles per al problema. També hem investigat les diferències de seguiment i d’intervenció durant l’embaràs i el part. Reflexiona sobre el teu aprenentatge omplint el qüestionari i la rúbrica, disponibles en anayaeducacion.es
Aspectes
Entenc com es produïx la funció de reproducció: fases i llocs del cos on té lloc cada una.
Soc capaç de distingir els conceptes zigot, embrió i fetus
POSA A PROVA LES TEUES COMPETÈNCIES
Fes l’autoavaluació competencial inclosa en anayaeducacion.es
U 5
Totalment aconseguit Bastant aconseguit AconseguitQuasi aconseguit










Vida sana
JAMES MCCUNE SMITH. L’esperança d’un poble




T’imagines com és pertànyer a una altra persona? Que el teu cos i les teues accions siguen propietat d’un altre... Això és el que significa ser esclau. Em dic James McCune i abans de dedicar-me a la medicina vaig ser un dels últims esclaus a Nova York. Vaig nàixer en 1813, però la meua vida, la vertaderament meua, va començar quan vaig ser alliberat 14 anys després. Vaig créixer sol amb ma mare, que també era esclava. Ella em va enviar a estudiar a l’«African Free School», un dels pocs llocs on s’educava els xics negres. Allà vaig demostrar ser un alumne excel·lent, sensible al patiment alié. El meu professorat em va animar a estudiar Medicina, però em van rebutjar totes les universitats de Nova York per ser afroamericà.
Un dels meus professors, el Reverend Peter Williams, em va proposar intentar-ho a la Universitat de Glasgow a Escòcia. I allà que vaig anar!, armat només amb la meua intel·ligència i amb els diners que el meu professor i alguns dels seus socis havien reunit per a ajudar-me. En 1837 em vaig graduar en Medicina i vaig ser el primer de la meua classe. A partir d’aleshores vaig començar a exercir com a ginecòleg i vaig publicar els meus primers articles. Els primers escrits per
un metge afroamericà! En aquella època hi havia un altre ginecòleg, Hannay, que tractava els seus pacients de gonorrea d’una forma dolorosa i, al meu entendre, ineficaç. Hauria sigut més fàcil mantindre’m al marge, però soc incapaç d’ignorar aquestes coses, de manera que em vaig posar mams a l’obra. Vaig entrevistar pacients de Hannay, vaig recopilar dades sobre el seu tractament i les vaig comparar amb les d’altres opcions. Vaig ser pioner a usar l’estadística per a traure conclusions. Vaig reunir tota la meua investigació en un article que va acabar amb les pràctiques de Hannay, cosa que em va alleujar molt.
Quan vaig tornar a Nova York, em van rebre com un heroi. Vaig obrir la meua consulta per a atendre tot tipus de pacients, sense discriminació. Vaig muntar una escola i una farmàcia, i després vaig treballar més de 20 anys com a metge d’un orfenat. Vaig publicar desenes d’articles sobre medicina i en contra de l’esclavitud i del racisme...
Així i tot, mai em van admetre en l’Associació Mèdica Americana. Que hi podem fer! La meua contribució a la comunitat afroamericana i a la humanitat en general és igual de valuosa.
136
6







Què descobriràs?
En aquesta unitat
• James McCune Smith. L’esperança d’un poble
1. La salut i la malaltia
2. Els tipus de malalties
3. El medi ambient i la salut: One Health
4. La transmissió de les malalties infeccioses
5. El sistema immunitari
6. Prevenció i curació de malalties infeccioses
7. Els trasplantaments i la donació
8. Els primers auxilis
• Comprén, reflexiona i posa a prova les teues competències
En anayaeducacion.es
Per a motivar
• Vídeo: Abans de començar
• Coneix més... James McCune
Per a detectar idees prèvies
• Presentació: Què necessites saber
Per a exposar
• Infografia: La circulació sanguínia
• Presentació: Emergències sanitàries en el segle XXI ; El cicle d’un retrovirus: el cas del VIH
• Vídeos: La importància de llavar-se les mans
Per a exercitar
• Activitats interactives: Aprén jugant; Posa’t a prova
• Taller de ciències: Analitza la composició del tabac
I, a més, tota la documentació necessària
per a aplicar les claus del projecte.
























SEQÜÈNCIA D’APRENENTATGE

















+ anayaeducacion.es


7.1 7.2 7.3 8.1 8.2 8.3 9.1 9.2

La salut i la malaltia
COMPRÉN, PENSA, INVESTIGA...
1 Definix salut i malaltia
2 Enumera els factors que influïxen en la salut.

3 De segur que en algun moment de la teua vida has patit alguna malaltia. Explica quins símptomes tenies, com et senties i quant de temps vas estar malalt. Escriu un text breu explicant-ho en el qual hauràs d’anotar també, si el recordes, el nom de la malaltia.
4 Compartiu a classe els vostres records i comproveu si heu patit malalties semblants. A què creieu que es deuen les diferències o les similituds que heu trobat en el grup?
5 La inclusió de la idea de benestar social en la definició de salut va suposar allunyar-se d’allò purament biològic. Per què creus que aquest fet es considera un avanç important?


1.1 Què són la salut i la malaltia
La salut és l’estat ple de benestar físic, mental i social, i no la mera absència de malaltia, segons l’Organització Mundial de la Salut (OMS), una organització que coordina a escala internacional els afers sanitaris.
El benestar físic s’aconseguix quan el cos funciona correctament; el benestar mental i social, quan hi ha un equilibri entre treball, família, amistats i oci, que permet a les persones desenvolupar les seues capacitats i ser felices.
La malaltia és una alteració de la salut que es manté durant un període de temps.
1.2 Factors que influïxen en la salut
- Les nostres característiques genètiques poden determinar l’aparició de malalties d’origen genètic, com la síndrome de Down.
- El nostre estil de vida, que és el conjunt d’activitats que realitzem en la nostra vida diària, pot propiciar l’aparició de malalties. Per exemple, la falta d’exercici físic i una alimentació inadequada afavorixen l’obesitat; el consum de drogues i d’alcohol, o no dormir les hores suficients, provoquen malalties en el sistema nerviós; una mala higiene afavorix l’aparició de diverses malalties, causades per organismes patògens (virus, bacteris...).

- El medi ambient, que ens exposa a contaminació, organismes patògens, soroll, etc., i que causen diversos danys al nostre organisme.
- La salut pública, que s’encarrega d’aplicar els coneixements i els avenços de la medicina per a millorar i conservar la salut de les persones que viuen en un lloc determinat. Algunes mesures de salut pública són el control sanitari dels aliments, de l’aigua potable, de les malalties contagioses, dels residus, etc. No obstant això, aquestes mesures de salut pública no estan a disposició de la gran majoria de la població mundial.
Aquests factors poden influir en la nostra salut de forma positiva o negativa.
138 1
1.3 El desenvolupament d’una malaltia
Quan una persona se sent malalta, acudix a un centre sanitari i exposa a la doctora o al doctor els símptomes que té, que són l’expressió dels danys que una persona malalta percep en el seu organisme. Aquests símptomes poden ser dolor, nàusees, marejos, etc. Els professionals sanitaris exploren el pacient i demanen proves per a buscar els signes de la malaltia, que són alteracions quantificables com la febra o la quantitat de sucre en sang.
L’actuació de la medicina davant d’una persona malalta
Als centres sanitaris, els professionals de la medicina apliquen un protocol per a aconseguir la curació de la malaltia:
- El primer pas és parlar amb el pacient i efectuar una exploració física. Si és necessari, se sol·liciten proves diagnòstiques; per exemple, una anàlisi de sang i d’orina o una radiografia.
- A partir de les proves diagnòstiques s’obtenen una sèrie de signes clínics que, units als símptomes que ha expressat el pacient i als coneixements dels professionals, permeten fer un diagnòstic; és a dir, identificar la malaltia.
- A continuació, es proposa una teràpia o tractament, que és el conjunt d’accions destinades a la curació de la malaltia. El tractament és molt variat i pot incloure prescripció de medicaments, cirurgia, canvis en la dieta, etc.
- Totes les dades recopilades queden registrats en un document: la història clínica del pacient. En aquesta figura el seguiment de la salut d’una persona al llarg de la seua vida.
1 S’identifica i es valora l’emergència.

2 Les autoritats del país on s’ha produït l’emergència emeten una alerta i sol·liciten cooperació internacional.

La resposta global a una emergència sanitària

Taula redona. De vegades es produïxen emergències sanitàries a les quals un país no pot fer front per si sol. Per això, hi ha institucions com l’OMS, l’ONU o l’AECID (Agència Espanyola de Cooperació Internacional per al Desenvolupament) que, junt amb nombroses ONG, actuen per a ajudar a resoldre-les. En l’esquema que pots veure més avall es reflectix com sol ser el protocol d’actuació en aquestes situacions; observeu-lo i contesteu les preguntes.
a) Per què es dividix l’actuació en tants treballs concrets?
b) En quines circumstàncies creieu que pot ser necessària una d’aquestes intervencions? Busqueu-ne alguns exemples i les institucions que han intervingut.
3 Les institucions internacionals confirmen l’alerta i, si és necessari, solliciten la intervenció d’agències de l’ONU i privades (ONG).
5 El govern local, les agències de l’ONU i les ONG s’organitzen per a cobrir totes les necessitats.
Informació Alerta Aigua i sanejament





4 Les agències de l’ONU i les ONG valoren l’emergència i preparen la intervenció sobre el terreny.




6 La intervenció es desenvolupa fins que l’emergència queda solucionada.

7 Les institucions que han participat en la intervenció fan un seguiment fins a assegurar que es torna a la normalitat.
139 U 6
Alimentació Tractament Seguretat Logística

Els tipus de malalties
Malalties genètiques

2.1 Com classifiquem les malalties
Hi ha nombroses malalties que es poden classificar, segons quines en siguen les causes, en infeccioses i no infeccioses.
2.2 Les malalties no infeccioses




Les malalties no infeccioses no estan provocades per organismes patògens, sinó per altres causes (accidents, envelliment, etcètera), i no es transmeten d’unes persones a altres.
La classificació de les malalties no infeccioses
Segons la causa que les produïx, les malalties no infeccioses es poden classificar en toxicològiques, genètiques, nutricionals, al·lèrgiques, autoimmunes, mentals, traumàtiques, degeneratives, endocrines i metabòliques.















- Toxicològiques. Es produïxen per toxines, substàncies que originen trastorns greus, fins i tot la mort. Les causen picadures de serps o d’aranyes, aliments en mal estat o la ingestió de drogues o de medicaments.



Com, per exemple, Com, per exemple,
- Genètiques. Es deuen a alteracions en l’ADN, heretades de pares a fills o produïdes espontàniament. Alguns exemples en són l’hemofília, la síndrome de Down o alguns tipus de càncer.











COMPRÉN, PENSA, INVESTIGA...
1 Explica quines característiques ha de tindre una malaltia per a ser considerada com no infecciosa.

2 Tria una malaltia no infecciosa i elabora un informe breu en què n’inclogues el nom, les causes i el tractament, si n’hi ha.
- Nutricionals. Les ocasiona la mancança o l’excés de determinats nutrients, a causa d’una mala absorció o d’hàbits alimentaris inadequats. En són exemples l’escorbut, l’anèmia i l’obesitat.
- Al·lèrgiques. Es deuen a una reacció de defensa exagerada de l’organisme enfront d’una substància externa inofensiva, com el pol·len, els àcars o el pèl dels gats.
- Autoimmunes. Les causa una reacció anormal de defensa de l’organisme contra si mateix. Per exemple, en la psoriasi l’organisme reacciona contra el propi teixit epitelial.
- Mentals. Són trastorns del sistema nerviós, causats per factors genètics o ambientals, que afecten la conducta. En són exemples la depressió, l’esquizofrènia i l’anorèxia.
- Traumatismes. Són alteracions de la pell o de l’aparell locomotor, degudes a accidents. Alguns exemples en són les fractures, els esquinços i les luxacions.
- Degeneratives. Les origina el desgast dels òrgans, com les cataractes als ulls, l’artritis a les articulacions o l’alzhèimer al cervell.
- Endocrines i metabòliques. Es deuen a la secreció excessiva o deficient d’una hormona, com la insulina en la diabetis, i a un funcionament defectuós en les reaccions químiques a l’interior de les cèl·lules, com l’hipercolesterolèmia.
140
2
2.3 Les malalties infeccioses
Les malalties infeccioses estan causades per organismes patògens (bacteris, virus, protozous i fongs) o per una substància produïda per aquests. La majoria d’aquestes malalties es transmeten d’unes persones a altres.
Una infecció és la invasió i multiplicació de microorganismes al cos d’una persona.
Exemples d’aquestes malalties són l’amigdalitis, el refredat comú o la toxoplasmosi.
Els agents infecciosos
Els agents infecciosos, o organismes patògens, destruïxen les cèl·lules, bé directament, bé per mitjà de la producció de toxines, unes substàncies que maten les cèl·lules o que n’alteren els processos fisiològics. No tots els agents infecciosos provoquen el mateix dany a la persona a la qual envaïxen.
S’anomena virulència la facultat d’un agent infecciós per a causar alteracions. La virulència depén de la capacitat d’invasió i de la de produir toxines.
Hi ha gèrmens, com el bacteri del tètan, amb poca capacitat d’invasió, però molt virulents, a causa de la gran toxicitat que tenen.
Alguns agents infecciosos
Els bacteris
Pertanyen al regne de les moneres; són organismes unicellulars amb cèl·lules de tipus procariota. No tots són danyosos per als éssers humans, però poden causar malalties com la pneumònia o el còlera.




Els fongs
Els fongs són organismes unicel·lulars o pluricel·lulars formats per cèl·lules eucariotes. La majoria no són perjudicials per als éssers humans, però n’hi ha alguns que poden provocar malalties com la clamidiosi o l’aspergil·losi.
COMPRÉN, PENSA, INVESTIGA...
3 Definix toxina i virulència

4 Alguns organismes fabriquen toxines que poden resultar mortals. Busca el nom i el tipus de l’organisme que fabrica la toxina botulínica. Quina aplicació es dona a aquesta toxina en medicina?
5 Els telèfons mòbils fan que ens exposem a una gran quantitat de patògens que poden ser perjudicials.
a) Com creus que els patògens arriben fins al telèfon?
b) Explica què creus que pots fer per a evitar aquest perill.
c) Comenta com creus que pots usar el mòbil per a millorar la teua salut.

Els protozous




Pertanyen al regne dels protoctists; són organismes unicellulars amb cèl·lules de tipus eucariota. No tots provoquen malalties en els éssers humans, però poden causar malalties com la malària o la malaltia de Chagas


Els virus
Són agents infecciosos que no estan formats per cèl·lules i estan obligats a parasitar cèl·lules d’altres éssers vius per a multiplicar-se. Causen malalties com la grip o la sida.













141 U 6

El medi ambient i la salut: One Health
3.1 One Health
El concepte One Health, creat per l’Organització Mundial de la Salut, és una proposta per a millorar la salut dels éssers humans des d’un enfocament multidisciplinari.
Aquest enfocament proposa que la millora en la salut dels ecosistemes i de tots els éssers vius, especialment dels animals, té una relació directa amb la millora de la salut humana.
Canvis socials que promouen l’enfocament One Health



El creixement ràpid de la població humana i la seua expansió a noves àrees geogràfiques.



La destrucció d’ecosistemes i el canvi climàtic fan que les poblacions animals es desplacen.



L’increment del contacte dels éssers humans amb animals, tant les mascotes com a les explotacions ramaderes.



El moviment d’animals i de persones entre diferents països ha augmentat.
142
3
3.2 Nous costums, nous riscos
Com ja hem vist, en les últimes dècades s’han produït molts canvis socials al món les conseqüències dels quals encara s’analitzen. Alguns d’aquests canvis són:
- Dispersió de malalties: l’augment de la quantitat de persones, béns i animals que es mouen cada dia pel món fa que tant les malalties com els seus vectors es dispersen amb més rapidesa.
- Més superbacteris: expansió dels bacteris resistents a antibiòtics a causa de l’ús massiu d’aquestes substàncies en ramaderia i per un ús inadequat en humans.
- Zoonosi: moltes malalties d’origen animal tenen més possibilitats de començar a afectar els éssers humans.
- Malalties agrícoles i ramaderes: s’expandixen a gran velocitat i amenacen tant el subministrament d’aliments per a la població com l’economia de grans zones del món.
- Amenaça als subministraments d’aigua: la contaminació i el canvi climàtic reduïxen els subministraments d’aigua disponibles per a l’ús i el consum humans.
3.3 Actuacions One Health
Les principals actuacions en les quals l’enfocament One Health pretén treballar són:
- Disminuir l a possibilitat que es produïsquen epidèmies en animals i que aquestes es transmeten als éssers human s; per exemple, reduir la destrucció d’ecosistemes que provoquen el desplaçament de poblacions salvatges o augmentar la seguretat i el control en la indústria alimentària mundial.
- Augmentar la regulació en l’ús d’antibiòtics, tant en humans com en la ramaderia, per a reduir les poblacions de bacteris resistents a antibiòtics.
- Incloure la ciència de la salut de la vida silvestre com un component essencial de prevenció, vigilància, monitoratge, control i mitigació global de malalties.
- Millorar i universalitzar l’atenció sanitària per a previndre els brots i la dispersió de malalties.

Les zoonosis





Les zoonosis són malalties que es transmeten de forma natural entre els animals i els éssers humans.
- Zoonosis alimentàries: es transmeten en consumir aliments contaminats: salmonel·losi, triquinosi, listeriosi, etc.
- Zoonosis no alimentàries: transmeses amb vector o sense vector.
• Amb vector: leismanoisis, malaltia de Lyme, malària, malaltia de Chagas, etc.
• Sense vector: ràbia, hidatidosi, psitacosis.
COMPRÉN, PENSA, INVESTIGA...
1 Explica amb les teues paraules en què consistix l’enfocament One Health

2 El Ministeri d’Agricultura, Pesca i Alimentació considera que la brucel·losi, la salmonel·losi, la triquinosi i la tuberculosi són algunes de les zoonosis que han d’estar vigilades contínuament a Espanya. Tria una d’aquestes malalties, investiga-la i explica en què consistix i com es transmet dels animals als éssers humans.
3 Justifica com la destrucció d’ecosistemes pot fer que es produïsca el brot d’una malaltia.
143 U 6

La transmissió de les malalties infeccioses
4.1 Formes de transmissió
Els agents infecciosos o organismes patògens ens envolten. Es poden trobar en l’aire, en els aliments, en l’aigua, en el sòl, fins i tot en els animals i en les persones. Aquests mitjans són fonts d’infecció i de transmissió de malalties. La transmissió pot tindre lloc:
- Per contacte directe amb el malalt, com en la sida i la sífilis.
Mites i contagis






De segur que alguna vegada has escoltat ordres com «No vages descalç que et refredaràs». Observa les imatges i contesta les preguntes.
a) En quina creus que és més probable que algú agafe un refredat? Argumenta la resposta.
b) Com creus que es produiria el contagi?

c) Viatges en l’espai i en el temps. Creus que fa dos segles la gent hauria respost d’una altra forma? Per què? Per a saber com aplicar aquesta estratègia de pensament, consulta anayaeducacion.es
- A través de l’aire, de l’aigua i d’objectes o aliments contaminats, com és el cas de la grip, el còlera o la salmonel·losi.
- Per mitjà de vectors de transmissió, que, generalment, són animals. Per exemple, la malària es contagia per la picadura d’un mosquit, la ràbia, pel mos de gossos infectats.
Vies d’entrada
L’entrada dels agents infecciosos en les persones es pot produir per:
- Via cutània. La nostra pell pot tindre talls, arraps o altres lesions per on poden penetrar els patògens. Aquests es distribuïxen a través de la sang per tot l’organisme.
- Via respiratòria. L’aire que respirem pot contindre bacteris o virus que entren a través de l’aparell respiratori.
- Via digestiva. Els gèrmens penetren quan prenem aliments o aigua contaminats.
- Via genitourinària. Els patògens poden entrar de diferents formes, com, per exemple, per contacte sexual.
COMPRÉN, PENSA, INVESTIGA...
1 Enumera les vies d’entrada dels agents infecciosos.
2 Classifica en el quadern com es transmeten les malalties següents i busca les vies de transmissió d’aquelles que no conegues: la ràbia, el còlera, la grip, la fenilcetonúria, la psoriasi, el dengue, l’Ebola, la malaltia de Chagas, l’anorèxia, la parotiditis i la candidiasi.
3 Explica almenys una mesura per a evitar contagiar-te d’una malaltia respiratòria, d’una digestiva i d’una genitourinària.
144 4
4.2 Desenvolupament de les malalties infeccioses
Les malalties infeccioses es caracteritzen per l’aparició de distints símptomes, entre els quals estan la febra, el malestar general o el decaïment. Totes aquestes malalties passen per un període d’incubació, un de desenvolupament i la convalescència.
El període d’incubació
El període d’incubació és el temps transcorregut entre l’entrada del germen i l’aparició dels primers símptomes. En aquesta fase, el microorganisme es multiplica i envaïx el cos.
El període de desenvolupament
El període de desenvolupament és aquell en què apareixen els símptomes característics de la malaltia. Per exemple, les bambolles cutànies de la varicel·la o les erupcions rogenques de la pallola.
La convalescència
Aquesta és l’etapa final, en la qual ha desaparegut l’agent infecciós i l’organisme es recupera dels danys patits durant la malaltia.
La malària
Observa la infografia i respon:
• Quin és el nom del paràsit que causa la malaltia? Com arriba la malaltia als humans?
• Escriu un informe sobre la mortalitat de la malària, la incidència que té i quines mesures es poden adoptar per a previndre-la.
• Recentment, l’OMS ha certificat l’eliminació de la malària a la Xina; busca informació sobre com s’ha aconseguit això.
• Busca informació sobre la vacuna RT,S/AS01 i explica si ha sigut eficaç o no.
1 El mosquit injecta el paràsit Plasmodium en un ésser humà.

5 El paràsit es reproduïx sexualment dins del mosquit i dona lloc a les cèl·lules que es poden transmetre als éssers humans.





4 Els paràsits arriben als mosquits a través de glòbuls rojos infectats amb les formes que es poden reproduir sexualment.



El cicle de vida en els mosquits.





El cicle de vida en els éssers humans.

Cèl·lula hepàtica

Cèl·lula parasitària



2 Els paràsits arriben a les cèl·lules hepàtiques i es multipliquen fins que les trenquen.

Formes sexuals del paràsit




Formes asexuals del paràsit
3 Els paràsits passen a la sang i infecten els glòbuls rojos, on es reproduïxen asexualment diverses generacions fins que sorgixen noves formes del paràsit que es poden reproduir sexualment.
145 U 6

El sistema immunitari
La resposta immunitària inespecífica
1 A través d’una ferida entren agents infecciosos que danyen el teixit. Els macròfags, un tipus de fagòcits, comencen a destruir els patògens i alliberen substàncies que produïxen vasodilatació.






Substàncies que activen la vasodilatació.
2 La vasodilatació pot provocar un augment de la temperatura i afavorix l’arribada de més sang amb altres fagòcits que continuen amb la destrucció de gèrmens.




3 Les restes de fagòcits i de patògens es drenen a través del sistema limfàtic.





El sistema immunitari és el conjunt de mecanismes de defensa que presenta el cos humà davant de les malalties infeccioses.
En l’ésser humà, la resistència enfront de microorganismes patògens es denomina immunitat.
La immunitat és congènita, és a dir, naixem preparats per a defensar-nos d’alguns agents estranys. Aquesta és una immunitat inespecífica, no especialitzada. No obstant això, al llarg de la vida, el sistema immunològic es perfecciona, i això dona lloc a una nova immunitat adquirida. Aquesta és una immunitat específica o especialitzada.
5.1 La immunitat inespecífica
La immunitat inespecífica actua independentment de l’agent causant de la malaltia. La constituïxen les dues primeres barreres defensives: les barreres físiques i la resposta inflamatòria.
Les barreres físiques
Per a evitar que qualsevol agent estrany penetre en el cos, disposem de barreres físiques: la pell, les mucoses i les secrecions.
La pell cobrix l’exterior del cos i les mucoses recobrixen cavitats internes i, ambdues, no deixen passar molts agents patògens. Les secrecions, com la suor, la saliva o l’àcid de l’estómac, contenen unes substàncies antimicrobianes que destruïxen alguns gèrmens.
La resposta inflamatòria
Si per qualsevol motiu (punxada, arrapada o ferida) l’agent infecciós travessa les barreres físiques, té lloc un mecanisme defensiu molt eficaç, la reacció inflamatòria, que comença amb la vasodilatació. La dilatació dels vasos sanguinis facilita l’arribada al teixit de més sang, amb una gran quantitat de fagòcits (un tipus de glòbuls blancs). La zona s’enrogix, s’unfla i augmenta de temperatura. De vegades, aquesta resposta generalitzada provoca un augment de temperatura corporal, denominat febra.
Un dels mecanismes de la resposta inflamatòria és la fagocitosi, que corre a càrrec d’un tipus de glòbuls blancs, anomenats fagòcits, que ataquen, capturen i digerixen internament els patògens.
146
5
5.2 La immunitat específica
La immunitat específica és l’adquirida al llarg de la vida, com a conseqüència de l’exposició de l’organisme a agents infecciosos que han aconseguit superar les barreres inespecífiques.
La resposta immunitària
La resposta immunitària és la que proporcionen els limfòcits, un tipus de glòbuls blancs.
Quan un patogen entra en l’organisme, els fagòcits que el digerixen alerten els limfòcits per mitjà d’unes substàncies que alliberen. Aquests limfòcits fabriquen unes proteïnes denominades anticossos.
Els anticossos s’unixen específicament a aquest patogen i en faciliten la destrucció.
Alguns limfòcits poden perdurar en la sang durant tota la nostra vida, guardant una memòria immunitària de l’agent patogen. Així, davant d’un nou contacte amb l’invasor, la resposta de l’organisme és tan ràpida que la malaltia no arriba a manifestar-se.
Un conte immunològic
L’activitat del sistema immunitari es podria assemblar a una d’aquelles invasions alienígenes, de zombis o de malvats megalòmans que volen dominar el món. En aquesta activitat t’invitem a triar entre la resposta immunitària inespecífica i la resposta immunitària específica i a explicar-les com si fora una història de ciència-ficció. Ací tens algunes pautes que et podrien ajudar:
• Tria els protagonistes i els antagonistes. Aquests poden ser individus o faccions senceres que representen els elements del sistema immunitari i les amenaces a què s’enfrontaran.
• Plantejament, nus i desenllaç. Estructura la història tenint en compte aquests tres elements.
• Pots investigar i triar un tipus concret d’infecció i de resposta immune que t’ajude a detallar més la història.
Quan tota la classe haja escrit la seua història, llegiu-les en veu alta i tracteu d’identificar quins personatges o situacions representen cada element i procés del sistema immunitari.
La resposta immunitària específica
1 Quan el patogen entra en l’organisme, un fagòcit el digerix i allibera unes substàncies que alerten alguns limfòcits i s’activen.


Patogen ogen


Limfòcit
Fagòcit


3 Els limfòcits fabriquen anticossos específics per a lluitar contra aquest patogen.




2 Els limfòcits activats es multipliquen per a lluitar contra el patogen.

4 El patogen és destruït pels anticossos que fabriquen els limfòcits.


147 U 6

Prevenció i curació de malalties infeccioses
Mesures específiques de prevenció
DENGUE ZIKA
Contra algunes malalties, per l’extrema gravetat que presenten o per la gran quantitat de persones que afecten, les autoritats apliquen mesures extraordinàries.
6.1 La prevenció
La salut de les persones està relacionada amb l’estil de vida i amb els hàbits diaris. Alguns hàbits saludables, que poden previndre l’aparició de malalties, són:
- Tindre accés a un sistema sanitari de qualitat.
- Estructures bàsiques de sanejament com clavegueram i accés fàcil a l’aigua potable.
- Portar una alimentació equilibrada i realitzar exercici físic.
- Seguir un horari regular, que proporcione el descans necessari, i evitar el consum de substàncies tòxiques, com les drogues o el tabac.


Cobrix les finestres i el llit amb malles antimosquit.

Buida i neteja els contenidors d’aigua.

Usa repel·lents d’insectes efectius.

Vist roba que cobrisca bé el cos.
Llig detingudament la informació i respon les preguntes.
a) Veient les mesures de prevenció del dengue i de la febre del Zika, com creus que es contagien? Justifica-les.
b) Escriu una altra malaltia a la qual es podrien aplicar les mesures de prevenció del dengue i de la febre del Zika.
c) Per què creus que són tan importants les campanyes de prevenció contra aquestes malalties?
- Previndre els riscos que poden causar malalties i accidents.
- Cuidar la nostra higiene personal i practicar la medicina preventiva, seguint les vacunacions oficials i acudint regularment al metge.
La importància de la higiene
Fins que a mitjan segle XIX Joseph Lister va desenvolupar un mètode per a esterilitzar l’instrumental mèdic, les intervencions quirúrgiques tenien un risc enorme de complicar-se amb infeccions que causaven una gran mortalitat als hospitals. El seu mètode d’esterilització es basava en l’aplicació d’un tipus d’alcohol a l’instrumental i a les mans del personal mèdic.
Hui en dia, la llavada de mans continua sent la principal forma de previndre malalties que podem practicar. Durant el dia entrem en contacte, a través de les mans, amb una gran quantitat de patògens que poden entrar en el nostre organisme, o ser contagiats a altres persones, en entrar en contacte amb les mucoses d’ulls, boca o nas. Es calcula que una llavada de mans adequada pot reduir les infeccions intestinals fins en un 40 %, i les respiratòries, fins en un 21 %.
COMPRÉN, PENSA, INVESTIGA...
1 Explica amb les teues paraules en què consistix la prevenció de malalties infeccioses anomenant algunes estratègies per a dur-la a terme.

2 Actualment hi ha nombrosos mètodes per a aconseguir l’esterilització del material mèdic. Busca dues d’aquestes tècniques i descriu en què consistixen.
148 6
6.2 Les vacunes
Les vacunes són preparats que contenen patògens debilitats o alguns dels seus components, que poden provocar la resposta immunitària sense causar la malaltia.
Les vacunes són una forma d’immunització artificial. La funció que tenen és introduir en l’organisme un agent patogen que ha perdut la capacitat infecciosa, bé perquè ha sigut prèviament debilitat, bé perquè no conté tots els seus components. No obstant això, el patogen manté la capacitat de provocar la resposta dels limfòcits, per la qual cosa la persona desenvolupa anticossos i queda immunitzada.
Encara que hi ha exemples anteriors d’immunització artificial, la primera vacunació, contra la pigota humana, la va realitzar el metge anglés Edward Jenner en 1796. Des d’aleshores, les vacunes han salvat moltes vides i han permés eradicar malalties de gran impacte per a l’ésser humà.
El moviment antivacunes

1-2-4. Llig el text següent i contesta les preguntes.
El moviment antivacunes
L’any 2019, l’OMS va incloure el moviment antivacunes com una de les qüestions que les autoritats sanitàries havien d’abordar per a evitar l’auge de malalties que es poden previndre.
A pesar que nombroses investigacions científiques han desmentit els seus arguments, aquests moviments seguixen actius. Alguns d’aquests arguments falsos són que les vacunes contenen substàncies perilloses o que la immunitat adquirida naturalment és millor que l’obtinguda per mitjà de vacunes.
a) Busca la teua cartilla de vacunació i anota contra quines malalties tens protecció.
b) Busca informació sobre una malaltia erradicada gràcies a la vacunació.
c) Com convenceries una persona antivacunes que aquestes són segures i que beneficien tota la societat? Fes una llista d’arguments.
d) Fes una llista amb els riscos per a la salut individual i col·lectiva que provoca la falta de vacunació.
Així actua una vacuna
1 S’injecta un agent patogen que ha perdut la capacitat infecciosa (patogen debilitat).





2 Aquests patògens provoquen la resposta dels limfòcits i la persona genera anticossos específics per a aquest patogen.



3 Quan entra el patogen sense debilitar, els anticossos generats el reconeixen.


4 Els anticossos reaccionen contra els patògens i els destruïxen.


149 U 6
La resistència als antibiòtics
Busca informació en la pàgina web de l’OMS sobre el problema que representen els bacteris resistents als antibiòtics. Després, llig atentament la informació i contesta les qüestions següents.
• Havies sentit parlar alguna vegada d’aquest problema?
• Quin creus que és l’ús indegut d’antibiòtics a què es referix l’OMS?
• Analitza la infografia inferior i explica amb les teues paraules com es produïx la resistència als antibiòtics.
• Els bacteris que desenvolupen aquest tipus de resistència es coneixen com superbacteris. A què creus que es deu això?
• Esbrina quines són les recomanacions de l’OMS per a tractar aquest problema i anota les que creus que podries aplicar personalment.

6.3 El tractament de malaties
Un dels motors més importants en el desenvolupament de la societat humana és l’avanç de la medicina, que ha permés a l’ésser humà prolongar i millorar les seues condicions de vida.
Entre altres progressos mèdics, el desenvolupament de substàncies terapèutiques, com els sèrums o els antibiòtics, tenen una importància vital en la curació de les malalties infeccioses.
Els sèrums immunològics
Els sèrums són preparats que contenen anticossos per a fer front als agents patògens.
Els sèrums s’utilitzen per a curar malalties contra les quals la persona no està immunitzada o no ha sigut vacunada.
Els sèrums es poden obtindre de la sang d’altres animals, que han sigut prèviament immunitzats contra una malaltia, ja que, durant un cert temps, es mantenen els anticossos generats contra el microorganisme causant de la malaltia.
Els antibiòtics
Els antibiòtics són substàncies que impedixen el creixement dels bacteris.
Els antibiòtics són substàncies naturals produïdes per alguns fongs, com un mecanisme de defensa enfront de determinats bacteris, contra els quals competixen per l’aliment.
El primer antibiòtic va ser la penicil·lina, descoberta pel metge anglés Alexander Fleming en 1928. Actualment, els antibiòtics se sintetitzen químicament de forma artificial.



En una població bacteriana hi ha alguns bacteris que són resistents als antibiòtics.
Els antibiòtics maten tots aquells bacteris no resistents, també els que són beneficiosos per a l’organisme.
Els bacteris resistents ara no tenen competència per a créixer i multiplicar-se.
Alguns bacteris poden transferir la seua capacitat de resistència a altres que no la tenien.
150
malalties
6 Prevenció i curació de
infeccioses
Els antivirals
Els antivirals són substàncies que s’usen per al tractament de malalties causades per virus.
Els medicaments antivirals són més complexos d’obtindre que altres fàrmacs com els antibiòtics. Això es deu a les limitacions que té el maneig dels virus al laboratori, i també al fet que hi ha poques molècules eficaces contra els virus que es descobrixen i al difícil equilibri entre eficàcia contra el virus i toxicitat per als pacients que tenen aquestes molècules.
Una de les primeres molècules utilitzades per a tractar infeccions víriques van ser els interferons, que són un grup de proteïnes que genera de forma natural l’organisme com una part de la resposta immunitària i que van aconseguir aïllar-se i produir-se artificialment per a usar-se com a medicaments.
Medicaments simptomàtics
A diferència dels antibiòtics o dels antivirals, que tracten directament la causa de la malaltia, aquests medicaments només alleugen alguns dels símptomes que genera la malaltia, la qual cosa dona temps a l’organisme per a recuperar-se.
Els dos grups de medicaments més habituals per al control dels símptomes de malalties infeccioses són:
- Els antiinflamatoris: tenen la funció de rebaixar la inflamació i, com a conseqüència, solen reduir el dolor. Molts tenen també funció antitèrmica i poden abaixar la febra. Alguns dels més habituals són l’ibuprofén o el naproxén.
- Els analgèsics: la seua funció és alleujar el dolor i també solen tindre efecte antitèrmic. El més habitual és el paracetamol.
- Els antihistamínics: són medicaments indicats per a reduir els efectes de les al·lèrgies. Tenen la funció de bloquejar l’acció de la histamina, una substància que allibera l’organisme quan reacciona davant d’un al·lergen.
Els riscos dels medicaments
Abans que un medicament siga apte per al consum humà, passa per nombrosos controls i proves per a comprovar que és eficaç i segur. No obstant això, tots els fàrmacs poden produir efectes secundaris; per això, és fonamental que el seu ús estiga sempre prescrit per un professional sanitari i llegir detingudament el prospecte.
Teràpia amb bacteriòfags
5 S’alliberen nous virus complets.




4 Es formen nous virus complets.
1 El virus reconeix el bacteri i s’hi fixa.
2 L’ADN del virus entra en el bacteri.



3 Es formen parts del virus dins del bacteri.
A causa del problema que suposa la resistència als antibiòtics que desenvolupen molts bacteris, es busquen formes noves de combatre’ls. Una de les més prometedores és el tractament amb virus bacteriòfags, un grup de virus que usen els bacteris per a reproduir-se i, en el procés, els destruïxen. Allò més prometedor d’aquest tipus de teràpia és que permetria dissenyar virus específics per a un tipus concret de bacteri.
COMPRÉN, PENSA, INVESTIGA...
3 Explica les dificultats amb què es troba la ciència a l’hora d’investigar els antivirals.
4 Argumenta la importància del fet que l’ús de medicaments estiga prescrit per un professional sanitari.
5 Quan algú emmalaltix de grip, el tractament sol implicar antiinflamatoris i analgèsics. Com relaciones l’acció d’aquests medicaments amb aquesta malaltia?

6 Paraules com posologia, excipient o cipient principi actiu són comunes en els prospectes dels medicaments. Busca’n el significat i anota’l.
151 U 6

Els trasplantaments i la donació
El protocol dels trasplantaments


1 Detecció del potencial donant.
2 Activació del protocol de recerca de receptor. El sistema busca primer entre els casos més greus. Si no hi ha casos extrems, es valoren els casos de la comunitat autònoma, després, a escala nacional i, finalment, es fa una recerca internacional.



7.1 Els trasplantaments
Un trasplantament és la substitució d’òrgans, teixits o cèl·lules malalts d’una persona anomenada receptor per òrgans, teixits o cèl·lules sanes d’una altra persona anomenada donant.
Els trasplantaments han suposat un gran avanç en la medicina per a aquelles malalties que no tenen una altra possibilitat de curació, com, per exemple, la insuficiència renal.
Els tipus de trasplantaments
Hi ha diferents tipus de trasplantaments: els autotrasplantaments, els alotrasplantaments i els xenotrasplantaments.
- Els autotrasplantaments. El donant i el receptor són la mateixa persona. Un exemple en són els autoempelts de pell.




2 Certificació de compatibilitat entre donant i receptor.

3 Notificació al receptor.
- Els alotrasplantaments. El donant i el receptor són de la mateixa espècie però no són genèticament idèntics. El cas més comú és el de trasplantament d’òrgans.





4 Trasllat de l’òrgan del donant al centre hospitalari en què es troba el pacient i realització del trasplantament.
5 Seguiment i tractament postoperatori.



A la vista del protocol, quant de temps creus que pot passar des que es troba un òrgan fins que aquest arriba al pacient?
Esbrina què és el temps d’isquèmia i explica com pot condicionar el procés de l’esquema. És igual el temps d’isquèmia per a tots els òrgans trasplantables?

- Els xenotrasplantaments. El donant i el receptor pertanyen a espècies diferents. Un exemple en són els implants d’ossos de porc en persones.
7.2 La donació
Perquè es realitzen trasplantaments, és necessari que hi haja donants, és a dir, persones sanes que, de forma desinteressada i solidària, cedixen una part del seu organisme a una altra persona que la necessita.
Qui pot donar
Les donacions es poden realitzar:
- Quan el donant està viu. És el cas d’algun teixit renovable, com la sang; d’algun òrgan prescindible, com un renyó; o d’una part d’un òrgan, com el fetge.
- Quan el donant ha mort. En aquest cas, les cèl·lules, els òrgans vitals o els teixits que s’han d’utilitzar s’han d’extraure ràpidament i conservar-se de forma artificial fins al moment de realitzar el trasplantament.
La donació està legislada per a assegurar que es realitze en condicions altruistes i justes. Espanya és el país del món on més donacions es produïxen
152 7
7.3 La compatibilitat i el rebuig
Perquè es puga realitzar un trasplantament amb èxit, és necessari que el donant i el receptor siguen compatibles. Això significa que el sistema immunitari del receptor no reconega les cèl·lules del donant com a estranyes. Si es dona aquesta situació, es produïx un rebuig, i l’òrgan trasplantat és destruït per part del sistema immunitari del receptor.
Les cèl·lules mare
Les cèl·lules mare són cèl·lules indiferenciades, que tenen la capacitat de diferenciar-se i originar distints tipus cel·lulars.
Suposen una gran esperança per a la medicina regenerativa, ja que oferixen la possibilitat d’obtindre teixits totalment compatibles amb l’individu malalt.
Hi ha dos tipus de cèl·lules mare:
- Les cèl·lules mare embrionàries, que formen l’embrió. Tenen capacitat per a generar tots els tipus cel·lulars humans.
- Les cèl·lules mare adultes, presents en tots els teixits, que només poden generar alguns tipus cel·lulars, com les cèl·lules mare de la medul·la òssia.
COMPRÉN, PENSA, INVESTIGA...
1 Enumera els tipus de trasplantaments que hi ha i explica en què consistix cada un.




2 Fes una llista amb els òrgans que es poden donar quan el donant està viu.
3 Un dels problemes més greus que es presenten en les persones trasplantades és que rebutgen l’òrgan que han rebut. Quines mesures es prenen des del punt de vista sanitari per a intentar evitar-ho?

4 Viatges en l’espai i en el temps. Al llarg de la història, la percepció de la societat respecte a la ciència ha canviat. Explica com creus que va ser en l’antiga Roma i en l’Edat Mitjana i compara-ho amb la situació actual. Creus que serà diferent en el futur?
La història de les cèl·lules mare
Descobriment de cèl·lules mare sanguínies en ratolins.
Es descobrixen cèl·lules mare en el cordó umbilical dels éssers humans.
S’aconseguix cultivar en laboratori cèl·lules mare embrionàries de ratolí.
Es creen diverses línies de cèl·lules mare embrionàries de distints animals.
Es clona l’ovella Dolly.




S’aconseguix aïllar cèl·lules mare embrionàries d’éssers humans.
S’aconseguix transformar cèl·lules de la pell en cèl·lules mare per mitjà de tècniques genètiques.
S’aconseguix corregir defectes genètics en cèl·lules mare embrionàries en un laboratori.
Comencen els assajos clínics per a tractar una forma de ceguera per mitjà de cèl·lules mare.
S’aconseguix revertir la degeneració macular (un tipus de ceguera) en dos pacients del Regne Unit.








Observa la línia del temps i respon les preguntes.
a) A què creus que es deu que passe tant de temps des del descobriment de les primeres cèl·lules mare fins que s’apliquen en una teràpia?
b) L’ús de cèl·lules mare embrionàries per a investigació està molt restringit i regulat. Busca informació sobre com s’obtenen aquestes cèl·lules per a la investigació.
153 U 6
1960 1978 1981 1997 1998 2006 2013 2014 2018

Els primers auxilis
El DESA







El desfibril·lador extern semiautomàtic (DESA) o automàtic (DEA) és capaç de diagnosticar i tractar una parada cardiorespiratòria. Actualment, nombroses comunitats autònomes establixen l’obligatorietat de col·locar i mantindre aquest tipus de dispositius en alguns espais públics.
COMPRÉN, PENSA, INVESTIGA...
1 Explica amb un exemple com s’ha d’actuar durant una emergència en què hi haja una persona ferida.
2 Esbrina si al lloc on vius hi ha obligatorietat d’installar dispositius DEA o DESA i, si és així, en quins llocs haurien d’estar instal·lats.
8.1 Què són els primers auxilis
Els primers auxilis són les atencions adequades que es presten a una persona accidentada o amb una malaltia, que apareix de forma sobtada, abans que la puguen atendre en un centre sanitari.
Què cal fer en una situació d’emergència
Davant d’una situació que requerisca primers auxilis, les actuacions bàsiques que s’aconsellen són:
- Mantindre la calma.
- Protegir-se i protegir la persona accidentada o malalta.
- Comprovar que el lloc on es troba el pacient és segur: si el pacient es pot moure, cal ubicar-lo en lloc segur; si no es pot moure, s’ha d’organitzar un cordó humà.
- Avisar els serveis d’emergència (112), indicant quin és el succés i l’adreça exacta del lloc en què s’ha produït.
- Mentre arriben els serveis d’emergència:
• Quan estiga assegurada l’escena del succés, no s’ha de moure el pacient ni desplaçar-lo.
• Parlar amb el pacient, tranquil·litzar-lo i intentar obtindre informació sobre malalties que patix, medicaments que pren...
• Observar el ritme respiratori, acostant la galta a la boca i al nas del pacient, i comprovar els moviments del tòrax. Si el pacient no respira, tornar a informar els serveis d’emergència.
• Comprovar el pols cardíac, però no s’ha d’actuar si no es coneixen les tècniques de reanimació.
8.2 La RCP
La reanimació cardiopulmonar (RCP) de primers auxilis és una tècnica que s’utilitza per a intentar mantindre les constants vitals d’una persona que ha patit una parada cardiorespiratòria fins que se li puguen aplicar tècniques avançades per part del personal sanitari.
Aquesta tècnica no s’ha d’usar sense una formació prèvia per part de professionals qualificats. Aquest tipus de formació se sol obtindre en cursos que moltes institucions oferixen gratuïtament de forma periòdica.
154
8

8.3 La farmaciola escolar
La farmaciola escolar és una caixa fàcil de transportar que pese poc, que tanque hermèticament i que continga els materials necessaris per a fer cures senzilles o alleujar alguns símptomes, com ara la febra, el dolor, etc.
Quins requisits ha de complir
- La farmaciola escolar s’ha d’identificar fàcilment.
- Ha d’estar ubicada en un lloc segur, sec i allunyat de la llum i fora de l’abast de l’alumnat.
- Ha de tindre una llista amb els medicaments i la resta d’elements que conté.
- Els medicaments han d’estar guardats en els envasos originals amb els prospectes corresponents per a conéixer la data de caducitat i les indicacions i les dosis que cal administrar.
- Totes les persones que treballen al centre escolar (professorat, personal administratiu, conserges...) han de conéixer la localització de la farmaciola.
- Ha d’haver-hi una persona responsable de la farmaciola que la revise periòdicament per a reposar el contingut que hi falte.

Antisèptics







Sèrum fisiològic
Medicaments

Corticoides tòpics o llapis d’amoníac per a picades

Què ha de contindre una farmaciola
En la imatge pots veure els elements bàsics que hauria de contindre una farmaciola. Observa’ls i respon les preguntes.
a) Afegiries més elements a la farmaciola? Justifica la resposta.
b) L’alcohol ja no és un producte que s’haja d’usar per a tractar ferides. Esbrina per què i explica per quin motiu creus que està en la farmaciola.
c) Quins números de telèfon creus que seria útil apuntar en la llibreta de la farmaciola?


Antiinflamatoris


Analgèsics


Material de cures
Guants estèrils


Embenatges

Accessoris


Quadern amb telèfons d’emergències







Termòmetre
155 U 6
Sabó
Povidona iodada
Alcohol
Bossa de fred
Clorhexidina
Llanterna i piles de recanvi
Tisores











COMPRÉN




1 Mapa conceptual jeràrquic. Completa en el quadern els espais buits del diagrama d’Ishikawa següent. Aprén a usar aquest organitzador amb el recurs disponible en anayaeducacion.es
Malalties no infeccioses
Toxicològiques
Genètiques
Nutricionals
Al·lèrgiques
Autoimmunes
Mentals
Traumatismes
Degeneratives
Endocrines i metabòliques
Es deuen a Exemples
Es deuen a Exemples
Es deuen a Exemples
Es deuen a Exemples
Es deuen a Exemples
Es deuen a Exemples
Es deuen a Exemples
Es deuen a Exemples
Es deuen a Exemples
Toxines que originen trastorns
Hemofília, síndrome de Down...
Al·lèrgia al pol·len, àcars...
Fes un resum
Depressió, esquizofrènia, anorèxia…
Desgast dels òrgans
2 Elabora el teu resum de la unitat seguint aquest guió.
• Definix salut i malaltia i anomena els factors que influïxen en la salut.
• Explica què són les malalties infeccioses i quins són els agents que les causen.
• Anomena les vies de transmissió i d’entrada al nostre cos dels organismes patògens.
• Indica les fases en què es desenvolupa una malaltia infecciosa.
• Definix sistema immunitari i establix les diferènci- ema es entre immunitat específica i inespecífica.
• Explica com té lloc la resposta inflamatòria.
• Explica com es poden previndre i curar les malalties.
• Indica què és un trasplantament i de quins tipus poden ser.
• Esmenta els possibles donants i explica per què es produïx el rebuig en els trasplantaments.






Interpreta imatges



3 Observa les imatges i respon.









a) Quin tipus d’organismes són i quina classe de malalties produïxen?
b) Anomena tres exemples de malalties causades per aquests tipus d’organismes.
4 Observa el gràfic següent i contesta.




Font: ONU/El nostre món en dades.

Esperança de vida en nàixer per regió — Amèrica del Nord — Europa — Amèrica del Sud — Món — Nord d’Àfrica — Àsia — África subsahariana 1950 1960 1980 2000 1970 1990 2010 2015
a) On hi ha més esperança de vida? I menys?
b) Deduïx les causes de les diferències observades quant a esperança de vida a les diferents parts del món.
c) Com ha evolucionat l’esperança de vida al llarg de les últimes dècades? Per què?
? ? ? ? ? ? ? ? ? ? ? ? ?
40 59,3 72,4 72,4 75,1 77,7 79,5 60 50 70

Recorda seleccionar el material de treball d’aquesta unitat per al dossier d’aprenentatge.
Aplica
5 Indica dos factors que poden influir en la nostra salut positivament i dos que poden fer-ho negativament. Justifica la resposta.
6 Establix les diferències entre:
a) Salut i malaltia.
b) Signe i símptoma.
c) Diagnòstic i teràpia.
d) Resposta inflamatòria i resposta immunitària.
e) Fagòcit i limfòcit.
f) Vacuna i sèrum.
7 Explica què és i de què depén la virulència d’un organisme patogen.
8 Com s’adquirix la immunitat específica? Què són els anticossos? En què consistix la memòria immunitària?
9 Indica si les frases següents fan referència a una vacuna o a un sèrum.
a) És un mètode curatiu.
b) És un mètode preventiu.
c) Conté anticossos.
d) Provoca la resposta immunitària en el pacient.
10 Raona si una persona ha d’estar morta per a ser donant d’un òrgan.
11 Definix cèl·lula mare i indica els avantatges d’utilitzar-les en els trasplantaments.
REFLEXIONA
Recorda que en el banc de recursos disposes de:

• de diversos tallers per a gestionar les teues emocions i d’una diana per a avaluar-les;
• de fitxes per a millorar la teua ciutadania digital.

Avança
12 Responeu en grup.

a) Seleccioneu una malaltia sobre la qual elaborareu un informe detallat del protocol mèdic per a diagnosticar-la i tractar-la.
b) Exposeu la informació a classe mitjançant una presentació.

13 Preparar la tasca. La SIDA (síndrome d’immunodeficiència adquirida) està produïda per la infecció d’un virus, el VIH (virus de la immunodeficiència humana). Investigueu sobre diferents aspectes d’aquesta malaltia i sobre l’agent causal i elaboreu un mural per a exposar-lo a classe.
a) Efecte de l’entrada del virus en el cos humà.
b) Símptomes, conseqüències i tractament.
c) Formes de transmissió de la malaltia.
d) Prevenció.
14 En l’actualitat, el mal ús dels antibiòtics i d’altres medicaments és un dels grans problemes sanitaris a què s’enfronten la societat i la ciència. Respon les preguntes següents sobre aquest fenomen.
a) Quins riscos sanitaris planteja aquest problema?
b) Quines mesures es podrien plantejar per a solucionar-lo?

Al llarg de les dues primeres unitats hem posat a prova l’eficàcia de diversos models de sistemes sanitaris comprovant com respondrien davant d’un accident de trànsit, un embaràs i un part, i, en aquesta unitat, davant de la pandèmia de la COVID-19. Reflexiona sobre el que has aprés omplint el qüestionari i la rúbrica corresponent, disponibles en anayaeducacion.es
Aspectes Totalment aconseguit Bastant aconseguit AconseguitQuasi aconseguit
Entenc el que significa estar sa, comprenc les tres dimensions de la salut.
Valore la importància de tindre un sistema sanitari fort davant d’emergències com la generada per la COVID-19.
POSA A PROVA LES TEUES COMPETÈNCIES
Fes l’autoavaluació competencial inclosa en anayaeducacion.es




U 6



















DOSSIER D’APRENENTATGE
















ÉS UNA EMERGÈNCIA!
Aquesta situació d’aprenentatge t’ha permés analitzar en detall el nostre sistema nacional de salut i dos sistemes més molt diferents: el dels Estats Units d’Amèrica i el de Sudan del Sud.
La matriu DAFO demostra les diferències a l’hora d’accedir a la sanitat en distints llocs. Els països analitzats són només una mostra dels diferents sistemes sanitaris del món i els obstacles són molt distints en cada país. En aquests obstacles i dificultats es reflectix com de lluny estem encara d’aconseguir l’objectiu de desenvolupament sostenible número 3 (Garantir una vida sana i promoure el benestar per a tots en totes les edats).
Tanmateix, la matriu DAFO també ens mostra oportunitats i fortaleses, uns aspectes positius que convé ressaltar i fomentar. Basant-nos en aquestes dades, i ampliant-les amb una recerca en Internet sobre bones pràctiques sanitàries en altres països, us proposem fer en grup un «Decàleg del millor sistema de salut». Es tracta de seleccionar les deu característiques més importants que ha de tindre un sistema de salut per a ser eficaç i per a aconseguir que tota la població hi puga accedir. Això implicarà fer una llista de característiques positives i ordenar-les d’acord amb la major o menor rellevància de cada aspecte identificat. El decàleg resultant es pot presentar en qualsevol format audiovisual: pot ser una presentació, un vídeo o un cartell.
Si voleu que la vostra marca siga encara major, us animem a compartir el decàleg i fer-lo arribar a la major quantitat de gent possible.














TRIMESTRE 2
TAMBÉ POTS PROVAR AQUESTS PROJECTES
Si aquest projecte t’ha resultat interessant i vols investigar més sobre els sistemes sanitaris, ací tens algunes idees per a crear els teus projectes.
Estudi dels sistemes de salut d’altres països
L’elecció de països del repte s’ha fet intentant mostrar tres realitats molt diferenciades, però l’anàlisi es pot realitzar sobre altres països que tinguen aspectes sanitaris diferents al nostre.
Relació entre taxes de mortalitat, l’esperança de vida i els sistemes sanitaris de distints països En comptes de fer una anàlisi molt exhaustiva de tres sistemes sanitaris, podem ampliar el nombre de països estudiats, centrant-nos en un parell de dades. En aquest cas es proposa analitzar si la taxa de mortalitat i l’esperança de vida estan relacionades amb les característiques dels sistemes de salut de cada país.
Estudi de la resposta davant de la COVID-19 de diferents països
Analitzar el que ha passat durant aquesta pandèmia als diferents països ens pot donar una visió molt global de la capacitat de resposta dels distints sistemes de salut pública davant de situacions d’emergència.
REVISA LA TEUA PLANIFICACIÓ
Anàlisi de països coneguts per l’alumnat Podem comparar les experiències que hagen pogut tindre els nostres companys i companyes o els seus familiars i coneguts en sistemes sanitaris diferents de l’espanyol. En aquest cas podria ser interessant diferenciar distints elements que caldria analitzar, com ara atenció primària, urgències i medicina preventiva.
I EL TREBALL EN
GRUP
Revisa la teua planificació del treball i el treball del teu grup en aquest projecte omplint la rúbrica que pots trobar en anayaeducacion.es
PERFIL COMPETENCIAL D’EIXIDA
En finalitzar aquests desafiaments, reflexiona i comprova si has aconseguit els objectius següents. Descarrega la rúbrica en anayaeducacion.es
Descriptor
Utilitze el pensament científic per a entendre i explicar fenòmens adoptant una actitud crítica.
Localitze, seleccione i contraste informació procedent de diferents fonts avaluant-ne la fiabilitat.
Faig recerques avançades en Internet atenent criteris de validesa, qualitat i fiabilitat.
Conec els riscos per a la salut relacionats amb factors socials.
Expresse conceptes i pensaments científics de forma adequada.
Emprenc accions fonamentades, conscients i responsables per a preservar la salut física i mental.


Completa en el quadern


Aconseguit Parcialment aconseguit No aconseguit



























PRESENTACIÓ DE LA SITUACIÓ

Què ha passat a La Palma?





























El nostre paisatge Volcans i

Analitzem mapes de prevenció de riscos
9 INDÚSTRIA, INNOVACIÓ I INFRAESTRUCTURA 11 CIUTATS I COMUNITATS SOSTENIBLES 15 VIDA TERRESTRESD’ECOSISTEMES
terratrèmols Unitat 7 Unitat 8
TRIMESTRE 3



VIURE EN UN VOLCÀ


Mirar al passat per a predir el futur






L’acció dels éssers vius



Elaborem el mapa de prevenció de riscos




Organitzem la informació en un informe










La Terra canviant
ALFRED WEGENER.
Un explorador a la deriva




Els continents s’han mogut. Com més investigava, més força cobrava la idea en la meua ment. Però, com pot ser que una cosa tan immensa s’haja passejat pel planeta? És sorprenent! No obstant això, hi ha proves que ho demostren. Jo les vaig recopilar i les vaig analitzar en la meua teoria de la deriva continental. I sabeu el que va opinar la majoria de la comunitat científica? Que això era una sobirana estupidesa.
Soc Alfred Lothar Wegener. Vaig nàixer a Berlín en 1880, i sempre vaig ser un xic molt mogut. M’encantava escalar, passejar, navegar... I com que, a més, era bon alumne i m’agradaven les ciències naturals, vaig decidir estudiar física, astronomia i meteorologia a la Universitat de Berlín. En 1906 em van oferir participar en una expedició... a Grenlàndia! M’atreia tremendament el repte físic i mental que implica investigar en un entorn brutalment hostil. Vaig passar dos anys allà, explorant la costa i instal·lant la primera base meteorològica. El que he dit, sempre he sigut molt mogut. En tornar a Alemanya, em vaig convertir en un reconegut professor de meteorologia a la Universitat de Marburg. Va ser aleshores quan vaig començar a gestar la meua teoria de la deriva continental. Em resultava
enigmàtic que les costes d’Àfrica i de Sud-amèrica no sols pareixia que encaixaven com les peces d’un puzle, sinó que ocultaven roques i fòssils semblants. Podrien haver estat juntes en algun moment?
En 1915, després de tornar d’una segona expedició a Grenlàndia, vaig publicar L’origen dels continents i oceans, el llibre en què vaig desenvolupar les meues idees sobre la deriva continental. En aquell moment, en plena Primera Guerra Mundial, va passar més bé desapercebut. En 1922 en vaig publicar una versió revisada, i aquesta vegada sí que va cridar l’atenció. No obstant això, com que no vaig poder explicar què provoca el moviment dels continents, la comunitat científica va titlar la meua teoria d’absurda.
Tristament, la meua quarta expedició a Grenlàndia em va costar la vida en 1930. Tenia només 50 anys quan vaig morir en el gel. Va ser una llàstima; a penes tres dècades més tard la meua teoria va ser rescatada i acceptada a la llum dels nous descobriments als oceans. De fet, és la base de l’actual teoria de la tectònica de plaques. M’haguera encantat viure per veure les cares dels qui la van considerar ridícula!
162
7







Què descobriràs?
En aquesta unitat
• Alfred Wegener. Un explorador a la deriva
1. La superfície terrestre i els seus canvis
2. El temps geològic
3. L’energia interna de la Terra i els processos endògens
4. El magmatisme i els volcans
5. Les forces tectòniques
6. Els riscos geològics
• Comprén, reflexiona i posa a prova les teues competències
En anayaeducacion.es
Per a motivar
• Vídeo: Abans de començar
• Coneix més... Alfred Wegener
Per a detectar idees prèvies
• Presentació: Què necessites saber
Per a exposar
• Presentació: Guia de roques; Tipus de vores de plaques
• Vídeos: Així es produïx una erupció volcànica
Per a exercitar
• Activitats interactives: Aprén jugant; Posa’t a prova
• Taller de ciències: Localitzem l’epicentre del terratrémol
I, a més, tota la documentació necessària per a aplicar les claus del projecte.
























SEQÜÈNCIA D’APRENENTATGE

















+ anayaeducacion.es


1.1 1.2 2.1 2.2 3.1 3.2

La superfície terrestre i els seus canvis
L’evolució del relleu. El cicle geològic
Orogènesi: L’energia interna de la Terra produïx moviments a la litosfera que formen volcans i alcen serralades noves. Es creen relleus nous.
Sediments procedents d’un relleu anterior
Serralada en formació



Volcans Moviments de la litosfera
Calor interna de la Terra

Serralada



Gliptogènesi: Els processos exògens del modelat del relleu desgasten les roques i transporten els sediments fins a zones baixes. El relleu queda pla i desgastat, fins que altres processos endògens el reactiven. Es depositen sediments. Els processos exògens erosionen el relleu.





Les formes del relleu terrestre, com una vall, un penya-segat, una muntanya o un volcà, presenten evidències d’haver-se format per fenòmens colossals en què hi ha molta energia involucrada. Aquests fenòmens, que continuen produint-se constantment en l’actualitat, són els processos geològics.
1.1 Els processos geològics
Els processos geològics són tots aquells fenòmens que canvien el relleu de la superfície terrestre i que formen i transformen els diferents tipus de roques.
Depenent de la font d’energia que els impulsa, es distingixen dos tipus de processos geològics: els endògens i els exògens.
Els processos geològics endògens
Els processos geològics endògens estan produïts per l’energia interna de la Terra. Són els fenòmens del magmatisme i les forces que deformen les roques, eleven les serralades, causen terratrémols...
Els processos geològics exògens
Els processos geològics exògens són impulsats per les dinàmiques de l’atmosfera i la hidrosfera que, al seu torn, depenen de l’energia solar i de la gravetat. Són els processos del modelat del relleu.
1.2 Efecte dels processos geològics


Com s’ha explicat, tant els processos geològics endògens com els exògens tenen dos efectes principals en la Terra: l’evolució del relleu i la formació i la transformació de les roques.
L’evolució del relleu
Els processos geològics actuen simultàniament sobre la litosfera i produïxen l’evolució constant de les formes del relleu:
- Els processos endògens solen associar-se amb la creació de relleus nous, ja que produïxen l’elevació de les serralades (orogènesi) o l’aparició de terrenys volcànics, com algunes illes.
- Els processos exògens solen associar-se a la destrucció o al modelat de relleus ja existents (gliptogènesi), per desgast o denudació de les muntanyes fins a transformar-les en planes.
164
1
La formació i la transformació de roques
L’altra conseqüència dels processos geològics és la formació i la transformació dels diferents tipus de roques que observem a l’escorça terrestre i que, si ho recordes, són de tres tipus principals segons l’origen:
- Les roques magmàtiques procedixen de la solidificació de magmes, que són masses de roques que es fonen a l’interior de l’escorça i del mantell a causa dels processos endògens.
- Les roques metamòrfiques s’originen a partir de la transformació en estat sòlid d’altres roques, que són sotmeses tant a pressions com a temperatures elevades pels processos endògens.
- Les roques sedimentàries es formen per la compactació i la cimentació de sediments, és a dir, dels materials resultants de l’acció dels processos exògens sobre les roques exposades a la superfície terrestre.
Els processos geològics endògens i els exògens actuen de forma conjunta i simultània sobre les roques de l’escorça terrestre i les sotmeten a canvis que les formen i les destruïxen, i que es poden resumir en un esquema denominat «cicle de les roques».
El cicle de les roques
1 Formació de roques magmàtiques
Els magmes que procedixen de l’interior de l’escorça se solidifiquen i donen lloc a roques plutòniques i volcàniques.
3 Formació de roques metamòrfiques
Les forces tectòniques i l’energia interna transformen les roques sedimentàries o magmàtiques en unes altres de noves anomenades metamòrfiques.
COMPRÉN, PENSA, INVESTIGA...
1 Explica les diferències entre els processos geològics endògens i els exògens.
2 Respecte als fenòmens de l’orogènesi i la gliptogènesi:
a) Relaciona’ls amb els tipus de processos geològics.
b) Explica per què diem que ambdós fenòmens es produïxen simultàniament.

3 Full giratori. Expliqueu per què el «cicle de les roques» no és realment un procés cíclic.
4 Quines energies intervenen en cada tipus de procés geològic?
5 Quins processos geològics intervenen en la formació dels diferents tipus de roques? Explica la resposta.
2 Formació de roques sedimentàries
Els processos exògens erosionen les roques del terreny i formen sediments. Després, la pressió deguda a la gravetat i a l’energia interna de la Terra compacten aquests sediments i formen roques sedimentàries.









165 U 7

El temps geològic
El Fanerozoic
L’eó Fanerozoic és en el que ens trobem en l’atualidad. Observa l’esquema i respon:
a) En quina era i període ens trobem?

b) Busca informació i completa en el quadern els esdeveniments i les dates aproximades dels períodes en què falta aquesta informació.
c) Els períodes són cada vegada més curts a mesura que ens acostem a l’actualitat. A què creus que es deu això?
Eons Eres
Quasi tots els processos geològics ocorren amb moltíssima lentitud. Per exemple, la coordillera de l’Himàlaia va començar a formar-se fa més de 70 milions d’anys i la mar Mediterrània va començar a omplir-se fa aproximadament 5,3 milions d’anys.
2.1 El temps geològic
El temps geològic és el temps transcorregut entre l’origen de la Terra i el moment actual. Es mesura en milions d’anys (Ma).
Per a estudiar la història de la Terra, que abraça més de 4 600 milions d’anys, es fa necessari dividir el temps en intervals que ens en faciliten la comprensió. Aquests intervals són:
- Els eons són les divisions més grans. S’estenen al llarg de centenars de milions d’anys. Els seus límits coincidixen amb canvis d’abast planetari. Són l’Hadeà, l’Arqueà, el Proterozoic i el Fanerozoic.
- Les eres són intervals en què es dividix cada eó. Els seus límits coincidixen amb grans extincions o amb els moments en què es van formar grans serralades.
- Els períodes són els intervals en què es dividix cada era. Els seus límits són canvis en el registre fòssil o en la composició dels grans blocs de roques sedimentàries.
Períodes
Cambrià
Ordovicià
Silurià
Devonià
Carbonífer
Permià
Triàsic
Juràssic
Cretaci
Paleogen
Neogen
Quaternari
Esdeveniments
Explosió de vida als oceans
La vida colonitza el medi terrestre
Extinció global massiva
Impacte de l’asteroide KT
Aparició de l’Homo sapiens
166
2
ACTUALITAT
Ma FANEROZOIC
Paleozoic Mesozoic Cenozoic 542 251 65 0,2
2.2 Estudiem el passat
La humanitat sempre ha tingut curiositat per saber l’origen de les muntanyes o dels rius i gran quantitat de mites de totes les cultures de la Terra intenten explicar-ho per mitjà de divinitats, personatges heroics i gegants.
El segle XVIII va sorgir un corrent científic, l’actualisme, que plantejava que es podia estudiar el passat de la Terra analitzant els fenòmens naturals actuals.
L’actualisme considera que les mateixes lleis físiques, químiques i biològiques que actuen hui, ho van fer també en el passat geològic, i amb conseqüències similars.
Així, un fenomen que hui afecta les roques, ho va fer de la mateixa manera en el passat de manera que estudiar el present ens ajuda a desxifrar el passat.
2.3 El registre estratigràfic
Totes les roques aporten informació sobre el passat de la Terra: sobre el que va ocórrer durant la seua formació o sobre els fenòmens que les van afectar (deformacions, modelat...). Però són les roques sedimentàries les que més informació aporten. Això es deu a les seues característiques, que resulten de l’evolució de les conques sedimentàries en les quals es van formar i que donen lloc a la formació d’estrats en els quals, molt sovint, trobem un registre fòssil.
Un estrat és una capa de sediments o de roques amb una composició homogènia que es va depositar durant un interval de temps concret.
Amb la informació continguda en un conjunt d’estrats es poden reconstruir i ordenar en el temps els esdeveniments geològics i biològics que van succeir en diferents moments de l’evolució d’una conca.
El registre estratigràfic


C
Estrat B
Estrat A
COMPRÉN, PENSA, INVESTIGA...
1 Explica què és l’actualisme i per què permet estudiar el passat geològic terrestre.
2 Consulta el recurs «La fossilització» que pots trobar en anayaeducacion.es i explica com es formen els fòssils.



Organismes enterrats
En una zona es van depositar en capes superposades materials arrossegats per l’aigua. Cada capa es va formar segons la composició dels sediments que hi arribaven en cada moment. Restes d’alguns organismes hi podien quedar enterrades.


Les capes de sediments es van compactar i van formar una seqüència sedimentària. Les restes d’éssers vius que hi havia entre els sediments es van transformar en fòssils.


Nou estrat

El territori va tornar a quedar submergit, es va reiniciar la sedimentació i es va formar una nova seqüència, disposada sobre l’anterior.



2
1
El pas del temps va fer que la zona tornara a assecar-se i que es puguen veure les dues seqüències de sediments.
167 U 7
Seqüència
Seqüència
Nou estrat (D)
Estrat
Relleu
Seqüències d’estrats
Fòssils
1
2 3
3

L’energia interna de la terra i els processos endògens
3.1 L’energia interna de la Terra
L’interior de la Terra conté una gran quantitat d’energia, denominada energia geotèrmica, que manté les capes més profundes del planeta a temperatures de milers de graus centígrads.
Aquesta energia procedix, en part, del violent origen de la Terra, en el qual l’energia de nombroses col·lisions de planetesimals van formar un planeta molt calent i fos. A més, a l’interior terrestre es produïx calor deguda a la desintegració dels elements radioactius presents en les roques.
La presència d’una litosfera sòlida que aïlla l’interior terrestre de l’atmosfera i de l’espai exterior ha mantingut la calor interna fins al moment actual. Així i tot, la Terra es refreda a poc a poc.
3.2 L’energia mou les roques
L’estructura de la Terra i la convecció al mantell
Fixa’t en la il·lustració del model de l’interior terrestre i:
a) Descriu com està representada la litosfera. És contínua?
b) Explica els moviments ascendents i descendents de materials al mantell.
L’energia geotèrmica es transferix des del nucli ardent cap a l’exterior fred del planeta en forma de calor, i pot causar desplaçaments de les roques del mantell, que tenen un comportament plàstic a causa de la pressió i de la temperatura que suporten. Aquests desplaçaments, coneguts amb el nom de convecció al mantell, són així:
- Masses de roques del mantell en contacte amb el nucli es calfen, per la qual cosa es fan menys denses i ascendixen cap a la superfície.
- Al mateix temps, masses fredes de litosfera poden introduir-se en el mantell en certes zones, fer-se més denses i afonar-se fins al límit amb el nucli.
Masses de roques calentes que ascendixen


1






litosfèrica 2
Masses fredes de litosfera que s’afonen



3
168
Placa litosfèrica
Placa
Placa litosfèrica
3.3 La litosfera i la seua dinàmica
Quan es va estudiar la distribució dels volcans i dels terratrémols en tot el món, es va descobrir que no és homogènia. Es va comprovar que la majoria d’aquests fenòmens es localitzen en regions concretes del globus, formant línies que coincidixen amb formacions com serralades, dorsals oceàniques i fosses marines.
En representar aquestes dades en mapes, semblava que la capa superficial de la Terra, la litosfera, es trobava fragmentada.
La litosfera, la capa més superficial del planeta, no és una capa contínua, sinó que es troba dividida en fragments que es denominen plaques litosfèriques o plaques tectòniques.
Prompte es va comprovar que aquestes plaques eren dinàmiques, és a dir, que havien canviat de grandària o de posició al llarg de la història de la Terra, a causa dels efectes de l’energia geotèrmica.
L’estudi de les plaques litosfèriques i de la seua dinàmica va donar origen a la principal teoria de la geologia, que explica la totalitat dels processos geològics: la teoria de la tectònica de plaques.
Les plaques tectòniques i els seus moviments principals






COMPRÉN, PENSA, INVESTIGA...
1 Explica les causes que fan que l’interior de la Terra estiga molt calent.
2 Explica com la transmissió de l’energia geotèrmica genera moviments en les roques del mantell.
3 Com es va arribar a la conclusió que la litosfera no era una capa contínua sinó que estava fragmentada en plaques?

4 anayaeducacion.es Consulta el recurs «Així han canviat les plaques litosfèriques» i formula una hipòtesi per a explicar per què creus que s’han produït aquests canvis en les plaques.







169 U 7
COMPRÉN, PENSA, INVESTIGA...
5 Escriu un text sobre els principis fonamentals de la tectònica de plaques, de manera que quede clar per què aquesta teoria explica tots els processos geològics.
6 Explica què és la zona de subducció i comenta en quin tipus de vores de plaques es pot donar.
3.4 La teoria de la tectònica de plaques
La teoria de la tectònica de plaques, o tectònica global, és la teoria fonamental de la geologia moderna. Permet explicar tots els processos geològics a partir de les propostes següents:
- Les plaques litosfèriques es mouen a causa de l’energia interna de la Terra. Es desplacen i canvien de posició, i poden canviar de grandària i de forma al llarg de milions d’anys.
- El moviment de les plaques fa que aquestes interactuen, especialment a les vores. Les forces i els canvis que resulten d’aquesta interacció entre vores de plaques produïxen una activitat geològica molt intensa que desencadena els processos geològics endògens i influïx de manera determinant en els exògens.
Estructura d’una vora divergent



Es formen magmes que ixen a l’exterior i se solidifiquen, de manera que originen litosfera nova.
Estructura d’una vora convergent




Estructura d’una vora transformant




La litosfera es fractura.
Litosfera oceànica


Litosfera continental



Si la placa que queda a la superfície és de litosfera continental, es plega i s’eleva, i forma una serralada paral·lela a la línia de costa, com la dels Andes.

Litosfera oceànica
La placa oceànica s’introduïx en el mantell (subducció) i aquesta litosfera es destruïx.
Litosfera continental
Es formen magmes, i el vulcanisme a la zona és intens. També l’activitat sísmica.







Les plaques es freguen en desplaçar-se en sentits oposats i originen terratrémols.




170 3 L’energia interna de la terra i els processos endògens
Dorsal
Placa 1
Placa 1
Placa 1
Placa 2
Placa 2
Placa 2
3.5 Tipus de vores de plaques
Segons com siga el contacte entre dues plaques litosfèriques, és a dir, segons com es mouen l’una respecte a l’altra, les seues vores poden ser divergents, convergents o transformants.
- Les vores divergents són límits entre dues plaques que se separen l’una de l’altra.
- Les vores convergents són límits entre dues plaques que s’aproximen l’una a l’altra.
- Les vores transformants són límits entre dues plaques que es mouen lateralment, una respecte a l’altra.
En separar-se dues plaques, la litosfera es fractura. Això disminuïx la pressió i es produïx la fusió de les roques del mantell, que formen magmes que ascendixen i se solidifiquen a la superfície i omplin les fractures. Així, s’origina litosfera oceànica nova, per la qual cosa aquests límits es denominen també vores constructives.
• Si la vora divergent s’obri en una placa de litosfera continental, la tensió fractura el continent i forma una depressió amb gran activitat volcànica al seu fons; és el cas de la vall del Rift, a Àfrica.
• Si les plaques que se separen són de litosfera oceànica, a la vora divergent s’origina una dorsal oceànica. És una gran serralada volcànica que s’alça al fons oceànic i que s’estén al llarg de la vora divergent; per exemple, la dorsal Centreatlàntica.
Generalment, una de les plaques que col·lidixen, formada per litosfera oceànica, més densa, s’introduïx davall de l’altra, de litosfera continental, cap al mantell en un procés anomenat subducció, i dona lloc a l’aparició de nombrosos volcans i terratrémols a la zona.
Si les dues plaques que convergixen són oceàniques, la més antiga i densa és la que s’introduïx davall de l’altra. A la zona de subducció també es formen magmes i volcans, i s’originen arcs d’illes volcàniques com el del Japó o el de les Aleutianes.
Com que en aquests límits de plaques la litosfera es reduïx, també s’anomenen vores destructives.
Aquestes vores es donen a les fractures transversals de les dorsals i en zones intracontinentals com la falla de San Andrés, a Califòrnia. S’hi produïxen tensions molt grans que originen terratrémols. També es denominen vores passives.
Volcans i terratrémols
Observa la imatge següent. Representa la superfície de la geosfera en una zona del planeta. S’hi han reproduït en roig els volcans actius i en groc, els focus dels terratrémols. Consulta el mapa de les plaques tectòniques i respon aquestes preguntes:
• A què creus que es deu aquesta distribució de volcans?
• Quina relació té amb l’orografia de la zona?
• Creus que aquestes circumstàncies influïxen en la forma de vida de la gent de la zona?
• Busca i anota altres zones del món en què hi haja una distribució semblant de terratrémols i de volcans.

171 U 7

El
magmatisme
i els volcans
Zones de la litosfera en què es formen magmes
A partir de la il·lustració inferior deduïx:
a) Per què les zones en què es formen magmes solen estar relacionades amb vores de plaques?
b) Localitza dues zones del planeta que tinguen una gran activitat magmàtica i explica les causes d’aquesta activitat.
c) Investiga i localitza al planeta un punt calent com el que es descriu en el dibuix.
1 Les vores convergents amb subducció
En aquestes vores, la placa que s’introduïx en el mantell es fon en part i provoca la fusió de més roques del mantell, i es generen bosses de magma.

Tal com s’explica en la teoria de la tectònica de plaques, les interaccions de les plaques litosfèriques desencadenen els processos geològics endògens. Entre aquests processos estan els del magmatisme.
El magmatisme és el conjunt dels processos geològics endògens en els quals intervenen magmes.
4.1 On es formen els magmes?
Els magmes es formen en zones de la litosfera o del mantell superior on la tectònica de plaques genera unes condicions que provoquen la fusió de les roques.
En totes aquestes regions, els magmes ascendixen a través de l’escorça terrestre i produïxen dos tipus de fenòmens magmàtics:
- La formació de les roques magmàtiques intrusives o plutòniques, com els granits o els gabres, per refredament lent i solidificació del magma en profunditat.
- L’activitat volcànica i la formació de roques magmàtiques extrusives o volcàniques, com el basalt, l’obsidiana o la pedra tosca, per l’eixida del magma a la superfície.
2 Les vores divergents
Tant a les dorsals com als rifts continentals, la fracturació de la litosfera fa disminuir la pressió sobre les roques calentes del mantell, la qual cosa provoca que es fonguen.



3 Els punts calents
Són zones que poden estar enmig de les plaques, lluny de les vores. Davall d’aquestes es produïx l’ascens de masses de roques molt calentes procedents del mantell profund que, quan arriben a la litosfera, es fonen.


172 4
4.2 L’activitat volcànica
Un volcà és un clevill o orifici de la litosfera per on ix a l’exterior el magma originat a l’interior terrestre.
Tots els volcans tenen unes característiques comunes i quatre parts principals (cambra magmàtica, xemeneia, cràter i edifici volcànic) que es descriuen en la il·lustració.




Les erupcions volcàniques
COMPRÉN, PENSA, INVESTIGA...

1 Busca informació i prepara una exposició oral per a explicar a classe:
a) Com es forma una massa de granit.
b) Com es produïx una erupció volcànica.




L’eixida de magma a través d’un volcà es denomina erupció. Les erupcions no es produïxen de forma contínua, sinó periòdicament, quan s’acumula molt de magma a la cambra magmàtica.
En aquestes condicions, els gasos del magma exercixen una gran pressió i s’obrin fissures o clevills entre la cambra magmàtica i l’exterior del volcà. Per aquests clevills ixen bruscament els gasos i espenten les roques foses de la cambra, de manera que ixen a l’exterior els diversos materials volcànics:
- Els gasos. Són, principalment, vapor d’aigua, diòxid de carboni i diòxid de sofre.
- La lava. És el magma desgasificat que fluïx vessant avall del con volcànic formant corrents anomenats colades. En solidificar, forma les roques volcàniques.
- Els sòlids (piroclastos). Són fragments de lava que ixen llançats a l’aire i solidifiquen abans de caure. Segons la seua dimensió, s’anomenen cendres (d’uns 2 mm de diàmetre), lapil·li (entre la grandària d’un pésol i la d’una nou) i bombes (més grans que una nou).
Segons on s’ubiquen a la superfície de la litosfera, els volcans poden tindre un aspecte i una activitat molt variables que depenen de la composició dels magmes que expulsen.
Xemeneia. És el conducte pel qual ix el magma des de la cambra magmàtica fins a l’exterior. Cràter. És l’orifici d’eixida de la lava a l’exterior. Si és de grans dimensions, es denomina caldera.
Edifici volcànic. És una estructura generalment de forma cònica i de les dimensions d’un tossal o d’una muntanya, que es forma per l’acumulació dels materials expulsats pel volcà.
Cambra magmàtica. És el lloc de l’interior de la litosfera en què s’emmagatzema el magma abans d’eixir a l’exterior.
Dos tipus de volcans
Volcà poc explosiu. Emet laves de composició basàltica, molt calentes i fluides, que tarden molt a solidificar, i per això ixen suaument junt amb gasos i molt pocs piroclastos.


Volcà molt explosiu. Emet laves de composició mixta, molt viscoses, que solidifiquen molt de pressa a la xemeneia i produïxen explosions que llancen bruscament lava i molts piroclastos.

173 U 7

Les forces tectòniques
Així es formen plecs i falles
Actuen forces que pleguen i trenquen les roques.






Així es produïxen els terratrémols
S’acumula tensió.





S’allibera la tensió i es produïx el terratrémol.
Un altre efecte de la dinàmica litosfèrica són les enormes forces tectòniques que actuen sobre les masses de roca i que causen en aquestes metamorfisme, deformacions o les sacsades dels terratrémols.
5.1 El metamorfisme
Quan un massís de roques se sotmet a les forces tectòniques i a la calor interna de la geosfera, experimenta augments de pressió i de temperatura que canvien els seus minerals sense variar el seu estat sòlid.
Anomenem metamorfisme el conjunt de processos geològics endògens que causen augments de pressió i de temperatura en zones de la litosfera i transformen les roques existents en altres de diferents anomenades roques metamòrfiques.
5.2 La deformació de les roques
Quan les forces tectòniques actuen sobre les masses de roca de forma intensa i duradora, poden produir en aquestes deformacions de tres tipus:
- Deformacions plàstiques. Són els plecs, que es mantenen en les masses de roques fins i tot quan cessa la força que els va causar.
- Fractures. Són ruptures de la massa de roca. Així s’originen les falles.
- Rebots elàstics. Són canvis de forma o desplaçaments en masses de roca, que recuperen bruscament el seu estat inicial en cessar les forces.
5.3 Els terratrémols
Els terratrémols o sismes són vibracions o oscil·lacions del terreny que es produïxen en trencar-se o en moure’s bruscament grans masses de roca sotmeses a forces tectòniques.
El desplaçament sobtat o fractura de grans masses de roques allibera energia que causa vibracions, les ones sísmiques, que es propaguen per la litosfera; són el terratrémol.
Quan les ones sísmiques arriben a la superfície de la litosfera fan que el terreny s’ondule, es trenque o s’altere. També originen onades enormes anomenades tsunamis si es produïxen al fons marí.
COMPRÉN, PENSA, INVESTIGA...
1 Busca informació sobre tres roques metamòrfiques i redacta una descripció breu de cada una. Indica la roca de la qual procedixen.
2 Quins tipus de deformacions de les roques causen terratrémols?
174
5
Falla Plecs

Els riscos geològics 6
Els riscos geològics
Localitat






Observa la imatge i avalua els riscos geològics que poden afectar la localitat que apareix en el dibuix.
6.1
El risc geològic
Els processos geològics endògens, en especial els que produïxen activitat volcànica i terratrémols, són fenòmens molt perillosos per a l’ésser humà a causa de la destrucció que poden causar. Per aquesta raó, es diu que constituïxen un risc geològic.
El risc geològic és la probabilitat que es produïsquen danys humans o materials en una zona a causa de l’acció de processos geològics.
El risc volcànic
Els volcans poden ocasionar destrucció de forma directa a causa de les explosions i de les emissions de materials durant les erupcions. A més, poden constituir perills indirectes, ja que provoquen terratrémols o tsunamis, a més d’allaus de fang si fonen la neu dels cims i l’aigua de fusió arrossega materials solts dels vessants.
El risc sísmic
Els terratrémols són destructius en el moment en què es produïxen pel fet que les vibracions de la superfície terrestre derroquen edificis i infraestructures i ocasionen moviments de terres. De forma indirecta, causen tsunamis i debiliten talussos que poden afonar-se després de forma inesperada.
6.2 Factors de risc
El risc volcànic o sísmic en una zona determinada pot ser major o menor depenent d’una sèrie de factors com:
COMPRÉN, PENSA, INVESTIGA...
1 Definix risc sísmic i risc volcànic.

2 anayaeducacion.es Consulta el recurs «Els mapes de risc» en el banc de recursos, interpreta el mapa del risc sísmic a Espanya i determina com és aquest risc a la teua localitat.
3 Explica com es pot reduir el risc sísmic en una ciutat situada en una zona amb terratrémols freqüents.
4 Posa exemples per a explicar com influïx el grau de perill dels volcans en el risc volcànic.
- El grau de perill del fenomen. Depén de la freqüència i de la violència de les erupcions volcàniques o dels terratrémols.
- La quantitat de població exposada al perill. Com més població hi haja en una zona volcànica o sísmica, més gran serà el risc.
- La capacitat per a la predicció i la prevenció. Les poblacions amb mitjans tècnics i econòmics desenvolupen programes de vigilància sísmica i volcànica i mesures per a minimitzar els efectes d’aquests successos (plans d’evacuació, construcció de refugis, dics per a desviar lava, construcció d’edificis sismoresistents...). En aquestes zones, el risc és menor que en aquelles en què no es disposa d’aquests mitjans.
175 U 7











COMPRÉN



Organitza les idees

1 Mapa mental. Completa en el quadern els espais buits del mapa mental següent sobre els volcans. Aprén a fer-los amb el recurs disponible en anayaeducacion.es ? Materials volcànics Tipus de volcans
Parts d’un P volcà Erupcions volcàniques periòdiques S’acumulen ? a la ?

Volcans poc ? Volcans molt ? ? ? ? ? ? ? ? ?
Fes un resum
Els gasos exercixen ?
2 Elabora el teu resum de la unitat seguint aquest guió:
• Diferencia els tipus de processos geològics i digues quins són els efectes de cada tipus.
• Explica què és el temps geològic i com es relaciona amb el registre estratigràfic.
• Anomena els tipus de roques segons l’origen i explica’n el cicle de formació a la geosfera.
• Explica la relació que hi ha entre l’energia interna de la Terra, la convecció al mantell i la dinàmica litosfèrica.
• Enuncia la teoria de la tectònica de plaques.
• Anomena els diferents tipus de límits de plaques tectòniques i explica les diferències entre aquestes.
• Definix magmatisme i explica quina relació té les vores de les plaques tectòniques.
• Descriu les diverses conseqüències que té amb l’acció de les forces tectòniques sobre les masses de roca de la litosfera.
• Explica què és el risc geològic a causa dels processos geològics endògens i cita els factors de què depén.






Interpreta imatges








3 Identifica el tipus de vores de plaques litosfèriques que es corresponen amb cada un dels dibuixos.






4 Quins tipus de roques creus que es poden formar a les zones de la litosfera assenyalades en el dibuix?


5 La imatge correspon a una formació de roques que ha patit l’acció dels processos geològics endògens. Explica quins han sigut aquests processos i quins els efectes sobre aquestes roques.




A B
A B C D

Recorda seleccionar el material de treball d’aquesta unitat per al dossier d’aprenentatge.

Aplica
6 Explica en el quadern per què són falses les frases següents.
a) L’energia solar és responsable de la fragmentació dels continents.
b) Els volcans i els terratrémols no se solen produir a les mateixes zones.
c) L’energia geotèrmica procedix del Sol.
d) La litosfera és una capa contínua i plàstica.
7 Classifica en una taula els diferents productes que expulsa un volcà i indica les característiques que presenten.
8 Escriu frases correctes amb els grups de paraules següents:
a) Exògens, relleu, gliptogènesi i modelat.
b) Relleu, forces, magmatisme, orogènesi.
c) Convergents, subducció, volcans, sismes.
9 Establix les diferències entre:
a) Orogènesi i gliptogènesi.
b) Roques sedimentàries i roques metamòrfiques.
c) Roques plutòniques i roques volcàniques.
d) Plecs i falles.
e) Risc volcànic i risc sísmic.
10 Explica com pot una població minimitzar els riscos sísmics i els riscos volcànics.
REFLEXIONA
11 Deduïx per què en zones de risc volcànic es construïxen habitatges amb teulades molt inclinades o semiesfèriques en comptes de planes.
Avança
12 Un exemple de punt calent a l’interior d’una placa tectònica és el que se situa davall de l’arxipèlag hawaià, responsable de l’activitat volcànica actual a l’illa de Hawaii. Com que la placa tectònica es mou sobre el punt calent, les illes es troben alineades, ja que s’han format en successives etapes eruptives del punt calent sobre la placa tectònica.



a) Investiga sobre l’edat de cada una de les illes de l’arxipèlag de Hawaii.
b) Hi ha alguna relació entre l’edat de les illes i la seua disposició? Per què?
c) A partir d’aquesta informació, deduïx en quina direcció es mou la placa tectònica.
En aquesta primera unitat hem investigat el que ha passat a La Palma per a comprendre com funciona la Terra per dins. Analitzant el que ha passat, hem sigut conscients dels processos d’orogènesi, del vulcanisme i dels terratrémols. Reflexiona sobre el teu aprenentatge omplint el qüestionari i la rúbrica, disponibles en anayaeducacion.es
Aspectes Totalment aconseguit
d’on
Bastant aconseguit
POSA A PROVA LES TEUES COMPETÈNCIES
AconseguitQuasi aconseguit
Fes l’autoavaluació competencial inclosa en anayaeducacion.es
U 7
Entenc
prové la lava que ha eixit del volcà de Cumbre Vieja i que ha arrasat una bona part de l’illa de La Palma.











El modelat del relleu
MARJORIE SWEETING.
La gran exploradora del carst 8
Sovint el meu alumnat de la universitat em pregunta com és que no em fa por endinsar-me en les entranyes de la pedra. A les coves, la foscor t’engul, el silenci és esglaiador, la humitat s’apega a la roba i el pendent és traïdorenc per les roques soltes... Tot això és cert, però ho considere un preu xicotet a canvi de poder admirar de primera mà les meravelles del modelat càrstic.
Em dic Marjorie Sweeting. Vaig nàixer a Fulham, Anglaterra, en 1920. Mon pare era professor de Geologia a l’Imperial College de Londres, per la qual cosa des de xiqueta vaig agafar el gust a aquesta ciència i vaig acabar per llicenciar-me en Geografia Física al Newham College de Cambridge, en 1941. A partir d’aquell moment vaig poder dedicar-me a les meues dues activitats preferides: la investigació i l’ensenyament. Durant les dècades següents vaig compaginar fer classes a la Universitat d’Òxford i al St Hugh’s College amb expedicions per a estudiar les zones càrstiques més impressionants del planeta.
La meua passió per la investigació i per les coves era tan gran que, en una ocasió, vaig convéncer un com-
pany acabat d’operar d’apendicitis que la millor forma de curar-se era vindre amb mi a fer espeleologia. No hi ha res millor que la combinació d’aire fresc, calcàries i un poc d’investigació per a recuperar-se de qualsevol mal. Quan el diòxid de carboni atmosfèric reacciona amb l’aigua de pluja, es forma una quantitat xicoteta d’àcid carbònic. Aquest compost químic té la capacitat de dissoldre les roques calcàries i, al llarg de milers d’anys, excavar-hi autèntiques catedrals d’estalactites, estalagmites, avencs i galeries d’una bellesa que lleva l’alé. Els geòlegs anomenem carst aquest tipus de paisatge. Em cridaven tant l’atenció que vaig arribar a convertir-me en la primera científica occidental a investigar la gran zona càrstica de Guilin, al sud de la Xina.
Fins als meus últims dies vaig organitzar excursions amb el meu alumnat per a visitar algunes de les meues coves preferides. Al cap i a la fi, no podia permetre que es perderen aquestes meravelles només per por a la foscor!
178

Què descobriràs?
En aquesta unitat
• Marjorie Sweeting. La gran exploradora del carst
1. El modelat del relleu
2. Els processos geològics exògens
3. El modelat de les aigües de torrentera
4. El modelat dels rius
5. El modelat de les aigües subterrànies
6. El modelat glacial
7. El modelat del vent
8. El modelat de la mar
9. Els éssers vius modelen el relleu
10. El sòl
• Comprén, reflexiona i posa a prova les teues competències
En anayaeducacion.es
Per a motivar
• Vídeo: Abans de començar
• Coneix més.. Marjorie Sweeting
Per a detectar idees prèvies
• Presentació: Què necessites saber
Per a exposar
• Presentació: El modelat i el clima; Éssers vius i meteorització
• Vídeos: L’aigua com a agent geològic
Per a exercitar
• Activitats interactives: Aprén jugant; Posa’t a prova
• Taller de ciències: Fabriquem estalactites i estalagmites amb sal
I, a més, tota la documentació necessària
per a aplicar les claus del projecte.






























SEQÜÈNCIA D’APRENENTATGE

















+ anayaeducacion.es


4.1 4.2 5.1 5.2 5.3 6.1 6.2 6.3
1

El modelat del relleu
Els agents geològics externs
La hidratació i la deshidratació degudes al vapor d’aigua provoquen reaccions successives que afavorixen la fragmentació de les roques.

Deshidratació

1.1 Els agents geològics exògens
Els agents geològics exògens són els que produïxen canvis en els materials de la superfície terrestre i donen lloc a determinades formes del relleu. Són l’aigua, el vent, els canvis de temperatura, alguns gasos atmosfèrics i els éssers vius.
L’aigua
L’aigua líquida afavorix la dissolució de minerals i la precipitació posterior.

Hidratació

Fragmentació
El vent
En el procés d’abrasió, el vent arrossega partícules que, com si foren paper d’escatar, desgasten les roques.

Els gasos atmosfèrics
Alguns gasos atmosfèrics alteren la composició de les roques, en reaccionar amb els seus minerals.

El CO2 junt amb l’aigua forma àcid carbònic que pot dissoldre les calcàries.

En el procés de gelifracció, el gel fragmenta les roques, i les glaceres les fragmenten i les trituren.


Els canvis de temperatura
Els canvis de temperatura fragmenten les roques en dilatar-les i contraure-les.


Els éssers vius
Els éssers vius poden fragmentar les roques mecànicament i alterar-les químicament.


180
CO2
Calcària
1.2 Factors que influïxen en el modelat
Els factors que influïxen en el modelat del relleu són el clima, la presència de vegetació, el tipus i la disposició de les roques; altres factors, com la presència de la mar o l’acció de l’ésser humà, també hi contribuïxen.
- El clima de la regió fa que predomine un agent exogen o un altre. Per exemple, a les zones glacials predominen l’acció de les glaceres i el gel; a les desèrtiques, el vent i els canvis de temperatura; a les temperades, l’aigua, i a les tropicals, els gasos i els éssers vius.
- La vegetació protegix la superfície de l’alteració causada per agents com l’aigua o el vent, ja que les arrels de les plantes subjecten el sòl i afavorixen la infiltració de l’aigua, amb la qual cosa disminuïx l’escolament.
- L’acció dels agents geològics depén de les característiques de cada roca, determinades, fonamentalment, per la textura i la composició química. Per exemple:
• Les argiles són roques impermeables, que afavorixen l’escolament superficial. Produïxen relleus suaus en els climes temperats, pel fet d’estar protegides per la vegetació, però s’alteren amb facilitat en els climes àrids.
• Els granits són roques molt resistents. No obstant això, presenten clevills pels quals s’infiltra l’aigua, la qual cosa afavorix que es fragmenten en blocs que donen lloc a un paisatge típic, denominat roquissar.
- La disposició de les roques en l’espai és un factor que influïx quan aquestes presenten diferents graus de resistència a l’erosió; per exemple, si hi alternen estrats horitzontals de roques dures amb estrats de roques blanes, els rius s’encaixen en un relleu en grades, en el qual els estrats durs produïxen parets verticals i els blans, parets de pendents suaus. Els plegaments, les falles i les fractures condicionen també l’erosió, que sempre actua buscant els punts més dèbils del relleu.
- La presència de la mar determina els relleus costaners, ja que el principal agent modelador és l’aigua marina.
- L’acció humana en la construcció de pantans, pedreres, etc. pot canviar la forma en què actuen els agents geològics exògens sobre els terrenys.
COMPRÉN, PENSA, INVESTIGA...
1 Enumera els agents geològics exògens.
2 Explica com influïxen els canvis de temperatura i els gasos atmosfèrics en les formes del relleu.
3 Definix roquissar, gelifracció i abrasió
4 Observa la fotografia de la dreta i anomena tres factors que hagen influït en el seu modelat. Justifica la espos resposta.






El tipus de roca condiciona les formes del relleu. Les roques com l’argila o el guix s’alteren amb facilitat en climes àrids, la qual cosa origina paisatges com els de la imatge A. Els granits, en canvi, originen el paisatge que es mostra en la fotografia B.


181 U 8
A B

Els processos geològics exògens




Quan l’aigua que es troba entre els clevills de les roques es congela, trenca les roques.



Els àcids produïts pels líquens alteren químicament les roques.
L’acció dels agents geològics exògens modela el relleu de la superfície terrestre a través de quatre processos: la meteorització, l’erosió, el transport i la sedimentació.
2.1 La meteorizació
La meteorització consistix en una sèrie de processos que alteren i disgreguen les roques de l’escorça. Hi ha dos tipus de meteorització: la meteorització física o mecànica i la meteorització química.
La meteorització física o mecànica
La meteorització física és la fragmentació de les roques sense que es produïsquen canvis en la seua composició. Els processos més importants de meteorització física són la gelifracció, l’abrasió eòlica, els cicles de dilatació i contracció de les roques i l’acció de les arrels de les plantes.
La meteorització química
La meteorització química és la descomposició de les roques com a resultat de reaccions químiques que alteren els minerals que les formen; és a dir, en canvien la composició química. Les reaccions de meteorització més importants són:
- La dissolució d’alguns components de les roques, sobretot de les sals.
- La hidratació de minerals, que reaccionen amb el vapor d’aigua atmosfèric.
- L’oxidació de minerals metàl·lics, que reaccionen amb l’oxigen atmosfèric.
- La carbonatació de minerals, que reaccionen amb el diòxid de carboni dissolt en l’aigua.
- L’ atac químic dels àcids, procedents de l’activitat dels éssers vius.
2.2 L’erosió
L’erosió és el desgast de les roques, a causa de l’arrossegament dels materials resultants de la meteorització. Aquests poden ser retirats de la roca per l’acció del mateix agent geològic que ha produït la meteorització, o bé per altres agents geològics com l’aigua o el vent.
COMPRÉN, PENSA, INVESTIGA...
1 Explica en què es diferencien la meteorització física i la química.
2 Raona per què l’erosió i la meteorització es consideren processos distints si ambdós degraden les roques.
2.3 El transport
El transport és el desplaçament dels materials erosionats d’un lloc a un altre. Durant el transport, els materials continuen patint processos erosius, que en canvien la forma. Generalment, els materials que han patit processos de transport curts presenten formes anguloses. Si, per contra, el procés de transport ha sigut intens, presenten formes més suaus i arredonides.
182
2
2.4 La sedimentació
La sedimentació és el depòsit i l’acumulació dels materials erosionats i transportats, denominats sediments. Es produïx en zones en què l’agent geològic ha perdut gran part de la seua energia i, per tant, ha disminuït la seua capacitat erosiva i de transport. Els materials es depositen segons la grandària, de manera que se sedimenten abans els més grans i, en últim lloc, els materials més fins.
El procés de sedimentació és més intens a les conques de sedimentació, zones de menor altitud de l’escorça terrestre, on els sediments s’acumulen durant milions d’anys, i donen lloc a la formació de roques sedimentàries.


Els agents geològics
Observa la imatge i indica en quina etapa tenen lloc cada un dels processos geològics exògens. Què creus que passarà amb la cascada a partir del quart pas?



L’aigua i les partícules de roca que aquesta arrossega erosionen les roques de la part inferior de la cascada i creen una zona més profunda anomenada piscina d’immersió.



A poc a poc augmenta la profunditat de la piscina d’immersió i es destruïx la paret de roca darrere de la cascada.



La roca més dura de la part superior es trenca i ompli la piscina d’immersió.
COMPRÉN, PENSA, INVESTIGA...
3 Explica què és la sedimentació.
4 Quina forma tindrà un fragment de roca que haja sigut transportat al llarg de molts quilòmetres en un riu?



El procés erosiu continua tant a la zona superior com a la inferior, on les roques es van arredonint.

5 Sac de dubtes. La geologia pot ser difícil de comprendre pel fet que els seus efectes es produïxen al llarg de milers d’anys. Utilitzeu aquesta tècnica de pensament per a resoldre en grup els dubtes que tingueu sobre els prsos geològics eògens.
183 U 8
Roca dura
Roca blana
A
C B D

El modelat de les aigües de torrentera
Identifica formes del relleu











Observa les imatges superiors i digues amb quina forma del relleu de les aigües de torrentera s’identifica cada una. Escriu el nom d’algun lloc que conegues en el qual pugues trobar alguna d’aquestes formacions.
3.1 Les aigües de
torrentera
Les aigües de torrentera o aigües salvatges són les aigües que circulen per la superfície terrestre sense un llit fix.
L’aigua de la pluja o del desgel que no s’infiltra en el subsòl circula per la superfície, i forma les aigües d’escolament.
Algunes d’aquestes aigües superficials discorren per un llit i van a parar als rius, als torrents i a les rambles. Però una altra part d’aquestes aigües d’escolament circula pels vessants, i formen les anomenades aigües de torrentera o aigües salvatges.
Les aigües de torrentera formen regueres xicotetes que s’unixen entre si, la qual cosa fa que el cabal i la velocitat amb què discorren pels vessants augmenten; això els conferix un gran poder erosiu.
Formes del relleu de les aigües de torrentera
Les principals formes del relleu que originen les aigües salvatges són:
- Els solcs són fenedures xicotetes que es formen quan l’aigua arrossega els materials. En terrenys de roques dures i solubles, com les calcàries, es formen superfícies extenses plenes de solcs de poca profunditat, denominats rasclers o lapiaz.
- Els regalls es formen quan els solcs són molt profunds. Si el sòl està desproveït de vegetació, s’hi formen grans extensions de solcs i regalls denominats badlands.
- Les xemeneies de fades són formacions còniques característiques de terrenys en què alternen roques dures i materials més blans. Les roques més resistents protegixen de l’erosió els materials més blans que es troben a les capes inferiors, de manera que es produïx una erosió diferencial.
COMPRÉN, PENSA, INVESTIGA...
1 Definix escolament i olament aigües de torrentera.

2 Interpretem. Consulta la documentació sobre aquesta tècnica en anayaeducacion.es i explica per què creus que les xemeneies de fades reben aquest nom.
184
A C B
3
3.2 Els torrents
Els torrents són cursos d’aigua de recorregut curt i de cabal irregular, situats en zones d’alta muntanya o amb pendents elevats.
Els torrents conduïxen l’aigua del desgel o de pluges intenses, per la qual cosa els seus llits estan secs la major part de l’any. A causa dels pendents elevats, les aigües torrencials descendixen a molta velocitat, i per això presenten un gran poder erosiu.
Estructura d’un torrent
En un torrent es diferencien tres parts:
- La conca de recepció està situada a la part més elevada del terreny. És la zona en què les aigües salvatges es canalitzen, i així alimenten el curs d’aigua. S’hi produïx una erosió intensa deguda a la inclinació del pendent.
- El canal de desaigüe és la zona intermèdia i el llit principal del torrent. Per aquest descendix l’aigua a gran velocitat, transportant els materials arrossegats. L’erosió ací també és molt intensa, la qual cosa afavorix la formació d’un llit profund de parets escarpades.
- El con de dejecció està situat a la zona de menys pendent del vessant. En aquesta zona, l’aigua perd velocitat, per la qual cosa disminuïx l’erosió i es depositen els sediments transportats pel torrent. Aquests materials solen presentar formes anguloses, perquè ací el transport és escàs.
COMPRÉN, PENSA, INVESTIGA...
3 Descriu què passa en un torrent durant una època amb pluges intenses i què passa en una època de sequera.
4 Enumera les parts d’un torrent i especifica a quines parts domina l’erosió i a quines parts ho fa la sedimentació.

5 És possible que hages sentit expressions com un «torrent d’idees» o «un torrent d’indignació». Explica quina relació creus que tenen aquestes expressions amb les característiques d’un torrent en geologia i, després, escriu una notícia en què n’utilitzes alguna.
Les formes del relleu de les aigües de torrentera i els torrents
Badlands






Canal de desaigüe
Con de dejecció Conca de recepció




Els cursos d’aigua dels torrents són curts i irregulars. emeneies de fades
185 U 8

El modelat dels rius 4

Vall en V: es forma per la intensa erosió que l’aigua exercix sobre el llit del riu.

Els rius són cursos d’aigua de llarg recorregut i de cabal estable, que discorren des de les zones més elevades fins a les zones més baixes del relleu.
Els rius, que reben l’aigua de la pluja i del desgel, són llits permanents pels quals circula l’aigua de manera contínua, encara que presenten variacions en el cabal al llarg de l’any.
Tot i que que els rius presenten pendents menys pronunciats que els torrents, tenen un paper erosiu molt important, que, juntament amb els processos de transport i de sedimentació, modelen el relleu i formen valls fluvials.
El curs d’un riu es dividix en tres trams: el curs alt, el curs mitjà i el curs baix. En cada un d’aquests trams, el relleu adquirix un modelat característic i diferencial que depén dels processos de modelat del relleu que predominen en cada cas.







Gorges i congosts: són propis de terrenys formats per roques dures. El riu excava un llit estret i profund de parets quasi verticals.


Cascades: es formen quan l’aigua troba desnivells bruscos al terreny. Amb el pas del temps se suavitzen i es poden formar ràpids.







186
4.1 El relleu al curs alt
En aquest tram del riu és on el pendent és més gran. Per aquesta raó, l’aigua hi circula a gran velocitat, i per això els processos predominants són l’erosió i el transport.
Les formes de relleu típiques d’aquest tram són les valls en V, les gorges i congosts i les cascades.
4.2 Relleu dels cursos mitjà i baix
Als cursos mitjà i baix del riu disminuïx el pendent. L’aigua perd velocitat i en disminuïx el poder erosiu, per la qual cosa en aquests trams els processos que predominen són el transport i la sedimentació.
Al curs baix del riu arriben gran quantitat de materials que procedixen dels cursos alt i mitjà. Aquests materials comencen a sedimentar, especialment els més gruixuts. A mesura que el riu s’acosta al tram final, la sedimentació és cada vegada més gran.
Les formes característiques d’aquests trams del riu són les valls d’obi o coms, els meandres, les terrasses fluvials, els deltes i els estuaris.
Vall d’obi: el llit del riu s’eixampla i s’aplana, i forma una vall més ampla. Quan hi ha grans crescudes, es depositen sediments abundants al fons de la vall i formen planes d’inundació o vegues.
Meandres: a les planes d’inundació, el riu descriu revoltes, denominades meandres. S’originen a causa d’una erosió diferencial a un costat i a l’altre del llit.




El modelat fluvial
Observa la il·lustració i respon les qüestions següents:
• Determina si l’origen dels dos llacs que es poden veure en el curs alt del riu és natural o artificial.
• Explica quins processos geològics predominen en cada tram del riu.
• Elabora una fitxa amb la descripció de quatre formes del relleu típiques dels rius. Busca una fotografia de cada una d’aquestes formes per a acompanyar la descripció.
Terrasses fluvials: són antigues planes d’inundació situades a distintes altures a ambdós marges del llit.


Deltes i estuaris: a la zona baixa predomina la sedimentació de materials. Als deltes, els sediments aportats pel riu guanyen terreny a la mar. Als estuaris, el poder erosiu de la mar provoca que aquesta avance cap a l’interior del curs fluvial.





187 U 8

El modelat de les aigües subterrànies
Així és un aqüífer
Zona d’infiltració


Nivell freàtic principal
Les aigües subterrànies procedixen de la infiltració de les aigües superficials a través de les roques permeables.
La infiltració de les aigües superficials augmenta a les zones de pluges abundants, de terrenys permeables i en aquelles en què hi ha vegetació (les arrels de les plantes retenen l’aigua). Al contrari, la infiltració disminuïx en zones on hi ha molta evaporació o en aquelles en què el terreny té molt de pendent, ja que l’aigua hi circula molt de pressa i no té temps per a infiltrar-se.
5.1 Què són els aqüífers
Els aqüífers són acumulacions d’aigua subterrània, situades davall de la superfície terrestre.
Els aqüífers es formen quan les aigües d’infiltració circulen a través dels porus i de les fissures de les roques permeables, fins a trobar una capa de roca impermeable que els impedix continuar. Aleshores l’aigua s’acumula, de manera que ocupa tots els porus de la roca fins a un nivell determinat, denominat nivell freàtic.
El nivell freàtic varia al llarg de l’any; és més profund en l’estació seca, i més superficial en les estacions plujoses. Les aigües d’un aqüífer poden eixir lliurement per fonts o brolladors, quan el relleu talla el nivell freàtic, o artificialment per mitjà de pous, que són perforacions que arriben a l’aqüífer.
Brollador

Nivell freàtic en època de pluges

Zona d’infiltració



188
5
Pou sec
Pou
5.2 El modelat càrstic
El modelat càrstic és conseqüència de l’acció química i mecànica de les aigües subterrànies sobre terrenys calcaris.
La calcària és una roca formada per carbonat de calci, la qual cosa la fa insoluble en aigua. Sol aparéixer formant masses grans plegades i amb fissures, i això afavorix que l’aigua de pluja s’hi infiltre.
L’aigua de pluja sol portar dissolt diòxid de carboni atmosfèric que reacciona amb el carbonat de calci de la calcària i el transforma en bicarbonat de calci, que sí que és soluble.
Així, l’aigua dissol a poc a poc els massissos de roca calcària, engrandix els clevills i els porus, i dona lloc a paisatges característics, tant a la superfície, formes exocàrstiques, com davall d’aquesta, formes endocàrstiques.
Les formes exocàrstiques
Es produïxen a les roques de la superfície i són molt variades.
- Els rasclers o lapiaz, formats en discórrer l’aigua sobre la roca.
- Els engolidors són pous estrets i verticals pels quals s’infiltra l’aigua.
- Les dolines són depressions en forma d’embut, formades en acumular-se l’aigua. La unió de diverses dolines forma grans depressions, denominades pòlies.
Les formes endocàrstiques
Es produïxen a l’interior del massís rocós. Algunes s’originen en eixamplar-se les fissures, com les galeries o conductes horitzontals; els avencs o conductes verticals; i les coves, que són grans cavitats formades per la unió de galeries i avencs.
El modelat càrstic
Les coves són llocs molt interessants i perillosos. La ciència que les estudia s’anomena espeleologia i, encara que no sols s’estudien les coves càrstiques, aquestes són de les més abundants. Busca una formació de coves càrstiques pròxima al lloc on vius i recopila’n informació per a elaborar una presentació o un cartell. Aquests són alguns dels apartats que ha de tindre l’estudi:
• Nom de la formació.
• Profunditat i extensió de la cova.
• Fotografies o il·lustracions de la cova i de formes endocàrstiques o exocàrstiques associades.
• Històries o llegendes associades a la cova. Si no n’hi ha, inventa’n una.









189 U 8
Riu subterrani
Engolidor
Dolina Pòlie
Lapiaz
Cova
Estalactita
Estalagmita
Columna
Galeria Sima

El modelat glacial



Glacera d’alta muntanya.




Les glaceres són masses de gel enormes que es desplacen lentament cap a zones més baixes, la qual cosa genera una gran transformació del relleu.
6.1 Els tipus de glaceres
Hi ha dos tipus de glaceres segons la latitud i l’altitud a què es troben: les glaceres de muntanya i les glaceres de casquet.
Les glaceres de muntanya
Es troben en zones d’alta muntanya, i s’hi distingixen tres parts: el circ, la vall glacial i la zona terminal.
- El circ és la zona més elevada on la neu s’acumula i es transforma en gel.
- La vall glacial és el llit pel qual descendix la massa de gel o llengua.
- La zona terminal és la zona de menor altitud on es produïx la fusió del gel.
Les glaceres de casquet
Aquestes glaceres es troben als pols, i són grans masses de gel amb llengües que acaben en la mar, i que, en trencar-se, donen lloc a icebergs.
6.2 El modelat glacial
Els moviments de les masses de gel, a més de produir abrasió, arrosseguen fragments de roca. Durant aquest procés, les masses de gel excaven el fons i les parets de la vall glacial.
Les masses de gel, a mesura que avancen per la vall glacial, transporten fragments de roca que queden inclosos en el gel. Quan aquest gel es fon, tots els materials transportats sedimenten i s’acumulen en depòsits, anomenats morrenes.
Les morrenes
Segons on se situen, les morrenes poden ser:
COMPRÉN, PENSA, INVESTIGA...
1 Enumera les parts d’una glacera de muntanya.

2 Durant l’última glaciació es van formar nombroses glaceres de muntanya a la península Ibèrica. Busca el nom de tres d’aquestes glaceres.
- Laterals, situades al costat de les parets de la vall.
- Centrals, que es troben entre dues llengües.
- De fons, que es troben al fons de la glacera.
- Terminals, que estan situades a la part frontal de la glacera, on el gel es fon.
190
6
Iceberg.
6.3 El relleu glacial
El relleu originat per l’acció d’una glacera es fa visible quan canvia el clima i el gel ha desaparegut de la zona.
- A les zones de circ, on es va acumular el gel, queden pics molt esmolats, anomenats agulles glacials. Les depressions poden omplir-se d’aigua, i donen lloc a llacs de circ.
- A les zones per les quals van discórrer les llengües de gel es formen valls glacials molt àmplies amb forma de U, on les roques del fons i les de les parets presenten estries o arraps, provocats pels materials que transporta la massa de gel. Aquestes roques es denominen roques amoltonades.
- A les zones terminals, on el gel es fon, els materials transportats, anomenats til, s’acumulen a les morrenes, i amb el temps es poden transformar en roques sedimentàries anomenades til·lites.
El modelat glaciar
Aspecte de les glaceres de muntanya en un terreny fa uns 30 000 anys
Circ
Llengua
Morrenes laterals
COMPRÉN, PENSA, INVESTIGA...
3 Anomena la zona d’una glacera de muntanya on podem trobar una vall en U quan el gel es retira.
4 En molts llocs, quan s’ha retirat el gel, queden llacs a les zones on es trobava el circ d’una glacera. Com creus que es formen?




Morrena terminal





de fons
Aspecte del terreny en l’actualitat, una vegada que s’han retirat les glaceres











191 U 8
Circ
Morrena
Morrena central
Til·lites
Til·lites
Vall en U
Llacs de circ
Vall en U
Llengua

El modelat del vent
Així transporta el vent
Pedres (reptació)
Grandària > 0,5 mm
Arena (saltació)
Grandària 0,02-0,06 mm
Fragments molt fins en suspensió.
Grandària de les partícules
< 0,02 mm

El vent, gràcies a l’energia cinètica, és un agent geològic important que modela i erosiona, transporta i sedimenta materials.
L’acció geològica del vent, o acció eòlica, depén de tres factors:
- L’existència en el terreny de materials solts, que el vent pot alçar.
- La velocitat del vent, que haurà de ser alta per a alçar i desplaçar els materials solts.
- L’existència de coberta vegetal, que disminuïx o anul·la l’acció del vent en subjectar el sòl.
Per això, els processos eòlics predominen en zones àrides, com els deserts.
7.1 Els processos eòlics
- La meteorització i l’erosió produïda pel vent es denomina abrasió eòlica, i és el procés de desgast que experimenten les roques per l’impacte de les partícules que transporta el vent.
- El transport eòlic es denomina deflació i es produïx de forma selectiva, ja que només les partícules més lleugeres poden ser arrossegades pel vent. Es pot realitzar per:
• Reptació, si les partícules són arrossegades per terra.
• Saltació, si les partícules s’eleven i cauen a intervals curts.
• Suspensió, quan les partícules són tan fines que poden mantindre’s en l’aire durant molt de temps.
- La sedimentació dels materials es produïx quan el vent perd força. Té lloc de forma selectiva, de manera que es depositen primer els materials més gruixuts i després, els més fins.








192
7
7.2 Formes d’erosió eòlica
Les principals formes d’erosió eòlica són:
- Les roques fungiformes, amb aspecte de bolet, més erosionades a la part inferior, a causa del transport d’una quantitat de partícules més gran.
- Els alvèols, que són buits xicotets a les roques ocasionats per l’abrasió.
- Les muntanyes illa, formacions rocoses més resistents a l’abrasió que la resta de materials de l’entorn.
- Els camps empedrats, deguts al transport i al depòsit selectiu de les partícules més fines.
7.3 Formes de sedimentació eòlica
La sedimentació eòlica dona lloc a formacions característiques com:
- Les dunes, que són monticles d’arena depositada pel vent, quan troba un obstacle que n’impedix el transport. Poden ser mòbils o fixes, segons que l’arena sobrepasse o no l’obstacle. Les més comunes, denominades barcanes, tenen forma de mitja lluna.
- Els depòsits de loess, que són acumulacions de partícules molt fines de llim i d’argila, que han sigut transportades a grans distàncies i que, en depositar-se, donen lloc a sòls fèrtils.



COMPRÉN, PENSA, INVESTIGA...
1 Enumera els factors que condicionen l’acció geològica del vent.
2 Explica què són l’abrasió eòlica i la deflació.
3 Raona i explica amb les teues paraules per què les roques fungiformes tenen la base més degradada que la part superior.

4 Busca el nom i una foto de cinc zones de dunes eòliques que hi haja a Europa.
Formes de modelat eòlic












Desert de roques

Roques fungiformes
193 U 8
Roca fungiforme
Loess

El modelat de la mar
L’aigua de la mar realitza una activitat constant de modelat sobre el litoral a causa de l’energia cinètica dels seus moviments.
8.1 Els moviments marins
Els moviments de l’aigua de la mar són les ones, els corrents i les marees.
Les ones
Són moviments ondulatoris que origina el vent sobre la superfície marina. Les ones realitzen fonamentalment una acció erosiva, que es veu augmentada pels fragments de roca que l’aigua arranca i torna a llançar contra la costa. Aquest procés es denomina abrasió marina.
Els corrents
Són moviments deguts al vent i a les diferències de salinitat i de temperatura. Els corrents litorals, generalment paral·lels a la costa, transporten i sedimenten materials.
Les marees
Són moviments periòdics d’elevació i descens causats per l’atracció solar i lunar. Les marees transporten i sedimenten materials; a més, amplien la superfície de costa que pot arribar a modelar la mar.


















194
8
El modelat de la mar
Barra Fletxa
Illot
Tómbol
Platja
Badia
8.2 Formes d’erosió marina
Les principals formes d’erosió marina són:
- Els penya-segats. Són talls verticals del terreny que es generen a causa de l’erosió marina de les costes rocoses i elevades. L’erosió marina produïx el soscavament de la base de les roques i la formació d’una volada que acaba per desplomar-se. L’acumulació de fragments que es genera al peu del penya-segat es denomina plataforma d’abrasió.
- Els arcs, coves i illots també es produïxen en aquest tipus de costa a causa de l’abrasió marina.
- Els promontoris i els caps. Són ixents del litoral que es formen on les roques són més resistents. Les cales i les badies són entrants del litoral que es formen on les roques són més blanes.
8.3 Formes de sedimentació marina
Les principals formes de sedimentació marina són:
- Les platges, que són acumulacions d’arenes o de graves que es formen en costes baixes i planes.
- Els tómbols, que són illes xicotetes unides a la costa per depòsits d’arena o de grava.
- Les barres i fletxes, que són acumulacions rectilínies d’arena que depositen els corrents. Es denominen barres si són paral·leles a la costa i restingues si tanquen una badia. Les fletxes es formen perpendicularment a la costa a partir d’un ixent.
- Les albuferes i marenys; quan una badia es tanca totalment o parcialment per una restinga, es forma una albufera. Si aquest procés l’experimenta l’estuari d’un riu, es denomina mareny o maresme, en el qual abunden els sediments fluvials.
Algunes formes del modelat costaner











COMPRÉN, PENSA, INVESTIGA...
1 Explica les diferències que hi ha entre les ones, els corrents i les marees.
2 Definix mareny, platja i tómbol

3 1-2-4. En alguns llocs, com a Lanzarote o a Islàndia, hi ha platges amb arenes negres. A què creus que es deu això?
4 Descriu el procés de formació d’un penya-segat.




195 U 8
Fletxa
Penya-segat
Arc
Tómbol

Els éssers vius modelen el relleu







Els éssers vius, i en especial l’ésser humà, són agents geològics exògens que poden modelar el relleu.
9.1 El modelat dels éssers vius
La meteorització biològica és el conjunt de processos a través dels quals els éssers vius disgreguen la roca mare per mitjà d’una alteració física o química.
La meteorització física
Consistix en la introducció de les arrels de les plantes a l’interior dels clevills de les roques, que és el primer pas de la formació del sòl.
La meteorització química
La meteorització química consistix en la segregació d’àcids i d’altres substàncies que ataquen les roques, de manera que les disgreguen i passen a formar part del sòl.
La realitzen els bacteris, els líquens i les arrels d’algunes plantes. Els animals excavadors, com els cucs i els talps, contribuïxen a aquesta alteració amb la construcció de galeries per les quals penetren l’aigua i l’aire, que faciliten les reaccions químiques.




196
9
Els cucs i els talps excaven galeries davall terra, per les quals penetren l’aire i l’aigua.
Les arrels de les plantes penetren en les roques i les fragmenten.
9.2 El modelat de l’ésser humà
L’ésser humà utilitza la tecnologia (grues, maquinària pesada, explosius, etc.) per a realitzar modificacions dràstiques del relleu.
Algunes de les modificacions del relleu degudes a les accions de les persones són:
- Els assentaments humans, com les poblacions i els polígons industrials.
- Les pedreres i les mines a cel obert.
- Laes vies de comunicació, com les carreteres, les vies ferroviàries, els ponts, els túnels, etc.
- Els abocadors, on s’acumulen tones de fem que s’acaben cobrint de terra, i els enderrocs, on es depositen àrids sobrants de mines o de construccions.
Alguns canvis, a més de modificar el relleu o el paisatge, també alteren l’acció dels agents geològics externs. Alguns exemples en són:
- Els pantans o canals, que modifiquen l’acció dels rius. Aquestes modificacions es donen tant en el lloc de construcció com en la resta del riu. Per exemple, en els sediments que es deixen de transportar al curs baix el riu.
- Els ports i espigons, que canvien l’acció dels corrents i modifiquen els llocs on es formen les platges.
- Els passejos marítims i les construccions prop de la línia de costa, que modifiquen l’acció del vent i afavorixen la desaparició de les dunes mòbils.
- Els bancals o terrasses de cultiu per a l’explotació agrícola, que modifiquen l’acció de les aigües de torrentera.
COMPRÉN, PENSA, INVESTIGA...
1 Detalla un exemple de meteorització física i un de meteorització química del qual siguen responsables els éssers vius.

2 Busca o fes deu fotografies de modificacions del relleu que es deguen als éssers humans.
3 En la fotografia de la dreta pots veure una presa. Com creus que altera el relleu l’acció dels agents geològics a la zona? Quines conseqüències ambieneus que tenen aques tals creus aquestes construccions?
Assentament













197 U 8
El modelat de l’ésser humà

El sòl
El sòl és un ecosistema
A partir d’aquesta imatge d’un sòl i dels seus habitants, indica quins són el biòtop i la biocenosi d’aquest ecosistema.


10.1
El sòl i els seus components
El sòl és la capa superficial de materials disgregats que recobrix gran part de l’escorça terrestre, sobre el qual es poden desenvolupar les plantes i altres éssers vius.
Els components del sòl
El sòl està format per una gran varietat de components, que es poden agrupar en orgànics i inorgànics.
- Entre els components orgànics podem trobar:
• Éssers vius, com ara bacteris, fongs i xicotets animals vertebrats i invertebrats.
• Restes orgàniques, com ara restes vegetals, cadàvers d’organismes o excrements
• Humus, que són restes de matèria orgànica en estat de descomposició.
- Els components inorgànics presents en el sòl són fragments de roques i minerals, sals minerals, aigua i aire.












198 10
10.2 La formació del sòl
La formació del sòl és un procés extremadament lent, resultat de l’acció conjunta de dos tipus de processos:
- L’alteració i degradació de les roques, deguda a l’acció d’agents atmosfèrics com l’aigua, el vent o els canvis de temperatura.
- L’acció sobre la roca alterada dels éssers vius, que remouen els materials, amb la qual cosa permeten que s’airege, i que descomponen les restes de matèria orgànica, de manera que les transformen en humus i en sals minerals.
La combinació d’aquests processos al llarg del temps transforma la roca en un sòl estructurat i cada vegada més gruixut.
10.3 La importància del sòl
El sòl constituïx una de les riqueses més destacades de la biosfera. Ens assentem sobre el sòl, d’aquest depén l’agricultura, i d’aquesta, la nostra alimentació. És la base per al desenvolupament dels ecosistemes, ja que:
- Al sòl poden arrelar i desenvolupar-se les plantes i altres éssers vius, de manera que és l’hàbitat d’una gran varietat d’organismes.
- Els bacteris i els fongs descomponedors del sòl realitzen el reciclatge de la matèria, de manera que produïxen les sals minerals necessàries per a la nutrició de les plantes.
- El sòl emmagatzema part de l’aigua que s’infiltra, que pot ser absorbida per les plantes i extreta per l’ésser humà.
COMPRÉN, PENSA, INVESTIGA...
1 Escriu la teua definició de sòl.
2 El sòl és imprescindible per als éssers vius; però, es pot formar un sòl sense la intervenció d’éssers vius? Per què?
3 Si la velocitat de formació d’un sòl és d’uns 2 cm cada 1 000 anys, quant de temps tardarà a formar-se un sòl madur d’un gruix de 50 cm?
4 Explica per què el sòl és tan important per als ecosistemes.
5 Explica també quina creus que és la importància del sòl per a l’ésser humà.
Les etapes de formació d’un sòl



1 La formació del sòl comença amb l’alteració de la roca, que genera un suport en el qual pot créixer vegetació.



2 La descomposició de la vegetació dona lloc a l’acumulació de matèria orgànica, que fa augmentar el gruix del sòl.



3 Amb el temps, els processos que renoven els materials (transport i meteorització) donen origen a un sòl totalment estructurat.
199 U 8











COMPRÉN



Organitza les idees

1 Diagrama d’Ishikawa. Completa en el quadern els espais buits d’aquest diagrama d’Ishikawa. Aprén a fer-los amb el recurs disponible en anayaeducacion.es



Per exemple:
• L’oxigen ?
• El diòxid de carboni ?

Fes un resum

L’aigua líquida ? Arrossega ?

Desgasta ?
2 Elabora el teu resum de la unitat seguint aquest guió:
• Anomena els agents geològics exògens responsables del modelat del relleu.
• Enumera els factors geològics i com influïxen en el modelat del relleu.
• Definix meteorització i explica en què consistixen l’erosió, el transport i la sedimentació.
• Diferencia entre les aigües de torrentera i els torrents, explicant els tipus de relleu a què donen lloc.
• Explica com modelen els rius el relleu al curs alt, mitjà i baix.
• Relaciona aqüífer i er modelat càrstic, i indica les diferències entre formes endocàrstiques i exocàrstiques.
• Definix glacera i explica de quins tipus poden ser i les formes de relleu a què donen lloc.
• Detalla com actua el vent i quines formes d’erosió i de sedimentació presenta.
• Explica els moviments de la mar i les formes d’erosió i de sedimentació marina.
• Comenta com influïxen l’ésser humà i altres éssers vius sobre el relleu.






Interpreta imatges








3 Observa i contesta per a cada una de les imatges.


a) Quin procés té lloc? Explica’l breument.
b) Quin és l’agent geològic responsable?
4 En les fotografies següents s’observen dues formes de meteorització causades pel mateix agent geològic.




a) De quin agent geològic es tracta?
b) Quin tipus de meteorització es produïx en cada cas?
c) En què es diferencien?
5 Observa les valls fotografiades en les imatges següents.




a) Identifica quina és una vall glacial i quina una vall fluvial.
b) En què t’has basat per a donar la resposta?
c) Quins altres elements del paisatge ens podrien informar sobre si l’agent que ha modelat el relleu ha sigut l’aigua o el gel?
El
Important
Poden
Alteren
Fragmenten les roques en ? L’ ? produïx hidratació-deshidratació
? produïx gelifracció
en zones ?
? i ?
? de temperatura
A B
A B
A B

Aplica
6 Anomena els processos de meteorització física més importants i indica, en cada cas, quin és l’agent geològic que els produïx.
7 Cita el tipus de reacció de meteorització química que es dona en els exemples següents.
a) Les roques calcàries reaccionen amb el diòxid de carboni de l’aigua, la qual cosa fa que es dissolguen.
b) El vapor d’aigua de l’atmosfera reacciona amb els components de les roques, amb la qual cosa augmenten de volum.
c) Les sals que actuen de ciment en les roques sedimentàries detrítiques són dissoltes per l’aigua.
d) Algunes roques contenen minerals metàl·lics, que reaccionen amb l’oxigen de l’aire.
8 Raona i argumenta, per mitjà d’algun exemple, per què el clima influïx en el modelat del relleu.
9 Explica com influïx la vegetació en el modelat del relleu.
10 Establix les diferències entre:
a) Estalactites i estalagmites.
b) Rius i torrents.
c) Platges i caps.
d) Deltes i estuaris.
e) Avencs i galeries.
f) Dolines i engolidors.
REFLEXIONA
Recorda que en el banc de recursos disposes de:

• de diversos tallers per a gestionar les teues emocions i d’una diana per a avaluar-les;
• de fitxes per a millorar la teua ciutadania digital.

Avança

11 Una de les formes de sedimentació eòlica més característiques són les dunes.


a) Quin tipus de dunes s’observen en la imatge següent?
b) Per la disposició que presenten, diries que els vents tenen una direcció predominant en aquesta regió? Per què?
12 Raona per què al con de dejecció d’un torrent poques vegades trobem sediments arredonits.
En aquesta unitat has aprés com els agents geològics externs actuen per a modelar el relleu i has analitzat els tipus de relleu i les formes peculiars que es formen segons l’agent predominant, el tipus de roca, etc. Reflexiona sobre el teu aprenentatge omplint el qüestionari i la rúbrica, disponibles en anayaeducacion.es
Aspectes
Identifique una formació en el paisatge pròxim i sé dir com s’anomena i com s’ha format.
Puc relacionar l’acció dels processos geològics interns i externs, posant un exemple d’aquesta interrelació.
POSA A PROVA LES TEUES COMPETÈNCIES
Fes l’autoavaluació competencial inclosa en anayaeducacion.es
U 8
Recorda seleccionar el material de treball d’aquesta unitat per al dossier d’aprenentatge.
Totalment aconseguit Bastant aconseguit AconseguitQuasi aconseguit
TRIMESTRE 3



















DOSSIER D’APRENENTATGE
















VIURE EN UN VOLCÀ
En aquest repte s’ha posat el focus en el factor social després d’un fenomen natural devastador. Cada procés geològic que afecta les persones o els seus béns suposa un perjudici que, en determinades zones del món, pot ser de grans dimensions.
Analitzant els riscos associats al vostre entorn més pròxim, és possible que hàgeu descobert perills que desconeixíeu i que podrien arribar a afectar-vos. És molt probable que les autoritats locals estiguen al corrent d’aquests riscos, però sempre són útils estudis nous amb altres perspectives, i més encara quan tenen un caràcter divulgatiu i de comprensió fàcil.
Us proposem enviar una carta a les autoritats locals (ajuntament, junta de districte, regidoria de medi ambient...) en la qual us presenteu i adjunteu l’informe i el mapa amb l’anàlisi dels riscos geològics que heu elaborat.
A més, des d’una perspectiva més global, l’objectiu de desenvolupament sostenible número 11 (Ciutats i comunitats sostenibles) fa al·lusió a la falta de resiliència davant dels desastres naturals de molts territoris, especialment els més vulnerables per no tindre recursos econòmics. Això ens porta a trobar que un terratrémol de la mateixa intensitat causa milers de morts a Haití, i molt poques al Japó.
Us proposem triar una zona del món especialment exposada a riscos naturals (per estar, per exemple, sobre límits de plaques) i analitzar quins són aquests riscos i quines normes i lleis relacionades amb la prevenció de riscos hi ha.
Compareu amb les zones que han analitzat els altres grups i comenteu si les mesures són paregudes o no i a què es poden deure les diferències que hi trobeu.











TAMBÉ POTS PROVAR AQUESTS PROJECTES
Si aquest projecte t’ha resultat interessant i vols investigar més sobre riscos geològics, ací tens algunes idees per a crear els teus projectes.
Estudi de riscos a la Comunitat Valenciana
Si el teu centre està ubicat en una zona de risc geològic baix, es pot ampliar l’àrea que s’ha d’estudiar, analitzant tota la comunitat.
Mapa de riscos geològics de les illes Canàries
Les illes Canàries són una zona geològicament activa i bastant localitzada que permet l’estudi detallat de diferents riscos geològics. El risc volcànic es pot treballar localitzant en el mapa els diversos volcans canaris i estudiant els efectes possibles en cas que s’activaren. A més, podem afegir els riscos derivats dels factors meteorològics associats a una erupció volcànica.
«Georeporters pel món»: anàlisi de riscos a escala mundial
Podem ampliar més l’objectiu de la nostra investigació, buscant com els reporters les zones amb més probabilitats dels diferents tipus de riscos geològics, ubicant-les en el mapa i estudiant-ne les causes i les mesures de prevenció que hi ha en aquests llocs.
Anàlisi de riscos geològics i canvi climàtic
Atés que molts desastres naturals depenen directament de la dinàmica atmosfèrica, i que aquesta està modificada per l’efecte de les activitats humanes, es pot analitzar si hi ha relació entre els riscos geològics i el canvi climàtic (ODS-13). Una anàlisi des d’una perspectiva global que ens farà entendre les diverses conseqüències de la nostra acció sobre el medi.
REVISA LA TEUA PLANIFICACIÓ I EL TREBALL EN GRUP
Revisa la teua planificació del treball i el treball del teu grup en aquest projecte omplint la rúbrica que pots trobar en anayaeducacion.es
PERFIL COMPETENCIAL D’EIXIDA
En finalitzar aquests desafiaments, reflexiona i comprova si has aconseguit els objectius següents:
Descriptor
Utilitze el pensament científic i comprove hipòtesis per mitjà de l’experimentació i de la indagació.
Use el pensament científic per a entendre i explicar fenòmens geològics que tenen lloc al meu voltant.
Localitze, seleccione i contraste informació relacionada amb la geologia de distintes fonts i avalue la fiabilitat que té.
Transmet la informació relacionada amb processos de forma clara i precisa en formats diversos (taules, mapes, esquemes).
Participe, col·labore i interactue, per mitjà d’eines digitals, en la realització de treballs cooperatius.
Emprenc accions fonamentades científicament per a preservar la meua integritat física.


en el quadern


Aconseguit Parcialment aconseguit No aconseguit
Completa
Explorem el nostre patrimoni geològic
El patrimoni geològic
El patrimoni geològic és el conjunt de recursos naturals geològics amb un valor científic, cultural o educatiu que permeten conéixer l’origen i l’evolució de la Terra, els processos que l’han modelada, els climes i els paisatges del passat i del present i l’origen i l’evolució de la vida.
Les figures legals de protecció més importants a Espanya són: lloc d’interés geològic (LIG), punt d’interés geològic (PIG), monument natural i la que oferix la xarxa de geoparcs.
Els llocs d’interés geològic (LIG)
Els LIG es definixen com zones d’interés científic, didàctic o turístic que, pel seu caràcter únic o representatiu, són necessàries per a l’estudi i la interpretació de l’origen i l’evolució dels grans dominis geològics espanyols, incloent-hi els processos que els han modelat, els climes del passat i la seua evolució paleobiològica. Actualment, hi ha més de 3 200 LIG a Espanya.
Monument natural
Els monuments naturals són espais o elements de la naturalesa constituïts bàsicament per formacions de notòria singularitat, raresa o bellesa que mereixen una protecció especial. Poden ser arbres, formacions geològiques, jaciments minerals o paleontològics i qualsevol altre element els valors científics, culturals o paisatgístics dels quals meresquen protecció.


COMPRÉN, PENSA, INVESTIGA...
1 Explica què és el patrimoni geològic i quina utilitat té la seua protecció.
2 Observa els plegaments de la fotografia inferior i explica com es formen.
El plegament Zalesky

El plegament Zalesky és un plegament tombat que es troba prop de la localitat de Pedrezuela, a la Comunitat de Madrid. És un plegament enorme format principalment per roques metamòrfiques com migmatites, quarsites i gneissos travessats per pegmatites, un tipus de roca volcànica.
El seu nom es deu a una pintada que publicitava una botiga d’esports que algú va fer sobre el plegament.


204
Els geoparcs
Els geoparcs són àrees de protecció que promouen l’ús del patrimoni geològic de forma sostenible. Van sorgir a partir d’una proposta de la UNESCO en 2001 per a la creació d’una xarxa global de protecció. En l’actualitat, hi ha més de 140 geoparcs en 41 països.






Geoparc de Villuercas Ibores de Jara
Aquest geoparc està situat al sud-est de la província de Càceres, a Extremadura, entre les conques del Tajo i el Guadiana. És un massís muntanyós que s’estén a través de més de 2 500 km. Dins d’aquest geoparc hi ha nombroses zones d’interés geològic com el cingle de la Villuerca, la mina de Costanza o el congost de Peña Amarilla.

Geoparc de SobrarbPirineus


Aquest geoparc està format per una gran part dels Pirineus, una serralada les roques de la qual es trobaven submergides davall de la mar fa més de 300 milions d’anys. El seu territori cobrix tota la comarca de Sobrarb, al nord de la província d’Osca. En aquest territori es troben el parc nacional d’Ordesa i Mont Perdut, uns quants parcs naturals i nombrosos espais protegits per la xarxa natura 2000.


205 ANNEX
Explorem el nostre patrimoni geològic
La Costa dels Dinosaures

Es coneix amb el nom de Costa dels Dinosaures una zona de la costa asturiana compresa entre les localitats de Gijón i Ribadesella que es caracteritza per la presència de gran quantitat de petjades i d’altres restes paleontològiques de dinosaures i d’altres éssers vius que van viure a la zona durant el Mesozoic i, fonamentalment, durant el Juràssic fa entre 150 i 200 milions d’anys. Actualment, es poden visitar nou jaciments als consells de Villaviciosa, Colunga i Ribadesella.





Les Gredas de Bolnuevo

Les Gredas de Bolnuevo són un monument natural situat al municipi de Mazarrón, a Múrcia. La zona protegida s’estén al llarg de més de 24 000 metres quadrats. Hi predominen les formacions relacionades amb l’erosió pel vent i també nombroses restes fòssils i falles verticals que permeten estudiar la història tectònica de la zona.


206
Rascler d’Escorca



Aquesta formació és un congost càrstic excavat en materials procedents de l’era mesozoica fa entre 66 i 250 milions d’anys. És un dels més significatius i es troba situat a la localitat d’Escorca, a la serra de Tramuntana, a l’illa de Mallorca. L’immens valor natural de la zona ha fet que obtinga la declaració de patrimoni mundial per part de la UNESCO.

Las Tuerces

Es coneix amb aquest nom un paisatge protegit situat a la província de Palència. Es tracta d’un paratge càrstic modelat a partir de calcàries formades durant el Cretaci Superior fa entre 66 i 100 milions d’anys. Una de les formacions més característiques de la zona és el congost de La Horadada, excavat pel riu Pisuerga. A més, l’anomenat Laberinto de Las Tuerces està declarat monument natural.



COMPRÉN, PENSA, INVESTIGA...

3 Busca un LIG que hi haja prop del lloc on vius i confecciona una fitxa en què inclogues les característiques geològiques i l’interés científic que té.


4 Dibuixa en el quadern un mapa d’Espanya i situa-hi els llocs d’interés geològic que es mencionen en aquestes pàgines.
207 ANNEX
© GRUPO ANAYA, S.A., 2024 - C/ Valentín Beato, 21 - 28037 Madrid.
Reservats tots els drets. El contingut d’aquesta obra està protegit per la llei, que estableix penes de presó, multes o ambdues ensems, ultra les indemnitzacions corresponents per danys i perjuís, per a aquells qui reproduïren, plagiaren, distribuïren o comunicaren públicament, en tot o en part, una obra literària, artística o científica, o la seua transformació, interpretació o execució artística fixada en qualsevol tipus de suport o comunicada per qualsevol mitjà sense autorització prèvia.